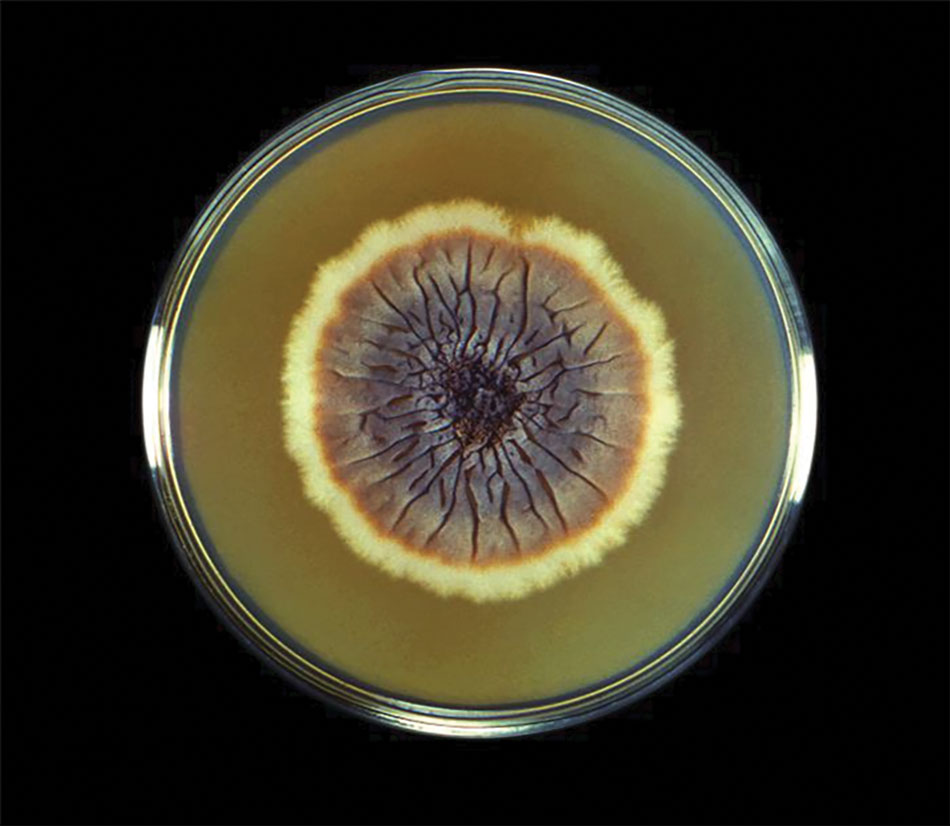
Smith-CDC-Nov-25-2

User login
Approach to Diagnosing and Managing Sporotrichosis
Approach to Diagnosing and Managing Sporotrichosis
Sporotrichosis is an implantation mycosis that classically manifests as a localized skin and subcutaneous fungal infection but may disseminate to other parts of the body.1 It is caused by several species within the Sporothrix genus2 and is associated with varying clinical manifestations, geographic distributions, virulence profiles, and antifungal susceptibility patterns.3,4 Transmission of the fungus can involve inoculation from wild or domestic animals (eg, cats).5,6 Occupations such as landscaping and gardening or elements in the environment (eg, soil, plant fragments) also can be sources of exposure.7,8
Sporotrichosis is recognized by the World Health Organization as a neglected tropical disease that warrants global advocacy to prevent infections and improve patient outcomes.9,10 It carries substantial stigma and socioeconomic burden.11,12 Diagnostics, species identification, and antifungal susceptibility testing often are limited, particularly in resource-limited settings.13 In this article, we outline steps to diagnose and manage sporotrichosis to improve care for affected patients globally.
Epidemiology
Sporotrichosis occurs worldwide but is most common in tropical and subtropical regions.14,15 Outbreaks and clusters of sporotrichosis have been observed across North, Central, and South America as well as in southern Africa and Asia. The estimated annual incidence is 40,000 cases worldwide,16-20 but global case counts likely are underestimated due to limited surveillance data and diagnostic capability.21
On the Asian subcontinent, Sporothrix globosa is the predominant causative species of sporotrichosis, typically via contaminated plant material22; however, at least 1 outbreak has been associated with severe flooding.23 In Africa, infections are most commonly caused by Sporothrix schenckii sensu stricto through a similar transmission route. Across Central America, S schenckii sensu stricto is the predominant causative species; however, Sporothrix brasiliensis is the predominant species in some countries in South America, particularly Brazil.20
Data describing the current geographic distribution and prevalence of sporotrichosis in the United States are limited. Historically, the disease was reported most commonly in Midwestern states and was associated with outbreaks related to handling Sphagnum moss.24,25 Epidemiologic studies using health insurance data indicate an average annual incidence of 2.0 cases per million individuals in the United States, with a higher prevalence among women and a median age at diagnosis of 54 years.26 A review of sporotrichosis-associated hospitalizations across the United States from 2000 to 2013 indicated an average hospitalization rate of 0.35 cases per 1 million individuals; rates were higher (0.45 cases per million) in the West and lower (0.15 per million) in the Northeast and in men (0.40 per million).27 Type 2 diabetes, immune-mediated inflammatory disease, and chronic obstructive pulmonary disease are associated with an increased risk for infection and hospitalization.27
Causative Organisms
Sporothrix species are thermally dimorphic fungi that can grow as mold in the environment and as yeast in human tissue. Sporothrix brasiliensis is the only thermodimorphic fungus known to be transmitted directly in its yeast form.28 In other species, inoculation usually occurs after contact with contaminated soil or plant material during gardening, carpentry, or agricultural practices.7
Zoonotic transmission of sporotrichosis from animals to humans has been reported from a range of domestic and wild animals and birds but historically has been rare.5,7,29,30 Recently, the importance of both cat-to-cat (epizootic) and cat-to-human (zoonotic) transmission of S brasiliensis has been recognized, with infection typically following traumatic inoculation after a scratch or bite; less frequently, transmission occurs due to exposure to respiratory droplets or contact with feline exudates.5,29,31Sporothrix brasiliensis is responsible for zoonotic epidemics in South America, primarily in Brazil. Transmission occurs among humans, cats, and canines, with felines serving as the primary vector.32 Transmission of this species is particularly common in stray and unneutered male cats that exhibit aggressive behaviors.33 This species also is thought to be the most virulent Sporothrix species.21
Sporothrix brasiliensis can persist on nondisinfected inanimate surfaces, which suggests that fomite transmission can lead to human infection.31 The epidemiology of sporotrichosis has transformed in regions where S brasiliensis circulates, with epidemic spread resulting in thousands of cases, whereas in other areas without S brasilinesis, sporotrichosis predominantly occurs sporadically with rare clusters.1,2,7,15
Sporotrichosis has been the subject of a taxonomic debate in the mycology community.21Sporothrix schenckii sensu lato originally was believed to be the sole fungal pathogen causing sporotrichosis34 but was later divided into S schenckii sensu stricto, Sporothrix globosa, and S brasiliensis.35 More than 60 distinct species now have been described within the Sporothrix genus,36,37 but the primary species causing human sporotrichosis include S schenckii sensu stricto, S brasiliensis, S globosa, Sporothrix mexicana, and Sporothrix luriei.35 Both S schenckii and S brasiliensis have greater virulence than other Sporothrix species4; however, S schenckii causes infections that typically are localized and are milder, while S brasiliensis can lead to more atypical, severe, and disseminated infections38,39 and can spread epidemically.
Clinical Manifestations
Sporotrichosis has 4 main clinical presentations: cutaneous lymphatic, fixed cutaneous, cutaneous or systemic disseminated, and extracutaneous.40,41 The most common clinical manifestation is the cutaneous lymphatic form, which predominantly affects the hands and forearms in adults and the face in children.7 The primary lesion usually manifests as a unilateral papule, nodule, or pustule that may ulcerate (sporotrichotic chancre), but multiple sites of inoculation are possible. Subsequent lesions may appear in a linear distribution along a regional lymphatic path (sporotrichoid spread). Systemic symptoms and regional lymphadenopathy are uncommon and usually are mild.
The second most common clinical manifestation is the fixed cutaneous form, typically affecting the face, neck, trunk, or legs with a single papule, nodule, or verrucous lesion with no lymphangitic spread.7 Usually confined to the inoculation site, the primary lesion may be accompanied by satellite lesions and often presents a diagnostic challenge.
Disseminated sporotrichosis (either cutaneous or systemic) is rare. Disseminated cutaneous sporotrichosis manifests with multiple noncontiguous skin lesions caused by lymphatic and possible hematogenous spread. Lesions may include a combination of papules, pustules, follicular eruptions, crusted plaques, and ulcers that may mimic other systemic infections. Immunoreactive changes such as erythema nodosum, erythema multiforme, or arthritis may accompany skin lesions, most commonly with S brasiliensis infections. Nearly 10% of S brasiliensis infections involve the ocular adnexa, and Parinaud oculoglandular syndrome is commonly described in cases reported in Brazil.42,43 Disseminated disease usually occurs in immunocompromised hosts; however, despite a focus on HIV co-infection,8,44 prior epidemiologic research has suggested that diabetes and alcoholism are the most common predisposing factors.45 Systemic disseminated sporotrichosis by definition affects at least 2 body systems, most commonly the central nervous system, lungs, and musculoskeletal system (including joints and bone marrow).45
Extracutaneous sporotrichosis is rare and often is difficult to diagnose. Risk factors include chronic obstructive pulmonary disease, alcoholism, use of steroid medications, AIDS, solid organ transplantation, and use of tumor necrosis factor α inhibitors. It usually affects bony structures through hematogenous spread in immunocompromised hosts and is associated with a high risk for osteomyelitis due to delayed diagnosis.2
Clinical progression of sporotrichosis usually is slow, and lesions may persist for months or years if untreated. Sporotrichosis should always be considered for atypical, persistent, or treatment-resistant manifestations of nodular or ulcerated skin lesions in endemic regions or acute illness with these symptoms following exposure. Preventing secondary bacterial infection is an important consideration as it can exacerbate disease severity, extend the treatment duration, prolong hospitalization, and increase mortality risk.46
Diagnosis
In regions endemic for S brasiliensis, it may be acceptable to commence treatment on clinical suspicion without a definitive diagnosis,21 but caution is necessary, as lesions easily can be mistaken for other conditions such as Mycobacterium marinum infections (sporotrichoid lesions) or cutaneous leishmaniasis. Limited availability of molecular diagnostic tools in routine clinical laboratories affects the diagnosis of sporotrichosis and species identification. Direct microscopy on a 10% to 30% potassium hydroxide wet mount has low diagnostic sensitivity and is not recommended47; findings typically include cigar-shaped yeast cells (eFigure 1). Biopsy and histopathology also are useful, although in many infections (other than those due to S brasiliensis) there are very few detectable organisms in the tissue. Fluorescent staining of fungi with optical brighteners (eg, Calcofluor, Blankophor) is a useful technique with high sensitivity in clinical specimens on histopathologic and direct examination.48

Fungal culture has higher sensitivity and specificity than microscopy and is the gold-standard approach for diagnosis of sporotrichosis (eFigure 2); however, culture cannot differentiate between Sporothrix species and may take more than a month to yield a positive result.7 No reliable serologic test for sporotrichosis has been validated, and a standardized antigen assay currently is unavailable.49 Serology may be more useful for patients who present with systemic disease or have persistently negative culture results despite a high index of suspicion.

A recent study evaluated the effectiveness of a lateral flow assay for detecting anti-Sporothrix antibodies, demonstrating the potential for its use as a rapid diagnostic test.50 Investigating different molecular methods to increase the sensitivity and specificity of diagnosis and distinguish Sporothrix species has been a focus of recent research, with a preference for polymerase chain reaction (PCR)–based genotypic methods.13,51 Recent advances in diagnostic testing include the development of multiplex PCR,52 culture-independent PCR techniques,53 and matrix-assisted laser desorption/ionization–time of flight mass spectrometry,54 each with varying clinical and practical applicability. Specialized testing can be beneficial for patients who have a poor therapeutic response to standard treatment, guide antifungal treatment choices, and identify epidemiologic disease and transmission patterns.21
Although rarely performed, antifungal susceptibility testing may be useful in guiding therapy to improve patient outcomes, particularly in the context of treatment failure, which has been documented with isolates exhibiting high minimal inhibitory concentrations (MICs) to first-line therapy and a poor clinical response.55,56 Proposed mechanisms of resistance include increased cellular melanin production, which protects against oxidative stress and reduces antifungal activity.56 Antifungal susceptibility profiles for therapeutics vary across Sporothrix species; for example, S brasiliensis generally shows lower MICs to itraconazole and terbinafine compared with S schenckii and S globosa, and S schenckii has shown a high MIC to itraconazole, as reflected in MIC distribution studies and epidemiologic cutoff values for antifungal agents.55,57-59 However, specific breakpoints for different Sporothrix species have not been determined.60 Robust clinical studies are needed to determine the correlation of in vitro MICs to clinical outcomes to assess the utility of antifungal susceptibility testing for Sporothrix species.
Management
Treatment of sporotrichosis is guided by clinical presentation, host immune status, and species identification. Management can be challenging in cases with an atypical or delayed diagnosis and limited access to molecular testing methods. Itraconazole is the first-line therapy for management of cutaneous sporotrichosis. It is regarded as safe, effective, well tolerated, and easily administered, with doses ranging from 100 mg in mild cases to 400 mg (with daily or twice-daily dosing).61 Treatment usually is for 3 to 6 months and should continue for 1 month after complete clinical resolution is achieved62; however, some cases of S brasiliensis infection require longer treatment, and complex or disseminated cases may require therapy for up to 12 months.61 Itraconazole is contraindicated in pregnancy and has many drug interactions (through cytochrome P450 inhibition) that may preclude administration, particularly in elderly populations. Therapeutic drug monitoring is recommended for prolonged or high-dose therapy, with periodic liver function testing to reduce the risk for toxicity. Itraconazole should be administered with food, and concurrent use of antacids or proton pump inhibitors should be avoided.61
Oral terbinafine (250 mg daily) can be considered as an effective alternative to treat cutaneous disease.63 Particularly in resource-limited settings, potassium iodide is an affordable and effective treatment for cutaneous sporotrichosis, administered as a saturated oral solution,64 but due to adverse effects such as severe nausea, the daily dose should be increased slowly each day to ensure tolerance.
Amphotericin B is the treatment of choice for severe and treatment-resistant cases of sporotrichosis as well as for immunocompromised patients.21,61 In patients with HIV, a longer treatment course is recommended with oversight from an infectious diseases specialist and usually is followed by a 12-month course of itraconazole after completion of initial therapy.61 Surgical excision infrequently is recommended but can be used in combination with another treatment modality and may be useful with a slow or incomplete response to medical therapy. Thermotherapy involves direct application of heat to cutaneous lesions and may be considered for small and localized lesions, particularly if antifungal agents are contraindicated or poorly tolerated.61 Public health measures include promoting case detection through practitioner education and patient awareness in endemic regions, as well as zoonotic control of infected animals to manage sporotrichosis.
Final Thoughts
Sporotrichosis is a fungal infection with growing public health significance. While the global disease burden is unknown, rising case numbers and geographic spread likely reflect a complex interaction between humans, the environment, and animals, exemplified by the spread of feline-associated infection due to S brasiliensis in South America.28 Cases of S brasiliensis infection after importation of an affected cat have been detected outside South America, and clinicians should be alert for introduction to the United States. Strengthening genotypic and phenotypic diagnostic capabilities will allow species identification and guide treatment and management. Disease surveillance and operational research will inform public health approaches to control sporotrichosis worldwide.
- Queiroz-Telles F, Nucci M, Colombo AL, et al. Mycoses of implantation in Latin America: an overview of epidemiology, clinical manifestations, diagnosis and treatment. Med Mycol. 2011;49:225-236.
- Orofino-Costa R, de Macedo PM, Rodrigues AM, et al. Sporotrichosis: an update on epidemiology, etiopathogenesis, laboratory and clinical therapeutics. An Bras Dermatol. 2017;92:606-620.
- Almeida-Paes R, de Oliveira MM, Freitas DF, et al. Sporotrichosis in Rio de Janeiro, Brazil: Sporothrix brasiliensis is associated with atypical clinical presentations. PLoS Negl Trop Dis. 2014;8:E3094.
- Arrillaga-Moncrieff I, Capilla J, Mayayo E, et al. Different virulence levels of the species of Sporothrix in a murine model. Clin Microbiol Infect. 2009;15:651-655.
- de Lima Barros MB, Schubach TM, Gutierrez-Galhardo MC, et al. Sporotrichosis: an emergent zoonosis in Rio de Janeiro. Mem Inst Oswaldo Cruz. 2001;96:777-779.
- Bao F, Huai P, Chen C, et al. An outbreak of sporotrichosis associated with tying crabs. JAMA Dermatol. 2025;161:883-885.
- de Lima Barros MB, de Almeida Paes R, Schubach AO. Sporothrix schenckii and sporotrichosis. Clin Microbiol Rev. 2011;24:633-654.
- Queiroz-Telles F, Buccheri R, Benard G. Sporotrichosis in immunocompromised hosts. J Fungi. 2019;5:8.
- World Health Organization. Generic Framework for Control, Elimination and Eradication of Neglected Tropical Diseases. World Health Organization; 2016.
- Smith DJ, Soebono H, Parajuli N, et al. South-East Asia regional neglected tropical disease framework: improving control of mycetoma, chromoblastomycosis, and sporotrichosis. Lancet Reg Health Southeast Asia. 2025;35:100561.
- Winck GR, Raimundo RL, Fernandes-Ferreira H, et al. Socioecological vulnerability and the risk of zoonotic disease emergence in Brazil. Sci Adv. 2022;8:eabo5774.
- Jenks JD, Prattes J, Wurster S, et al. Social determinants of health as drivers of fungal disease. EClinicalMedicine. 2023;66:102325.
- Rodrigues AM, Gonçalves SS, de Carvalho JA, et al. Current progress on epidemiology, diagnosis, and treatment of sporotrichosis and their future trends. J Fungi. 2022;8:776.
- Evans EGV, Ashbee HR, Frankland JC, et al. Tropical mycoses: hazards to travellers. In: Evans EGV, Ashbee HR, eds. Tropical Mycology. Vol 2. CABI Publishing; 2002:145-163.
- Matute DR, Teixeira MM. Sporothrix is neglected among the neglected. PLoS Pathog. 2025;21:E1012898.
- Matruchot L. Sur un nouveau groupe de champignons pathogenes, agents des sporotrichoses. Comptes Rendus De L’Académie Des Sci. 1910;150:543-545.
- Dangerfield LF. Sporotriehosis among miners on the Witwatersrand gold mines. S Afr Med J. 1941;15:128-131.
- Fukushiro R. Epidemiology and ecology of sporotrichosis in Japan. Zentralbl Bakteriol Mikrobiol Hyg. 1984;257:228-233.
- Dixon DM, Salkin IF, Duncan RA, et al. Isolation and characterization of Sporothrix schenckii from clinical and environmental sources associated with the largest US epidemic of sporotrichosis. J Clin Microbiol. 1991;29:1106-1113.
- dos Santos AR, Misas E, Min B, et al. Emergence of zoonotic sporotrichosis in Brazil: a genomic epidemiology study. Lancet Microbe. 2024;5:E282-E290.
- Schechtman RC, Falcão EM, Carard M, et al. Sporotrichosis: hyperendemic by zoonotic transmission, with atypical presentations, hypersensitivity reactions and greater severity. An Bras Dermatol. 2022;97:1-13.
- Rodrigues AM, de Hoog GS, de Camargo ZP. Sporothrix species causing outbreaks in animals and humans driven by animal-animal transmission. PLoS Pathog. 2016;12:E1005638.
- Li HY, Song J, Zhang Y. Epidemiological survey of sporotrichosis in Zhaodong, Heilongjiang. Chin J Dermatol. 1995;28:401-402.
- Hajjeh R, McDonnell S, Reef S, et al. Outbreak of sporotrichosis among tree nursery workers. J Infect Dis. 1997;176:499-504.
- Coles FB, Schuchat A, Hibbs JR, et al. A multistate outbreak of sporotrichosis associated with sphagnum moss. Am J Epidemiol. 1992;136:475-487.
- Benedict K, Jackson BR. Sporotrichosis cases in commercial insurance data, United States, 2012-2018. Emerg Infect Dis. 2020;26:2783-2785.
- Gold JAW, Derado G, Mody RK, et al. Sporotrichosis-associated hospitalizations, United States, 2000-2013. Emerg Infect Dis. 2016;22:1817-1820.
- Rossow JA, Queiroz-Telles F, Caceres DH, et al. A One Health approach to combatting Sporothrix brasiliensis: narrative review of an emerging zoonotic fungal pathogen in South America. J Fungi. 2020;6:247-274.
- Madrid IM, Mattei AS, Fernandes CG, et al. Epidemiological findings and laboratory evaluation of sporotrichosis: a description of 103 cases in cats and dogs in southern Brazil. Mycopathologia. 2012;173:265-273.
- Fichman V, Gremião ID, Mendes-Júnior AA, et al. Sporotrichosis transmitted by a cockatiel (Nymphicus hollandicus). J Eur Acad Dermatol Venereol. 2018;32:E157-E158.
- Cognialli RC, Queiroz-Telles F, Cavanaugh AM, et al. New insights on transmission of Sporothrix brasiliensis. Mycoses. 2025;68:E70047.
- Bastos FA, De Farias MR, Gremião ID, et al. Cat-transmitted sporotrichosis by Sporothrix brasiliensis: focus on its potential transmission routes and epidemiological profile. Med Mycol. 2025;63.
- Gremiao ID, Menezes RC, Schubach TM, et al. Feline sporotrichosis: epidemiological and clinical aspects. Med Mycol. 2015;53:15-21.
- Hektoen L, Perkins CF. Refractory subcutaneous abscesses caused by Sporothrix schenckii: a new pathogenic fungus. J Exp Med. 1900;5:77-89.
- Marimon R, Cano J, Gené J, et al. Sporothrix brasiliensis, S. globosa, and S. mexicana, three new Sporothrix species of clinical interest. J Clin Microbiol. 2007;45:3198-3206.
- Rodrigues AM, Della Terra PP, Gremião ID, et al. The threat of emerging and re-emerging pathogenic Sporothrix species. Mycopathologia. 2020;185:813-842.
- Morgado DS, Castro R, Ribeiro-Alves M, et al. Global distribution of animal sporotrichosis: a systematic review of Sporothrix sp. identified using molecular tools. Curr Res Microbial Sci. 2022;3:100140.
- de Lima IM, Ferraz CE, Lima-Neto RG, et al. Case report: Sweet syndrome in patients with sporotrichosis: a 10-case series. Am J Trop Med Hyg. 2020;103:2533-2538.
- Xavier MO, Bittencourt LR, da Silva CM, et al. Atypical presentation of sporotrichosis: report of three cases. Rev Soc Bras Med Trop. 2013;46:116-118.
- Ramos-e-Silva M, Vasconcelos C, Carneiro S, et al. Sporotrichosis. Clin Dermatol. 2007;25:181-187.
- Sampaio SA, Lacaz CS. Klinische und statische Untersuchungen uber Sporotrichose in Sao Paulo. Der Hautarzt. 1959;10:490-493.
- Arinelli A, Aleixo L, Freitas DF, et al. Ocular manifestations of sporotrichosis in a hyperendemic region in Brazil: description of a series of 120 cases. Ocul Immunol Inflamm. 2023;31:329-337.
- Cognialli RC, Cáceres DH, Bastos FA, et al. Rising incidence of Sporothrix brasiliensis infections, Curitiba, Brazil, 2011-2022. Emerg Infect Dis. 2023;29:1330-1339.
- Freitas DF, Valle AC, da Silva MB, et al. Sporotrichosis: an emerging neglected opportunistic infection in HIV-infected patients in Rio de Janeiro, Brazil. PLoS Negl Trop Dis. 2014;8:E3110.
- Bonifaz A, Tirado-Sánchez A. Cutaneous disseminated and extracutaneous sporotrichosis: current status of a complex disease. J Fungi. 2017;3:6.
- Falcão EM, de Lima Filho JB, Campos DP, et al. Hospitalizações e óbitos relacionados à esporotricose no Brasil (1992-2015). Cad Saude Publica. 2019;35:4.
- Mahajan VK, Burkhart CG. Sporotrichosis: an overview and therapeutic options. Dermatol Res Pract. 2014;2014:32-44.
- Hamer EC, Moore CB, Denning DW. Comparison of two fluorescent whiteners, Calcofluor and Blankophor, for the detection of fungal elements in clinical specimens in the diagnostic laboratory. Clin Microbiol Infect. 2006;12:181-184.
- Bernardes-Engemann AR, Orofino Costa RC, Miguens BP, et al. Development of an enzyme-linked immunosorbent assay for the serodiagnosis of several clinical forms of sporotrichosis. Med Mycol. 2005;43:487-493.
- Cognialli R, Bloss K, Weiss I, et al. A lateral flow assay for the immunodiagnosis of human cat-transmitted sporotrichosis. Mycoses. 2022;65:926-934.
- Rodrigues AM, de Hoog GS, de Camargo ZP. Molecular diagnosis of pathogenic Sporothrix species. PLoS Negl Trop Dis. 2015;9:E0004190.
- Della Terra PP, Gonsales FF, de Carvalho JA, et al. Development and evaluation of a multiplex qPCR assay for rapid diagnostics of emerging sporotrichosis. Transbound Emerg Dis. 2022;69.
- Kano R, Nakamura Y, Watanabe S, et al. Identification of Sporothrix schenckii based on sequences of the chitin synthase 1 gene. Mycoses. 2001;44:261-265.
- Oliveira MM, Santos C, Sampaio P, et al. Development and optimization of a new MALDI-TOF protocol for identification of the Sporothrix species complex. Res Microbiol. 2015;166:102-110.
- Bernardes-Engemann AR, Tomki GF, Rabello VBS, et al. Sporotrichosis caused by non-wild type Sporothrix brasiliensis strains. Front Cell Infect Microbiol. 2022;12:893501.
- Waller SB, Dalla Lana DF, Quatrin PM, et al. Antifungal resistance on Sporothrix species: an overview. Braz J Microbiol. 2021;52:73-80.
- Marimon R, Serena C, Gene J. In vitro antifungal susceptibilities of five species of sporothrix. Antimicrob Agents Chemother. 2008;52:732-734.
- Clinical and Laboratory Standards Institute (CLSI). Reference Method for Broth Dilution Antifungal Susceptibility Testing of Yeasts (M27, 4th edition). 4th ed. Clinical and Laboratory Standards Institute (CLSI); 2017.
- Clinical and Laboratory Standards Institute (CLSI). Reference Method for Broth Dilution Antifungal Susceptibility Testing of Filamentous Fungi (Approved Standard, M38, 3rd edition). Clinical and Laboratory Standards Institute (CLSI); 2017
- Oliveira DC, Lopes PG, Spader TB, et al. Antifungal susceptibilities of Sporothrix albicans, S. brasiliensis, and S. luriei of the S. schenckii complex identified in Brazil. J Clin Microbiol. 2011;49:3047-3049.
- Kauffman CA, Bustamante B, Chapman SW, et al. Clinical practice guidelines for the management of sporotrichosis: 2007 update by the Infectious Diseases Society of America. Clin Infect Dis. 2007;45:1255-1265.
- Thompson GR, Le T, Chindamporn A, et al. Global guideline for the diagnosis and management of the endemic mycoses: an initiative of the European Confederation of Medical Mycology in cooperation with the International Society for Human and Animal Mycology. Lancet Infect Dis. 2021;21:E364-E374.
- Francesconi G, Valle AC, Passos S, et al. Terbinafine (250 mg/day): an effective and safe treatment of cutaneous sporotrichosis. J Eur Acad Dermatol Venereol. 2009;23:1273-1276.
- Macedo PM, Lopes-Bezerra LM, Bernardes-Engemann AR, et al. New posology of potassium iodide for the treatment of cutaneous sporotrichosis: study of efficacy and safety in 102 patients. J Eur Acad Dermatol Venereol. 2015;29:719-724.
Sporotrichosis is an implantation mycosis that classically manifests as a localized skin and subcutaneous fungal infection but may disseminate to other parts of the body.1 It is caused by several species within the Sporothrix genus2 and is associated with varying clinical manifestations, geographic distributions, virulence profiles, and antifungal susceptibility patterns.3,4 Transmission of the fungus can involve inoculation from wild or domestic animals (eg, cats).5,6 Occupations such as landscaping and gardening or elements in the environment (eg, soil, plant fragments) also can be sources of exposure.7,8
Sporotrichosis is recognized by the World Health Organization as a neglected tropical disease that warrants global advocacy to prevent infections and improve patient outcomes.9,10 It carries substantial stigma and socioeconomic burden.11,12 Diagnostics, species identification, and antifungal susceptibility testing often are limited, particularly in resource-limited settings.13 In this article, we outline steps to diagnose and manage sporotrichosis to improve care for affected patients globally.
Epidemiology
Sporotrichosis occurs worldwide but is most common in tropical and subtropical regions.14,15 Outbreaks and clusters of sporotrichosis have been observed across North, Central, and South America as well as in southern Africa and Asia. The estimated annual incidence is 40,000 cases worldwide,16-20 but global case counts likely are underestimated due to limited surveillance data and diagnostic capability.21
On the Asian subcontinent, Sporothrix globosa is the predominant causative species of sporotrichosis, typically via contaminated plant material22; however, at least 1 outbreak has been associated with severe flooding.23 In Africa, infections are most commonly caused by Sporothrix schenckii sensu stricto through a similar transmission route. Across Central America, S schenckii sensu stricto is the predominant causative species; however, Sporothrix brasiliensis is the predominant species in some countries in South America, particularly Brazil.20
Data describing the current geographic distribution and prevalence of sporotrichosis in the United States are limited. Historically, the disease was reported most commonly in Midwestern states and was associated with outbreaks related to handling Sphagnum moss.24,25 Epidemiologic studies using health insurance data indicate an average annual incidence of 2.0 cases per million individuals in the United States, with a higher prevalence among women and a median age at diagnosis of 54 years.26 A review of sporotrichosis-associated hospitalizations across the United States from 2000 to 2013 indicated an average hospitalization rate of 0.35 cases per 1 million individuals; rates were higher (0.45 cases per million) in the West and lower (0.15 per million) in the Northeast and in men (0.40 per million).27 Type 2 diabetes, immune-mediated inflammatory disease, and chronic obstructive pulmonary disease are associated with an increased risk for infection and hospitalization.27
Causative Organisms
Sporothrix species are thermally dimorphic fungi that can grow as mold in the environment and as yeast in human tissue. Sporothrix brasiliensis is the only thermodimorphic fungus known to be transmitted directly in its yeast form.28 In other species, inoculation usually occurs after contact with contaminated soil or plant material during gardening, carpentry, or agricultural practices.7
Zoonotic transmission of sporotrichosis from animals to humans has been reported from a range of domestic and wild animals and birds but historically has been rare.5,7,29,30 Recently, the importance of both cat-to-cat (epizootic) and cat-to-human (zoonotic) transmission of S brasiliensis has been recognized, with infection typically following traumatic inoculation after a scratch or bite; less frequently, transmission occurs due to exposure to respiratory droplets or contact with feline exudates.5,29,31Sporothrix brasiliensis is responsible for zoonotic epidemics in South America, primarily in Brazil. Transmission occurs among humans, cats, and canines, with felines serving as the primary vector.32 Transmission of this species is particularly common in stray and unneutered male cats that exhibit aggressive behaviors.33 This species also is thought to be the most virulent Sporothrix species.21
Sporothrix brasiliensis can persist on nondisinfected inanimate surfaces, which suggests that fomite transmission can lead to human infection.31 The epidemiology of sporotrichosis has transformed in regions where S brasiliensis circulates, with epidemic spread resulting in thousands of cases, whereas in other areas without S brasilinesis, sporotrichosis predominantly occurs sporadically with rare clusters.1,2,7,15
Sporotrichosis has been the subject of a taxonomic debate in the mycology community.21Sporothrix schenckii sensu lato originally was believed to be the sole fungal pathogen causing sporotrichosis34 but was later divided into S schenckii sensu stricto, Sporothrix globosa, and S brasiliensis.35 More than 60 distinct species now have been described within the Sporothrix genus,36,37 but the primary species causing human sporotrichosis include S schenckii sensu stricto, S brasiliensis, S globosa, Sporothrix mexicana, and Sporothrix luriei.35 Both S schenckii and S brasiliensis have greater virulence than other Sporothrix species4; however, S schenckii causes infections that typically are localized and are milder, while S brasiliensis can lead to more atypical, severe, and disseminated infections38,39 and can spread epidemically.
Clinical Manifestations
Sporotrichosis has 4 main clinical presentations: cutaneous lymphatic, fixed cutaneous, cutaneous or systemic disseminated, and extracutaneous.40,41 The most common clinical manifestation is the cutaneous lymphatic form, which predominantly affects the hands and forearms in adults and the face in children.7 The primary lesion usually manifests as a unilateral papule, nodule, or pustule that may ulcerate (sporotrichotic chancre), but multiple sites of inoculation are possible. Subsequent lesions may appear in a linear distribution along a regional lymphatic path (sporotrichoid spread). Systemic symptoms and regional lymphadenopathy are uncommon and usually are mild.
The second most common clinical manifestation is the fixed cutaneous form, typically affecting the face, neck, trunk, or legs with a single papule, nodule, or verrucous lesion with no lymphangitic spread.7 Usually confined to the inoculation site, the primary lesion may be accompanied by satellite lesions and often presents a diagnostic challenge.
Disseminated sporotrichosis (either cutaneous or systemic) is rare. Disseminated cutaneous sporotrichosis manifests with multiple noncontiguous skin lesions caused by lymphatic and possible hematogenous spread. Lesions may include a combination of papules, pustules, follicular eruptions, crusted plaques, and ulcers that may mimic other systemic infections. Immunoreactive changes such as erythema nodosum, erythema multiforme, or arthritis may accompany skin lesions, most commonly with S brasiliensis infections. Nearly 10% of S brasiliensis infections involve the ocular adnexa, and Parinaud oculoglandular syndrome is commonly described in cases reported in Brazil.42,43 Disseminated disease usually occurs in immunocompromised hosts; however, despite a focus on HIV co-infection,8,44 prior epidemiologic research has suggested that diabetes and alcoholism are the most common predisposing factors.45 Systemic disseminated sporotrichosis by definition affects at least 2 body systems, most commonly the central nervous system, lungs, and musculoskeletal system (including joints and bone marrow).45
Extracutaneous sporotrichosis is rare and often is difficult to diagnose. Risk factors include chronic obstructive pulmonary disease, alcoholism, use of steroid medications, AIDS, solid organ transplantation, and use of tumor necrosis factor α inhibitors. It usually affects bony structures through hematogenous spread in immunocompromised hosts and is associated with a high risk for osteomyelitis due to delayed diagnosis.2
Clinical progression of sporotrichosis usually is slow, and lesions may persist for months or years if untreated. Sporotrichosis should always be considered for atypical, persistent, or treatment-resistant manifestations of nodular or ulcerated skin lesions in endemic regions or acute illness with these symptoms following exposure. Preventing secondary bacterial infection is an important consideration as it can exacerbate disease severity, extend the treatment duration, prolong hospitalization, and increase mortality risk.46
Diagnosis
In regions endemic for S brasiliensis, it may be acceptable to commence treatment on clinical suspicion without a definitive diagnosis,21 but caution is necessary, as lesions easily can be mistaken for other conditions such as Mycobacterium marinum infections (sporotrichoid lesions) or cutaneous leishmaniasis. Limited availability of molecular diagnostic tools in routine clinical laboratories affects the diagnosis of sporotrichosis and species identification. Direct microscopy on a 10% to 30% potassium hydroxide wet mount has low diagnostic sensitivity and is not recommended47; findings typically include cigar-shaped yeast cells (eFigure 1). Biopsy and histopathology also are useful, although in many infections (other than those due to S brasiliensis) there are very few detectable organisms in the tissue. Fluorescent staining of fungi with optical brighteners (eg, Calcofluor, Blankophor) is a useful technique with high sensitivity in clinical specimens on histopathologic and direct examination.48

Fungal culture has higher sensitivity and specificity than microscopy and is the gold-standard approach for diagnosis of sporotrichosis (eFigure 2); however, culture cannot differentiate between Sporothrix species and may take more than a month to yield a positive result.7 No reliable serologic test for sporotrichosis has been validated, and a standardized antigen assay currently is unavailable.49 Serology may be more useful for patients who present with systemic disease or have persistently negative culture results despite a high index of suspicion.

A recent study evaluated the effectiveness of a lateral flow assay for detecting anti-Sporothrix antibodies, demonstrating the potential for its use as a rapid diagnostic test.50 Investigating different molecular methods to increase the sensitivity and specificity of diagnosis and distinguish Sporothrix species has been a focus of recent research, with a preference for polymerase chain reaction (PCR)–based genotypic methods.13,51 Recent advances in diagnostic testing include the development of multiplex PCR,52 culture-independent PCR techniques,53 and matrix-assisted laser desorption/ionization–time of flight mass spectrometry,54 each with varying clinical and practical applicability. Specialized testing can be beneficial for patients who have a poor therapeutic response to standard treatment, guide antifungal treatment choices, and identify epidemiologic disease and transmission patterns.21
Although rarely performed, antifungal susceptibility testing may be useful in guiding therapy to improve patient outcomes, particularly in the context of treatment failure, which has been documented with isolates exhibiting high minimal inhibitory concentrations (MICs) to first-line therapy and a poor clinical response.55,56 Proposed mechanisms of resistance include increased cellular melanin production, which protects against oxidative stress and reduces antifungal activity.56 Antifungal susceptibility profiles for therapeutics vary across Sporothrix species; for example, S brasiliensis generally shows lower MICs to itraconazole and terbinafine compared with S schenckii and S globosa, and S schenckii has shown a high MIC to itraconazole, as reflected in MIC distribution studies and epidemiologic cutoff values for antifungal agents.55,57-59 However, specific breakpoints for different Sporothrix species have not been determined.60 Robust clinical studies are needed to determine the correlation of in vitro MICs to clinical outcomes to assess the utility of antifungal susceptibility testing for Sporothrix species.
Management
Treatment of sporotrichosis is guided by clinical presentation, host immune status, and species identification. Management can be challenging in cases with an atypical or delayed diagnosis and limited access to molecular testing methods. Itraconazole is the first-line therapy for management of cutaneous sporotrichosis. It is regarded as safe, effective, well tolerated, and easily administered, with doses ranging from 100 mg in mild cases to 400 mg (with daily or twice-daily dosing).61 Treatment usually is for 3 to 6 months and should continue for 1 month after complete clinical resolution is achieved62; however, some cases of S brasiliensis infection require longer treatment, and complex or disseminated cases may require therapy for up to 12 months.61 Itraconazole is contraindicated in pregnancy and has many drug interactions (through cytochrome P450 inhibition) that may preclude administration, particularly in elderly populations. Therapeutic drug monitoring is recommended for prolonged or high-dose therapy, with periodic liver function testing to reduce the risk for toxicity. Itraconazole should be administered with food, and concurrent use of antacids or proton pump inhibitors should be avoided.61
Oral terbinafine (250 mg daily) can be considered as an effective alternative to treat cutaneous disease.63 Particularly in resource-limited settings, potassium iodide is an affordable and effective treatment for cutaneous sporotrichosis, administered as a saturated oral solution,64 but due to adverse effects such as severe nausea, the daily dose should be increased slowly each day to ensure tolerance.
Amphotericin B is the treatment of choice for severe and treatment-resistant cases of sporotrichosis as well as for immunocompromised patients.21,61 In patients with HIV, a longer treatment course is recommended with oversight from an infectious diseases specialist and usually is followed by a 12-month course of itraconazole after completion of initial therapy.61 Surgical excision infrequently is recommended but can be used in combination with another treatment modality and may be useful with a slow or incomplete response to medical therapy. Thermotherapy involves direct application of heat to cutaneous lesions and may be considered for small and localized lesions, particularly if antifungal agents are contraindicated or poorly tolerated.61 Public health measures include promoting case detection through practitioner education and patient awareness in endemic regions, as well as zoonotic control of infected animals to manage sporotrichosis.
Final Thoughts
Sporotrichosis is a fungal infection with growing public health significance. While the global disease burden is unknown, rising case numbers and geographic spread likely reflect a complex interaction between humans, the environment, and animals, exemplified by the spread of feline-associated infection due to S brasiliensis in South America.28 Cases of S brasiliensis infection after importation of an affected cat have been detected outside South America, and clinicians should be alert for introduction to the United States. Strengthening genotypic and phenotypic diagnostic capabilities will allow species identification and guide treatment and management. Disease surveillance and operational research will inform public health approaches to control sporotrichosis worldwide.
Sporotrichosis is an implantation mycosis that classically manifests as a localized skin and subcutaneous fungal infection but may disseminate to other parts of the body.1 It is caused by several species within the Sporothrix genus2 and is associated with varying clinical manifestations, geographic distributions, virulence profiles, and antifungal susceptibility patterns.3,4 Transmission of the fungus can involve inoculation from wild or domestic animals (eg, cats).5,6 Occupations such as landscaping and gardening or elements in the environment (eg, soil, plant fragments) also can be sources of exposure.7,8
Sporotrichosis is recognized by the World Health Organization as a neglected tropical disease that warrants global advocacy to prevent infections and improve patient outcomes.9,10 It carries substantial stigma and socioeconomic burden.11,12 Diagnostics, species identification, and antifungal susceptibility testing often are limited, particularly in resource-limited settings.13 In this article, we outline steps to diagnose and manage sporotrichosis to improve care for affected patients globally.
Epidemiology
Sporotrichosis occurs worldwide but is most common in tropical and subtropical regions.14,15 Outbreaks and clusters of sporotrichosis have been observed across North, Central, and South America as well as in southern Africa and Asia. The estimated annual incidence is 40,000 cases worldwide,16-20 but global case counts likely are underestimated due to limited surveillance data and diagnostic capability.21
On the Asian subcontinent, Sporothrix globosa is the predominant causative species of sporotrichosis, typically via contaminated plant material22; however, at least 1 outbreak has been associated with severe flooding.23 In Africa, infections are most commonly caused by Sporothrix schenckii sensu stricto through a similar transmission route. Across Central America, S schenckii sensu stricto is the predominant causative species; however, Sporothrix brasiliensis is the predominant species in some countries in South America, particularly Brazil.20
Data describing the current geographic distribution and prevalence of sporotrichosis in the United States are limited. Historically, the disease was reported most commonly in Midwestern states and was associated with outbreaks related to handling Sphagnum moss.24,25 Epidemiologic studies using health insurance data indicate an average annual incidence of 2.0 cases per million individuals in the United States, with a higher prevalence among women and a median age at diagnosis of 54 years.26 A review of sporotrichosis-associated hospitalizations across the United States from 2000 to 2013 indicated an average hospitalization rate of 0.35 cases per 1 million individuals; rates were higher (0.45 cases per million) in the West and lower (0.15 per million) in the Northeast and in men (0.40 per million).27 Type 2 diabetes, immune-mediated inflammatory disease, and chronic obstructive pulmonary disease are associated with an increased risk for infection and hospitalization.27
Causative Organisms
Sporothrix species are thermally dimorphic fungi that can grow as mold in the environment and as yeast in human tissue. Sporothrix brasiliensis is the only thermodimorphic fungus known to be transmitted directly in its yeast form.28 In other species, inoculation usually occurs after contact with contaminated soil or plant material during gardening, carpentry, or agricultural practices.7
Zoonotic transmission of sporotrichosis from animals to humans has been reported from a range of domestic and wild animals and birds but historically has been rare.5,7,29,30 Recently, the importance of both cat-to-cat (epizootic) and cat-to-human (zoonotic) transmission of S brasiliensis has been recognized, with infection typically following traumatic inoculation after a scratch or bite; less frequently, transmission occurs due to exposure to respiratory droplets or contact with feline exudates.5,29,31Sporothrix brasiliensis is responsible for zoonotic epidemics in South America, primarily in Brazil. Transmission occurs among humans, cats, and canines, with felines serving as the primary vector.32 Transmission of this species is particularly common in stray and unneutered male cats that exhibit aggressive behaviors.33 This species also is thought to be the most virulent Sporothrix species.21
Sporothrix brasiliensis can persist on nondisinfected inanimate surfaces, which suggests that fomite transmission can lead to human infection.31 The epidemiology of sporotrichosis has transformed in regions where S brasiliensis circulates, with epidemic spread resulting in thousands of cases, whereas in other areas without S brasilinesis, sporotrichosis predominantly occurs sporadically with rare clusters.1,2,7,15
Sporotrichosis has been the subject of a taxonomic debate in the mycology community.21Sporothrix schenckii sensu lato originally was believed to be the sole fungal pathogen causing sporotrichosis34 but was later divided into S schenckii sensu stricto, Sporothrix globosa, and S brasiliensis.35 More than 60 distinct species now have been described within the Sporothrix genus,36,37 but the primary species causing human sporotrichosis include S schenckii sensu stricto, S brasiliensis, S globosa, Sporothrix mexicana, and Sporothrix luriei.35 Both S schenckii and S brasiliensis have greater virulence than other Sporothrix species4; however, S schenckii causes infections that typically are localized and are milder, while S brasiliensis can lead to more atypical, severe, and disseminated infections38,39 and can spread epidemically.
Clinical Manifestations
Sporotrichosis has 4 main clinical presentations: cutaneous lymphatic, fixed cutaneous, cutaneous or systemic disseminated, and extracutaneous.40,41 The most common clinical manifestation is the cutaneous lymphatic form, which predominantly affects the hands and forearms in adults and the face in children.7 The primary lesion usually manifests as a unilateral papule, nodule, or pustule that may ulcerate (sporotrichotic chancre), but multiple sites of inoculation are possible. Subsequent lesions may appear in a linear distribution along a regional lymphatic path (sporotrichoid spread). Systemic symptoms and regional lymphadenopathy are uncommon and usually are mild.
The second most common clinical manifestation is the fixed cutaneous form, typically affecting the face, neck, trunk, or legs with a single papule, nodule, or verrucous lesion with no lymphangitic spread.7 Usually confined to the inoculation site, the primary lesion may be accompanied by satellite lesions and often presents a diagnostic challenge.
Disseminated sporotrichosis (either cutaneous or systemic) is rare. Disseminated cutaneous sporotrichosis manifests with multiple noncontiguous skin lesions caused by lymphatic and possible hematogenous spread. Lesions may include a combination of papules, pustules, follicular eruptions, crusted plaques, and ulcers that may mimic other systemic infections. Immunoreactive changes such as erythema nodosum, erythema multiforme, or arthritis may accompany skin lesions, most commonly with S brasiliensis infections. Nearly 10% of S brasiliensis infections involve the ocular adnexa, and Parinaud oculoglandular syndrome is commonly described in cases reported in Brazil.42,43 Disseminated disease usually occurs in immunocompromised hosts; however, despite a focus on HIV co-infection,8,44 prior epidemiologic research has suggested that diabetes and alcoholism are the most common predisposing factors.45 Systemic disseminated sporotrichosis by definition affects at least 2 body systems, most commonly the central nervous system, lungs, and musculoskeletal system (including joints and bone marrow).45
Extracutaneous sporotrichosis is rare and often is difficult to diagnose. Risk factors include chronic obstructive pulmonary disease, alcoholism, use of steroid medications, AIDS, solid organ transplantation, and use of tumor necrosis factor α inhibitors. It usually affects bony structures through hematogenous spread in immunocompromised hosts and is associated with a high risk for osteomyelitis due to delayed diagnosis.2
Clinical progression of sporotrichosis usually is slow, and lesions may persist for months or years if untreated. Sporotrichosis should always be considered for atypical, persistent, or treatment-resistant manifestations of nodular or ulcerated skin lesions in endemic regions or acute illness with these symptoms following exposure. Preventing secondary bacterial infection is an important consideration as it can exacerbate disease severity, extend the treatment duration, prolong hospitalization, and increase mortality risk.46
Diagnosis
In regions endemic for S brasiliensis, it may be acceptable to commence treatment on clinical suspicion without a definitive diagnosis,21 but caution is necessary, as lesions easily can be mistaken for other conditions such as Mycobacterium marinum infections (sporotrichoid lesions) or cutaneous leishmaniasis. Limited availability of molecular diagnostic tools in routine clinical laboratories affects the diagnosis of sporotrichosis and species identification. Direct microscopy on a 10% to 30% potassium hydroxide wet mount has low diagnostic sensitivity and is not recommended47; findings typically include cigar-shaped yeast cells (eFigure 1). Biopsy and histopathology also are useful, although in many infections (other than those due to S brasiliensis) there are very few detectable organisms in the tissue. Fluorescent staining of fungi with optical brighteners (eg, Calcofluor, Blankophor) is a useful technique with high sensitivity in clinical specimens on histopathologic and direct examination.48

Fungal culture has higher sensitivity and specificity than microscopy and is the gold-standard approach for diagnosis of sporotrichosis (eFigure 2); however, culture cannot differentiate between Sporothrix species and may take more than a month to yield a positive result.7 No reliable serologic test for sporotrichosis has been validated, and a standardized antigen assay currently is unavailable.49 Serology may be more useful for patients who present with systemic disease or have persistently negative culture results despite a high index of suspicion.
A recent study evaluated the effectiveness of a lateral flow assay for detecting anti-Sporothrix antibodies, demonstrating the potential for its use as a rapid diagnostic test.50 Investigating different molecular methods to increase the sensitivity and specificity of diagnosis and distinguish Sporothrix species has been a focus of recent research, with a preference for polymerase chain reaction (PCR)–based genotypic methods.13,51 Recent advances in diagnostic testing include the development of multiplex PCR,52 culture-independent PCR techniques,53 and matrix-assisted laser desorption/ionization–time of flight mass spectrometry,54 each with varying clinical and practical applicability. Specialized testing can be beneficial for patients who have a poor therapeutic response to standard treatment, guide antifungal treatment choices, and identify epidemiologic disease and transmission patterns.21
Although rarely performed, antifungal susceptibility testing may be useful in guiding therapy to improve patient outcomes, particularly in the context of treatment failure, which has been documented with isolates exhibiting high minimal inhibitory concentrations (MICs) to first-line therapy and a poor clinical response.55,56 Proposed mechanisms of resistance include increased cellular melanin production, which protects against oxidative stress and reduces antifungal activity.56 Antifungal susceptibility profiles for therapeutics vary across Sporothrix species; for example, S brasiliensis generally shows lower MICs to itraconazole and terbinafine compared with S schenckii and S globosa, and S schenckii has shown a high MIC to itraconazole, as reflected in MIC distribution studies and epidemiologic cutoff values for antifungal agents.55,57-59 However, specific breakpoints for different Sporothrix species have not been determined.60 Robust clinical studies are needed to determine the correlation of in vitro MICs to clinical outcomes to assess the utility of antifungal susceptibility testing for Sporothrix species.
Management
Treatment of sporotrichosis is guided by clinical presentation, host immune status, and species identification. Management can be challenging in cases with an atypical or delayed diagnosis and limited access to molecular testing methods. Itraconazole is the first-line therapy for management of cutaneous sporotrichosis. It is regarded as safe, effective, well tolerated, and easily administered, with doses ranging from 100 mg in mild cases to 400 mg (with daily or twice-daily dosing).61 Treatment usually is for 3 to 6 months and should continue for 1 month after complete clinical resolution is achieved62; however, some cases of S brasiliensis infection require longer treatment, and complex or disseminated cases may require therapy for up to 12 months.61 Itraconazole is contraindicated in pregnancy and has many drug interactions (through cytochrome P450 inhibition) that may preclude administration, particularly in elderly populations. Therapeutic drug monitoring is recommended for prolonged or high-dose therapy, with periodic liver function testing to reduce the risk for toxicity. Itraconazole should be administered with food, and concurrent use of antacids or proton pump inhibitors should be avoided.61
Oral terbinafine (250 mg daily) can be considered as an effective alternative to treat cutaneous disease.63 Particularly in resource-limited settings, potassium iodide is an affordable and effective treatment for cutaneous sporotrichosis, administered as a saturated oral solution,64 but due to adverse effects such as severe nausea, the daily dose should be increased slowly each day to ensure tolerance.
Amphotericin B is the treatment of choice for severe and treatment-resistant cases of sporotrichosis as well as for immunocompromised patients.21,61 In patients with HIV, a longer treatment course is recommended with oversight from an infectious diseases specialist and usually is followed by a 12-month course of itraconazole after completion of initial therapy.61 Surgical excision infrequently is recommended but can be used in combination with another treatment modality and may be useful with a slow or incomplete response to medical therapy. Thermotherapy involves direct application of heat to cutaneous lesions and may be considered for small and localized lesions, particularly if antifungal agents are contraindicated or poorly tolerated.61 Public health measures include promoting case detection through practitioner education and patient awareness in endemic regions, as well as zoonotic control of infected animals to manage sporotrichosis.
Final Thoughts
Sporotrichosis is a fungal infection with growing public health significance. While the global disease burden is unknown, rising case numbers and geographic spread likely reflect a complex interaction between humans, the environment, and animals, exemplified by the spread of feline-associated infection due to S brasiliensis in South America.28 Cases of S brasiliensis infection after importation of an affected cat have been detected outside South America, and clinicians should be alert for introduction to the United States. Strengthening genotypic and phenotypic diagnostic capabilities will allow species identification and guide treatment and management. Disease surveillance and operational research will inform public health approaches to control sporotrichosis worldwide.
- Queiroz-Telles F, Nucci M, Colombo AL, et al. Mycoses of implantation in Latin America: an overview of epidemiology, clinical manifestations, diagnosis and treatment. Med Mycol. 2011;49:225-236.
- Orofino-Costa R, de Macedo PM, Rodrigues AM, et al. Sporotrichosis: an update on epidemiology, etiopathogenesis, laboratory and clinical therapeutics. An Bras Dermatol. 2017;92:606-620.
- Almeida-Paes R, de Oliveira MM, Freitas DF, et al. Sporotrichosis in Rio de Janeiro, Brazil: Sporothrix brasiliensis is associated with atypical clinical presentations. PLoS Negl Trop Dis. 2014;8:E3094.
- Arrillaga-Moncrieff I, Capilla J, Mayayo E, et al. Different virulence levels of the species of Sporothrix in a murine model. Clin Microbiol Infect. 2009;15:651-655.
- de Lima Barros MB, Schubach TM, Gutierrez-Galhardo MC, et al. Sporotrichosis: an emergent zoonosis in Rio de Janeiro. Mem Inst Oswaldo Cruz. 2001;96:777-779.
- Bao F, Huai P, Chen C, et al. An outbreak of sporotrichosis associated with tying crabs. JAMA Dermatol. 2025;161:883-885.
- de Lima Barros MB, de Almeida Paes R, Schubach AO. Sporothrix schenckii and sporotrichosis. Clin Microbiol Rev. 2011;24:633-654.
- Queiroz-Telles F, Buccheri R, Benard G. Sporotrichosis in immunocompromised hosts. J Fungi. 2019;5:8.
- World Health Organization. Generic Framework for Control, Elimination and Eradication of Neglected Tropical Diseases. World Health Organization; 2016.
- Smith DJ, Soebono H, Parajuli N, et al. South-East Asia regional neglected tropical disease framework: improving control of mycetoma, chromoblastomycosis, and sporotrichosis. Lancet Reg Health Southeast Asia. 2025;35:100561.
- Winck GR, Raimundo RL, Fernandes-Ferreira H, et al. Socioecological vulnerability and the risk of zoonotic disease emergence in Brazil. Sci Adv. 2022;8:eabo5774.
- Jenks JD, Prattes J, Wurster S, et al. Social determinants of health as drivers of fungal disease. EClinicalMedicine. 2023;66:102325.
- Rodrigues AM, Gonçalves SS, de Carvalho JA, et al. Current progress on epidemiology, diagnosis, and treatment of sporotrichosis and their future trends. J Fungi. 2022;8:776.
- Evans EGV, Ashbee HR, Frankland JC, et al. Tropical mycoses: hazards to travellers. In: Evans EGV, Ashbee HR, eds. Tropical Mycology. Vol 2. CABI Publishing; 2002:145-163.
- Matute DR, Teixeira MM. Sporothrix is neglected among the neglected. PLoS Pathog. 2025;21:E1012898.
- Matruchot L. Sur un nouveau groupe de champignons pathogenes, agents des sporotrichoses. Comptes Rendus De L’Académie Des Sci. 1910;150:543-545.
- Dangerfield LF. Sporotriehosis among miners on the Witwatersrand gold mines. S Afr Med J. 1941;15:128-131.
- Fukushiro R. Epidemiology and ecology of sporotrichosis in Japan. Zentralbl Bakteriol Mikrobiol Hyg. 1984;257:228-233.
- Dixon DM, Salkin IF, Duncan RA, et al. Isolation and characterization of Sporothrix schenckii from clinical and environmental sources associated with the largest US epidemic of sporotrichosis. J Clin Microbiol. 1991;29:1106-1113.
- dos Santos AR, Misas E, Min B, et al. Emergence of zoonotic sporotrichosis in Brazil: a genomic epidemiology study. Lancet Microbe. 2024;5:E282-E290.
- Schechtman RC, Falcão EM, Carard M, et al. Sporotrichosis: hyperendemic by zoonotic transmission, with atypical presentations, hypersensitivity reactions and greater severity. An Bras Dermatol. 2022;97:1-13.
- Rodrigues AM, de Hoog GS, de Camargo ZP. Sporothrix species causing outbreaks in animals and humans driven by animal-animal transmission. PLoS Pathog. 2016;12:E1005638.
- Li HY, Song J, Zhang Y. Epidemiological survey of sporotrichosis in Zhaodong, Heilongjiang. Chin J Dermatol. 1995;28:401-402.
- Hajjeh R, McDonnell S, Reef S, et al. Outbreak of sporotrichosis among tree nursery workers. J Infect Dis. 1997;176:499-504.
- Coles FB, Schuchat A, Hibbs JR, et al. A multistate outbreak of sporotrichosis associated with sphagnum moss. Am J Epidemiol. 1992;136:475-487.
- Benedict K, Jackson BR. Sporotrichosis cases in commercial insurance data, United States, 2012-2018. Emerg Infect Dis. 2020;26:2783-2785.
- Gold JAW, Derado G, Mody RK, et al. Sporotrichosis-associated hospitalizations, United States, 2000-2013. Emerg Infect Dis. 2016;22:1817-1820.
- Rossow JA, Queiroz-Telles F, Caceres DH, et al. A One Health approach to combatting Sporothrix brasiliensis: narrative review of an emerging zoonotic fungal pathogen in South America. J Fungi. 2020;6:247-274.
- Madrid IM, Mattei AS, Fernandes CG, et al. Epidemiological findings and laboratory evaluation of sporotrichosis: a description of 103 cases in cats and dogs in southern Brazil. Mycopathologia. 2012;173:265-273.
- Fichman V, Gremião ID, Mendes-Júnior AA, et al. Sporotrichosis transmitted by a cockatiel (Nymphicus hollandicus). J Eur Acad Dermatol Venereol. 2018;32:E157-E158.
- Cognialli RC, Queiroz-Telles F, Cavanaugh AM, et al. New insights on transmission of Sporothrix brasiliensis. Mycoses. 2025;68:E70047.
- Bastos FA, De Farias MR, Gremião ID, et al. Cat-transmitted sporotrichosis by Sporothrix brasiliensis: focus on its potential transmission routes and epidemiological profile. Med Mycol. 2025;63.
- Gremiao ID, Menezes RC, Schubach TM, et al. Feline sporotrichosis: epidemiological and clinical aspects. Med Mycol. 2015;53:15-21.
- Hektoen L, Perkins CF. Refractory subcutaneous abscesses caused by Sporothrix schenckii: a new pathogenic fungus. J Exp Med. 1900;5:77-89.
- Marimon R, Cano J, Gené J, et al. Sporothrix brasiliensis, S. globosa, and S. mexicana, three new Sporothrix species of clinical interest. J Clin Microbiol. 2007;45:3198-3206.
- Rodrigues AM, Della Terra PP, Gremião ID, et al. The threat of emerging and re-emerging pathogenic Sporothrix species. Mycopathologia. 2020;185:813-842.
- Morgado DS, Castro R, Ribeiro-Alves M, et al. Global distribution of animal sporotrichosis: a systematic review of Sporothrix sp. identified using molecular tools. Curr Res Microbial Sci. 2022;3:100140.
- de Lima IM, Ferraz CE, Lima-Neto RG, et al. Case report: Sweet syndrome in patients with sporotrichosis: a 10-case series. Am J Trop Med Hyg. 2020;103:2533-2538.
- Xavier MO, Bittencourt LR, da Silva CM, et al. Atypical presentation of sporotrichosis: report of three cases. Rev Soc Bras Med Trop. 2013;46:116-118.
- Ramos-e-Silva M, Vasconcelos C, Carneiro S, et al. Sporotrichosis. Clin Dermatol. 2007;25:181-187.
- Sampaio SA, Lacaz CS. Klinische und statische Untersuchungen uber Sporotrichose in Sao Paulo. Der Hautarzt. 1959;10:490-493.
- Arinelli A, Aleixo L, Freitas DF, et al. Ocular manifestations of sporotrichosis in a hyperendemic region in Brazil: description of a series of 120 cases. Ocul Immunol Inflamm. 2023;31:329-337.
- Cognialli RC, Cáceres DH, Bastos FA, et al. Rising incidence of Sporothrix brasiliensis infections, Curitiba, Brazil, 2011-2022. Emerg Infect Dis. 2023;29:1330-1339.
- Freitas DF, Valle AC, da Silva MB, et al. Sporotrichosis: an emerging neglected opportunistic infection in HIV-infected patients in Rio de Janeiro, Brazil. PLoS Negl Trop Dis. 2014;8:E3110.
- Bonifaz A, Tirado-Sánchez A. Cutaneous disseminated and extracutaneous sporotrichosis: current status of a complex disease. J Fungi. 2017;3:6.
- Falcão EM, de Lima Filho JB, Campos DP, et al. Hospitalizações e óbitos relacionados à esporotricose no Brasil (1992-2015). Cad Saude Publica. 2019;35:4.
- Mahajan VK, Burkhart CG. Sporotrichosis: an overview and therapeutic options. Dermatol Res Pract. 2014;2014:32-44.
- Hamer EC, Moore CB, Denning DW. Comparison of two fluorescent whiteners, Calcofluor and Blankophor, for the detection of fungal elements in clinical specimens in the diagnostic laboratory. Clin Microbiol Infect. 2006;12:181-184.
- Bernardes-Engemann AR, Orofino Costa RC, Miguens BP, et al. Development of an enzyme-linked immunosorbent assay for the serodiagnosis of several clinical forms of sporotrichosis. Med Mycol. 2005;43:487-493.
- Cognialli R, Bloss K, Weiss I, et al. A lateral flow assay for the immunodiagnosis of human cat-transmitted sporotrichosis. Mycoses. 2022;65:926-934.
- Rodrigues AM, de Hoog GS, de Camargo ZP. Molecular diagnosis of pathogenic Sporothrix species. PLoS Negl Trop Dis. 2015;9:E0004190.
- Della Terra PP, Gonsales FF, de Carvalho JA, et al. Development and evaluation of a multiplex qPCR assay for rapid diagnostics of emerging sporotrichosis. Transbound Emerg Dis. 2022;69.
- Kano R, Nakamura Y, Watanabe S, et al. Identification of Sporothrix schenckii based on sequences of the chitin synthase 1 gene. Mycoses. 2001;44:261-265.
- Oliveira MM, Santos C, Sampaio P, et al. Development and optimization of a new MALDI-TOF protocol for identification of the Sporothrix species complex. Res Microbiol. 2015;166:102-110.
- Bernardes-Engemann AR, Tomki GF, Rabello VBS, et al. Sporotrichosis caused by non-wild type Sporothrix brasiliensis strains. Front Cell Infect Microbiol. 2022;12:893501.
- Waller SB, Dalla Lana DF, Quatrin PM, et al. Antifungal resistance on Sporothrix species: an overview. Braz J Microbiol. 2021;52:73-80.
- Marimon R, Serena C, Gene J. In vitro antifungal susceptibilities of five species of sporothrix. Antimicrob Agents Chemother. 2008;52:732-734.
- Clinical and Laboratory Standards Institute (CLSI). Reference Method for Broth Dilution Antifungal Susceptibility Testing of Yeasts (M27, 4th edition). 4th ed. Clinical and Laboratory Standards Institute (CLSI); 2017.
- Clinical and Laboratory Standards Institute (CLSI). Reference Method for Broth Dilution Antifungal Susceptibility Testing of Filamentous Fungi (Approved Standard, M38, 3rd edition). Clinical and Laboratory Standards Institute (CLSI); 2017
- Oliveira DC, Lopes PG, Spader TB, et al. Antifungal susceptibilities of Sporothrix albicans, S. brasiliensis, and S. luriei of the S. schenckii complex identified in Brazil. J Clin Microbiol. 2011;49:3047-3049.
- Kauffman CA, Bustamante B, Chapman SW, et al. Clinical practice guidelines for the management of sporotrichosis: 2007 update by the Infectious Diseases Society of America. Clin Infect Dis. 2007;45:1255-1265.
- Thompson GR, Le T, Chindamporn A, et al. Global guideline for the diagnosis and management of the endemic mycoses: an initiative of the European Confederation of Medical Mycology in cooperation with the International Society for Human and Animal Mycology. Lancet Infect Dis. 2021;21:E364-E374.
- Francesconi G, Valle AC, Passos S, et al. Terbinafine (250 mg/day): an effective and safe treatment of cutaneous sporotrichosis. J Eur Acad Dermatol Venereol. 2009;23:1273-1276.
- Macedo PM, Lopes-Bezerra LM, Bernardes-Engemann AR, et al. New posology of potassium iodide for the treatment of cutaneous sporotrichosis: study of efficacy and safety in 102 patients. J Eur Acad Dermatol Venereol. 2015;29:719-724.
- Queiroz-Telles F, Nucci M, Colombo AL, et al. Mycoses of implantation in Latin America: an overview of epidemiology, clinical manifestations, diagnosis and treatment. Med Mycol. 2011;49:225-236.
- Orofino-Costa R, de Macedo PM, Rodrigues AM, et al. Sporotrichosis: an update on epidemiology, etiopathogenesis, laboratory and clinical therapeutics. An Bras Dermatol. 2017;92:606-620.
- Almeida-Paes R, de Oliveira MM, Freitas DF, et al. Sporotrichosis in Rio de Janeiro, Brazil: Sporothrix brasiliensis is associated with atypical clinical presentations. PLoS Negl Trop Dis. 2014;8:E3094.
- Arrillaga-Moncrieff I, Capilla J, Mayayo E, et al. Different virulence levels of the species of Sporothrix in a murine model. Clin Microbiol Infect. 2009;15:651-655.
- de Lima Barros MB, Schubach TM, Gutierrez-Galhardo MC, et al. Sporotrichosis: an emergent zoonosis in Rio de Janeiro. Mem Inst Oswaldo Cruz. 2001;96:777-779.
- Bao F, Huai P, Chen C, et al. An outbreak of sporotrichosis associated with tying crabs. JAMA Dermatol. 2025;161:883-885.
- de Lima Barros MB, de Almeida Paes R, Schubach AO. Sporothrix schenckii and sporotrichosis. Clin Microbiol Rev. 2011;24:633-654.
- Queiroz-Telles F, Buccheri R, Benard G. Sporotrichosis in immunocompromised hosts. J Fungi. 2019;5:8.
- World Health Organization. Generic Framework for Control, Elimination and Eradication of Neglected Tropical Diseases. World Health Organization; 2016.
- Smith DJ, Soebono H, Parajuli N, et al. South-East Asia regional neglected tropical disease framework: improving control of mycetoma, chromoblastomycosis, and sporotrichosis. Lancet Reg Health Southeast Asia. 2025;35:100561.
- Winck GR, Raimundo RL, Fernandes-Ferreira H, et al. Socioecological vulnerability and the risk of zoonotic disease emergence in Brazil. Sci Adv. 2022;8:eabo5774.
- Jenks JD, Prattes J, Wurster S, et al. Social determinants of health as drivers of fungal disease. EClinicalMedicine. 2023;66:102325.
- Rodrigues AM, Gonçalves SS, de Carvalho JA, et al. Current progress on epidemiology, diagnosis, and treatment of sporotrichosis and their future trends. J Fungi. 2022;8:776.
- Evans EGV, Ashbee HR, Frankland JC, et al. Tropical mycoses: hazards to travellers. In: Evans EGV, Ashbee HR, eds. Tropical Mycology. Vol 2. CABI Publishing; 2002:145-163.
- Matute DR, Teixeira MM. Sporothrix is neglected among the neglected. PLoS Pathog. 2025;21:E1012898.
- Matruchot L. Sur un nouveau groupe de champignons pathogenes, agents des sporotrichoses. Comptes Rendus De L’Académie Des Sci. 1910;150:543-545.
- Dangerfield LF. Sporotriehosis among miners on the Witwatersrand gold mines. S Afr Med J. 1941;15:128-131.
- Fukushiro R. Epidemiology and ecology of sporotrichosis in Japan. Zentralbl Bakteriol Mikrobiol Hyg. 1984;257:228-233.
- Dixon DM, Salkin IF, Duncan RA, et al. Isolation and characterization of Sporothrix schenckii from clinical and environmental sources associated with the largest US epidemic of sporotrichosis. J Clin Microbiol. 1991;29:1106-1113.
- dos Santos AR, Misas E, Min B, et al. Emergence of zoonotic sporotrichosis in Brazil: a genomic epidemiology study. Lancet Microbe. 2024;5:E282-E290.
- Schechtman RC, Falcão EM, Carard M, et al. Sporotrichosis: hyperendemic by zoonotic transmission, with atypical presentations, hypersensitivity reactions and greater severity. An Bras Dermatol. 2022;97:1-13.
- Rodrigues AM, de Hoog GS, de Camargo ZP. Sporothrix species causing outbreaks in animals and humans driven by animal-animal transmission. PLoS Pathog. 2016;12:E1005638.
- Li HY, Song J, Zhang Y. Epidemiological survey of sporotrichosis in Zhaodong, Heilongjiang. Chin J Dermatol. 1995;28:401-402.
- Hajjeh R, McDonnell S, Reef S, et al. Outbreak of sporotrichosis among tree nursery workers. J Infect Dis. 1997;176:499-504.
- Coles FB, Schuchat A, Hibbs JR, et al. A multistate outbreak of sporotrichosis associated with sphagnum moss. Am J Epidemiol. 1992;136:475-487.
- Benedict K, Jackson BR. Sporotrichosis cases in commercial insurance data, United States, 2012-2018. Emerg Infect Dis. 2020;26:2783-2785.
- Gold JAW, Derado G, Mody RK, et al. Sporotrichosis-associated hospitalizations, United States, 2000-2013. Emerg Infect Dis. 2016;22:1817-1820.
- Rossow JA, Queiroz-Telles F, Caceres DH, et al. A One Health approach to combatting Sporothrix brasiliensis: narrative review of an emerging zoonotic fungal pathogen in South America. J Fungi. 2020;6:247-274.
- Madrid IM, Mattei AS, Fernandes CG, et al. Epidemiological findings and laboratory evaluation of sporotrichosis: a description of 103 cases in cats and dogs in southern Brazil. Mycopathologia. 2012;173:265-273.
- Fichman V, Gremião ID, Mendes-Júnior AA, et al. Sporotrichosis transmitted by a cockatiel (Nymphicus hollandicus). J Eur Acad Dermatol Venereol. 2018;32:E157-E158.
- Cognialli RC, Queiroz-Telles F, Cavanaugh AM, et al. New insights on transmission of Sporothrix brasiliensis. Mycoses. 2025;68:E70047.
- Bastos FA, De Farias MR, Gremião ID, et al. Cat-transmitted sporotrichosis by Sporothrix brasiliensis: focus on its potential transmission routes and epidemiological profile. Med Mycol. 2025;63.
- Gremiao ID, Menezes RC, Schubach TM, et al. Feline sporotrichosis: epidemiological and clinical aspects. Med Mycol. 2015;53:15-21.
- Hektoen L, Perkins CF. Refractory subcutaneous abscesses caused by Sporothrix schenckii: a new pathogenic fungus. J Exp Med. 1900;5:77-89.
- Marimon R, Cano J, Gené J, et al. Sporothrix brasiliensis, S. globosa, and S. mexicana, three new Sporothrix species of clinical interest. J Clin Microbiol. 2007;45:3198-3206.
- Rodrigues AM, Della Terra PP, Gremião ID, et al. The threat of emerging and re-emerging pathogenic Sporothrix species. Mycopathologia. 2020;185:813-842.
- Morgado DS, Castro R, Ribeiro-Alves M, et al. Global distribution of animal sporotrichosis: a systematic review of Sporothrix sp. identified using molecular tools. Curr Res Microbial Sci. 2022;3:100140.
- de Lima IM, Ferraz CE, Lima-Neto RG, et al. Case report: Sweet syndrome in patients with sporotrichosis: a 10-case series. Am J Trop Med Hyg. 2020;103:2533-2538.
- Xavier MO, Bittencourt LR, da Silva CM, et al. Atypical presentation of sporotrichosis: report of three cases. Rev Soc Bras Med Trop. 2013;46:116-118.
- Ramos-e-Silva M, Vasconcelos C, Carneiro S, et al. Sporotrichosis. Clin Dermatol. 2007;25:181-187.
- Sampaio SA, Lacaz CS. Klinische und statische Untersuchungen uber Sporotrichose in Sao Paulo. Der Hautarzt. 1959;10:490-493.
- Arinelli A, Aleixo L, Freitas DF, et al. Ocular manifestations of sporotrichosis in a hyperendemic region in Brazil: description of a series of 120 cases. Ocul Immunol Inflamm. 2023;31:329-337.
- Cognialli RC, Cáceres DH, Bastos FA, et al. Rising incidence of Sporothrix brasiliensis infections, Curitiba, Brazil, 2011-2022. Emerg Infect Dis. 2023;29:1330-1339.
- Freitas DF, Valle AC, da Silva MB, et al. Sporotrichosis: an emerging neglected opportunistic infection in HIV-infected patients in Rio de Janeiro, Brazil. PLoS Negl Trop Dis. 2014;8:E3110.
- Bonifaz A, Tirado-Sánchez A. Cutaneous disseminated and extracutaneous sporotrichosis: current status of a complex disease. J Fungi. 2017;3:6.
- Falcão EM, de Lima Filho JB, Campos DP, et al. Hospitalizações e óbitos relacionados à esporotricose no Brasil (1992-2015). Cad Saude Publica. 2019;35:4.
- Mahajan VK, Burkhart CG. Sporotrichosis: an overview and therapeutic options. Dermatol Res Pract. 2014;2014:32-44.
- Hamer EC, Moore CB, Denning DW. Comparison of two fluorescent whiteners, Calcofluor and Blankophor, for the detection of fungal elements in clinical specimens in the diagnostic laboratory. Clin Microbiol Infect. 2006;12:181-184.
- Bernardes-Engemann AR, Orofino Costa RC, Miguens BP, et al. Development of an enzyme-linked immunosorbent assay for the serodiagnosis of several clinical forms of sporotrichosis. Med Mycol. 2005;43:487-493.
- Cognialli R, Bloss K, Weiss I, et al. A lateral flow assay for the immunodiagnosis of human cat-transmitted sporotrichosis. Mycoses. 2022;65:926-934.
- Rodrigues AM, de Hoog GS, de Camargo ZP. Molecular diagnosis of pathogenic Sporothrix species. PLoS Negl Trop Dis. 2015;9:E0004190.
- Della Terra PP, Gonsales FF, de Carvalho JA, et al. Development and evaluation of a multiplex qPCR assay for rapid diagnostics of emerging sporotrichosis. Transbound Emerg Dis. 2022;69.
- Kano R, Nakamura Y, Watanabe S, et al. Identification of Sporothrix schenckii based on sequences of the chitin synthase 1 gene. Mycoses. 2001;44:261-265.
- Oliveira MM, Santos C, Sampaio P, et al. Development and optimization of a new MALDI-TOF protocol for identification of the Sporothrix species complex. Res Microbiol. 2015;166:102-110.
- Bernardes-Engemann AR, Tomki GF, Rabello VBS, et al. Sporotrichosis caused by non-wild type Sporothrix brasiliensis strains. Front Cell Infect Microbiol. 2022;12:893501.
- Waller SB, Dalla Lana DF, Quatrin PM, et al. Antifungal resistance on Sporothrix species: an overview. Braz J Microbiol. 2021;52:73-80.
- Marimon R, Serena C, Gene J. In vitro antifungal susceptibilities of five species of sporothrix. Antimicrob Agents Chemother. 2008;52:732-734.
- Clinical and Laboratory Standards Institute (CLSI). Reference Method for Broth Dilution Antifungal Susceptibility Testing of Yeasts (M27, 4th edition). 4th ed. Clinical and Laboratory Standards Institute (CLSI); 2017.
- Clinical and Laboratory Standards Institute (CLSI). Reference Method for Broth Dilution Antifungal Susceptibility Testing of Filamentous Fungi (Approved Standard, M38, 3rd edition). Clinical and Laboratory Standards Institute (CLSI); 2017
- Oliveira DC, Lopes PG, Spader TB, et al. Antifungal susceptibilities of Sporothrix albicans, S. brasiliensis, and S. luriei of the S. schenckii complex identified in Brazil. J Clin Microbiol. 2011;49:3047-3049.
- Kauffman CA, Bustamante B, Chapman SW, et al. Clinical practice guidelines for the management of sporotrichosis: 2007 update by the Infectious Diseases Society of America. Clin Infect Dis. 2007;45:1255-1265.
- Thompson GR, Le T, Chindamporn A, et al. Global guideline for the diagnosis and management of the endemic mycoses: an initiative of the European Confederation of Medical Mycology in cooperation with the International Society for Human and Animal Mycology. Lancet Infect Dis. 2021;21:E364-E374.
- Francesconi G, Valle AC, Passos S, et al. Terbinafine (250 mg/day): an effective and safe treatment of cutaneous sporotrichosis. J Eur Acad Dermatol Venereol. 2009;23:1273-1276.
- Macedo PM, Lopes-Bezerra LM, Bernardes-Engemann AR, et al. New posology of potassium iodide for the treatment of cutaneous sporotrichosis: study of efficacy and safety in 102 patients. J Eur Acad Dermatol Venereol. 2015;29:719-724.
Approach to Diagnosing and Managing Sporotrichosis
Approach to Diagnosing and Managing Sporotrichosis
Practice Points
- Sporotrichosis is an implantation mycosis that is considered a neglected tropical disease warranting global advocacy to prevent infections and improve patient outcomes.
- Common diagnostic methods such as microscopy may have a low sensitivity for confirming sporotrichosis. Culture from lesional tissue or pus is considered the gold standard for diagnosis.
Dermoscopic Documentation of a No-see-um Bite
Dermoscopic Documentation of a No-see-um Bite
Biting midges, commonly known as no-see-ums, are true flies (order Diptera) and members of the Ceratopogonidae family. Regionally, they are known as punkies in the Northeast, pinyon gnats in the Southwest, moose flies in Canada, and sand gnats in Georgia, among other names.1 There are 6206 species found worldwide except for Antarctica.2 The 3 genera of greatest importance to human and livestock health in the United States are Culicoides, Leptoconops, and Forcipomyia.1 Forty-seven species of the genus Culicoides are known to be present in Florida.3 Species belonging to the genus Leptoconops also are present in coastal areas of southeast Florida as well as in the tropics, subtropics, and Caribbean.3 In the United States, biting midges primarily are a nuisance; the major medical issue associated with Culicoides insects are allergic reactions to their bites. Even though no-see-ums are not known to transmit disease in humans, they have an impact on other animal species in the United States as biting pests and vectors of disease-causing pathogens.1 Biting midges pose quite a nuisance for the proper enjoyment of outdoor spaces in the southeastern United States.
Characteristics
Morphologically, no-see-ums are gray flies measuring 1 to 3 mm in length (eFigure 1). Adults have 2 wings with distinctive patterns, large compound eyes, a thorax that extends slightly over the head, an abdomen with 9 segments, and antennae with 15 segments (eFigure 2).1,3,4 Females have modified mouth parts including mandibles that lacerate the skin during feeding, which is mainly on blood from vertebrate hosts (primarily mammals but also birds, reptiles, and amphibians).1,4 They also can feed on invertebrate hosts. Both male and female no-see-ums feed on nectar, but adult females require a blood meal to develop their eggs.2 Their life cycle progresses in stages from egg to larva to pupa to adult. Larval habitats include salt marshes, swamps, shores of streams and ponds, water-holding plants, rotting fruit, and saturated wood- and manure-enriched soil. Adults can live 2 to 7 weeks. They are weak fliers, particularly in windy conditions.1


In Florida, no-see-ums are more active during the rainy months of May to October but are active year-round in the southeastern United States and the Gulf Coast from Florida to West Texas. They are active throughout the United States in the warmer months of June and July.5 Their peak feeding activity occurs at dawn and dusk, but different species of biting midges such as Leptoconops and Culicoides also can feed during daylight hours and at night, respectively.1,6,7
Case Report
One of the authors (M.J.S.), a healthy 54-year-old man with no remarkable medical history or current use of medications, documented the natural progression of a no-see-um bite by sitting in an outdoor Florida space at 8:00



Clinical Manifestations
Although no-see-ums are not known to transmit disease in the United States, they are important biting pests that can affect tourism and prevent enjoyment of outdoor spaces and activities.2 The bite reactions on the host can range from wheal-like lesions to papules measuring 2 to 3 mm (at times with overlying vesicles) to nodules up to 1 cm in diameter.8 In our reported case, the small wheals disappeared within hours, but pruritic papules have been described to last from weeks to months. Published histopathologic correlation of biopsied indurated papules within 3 days of bite occurrence have revealed a superficial infiltrate composed of lymphocytes and histiocytes, while eosinophils were found in the deeper dermis and subcutaneous fat. Within 2 weeks, as the lesions aged, the infiltrate contained a smaller percentage of eosinophils and predominantly was present in only the superficial dermis.8 Delayed-type hypersensitivity reactions including pustules and bullous lesions also have been described.9,10 Host immune reaction to the saliva introduced during the bite dictates the severity of the response, and lesions may become secondarily infected due to scratching.11
Management Recommendations
Management consists of cleaning the bite site with soap and water to prevent infection, applying cold compresses or ice packs to relieve the intense itch, and avoiding scratching.11 Application of over-the-counter calamine lotion or hydrocortisone cream can relieve itch, and mid- to high-potency topical corticosteroids also can be prescribed for 1 to 2 weeks for more intense bite reactions in conjunction with oral antihistamines. Topical or oral antibiotics may be indicated if redness and swelling progress at the bite site or if breaks in the skin become secondarily infected.
Final Thoughts
Because of the wide-ranging habitats of no-see-ums, eradication programs using insecticides have been inefficient or environmentally suboptimal. Emptying all standing water in outdoor spaces will reduce the number of no-see-ums. Avoidance of the outdoors at dawn and dusk when no-see-ums are most active is helpful, as well as protecting exposed skin by wearing long-sleeved shirts and long pants when outside. Insect repellents containing DEET (N-N-diethyl-meta-toluamide) or picaridin can offer additional protection on the remaining exposed skin. Oil of lemon eucalyptus, or active compound p-menthane-3,8-diol, has been shown to be effective against no-see-ums. Use of DEET should be avoided in children younger than 2 years and p-menthane-3,8-diol in those younger than 3 years. Picaridin is safe for use in children.12 Citronella oil is ineffective. Installing window and patio screens with a mesh size less than 16 can prevent no-see-ums from passing through the netting but will restrict air flow.3 Turning off porch lights also is helpful, as no-see-ums are attracted to light sources.6 Since no-see-ums are weak flyers, setting ceiling or window fans at high speeds can minimize exposure; similarly, being outdoors on a windy day may decrease the likelihood of being bitten. Ultimately, the best remedy for a bite is to prevent them from happening.
- Hill CA, MacDonald JF. Biting midges: biology and public health risk. Purdue University. Published July 2013. Accessed September 3, 2025. http://extension.entm.purdue.edu/publichealth/insects/bitingmidge.html
- Borkent A, Dominiak P. Catalog of the biting midges of the world (Diptera: Ceratopogonidae). Zootaxa. 2020;4787:1-377.
- Connelly CR. Biting midges, no-see-ums Culicoides spp. (Insecta: Diptera: Ceratopogonidae). University of Florida publication #EENY 349. Published August 2, 2022. Accessed September 3, 2025. https://edis.ifas.ufl.edu/publication/IN626
- Mullen GR, Murphree CS. Biting midges (Ceratopogonidae). In: Mullen GR, Durden LA, eds. Medical and Veterinary Entomology. 3rd ed. Academic Press; 2019:213-236.
- Best Bee Brothers. No-see-um seasonality range map & season information. Published March 4, 2022. Accessed September 3, 2025. https://bestbeebrothers.com/blogs/blog/no-see-um-season
- Biology Insights. Is there a season for no see ums in Florida? Published August 28, 2025. Accessed September 16, 2025. https://biologyinsights.com/is-there-a-season-for-no-see-ums-in-florida/
- Burris S. Florida no see ums: how to navigate the woes of no see ums in Florida. The Bug Agenda. Published February 2, 2022. Accessed September 3, 2025. https://thebugagenda.com/no-see-ums-in-florida/
- Steffen C. Clinical and histopathologic correlation of midge bites. Arch Dermatol. 1981;117:785-787.
- Krakowski AC, Ho B. Arthropod assault from biting midges. J Pediatr. 2013;163:298.
- Maves RC, Reaves EJ, Martin GJ. Images in clinical tropical medicine: bullous leg lesions caused by Culicoides midges after travel in the Amazon basin. Am J Trop Med Hyg. 2010;83:447.
- Swank B. How long do no-see-ums live? Pest Source. Updated March 17, 2025. Accessed September 3, 2025. https://pestsource.com/no-see-um/lifespan/
- Nguyen QD, Vu MN, Herbert AA. Insect repellents: an updated review for the clinician. J Am Acad Dermatol. 2023;88:123-130.
Biting midges, commonly known as no-see-ums, are true flies (order Diptera) and members of the Ceratopogonidae family. Regionally, they are known as punkies in the Northeast, pinyon gnats in the Southwest, moose flies in Canada, and sand gnats in Georgia, among other names.1 There are 6206 species found worldwide except for Antarctica.2 The 3 genera of greatest importance to human and livestock health in the United States are Culicoides, Leptoconops, and Forcipomyia.1 Forty-seven species of the genus Culicoides are known to be present in Florida.3 Species belonging to the genus Leptoconops also are present in coastal areas of southeast Florida as well as in the tropics, subtropics, and Caribbean.3 In the United States, biting midges primarily are a nuisance; the major medical issue associated with Culicoides insects are allergic reactions to their bites. Even though no-see-ums are not known to transmit disease in humans, they have an impact on other animal species in the United States as biting pests and vectors of disease-causing pathogens.1 Biting midges pose quite a nuisance for the proper enjoyment of outdoor spaces in the southeastern United States.
Characteristics
Morphologically, no-see-ums are gray flies measuring 1 to 3 mm in length (eFigure 1). Adults have 2 wings with distinctive patterns, large compound eyes, a thorax that extends slightly over the head, an abdomen with 9 segments, and antennae with 15 segments (eFigure 2).1,3,4 Females have modified mouth parts including mandibles that lacerate the skin during feeding, which is mainly on blood from vertebrate hosts (primarily mammals but also birds, reptiles, and amphibians).1,4 They also can feed on invertebrate hosts. Both male and female no-see-ums feed on nectar, but adult females require a blood meal to develop their eggs.2 Their life cycle progresses in stages from egg to larva to pupa to adult. Larval habitats include salt marshes, swamps, shores of streams and ponds, water-holding plants, rotting fruit, and saturated wood- and manure-enriched soil. Adults can live 2 to 7 weeks. They are weak fliers, particularly in windy conditions.1


In Florida, no-see-ums are more active during the rainy months of May to October but are active year-round in the southeastern United States and the Gulf Coast from Florida to West Texas. They are active throughout the United States in the warmer months of June and July.5 Their peak feeding activity occurs at dawn and dusk, but different species of biting midges such as Leptoconops and Culicoides also can feed during daylight hours and at night, respectively.1,6,7
Case Report
One of the authors (M.J.S.), a healthy 54-year-old man with no remarkable medical history or current use of medications, documented the natural progression of a no-see-um bite by sitting in an outdoor Florida space at 8:00



Clinical Manifestations
Although no-see-ums are not known to transmit disease in the United States, they are important biting pests that can affect tourism and prevent enjoyment of outdoor spaces and activities.2 The bite reactions on the host can range from wheal-like lesions to papules measuring 2 to 3 mm (at times with overlying vesicles) to nodules up to 1 cm in diameter.8 In our reported case, the small wheals disappeared within hours, but pruritic papules have been described to last from weeks to months. Published histopathologic correlation of biopsied indurated papules within 3 days of bite occurrence have revealed a superficial infiltrate composed of lymphocytes and histiocytes, while eosinophils were found in the deeper dermis and subcutaneous fat. Within 2 weeks, as the lesions aged, the infiltrate contained a smaller percentage of eosinophils and predominantly was present in only the superficial dermis.8 Delayed-type hypersensitivity reactions including pustules and bullous lesions also have been described.9,10 Host immune reaction to the saliva introduced during the bite dictates the severity of the response, and lesions may become secondarily infected due to scratching.11
Management Recommendations
Management consists of cleaning the bite site with soap and water to prevent infection, applying cold compresses or ice packs to relieve the intense itch, and avoiding scratching.11 Application of over-the-counter calamine lotion or hydrocortisone cream can relieve itch, and mid- to high-potency topical corticosteroids also can be prescribed for 1 to 2 weeks for more intense bite reactions in conjunction with oral antihistamines. Topical or oral antibiotics may be indicated if redness and swelling progress at the bite site or if breaks in the skin become secondarily infected.
Final Thoughts
Because of the wide-ranging habitats of no-see-ums, eradication programs using insecticides have been inefficient or environmentally suboptimal. Emptying all standing water in outdoor spaces will reduce the number of no-see-ums. Avoidance of the outdoors at dawn and dusk when no-see-ums are most active is helpful, as well as protecting exposed skin by wearing long-sleeved shirts and long pants when outside. Insect repellents containing DEET (N-N-diethyl-meta-toluamide) or picaridin can offer additional protection on the remaining exposed skin. Oil of lemon eucalyptus, or active compound p-menthane-3,8-diol, has been shown to be effective against no-see-ums. Use of DEET should be avoided in children younger than 2 years and p-menthane-3,8-diol in those younger than 3 years. Picaridin is safe for use in children.12 Citronella oil is ineffective. Installing window and patio screens with a mesh size less than 16 can prevent no-see-ums from passing through the netting but will restrict air flow.3 Turning off porch lights also is helpful, as no-see-ums are attracted to light sources.6 Since no-see-ums are weak flyers, setting ceiling or window fans at high speeds can minimize exposure; similarly, being outdoors on a windy day may decrease the likelihood of being bitten. Ultimately, the best remedy for a bite is to prevent them from happening.
Biting midges, commonly known as no-see-ums, are true flies (order Diptera) and members of the Ceratopogonidae family. Regionally, they are known as punkies in the Northeast, pinyon gnats in the Southwest, moose flies in Canada, and sand gnats in Georgia, among other names.1 There are 6206 species found worldwide except for Antarctica.2 The 3 genera of greatest importance to human and livestock health in the United States are Culicoides, Leptoconops, and Forcipomyia.1 Forty-seven species of the genus Culicoides are known to be present in Florida.3 Species belonging to the genus Leptoconops also are present in coastal areas of southeast Florida as well as in the tropics, subtropics, and Caribbean.3 In the United States, biting midges primarily are a nuisance; the major medical issue associated with Culicoides insects are allergic reactions to their bites. Even though no-see-ums are not known to transmit disease in humans, they have an impact on other animal species in the United States as biting pests and vectors of disease-causing pathogens.1 Biting midges pose quite a nuisance for the proper enjoyment of outdoor spaces in the southeastern United States.
Characteristics
Morphologically, no-see-ums are gray flies measuring 1 to 3 mm in length (eFigure 1). Adults have 2 wings with distinctive patterns, large compound eyes, a thorax that extends slightly over the head, an abdomen with 9 segments, and antennae with 15 segments (eFigure 2).1,3,4 Females have modified mouth parts including mandibles that lacerate the skin during feeding, which is mainly on blood from vertebrate hosts (primarily mammals but also birds, reptiles, and amphibians).1,4 They also can feed on invertebrate hosts. Both male and female no-see-ums feed on nectar, but adult females require a blood meal to develop their eggs.2 Their life cycle progresses in stages from egg to larva to pupa to adult. Larval habitats include salt marshes, swamps, shores of streams and ponds, water-holding plants, rotting fruit, and saturated wood- and manure-enriched soil. Adults can live 2 to 7 weeks. They are weak fliers, particularly in windy conditions.1


In Florida, no-see-ums are more active during the rainy months of May to October but are active year-round in the southeastern United States and the Gulf Coast from Florida to West Texas. They are active throughout the United States in the warmer months of June and July.5 Their peak feeding activity occurs at dawn and dusk, but different species of biting midges such as Leptoconops and Culicoides also can feed during daylight hours and at night, respectively.1,6,7
Case Report
One of the authors (M.J.S.), a healthy 54-year-old man with no remarkable medical history or current use of medications, documented the natural progression of a no-see-um bite by sitting in an outdoor Florida space at 8:00



Clinical Manifestations
Although no-see-ums are not known to transmit disease in the United States, they are important biting pests that can affect tourism and prevent enjoyment of outdoor spaces and activities.2 The bite reactions on the host can range from wheal-like lesions to papules measuring 2 to 3 mm (at times with overlying vesicles) to nodules up to 1 cm in diameter.8 In our reported case, the small wheals disappeared within hours, but pruritic papules have been described to last from weeks to months. Published histopathologic correlation of biopsied indurated papules within 3 days of bite occurrence have revealed a superficial infiltrate composed of lymphocytes and histiocytes, while eosinophils were found in the deeper dermis and subcutaneous fat. Within 2 weeks, as the lesions aged, the infiltrate contained a smaller percentage of eosinophils and predominantly was present in only the superficial dermis.8 Delayed-type hypersensitivity reactions including pustules and bullous lesions also have been described.9,10 Host immune reaction to the saliva introduced during the bite dictates the severity of the response, and lesions may become secondarily infected due to scratching.11
Management Recommendations
Management consists of cleaning the bite site with soap and water to prevent infection, applying cold compresses or ice packs to relieve the intense itch, and avoiding scratching.11 Application of over-the-counter calamine lotion or hydrocortisone cream can relieve itch, and mid- to high-potency topical corticosteroids also can be prescribed for 1 to 2 weeks for more intense bite reactions in conjunction with oral antihistamines. Topical or oral antibiotics may be indicated if redness and swelling progress at the bite site or if breaks in the skin become secondarily infected.
Final Thoughts
Because of the wide-ranging habitats of no-see-ums, eradication programs using insecticides have been inefficient or environmentally suboptimal. Emptying all standing water in outdoor spaces will reduce the number of no-see-ums. Avoidance of the outdoors at dawn and dusk when no-see-ums are most active is helpful, as well as protecting exposed skin by wearing long-sleeved shirts and long pants when outside. Insect repellents containing DEET (N-N-diethyl-meta-toluamide) or picaridin can offer additional protection on the remaining exposed skin. Oil of lemon eucalyptus, or active compound p-menthane-3,8-diol, has been shown to be effective against no-see-ums. Use of DEET should be avoided in children younger than 2 years and p-menthane-3,8-diol in those younger than 3 years. Picaridin is safe for use in children.12 Citronella oil is ineffective. Installing window and patio screens with a mesh size less than 16 can prevent no-see-ums from passing through the netting but will restrict air flow.3 Turning off porch lights also is helpful, as no-see-ums are attracted to light sources.6 Since no-see-ums are weak flyers, setting ceiling or window fans at high speeds can minimize exposure; similarly, being outdoors on a windy day may decrease the likelihood of being bitten. Ultimately, the best remedy for a bite is to prevent them from happening.
- Hill CA, MacDonald JF. Biting midges: biology and public health risk. Purdue University. Published July 2013. Accessed September 3, 2025. http://extension.entm.purdue.edu/publichealth/insects/bitingmidge.html
- Borkent A, Dominiak P. Catalog of the biting midges of the world (Diptera: Ceratopogonidae). Zootaxa. 2020;4787:1-377.
- Connelly CR. Biting midges, no-see-ums Culicoides spp. (Insecta: Diptera: Ceratopogonidae). University of Florida publication #EENY 349. Published August 2, 2022. Accessed September 3, 2025. https://edis.ifas.ufl.edu/publication/IN626
- Mullen GR, Murphree CS. Biting midges (Ceratopogonidae). In: Mullen GR, Durden LA, eds. Medical and Veterinary Entomology. 3rd ed. Academic Press; 2019:213-236.
- Best Bee Brothers. No-see-um seasonality range map & season information. Published March 4, 2022. Accessed September 3, 2025. https://bestbeebrothers.com/blogs/blog/no-see-um-season
- Biology Insights. Is there a season for no see ums in Florida? Published August 28, 2025. Accessed September 16, 2025. https://biologyinsights.com/is-there-a-season-for-no-see-ums-in-florida/
- Burris S. Florida no see ums: how to navigate the woes of no see ums in Florida. The Bug Agenda. Published February 2, 2022. Accessed September 3, 2025. https://thebugagenda.com/no-see-ums-in-florida/
- Steffen C. Clinical and histopathologic correlation of midge bites. Arch Dermatol. 1981;117:785-787.
- Krakowski AC, Ho B. Arthropod assault from biting midges. J Pediatr. 2013;163:298.
- Maves RC, Reaves EJ, Martin GJ. Images in clinical tropical medicine: bullous leg lesions caused by Culicoides midges after travel in the Amazon basin. Am J Trop Med Hyg. 2010;83:447.
- Swank B. How long do no-see-ums live? Pest Source. Updated March 17, 2025. Accessed September 3, 2025. https://pestsource.com/no-see-um/lifespan/
- Nguyen QD, Vu MN, Herbert AA. Insect repellents: an updated review for the clinician. J Am Acad Dermatol. 2023;88:123-130.
- Hill CA, MacDonald JF. Biting midges: biology and public health risk. Purdue University. Published July 2013. Accessed September 3, 2025. http://extension.entm.purdue.edu/publichealth/insects/bitingmidge.html
- Borkent A, Dominiak P. Catalog of the biting midges of the world (Diptera: Ceratopogonidae). Zootaxa. 2020;4787:1-377.
- Connelly CR. Biting midges, no-see-ums Culicoides spp. (Insecta: Diptera: Ceratopogonidae). University of Florida publication #EENY 349. Published August 2, 2022. Accessed September 3, 2025. https://edis.ifas.ufl.edu/publication/IN626
- Mullen GR, Murphree CS. Biting midges (Ceratopogonidae). In: Mullen GR, Durden LA, eds. Medical and Veterinary Entomology. 3rd ed. Academic Press; 2019:213-236.
- Best Bee Brothers. No-see-um seasonality range map & season information. Published March 4, 2022. Accessed September 3, 2025. https://bestbeebrothers.com/blogs/blog/no-see-um-season
- Biology Insights. Is there a season for no see ums in Florida? Published August 28, 2025. Accessed September 16, 2025. https://biologyinsights.com/is-there-a-season-for-no-see-ums-in-florida/
- Burris S. Florida no see ums: how to navigate the woes of no see ums in Florida. The Bug Agenda. Published February 2, 2022. Accessed September 3, 2025. https://thebugagenda.com/no-see-ums-in-florida/
- Steffen C. Clinical and histopathologic correlation of midge bites. Arch Dermatol. 1981;117:785-787.
- Krakowski AC, Ho B. Arthropod assault from biting midges. J Pediatr. 2013;163:298.
- Maves RC, Reaves EJ, Martin GJ. Images in clinical tropical medicine: bullous leg lesions caused by Culicoides midges after travel in the Amazon basin. Am J Trop Med Hyg. 2010;83:447.
- Swank B. How long do no-see-ums live? Pest Source. Updated March 17, 2025. Accessed September 3, 2025. https://pestsource.com/no-see-um/lifespan/
- Nguyen QD, Vu MN, Herbert AA. Insect repellents: an updated review for the clinician. J Am Acad Dermatol. 2023;88:123-130.
Dermoscopic Documentation of a No-see-um Bite
Dermoscopic Documentation of a No-see-um Bite
Practice Points
- Biting midges, commonly known as no-see-ums, are extremely small flies whose bites can cause a burning sensation, mild pain, and reactions ranging from small wheals to intensely pruritic papules.
- Medical management of no-see-um bites is based on the severity of the skin reaction.
Hyperpigmented Macules Caused by Burrowing Bugs (Cydnidae) May Mimic More Serious Conditions
Hyperpigmented Macules Caused by Burrowing Bugs (Cydnidae) May Mimic More Serious Conditions
Cydnidae is a family of small to medium-sized shield bugs with spiny legs that commonly are known as burrowing bugs (or burrower bugs). The family Cydnidae includes more than 100 genera and approximately 600 species worldwide.1 These insects are arthropods of the order Hemiptera (suborder: Heteroptera; superfamily: Pentatomoidae) and largely are concentrated in tropical and temperate regions. Approximately 145 species have been recorded in the Neotropical Region and have been included in the subfamilies Amnestinae, Cephalocteinae, and Sehirinae, in addition to Cydnidae.2 Burrowing bugs are ovoid in shape and 2 to 20 mm in length and morphologically are well adapted for burrowing. Their life span is 100 to 300 days. Being phytophagous, they burrow to feed on plants and roots. Adult burrowing bugs have wings and can fly. They have specialized glands located in either the abdomen (nymph) or thorax (adult) that secrete odorous chemicals for self-protection.3 The secretions contain hydrocarbonates that function as repellents and danger signals, can cause paralysis in prey, and act as a chemoattractant for mates.4-6 They also cause hyperpigmentation upon contact with the skin.
In this article, we present a series of cases from the same community to demonstrate the characteristic features of hyperpigmented macules caused by exposure to burrowing bugs. Dermatologists should be aware of this entity to prevent misdiagnosis and unnecessary investigations and treatment.
Case Series
A 36-year-old woman and 6 children (age range, 6-12 years) presented with a widespread, acute, brown-pigmented, macular eruption with lesions that increased in number over a 1-week period. All 7 patients resided in the same locality and were otherwise systemically healthy. Initially, the index case, a 7-year-old girl, was referred to our tertiary care center by a dermatologist with a provisional diagnosis of idiopathic macular eruptive pigmentation. The patient’s mother recalled noticing a tiny black insect on the child's scalp that left pigment on the skin when she crushed it between her fingers. The rest of the patients presented over the next few days: 3 of the children belonged to the same household as the index case, and there was history of all 6 children playing in the neighborhood park during late evening hours. The adult patient was the parent of one of the affected children. The lesions were associated with mild itching and tingling in 3 children but were asymptomatic in the other patients.
Clinical examination of the patients revealed multiple dark- to light-brown, discrete, irregularly shaped macules over the trunk, arms, and soles (eFigure 1). Dermoscopic examination of a pigmented macule showed an irregularly shaped, brownish, structureless area with accentuation of the pigment at skin creases and perieccrine pigmentation (eFigure 2). The pigmentation was unaffected by rubbing with alcohol or water. Clinicoepidemiologic parameters of the patients are summarized in the eTable.



One of the children’s parents conducted a geological examination of the ground in the neighborhood park during evening hours and found tiny burrowing bugs (eFigure 3). When crushed between the fingers, these insects left a similar brownish hyperpigmentation on the skin. The parents were counseled on the nature of the eruption, and the patients were kept under observation for 2 weeks. On follow-up after 5 days, the lesions showed markedly decreased intensity of hyperpigmentation, and no new lesions were observed in any of the 7 patients.

Comment
Pentatomoidae insects generally are benign and harmless to humans. There have been isolated reports of erythematous plaques caused by Antiteuchus mixtus and Edessa maculate.7 Malhotra et al8 reported the first known series of cases with Cydnidae insect–induced hyperpigmented macules. The reported patients presented with asymptomatic, brown, hyperpigmented macules over exposed sites such as the feet, neck, and chest. All the cases occurred during the monsoon season in tropical and temperate regions of the world, and the patients were characteristically clustered in similar geographic areas. The causative insect was identified as Chilocoris assmuthi Breddin, 1904, belonging to the family Cydnidae. When it was crushed between the fingers, the skin became hyperpigmented, confirming the role of the secretions from the insect in the etiology.8
A second case was described by Sonthalia,9 who also described the dermoscopic features of hyperpigmented macules caused by burrowing bugs. The lesions showed a stuck-on, clustered appearance of ovoid and bizarre pigmented clods, globules, and granules.9 Although the lesions occur mainly over exposed sites, pigmented macules occurring over unusual sites such as the abdomen and back also have been reported in association with burrowing bugs.10 Characteristically, the lesions initially are faint and darken with time and usually fade within a week. They can be rubbed off with acetone but persist when washed with soap and water. The fleeting nature of the pigmentation also has led to the term transient pseudo-lentigines sign to describe hyperpigmentation caused by burrowing bugs.11
Soil and plants are burrowing bugs’ natural habitats, and the insects typically are seen in vegetation-rich, moist areas adjoining human dwellings (eg, parks, gardens), where clusters of cases can occur. These insects proliferate during the monsoon season in tropical and temperate areas, leading to more cases occurring during these months.
Compared to prior reports,8,9 a few of our patients had predominant trunk and neck involvement with an occasional tingling sensation or pruritus while the rest were asymptomatic. Dermoscopic features from our patients shared similar reported features of Cydnidae pigmentation.4,5 The accentuation of pigment over skin creases seen on dermoscopy was due to accumulation of Cydnidae secretion at these sites.
The differential diagnosis commonly includes idiopathic macular eruptive pigmentation, which is characterized by an asymptomatic progressive eruption of hyperpigmented macules over the trunk that persists from a few months up to 3 years. Other conditions in the differential include benign conditions such as acral benign melanocytic nevi, lentigines, pigmented purpuric dermatosis, and postinflammatory hyperpigmentation, as well as malignant conditions such as acral melanoma. Dermoscopy is a helpful, easy-to-use tool in differentiating these pigmentation disorders, obviating the need for an invasive investigation such as histopathologic analysis. Simultaneous involvement in a group of people living together or visiting the same place, abrupt onset, predominant involvement of the exposed sites, characteristic clinical and dermoscopic features, self-limiting course, and timing with the monsoon season should suggest a possibility of Cydnidae dermatitis/pigmentation, which can be confirmed by finding the causative bug in the affected locality.
Management
No specific treatment is required for the pigmentation caused by Cydnidae, as it is self-resolving. The macules can, however, be removed with acetone. Patients must be counseled regarding the benign and fleeting nature of this condition, as the abrupt onset may alarm them of a systemic disease. Affected patients should be advised against walking barefoot in areas where the insects can be found. Spraying insecticides in the affected locality also helps to reduce the presence of burrowing bugs.
- Hosokawa T, Kikuchi Y, Nikoh N, et al. Polyphyly of gut symbionts in stinkbugs of the family Cydnidae. Appl Environ Microbiol. 2012; 78:4758-4761.
- Schwertner CF, Nardi C. Burrower bugs (Cydnidae). In: Panizzi A, Grazia J, eds. True Bugs (Heteroptera) of the Neotropics. Entomology in Focus, vol 2. Springer; 2015.
- Lis JA. Burrower bugs of the Old World: a catalogue (Hemiptera: Heteroptera: Cydnidae). Genus (Wroclaw). 1999;10:165-249.
- Hayashi N, Yamamura Y, Ôhama S, et al. Defensive substances from stink bugs of Cydnidae. Experientia. 1976;32:418-419.
- Smith RM. The defensive secretion of the bugs Lampropharadifasciata, Adrisanumeensis, and Tectocorisdiophthalmus from Fiji. NZ J Zool. 1978;5:821-822.
- Krall BS, Zilkowski BW, Kight SL, et al. Chemistry and defensive efficacy of secretion of burrowing bugs. J Chem Ecol. 1997;23:1951-1962.
- Haddad V Jr, Cardoso J, Moraes R. Skin lesions caused by stink bugs (Insecta: Heteroptera: Pentatomidae): first report of dermatological injuries in humans. Wilderness Environ Med. 2002;13:48-50.
- Malhotra AK, Lis JA, Ramam M. Cydnidae (burrowing bug) pigmentation: a novel arthropod dermatosis. JAMA Dermatol. 2015;151:232-233.
- Sonthalia S. Dermoscopy of Cydnidae pigmentation: a novel disorder of pigmentation. Dermatol Pract Concept. 2019;9:228-229.
- Poojary S, Baddireddy K. Demystifying the stinking reddish brown stains through the dermoscope: Cydnidae pigmentation. Indian Dermatol Online J. 2019;10:757-758.
- Amrani A, Das A. Cydnidae pigmentation: unusual location on the abdomen and back. Br J Dermatol. 2021;184:E125.
Cydnidae is a family of small to medium-sized shield bugs with spiny legs that commonly are known as burrowing bugs (or burrower bugs). The family Cydnidae includes more than 100 genera and approximately 600 species worldwide.1 These insects are arthropods of the order Hemiptera (suborder: Heteroptera; superfamily: Pentatomoidae) and largely are concentrated in tropical and temperate regions. Approximately 145 species have been recorded in the Neotropical Region and have been included in the subfamilies Amnestinae, Cephalocteinae, and Sehirinae, in addition to Cydnidae.2 Burrowing bugs are ovoid in shape and 2 to 20 mm in length and morphologically are well adapted for burrowing. Their life span is 100 to 300 days. Being phytophagous, they burrow to feed on plants and roots. Adult burrowing bugs have wings and can fly. They have specialized glands located in either the abdomen (nymph) or thorax (adult) that secrete odorous chemicals for self-protection.3 The secretions contain hydrocarbonates that function as repellents and danger signals, can cause paralysis in prey, and act as a chemoattractant for mates.4-6 They also cause hyperpigmentation upon contact with the skin.
In this article, we present a series of cases from the same community to demonstrate the characteristic features of hyperpigmented macules caused by exposure to burrowing bugs. Dermatologists should be aware of this entity to prevent misdiagnosis and unnecessary investigations and treatment.
Case Series
A 36-year-old woman and 6 children (age range, 6-12 years) presented with a widespread, acute, brown-pigmented, macular eruption with lesions that increased in number over a 1-week period. All 7 patients resided in the same locality and were otherwise systemically healthy. Initially, the index case, a 7-year-old girl, was referred to our tertiary care center by a dermatologist with a provisional diagnosis of idiopathic macular eruptive pigmentation. The patient’s mother recalled noticing a tiny black insect on the child's scalp that left pigment on the skin when she crushed it between her fingers. The rest of the patients presented over the next few days: 3 of the children belonged to the same household as the index case, and there was history of all 6 children playing in the neighborhood park during late evening hours. The adult patient was the parent of one of the affected children. The lesions were associated with mild itching and tingling in 3 children but were asymptomatic in the other patients.
Clinical examination of the patients revealed multiple dark- to light-brown, discrete, irregularly shaped macules over the trunk, arms, and soles (eFigure 1). Dermoscopic examination of a pigmented macule showed an irregularly shaped, brownish, structureless area with accentuation of the pigment at skin creases and perieccrine pigmentation (eFigure 2). The pigmentation was unaffected by rubbing with alcohol or water. Clinicoepidemiologic parameters of the patients are summarized in the eTable.



One of the children’s parents conducted a geological examination of the ground in the neighborhood park during evening hours and found tiny burrowing bugs (eFigure 3). When crushed between the fingers, these insects left a similar brownish hyperpigmentation on the skin. The parents were counseled on the nature of the eruption, and the patients were kept under observation for 2 weeks. On follow-up after 5 days, the lesions showed markedly decreased intensity of hyperpigmentation, and no new lesions were observed in any of the 7 patients.

Comment
Pentatomoidae insects generally are benign and harmless to humans. There have been isolated reports of erythematous plaques caused by Antiteuchus mixtus and Edessa maculate.7 Malhotra et al8 reported the first known series of cases with Cydnidae insect–induced hyperpigmented macules. The reported patients presented with asymptomatic, brown, hyperpigmented macules over exposed sites such as the feet, neck, and chest. All the cases occurred during the monsoon season in tropical and temperate regions of the world, and the patients were characteristically clustered in similar geographic areas. The causative insect was identified as Chilocoris assmuthi Breddin, 1904, belonging to the family Cydnidae. When it was crushed between the fingers, the skin became hyperpigmented, confirming the role of the secretions from the insect in the etiology.8
A second case was described by Sonthalia,9 who also described the dermoscopic features of hyperpigmented macules caused by burrowing bugs. The lesions showed a stuck-on, clustered appearance of ovoid and bizarre pigmented clods, globules, and granules.9 Although the lesions occur mainly over exposed sites, pigmented macules occurring over unusual sites such as the abdomen and back also have been reported in association with burrowing bugs.10 Characteristically, the lesions initially are faint and darken with time and usually fade within a week. They can be rubbed off with acetone but persist when washed with soap and water. The fleeting nature of the pigmentation also has led to the term transient pseudo-lentigines sign to describe hyperpigmentation caused by burrowing bugs.11
Soil and plants are burrowing bugs’ natural habitats, and the insects typically are seen in vegetation-rich, moist areas adjoining human dwellings (eg, parks, gardens), where clusters of cases can occur. These insects proliferate during the monsoon season in tropical and temperate areas, leading to more cases occurring during these months.
Compared to prior reports,8,9 a few of our patients had predominant trunk and neck involvement with an occasional tingling sensation or pruritus while the rest were asymptomatic. Dermoscopic features from our patients shared similar reported features of Cydnidae pigmentation.4,5 The accentuation of pigment over skin creases seen on dermoscopy was due to accumulation of Cydnidae secretion at these sites.
The differential diagnosis commonly includes idiopathic macular eruptive pigmentation, which is characterized by an asymptomatic progressive eruption of hyperpigmented macules over the trunk that persists from a few months up to 3 years. Other conditions in the differential include benign conditions such as acral benign melanocytic nevi, lentigines, pigmented purpuric dermatosis, and postinflammatory hyperpigmentation, as well as malignant conditions such as acral melanoma. Dermoscopy is a helpful, easy-to-use tool in differentiating these pigmentation disorders, obviating the need for an invasive investigation such as histopathologic analysis. Simultaneous involvement in a group of people living together or visiting the same place, abrupt onset, predominant involvement of the exposed sites, characteristic clinical and dermoscopic features, self-limiting course, and timing with the monsoon season should suggest a possibility of Cydnidae dermatitis/pigmentation, which can be confirmed by finding the causative bug in the affected locality.
Management
No specific treatment is required for the pigmentation caused by Cydnidae, as it is self-resolving. The macules can, however, be removed with acetone. Patients must be counseled regarding the benign and fleeting nature of this condition, as the abrupt onset may alarm them of a systemic disease. Affected patients should be advised against walking barefoot in areas where the insects can be found. Spraying insecticides in the affected locality also helps to reduce the presence of burrowing bugs.
Cydnidae is a family of small to medium-sized shield bugs with spiny legs that commonly are known as burrowing bugs (or burrower bugs). The family Cydnidae includes more than 100 genera and approximately 600 species worldwide.1 These insects are arthropods of the order Hemiptera (suborder: Heteroptera; superfamily: Pentatomoidae) and largely are concentrated in tropical and temperate regions. Approximately 145 species have been recorded in the Neotropical Region and have been included in the subfamilies Amnestinae, Cephalocteinae, and Sehirinae, in addition to Cydnidae.2 Burrowing bugs are ovoid in shape and 2 to 20 mm in length and morphologically are well adapted for burrowing. Their life span is 100 to 300 days. Being phytophagous, they burrow to feed on plants and roots. Adult burrowing bugs have wings and can fly. They have specialized glands located in either the abdomen (nymph) or thorax (adult) that secrete odorous chemicals for self-protection.3 The secretions contain hydrocarbonates that function as repellents and danger signals, can cause paralysis in prey, and act as a chemoattractant for mates.4-6 They also cause hyperpigmentation upon contact with the skin.
In this article, we present a series of cases from the same community to demonstrate the characteristic features of hyperpigmented macules caused by exposure to burrowing bugs. Dermatologists should be aware of this entity to prevent misdiagnosis and unnecessary investigations and treatment.
Case Series
A 36-year-old woman and 6 children (age range, 6-12 years) presented with a widespread, acute, brown-pigmented, macular eruption with lesions that increased in number over a 1-week period. All 7 patients resided in the same locality and were otherwise systemically healthy. Initially, the index case, a 7-year-old girl, was referred to our tertiary care center by a dermatologist with a provisional diagnosis of idiopathic macular eruptive pigmentation. The patient’s mother recalled noticing a tiny black insect on the child's scalp that left pigment on the skin when she crushed it between her fingers. The rest of the patients presented over the next few days: 3 of the children belonged to the same household as the index case, and there was history of all 6 children playing in the neighborhood park during late evening hours. The adult patient was the parent of one of the affected children. The lesions were associated with mild itching and tingling in 3 children but were asymptomatic in the other patients.
Clinical examination of the patients revealed multiple dark- to light-brown, discrete, irregularly shaped macules over the trunk, arms, and soles (eFigure 1). Dermoscopic examination of a pigmented macule showed an irregularly shaped, brownish, structureless area with accentuation of the pigment at skin creases and perieccrine pigmentation (eFigure 2). The pigmentation was unaffected by rubbing with alcohol or water. Clinicoepidemiologic parameters of the patients are summarized in the eTable.



One of the children’s parents conducted a geological examination of the ground in the neighborhood park during evening hours and found tiny burrowing bugs (eFigure 3). When crushed between the fingers, these insects left a similar brownish hyperpigmentation on the skin. The parents were counseled on the nature of the eruption, and the patients were kept under observation for 2 weeks. On follow-up after 5 days, the lesions showed markedly decreased intensity of hyperpigmentation, and no new lesions were observed in any of the 7 patients.

Comment
Pentatomoidae insects generally are benign and harmless to humans. There have been isolated reports of erythematous plaques caused by Antiteuchus mixtus and Edessa maculate.7 Malhotra et al8 reported the first known series of cases with Cydnidae insect–induced hyperpigmented macules. The reported patients presented with asymptomatic, brown, hyperpigmented macules over exposed sites such as the feet, neck, and chest. All the cases occurred during the monsoon season in tropical and temperate regions of the world, and the patients were characteristically clustered in similar geographic areas. The causative insect was identified as Chilocoris assmuthi Breddin, 1904, belonging to the family Cydnidae. When it was crushed between the fingers, the skin became hyperpigmented, confirming the role of the secretions from the insect in the etiology.8
A second case was described by Sonthalia,9 who also described the dermoscopic features of hyperpigmented macules caused by burrowing bugs. The lesions showed a stuck-on, clustered appearance of ovoid and bizarre pigmented clods, globules, and granules.9 Although the lesions occur mainly over exposed sites, pigmented macules occurring over unusual sites such as the abdomen and back also have been reported in association with burrowing bugs.10 Characteristically, the lesions initially are faint and darken with time and usually fade within a week. They can be rubbed off with acetone but persist when washed with soap and water. The fleeting nature of the pigmentation also has led to the term transient pseudo-lentigines sign to describe hyperpigmentation caused by burrowing bugs.11
Soil and plants are burrowing bugs’ natural habitats, and the insects typically are seen in vegetation-rich, moist areas adjoining human dwellings (eg, parks, gardens), where clusters of cases can occur. These insects proliferate during the monsoon season in tropical and temperate areas, leading to more cases occurring during these months.
Compared to prior reports,8,9 a few of our patients had predominant trunk and neck involvement with an occasional tingling sensation or pruritus while the rest were asymptomatic. Dermoscopic features from our patients shared similar reported features of Cydnidae pigmentation.4,5 The accentuation of pigment over skin creases seen on dermoscopy was due to accumulation of Cydnidae secretion at these sites.
The differential diagnosis commonly includes idiopathic macular eruptive pigmentation, which is characterized by an asymptomatic progressive eruption of hyperpigmented macules over the trunk that persists from a few months up to 3 years. Other conditions in the differential include benign conditions such as acral benign melanocytic nevi, lentigines, pigmented purpuric dermatosis, and postinflammatory hyperpigmentation, as well as malignant conditions such as acral melanoma. Dermoscopy is a helpful, easy-to-use tool in differentiating these pigmentation disorders, obviating the need for an invasive investigation such as histopathologic analysis. Simultaneous involvement in a group of people living together or visiting the same place, abrupt onset, predominant involvement of the exposed sites, characteristic clinical and dermoscopic features, self-limiting course, and timing with the monsoon season should suggest a possibility of Cydnidae dermatitis/pigmentation, which can be confirmed by finding the causative bug in the affected locality.
Management
No specific treatment is required for the pigmentation caused by Cydnidae, as it is self-resolving. The macules can, however, be removed with acetone. Patients must be counseled regarding the benign and fleeting nature of this condition, as the abrupt onset may alarm them of a systemic disease. Affected patients should be advised against walking barefoot in areas where the insects can be found. Spraying insecticides in the affected locality also helps to reduce the presence of burrowing bugs.
- Hosokawa T, Kikuchi Y, Nikoh N, et al. Polyphyly of gut symbionts in stinkbugs of the family Cydnidae. Appl Environ Microbiol. 2012; 78:4758-4761.
- Schwertner CF, Nardi C. Burrower bugs (Cydnidae). In: Panizzi A, Grazia J, eds. True Bugs (Heteroptera) of the Neotropics. Entomology in Focus, vol 2. Springer; 2015.
- Lis JA. Burrower bugs of the Old World: a catalogue (Hemiptera: Heteroptera: Cydnidae). Genus (Wroclaw). 1999;10:165-249.
- Hayashi N, Yamamura Y, Ôhama S, et al. Defensive substances from stink bugs of Cydnidae. Experientia. 1976;32:418-419.
- Smith RM. The defensive secretion of the bugs Lampropharadifasciata, Adrisanumeensis, and Tectocorisdiophthalmus from Fiji. NZ J Zool. 1978;5:821-822.
- Krall BS, Zilkowski BW, Kight SL, et al. Chemistry and defensive efficacy of secretion of burrowing bugs. J Chem Ecol. 1997;23:1951-1962.
- Haddad V Jr, Cardoso J, Moraes R. Skin lesions caused by stink bugs (Insecta: Heteroptera: Pentatomidae): first report of dermatological injuries in humans. Wilderness Environ Med. 2002;13:48-50.
- Malhotra AK, Lis JA, Ramam M. Cydnidae (burrowing bug) pigmentation: a novel arthropod dermatosis. JAMA Dermatol. 2015;151:232-233.
- Sonthalia S. Dermoscopy of Cydnidae pigmentation: a novel disorder of pigmentation. Dermatol Pract Concept. 2019;9:228-229.
- Poojary S, Baddireddy K. Demystifying the stinking reddish brown stains through the dermoscope: Cydnidae pigmentation. Indian Dermatol Online J. 2019;10:757-758.
- Amrani A, Das A. Cydnidae pigmentation: unusual location on the abdomen and back. Br J Dermatol. 2021;184:E125.
- Hosokawa T, Kikuchi Y, Nikoh N, et al. Polyphyly of gut symbionts in stinkbugs of the family Cydnidae. Appl Environ Microbiol. 2012; 78:4758-4761.
- Schwertner CF, Nardi C. Burrower bugs (Cydnidae). In: Panizzi A, Grazia J, eds. True Bugs (Heteroptera) of the Neotropics. Entomology in Focus, vol 2. Springer; 2015.
- Lis JA. Burrower bugs of the Old World: a catalogue (Hemiptera: Heteroptera: Cydnidae). Genus (Wroclaw). 1999;10:165-249.
- Hayashi N, Yamamura Y, Ôhama S, et al. Defensive substances from stink bugs of Cydnidae. Experientia. 1976;32:418-419.
- Smith RM. The defensive secretion of the bugs Lampropharadifasciata, Adrisanumeensis, and Tectocorisdiophthalmus from Fiji. NZ J Zool. 1978;5:821-822.
- Krall BS, Zilkowski BW, Kight SL, et al. Chemistry and defensive efficacy of secretion of burrowing bugs. J Chem Ecol. 1997;23:1951-1962.
- Haddad V Jr, Cardoso J, Moraes R. Skin lesions caused by stink bugs (Insecta: Heteroptera: Pentatomidae): first report of dermatological injuries in humans. Wilderness Environ Med. 2002;13:48-50.
- Malhotra AK, Lis JA, Ramam M. Cydnidae (burrowing bug) pigmentation: a novel arthropod dermatosis. JAMA Dermatol. 2015;151:232-233.
- Sonthalia S. Dermoscopy of Cydnidae pigmentation: a novel disorder of pigmentation. Dermatol Pract Concept. 2019;9:228-229.
- Poojary S, Baddireddy K. Demystifying the stinking reddish brown stains through the dermoscope: Cydnidae pigmentation. Indian Dermatol Online J. 2019;10:757-758.
- Amrani A, Das A. Cydnidae pigmentation: unusual location on the abdomen and back. Br J Dermatol. 2021;184:E125.
Hyperpigmented Macules Caused by Burrowing Bugs (Cydnidae) May Mimic More Serious Conditions
Hyperpigmented Macules Caused by Burrowing Bugs (Cydnidae) May Mimic More Serious Conditions
Practice Points
- Burrowing bugs (Cydnidae) are phytophagous and burrow to feed on plants and roots. They are more numerous during the monsoon season in tropical and temperate regions.
- Secretions from burrowing bugs cause asymptomatic, hyperpigmented, irregularly shaped macules suggestive of an exogenous cause that commonly affect clusters of patients from the same geographic locality.
- The lesions are self-limiting and must be differentiated from close mimickers to ensure adequate and appropriate patient counseling.
Approach to Diagnosing and Managing Implantation Mycoses
Approach to Diagnosing and Managing Implantation Mycoses
Implantation mycoses such as chromoblastomycosis, subcutaneous phaeohyphomycosis, and mycetoma are a diverse group of fungal diseases that occur when a break in the skin allows the entry of the causative fungus. These diseases disproportionately affect individuals in low- and middle-income countries causing substantial disability, decreased quality of life, and severe social stigma.1-3 Timely diagnosis and appropriate treatment are critical.
Chromoblastomycosis and mycetoma are designated as neglected tropical diseases, but research to improve their management is sparse, even compared to other neglected tropical diseases.4,5 Since there are no global diagnostic and treatment guidelines to date, we outline steps to diagnose and manage chromoblastomycosis, subcutaneous phaeohyphomycosis, and mycetoma.
Chromoblastomycosis
Chromoblastomycosis is caused by dematiaceous fungi that typically affect the skin and subcutaneous tissue. Chromoblastomycosis is distinguished from subcutaneous phaeohyphomycosis by microscopically visualizing the characteristic thick-walled, single, or multicellular clusters of pigmented fungal cells (also known as medlar bodies, muriform cells, or sclerotic bodies).6 In phaeohyphomycosis, short hyphae and pseudohyphae plus some single cells typically are seen.
Epidemiology—Globally, the distribution and burden of chromoblastomycosis are relatively unknown. Infections are more common in tropical and subtropical areas but can be acquired anywhere. A literature review conducted in 2021 identified 7740 cases of chromoblastomycosis, mostly reported in South America, Africa, Central America and Mexico, and Asia.7 Most of the patients were male, and the median age was 52 years. One study found an incidence of 14.7 per 1,000,000 patients in the United States for both chromoblastomycosis and phaeohyphomycotic abscesses (which included both skin and brain abscesses).8 Most patients were aged 65 years or older, with a higher incidence in males. Geographically, the incidence was highest in the Northeast followed by the South; patients in rural areas also had higher incidence of disease.8
Causative Organisms—Causative species cannot reliably distinguish between chromoblastomycosis and subcutaneous phaeohyphomycosis, as some species overlap. Cladophialophora carrionii, Fonsecaea species, Phialophora verrucosa species complex, and Rhinocladiella aquaspersa most commonly cause chromoblastomycosis.9,10
Clinical Manifestations—Chromoblastomycosis initially manifests as a solitary erythematous macule at a site of trauma (often not recalled by the patient) that can evolve to a smooth pink papule and may progress to 1 of 5 morphologies: nodular, verrucous, tumorous, cicatricial, or plaque.6 Patients may present with more than one morphology, particularly in long-standing or advanced disease. Lesions commonly manifest on the arms and legs in otherwise healthy individuals in environments (eg, rural, agricultural) that have more opportunities for injury and exposure to the causative fungi. Affected individuals often have small black specks on the lesion surface that are visible with the naked eye.6
Diagnosis—Common differential diagnoses include cutaneous blastomycosis, fixed sporotrichosis, warty tuberculosis nocardiosis, cutaneous leishmaniasis, human papillomavirus (HPV) infection, podoconiosis, lymphatic filariasis, cutaneous tuberculosis, and psoriasis.6 Squamous cell carcinoma is both a differential diagnosis as well as a potential complication of the disease.11
Potassium hydroxide preparation with skin scapings or a biopsy from the lesion has high sensitivity and quick turnaround times. There often is a background histopathologic reaction of pseudoepitheliomatous hyperplasia. Examining samples taken from areas with the visible small black dots on the skin surface can increase the likelihood of detecting fungal elements (Figure 1). Clinicians also may choose to obtain a 6- to 8-mm deep skin biopsy from the lesion and splice it in half, with one sample sent for histopathology and the other for culture (Figure 2). Skin scrapings can be sent for culture instead. In the case of verrucous lesions, biopsy is preferred if feasible.


Treatment should not be delayed while awaiting the culture results if infection is otherwise confirmed by direct microscopy or histopathology. The treatment approach remains similar regardless of the causative species. If the culture results are positive, the causative genus can be identified by the microscopic morphology; however, molecular diagnostic tools are needed for accurate species identification.12,13
Antifungal Susceptibility Testing—For most dematiaceous fungi, interpreting minimum inhibitory concentrations (MICs) is challenging due to a lack of data from multicenter studies. One report examined sequential isolates of Fonsecaea pedrosoi and demonstrated both high MIC values and clinical resistance to itraconazole in some cases, likely from treatment pressure.14 Clinical Laboratory Standards Institute–approved epidemiologic cutoff values (ECVs) are established for F pedrosoi for commonly used antifungals including itraconazole (0.5 µg/mL), terbinafine (0.25 µg/mL), and posaconazole (0.5 µg/mL).15 Clinicians may choose to obtain sequential isolates for any causative fungi in recalcitrant disease to monitor for increases in MIC.
Management—In early-stage disease, excision of the skin nodule may be curative, although concomitant treatment for several months with an antifungal is advised. If antifungals are needed, itraconazole is the most commonly prescribed agent, typically at a dose of 100 to 200 mg twice daily. Terbinafine also has been used first-line at a dose of 250 to 500 mg per day. Voriconazole and posaconazole also may be suitable options for first-line or for refractory disease treatment. Fluconazole does not have good activity against dematiaceous fungi and should be avoided.16 Topical antifungals will not reach the site of infection in adequate concentrations. Topical corticosteroids can make the disease worse and should be avoided. The duration of therapy usually is several months, but many patients require years of therapy until resolution of lesions.
Clinicians can consider combination therapy with an antifungal and a topical immunomodulator such as imiquimod (applied topically 3 times per week); this combination can be considered in refractory disease and even upon initial diagnosis, especially in severe disease.17,18 Nonpharmacologic interventions such as cryotherapy, heat, and light-based therapies have been used, but outcome data are scarce.19-23
Subcutaneous Phaeohyphomycosis
Subcutaneous phaeohyphomycosis also is caused by dematiaceous fungi that typically affect the skin and subcutaneous tissue. Subcutaneous phaeohyphomycosis is distinguished from chromoblastomycosis by short hyphae and hyphal fragments usually seen microscopically instead of visualizing thick-walled, single, or multicellular clusters of pigmented fungal cells.6
Epidemiology—Globally, the burden and distribution of phaeohyphomycosis, including its cutaneous manifestations, are not well understood. Infections are more common in tropical and subtropical areas but can be acquired anywhere. Phaeohyphomycosis is a generic term used to describe infections caused by pigmented hyphal fungi that can manifest on the skin (subcutaneous phaeohyphomycosis) but also can affect deep structures including the brain (systemic phaeohyphomycosis).24
Causative Organisms—Alternaria, Bipolaris, Cladosporium, Curvularia, Exophiala, and Exserohilum species most commonly cause subcutaneous phaeohyphomycosis. Alternaria infections manifesting with skin lesions often are referred to as cutaneous alternariosis.25
Clinical Manifestations—The most common skin manifestation of phaeohyphomycosis is a subcutaneous cyst (cystic phaeohyphomycosis)(Figure 2). Subcutaneous phaeohyphomycosis also may manifest with nodules or plaques (Figure 3). Phaeohyphomycosis appears to occur more commonly in individuals who are immunosuppressed, those in whom T-cell function is affected, in congenital immunodeficiency states (eg, individuals with CARD9 mutations).26

Diagnosis—Culture is the gold standard for confirming phaeohyphomycosis.27 For cystic phaeohyphomycosis, clinicians can consider aspiration of the cyst for direct microscopic examination and culture. Histopathology may be utilized but can have lower sensitivity in showing dematiaceous hyphae and granulomatous inflammation; using the Masson-Fontana stain for melanin can be helpful. Molecular diagnostic tools including metagenomics applied directly to the tissue may be useful but are likely to have lower sensitivity than culture and require specialist diagnostic facilities.
Management—The approaches to managing chromoblastomycosis and subcutaneous phaeohyphomycosis are similar, though the preferred agents often differ. In early-stage disease, excision of the skin nodule may be curative, although concomitant treatment for several months with an antifungal is advised. In localized forms, itraconazole usually is used, but in those cases associated with immunodeficiency states, voriconazole may be necessary. Fluconazole does not have good activity against dematiaceous fungi and should be avoided.16 Topical antifungals will not reach the site of infection in adequate concentrations. Topical corticosteroids can make the disease worse and should be avoided. The duration of therapy may be substantially longer for chromoblastomycosis (months to years) compared to subcutaneous phaeohyphomycosis (weeks to months), although in immunocompromised individuals treatment may be even more prolonged.
Mycetoma
Mycetoma is caused by one of several different types of fungi (eumycetoma) and bacteria (actinomycetoma) that lead to progressively debilitating yet painless subcutaneous tumorlike lesions. The lesions usually manifest on the arms and legs but can occur anywhere.
Epidemiology—Little is known about the true global burden of mycetoma, but it occurs more frequently in low-income communities in rural areas.28 A retrospective review identified 19,494 cases published from 1876 to 2019, with cases reported in 102 countries.29 The countries with the highest numbers of cases are Sudan and Mexico, where there is more information on the distribution of the disease. Cases often are reported in what is known as the mycetoma belt (between latitudes 15° south and 30° north) but are increasingly identified outside this region.28 Young men aged 20 to 40 years are most commonly affected.
In the United States, mycetoma is uncommon, but clinicians can encounter locally acquired and travel-associated cases; hence, taking a good travel history is essential. One study specifically evaluating eumycetoma found a prevalence of 5.2 per 1,000,000 patients.8 Women and those aged 65 years or older had a higher incidence. Incidence was similar across US regions, but a higher incidence was reported in nonrural areas.8
Causative Organisms—More than 60 different species of fungi can cause eumycetoma; most cases are caused by Madurella mycetomatis, Trematosphaeria grisea (formerly Madurella grisea); Pseudallescheria boydii species complex, and Falciformispora (formerly Leptosphaeria) senegalensis.30 Actinomycetoma commonly is caused by Nocardia species (Nocardia brasiliensis, Nocardia asteroides, Nocardia otitidiscaviarum, Nocardia transvalensis, Nocardia harenae, and Nocardia takedensis), Streptomyces somaliensis, and Actinomadura species (Actinomadura madurae, Actinomadura pelletieri).31
Clinical Manifestations—Mycetoma is a chronic granulomatous disease with a progressive inflammatory reaction (Figures 4 and 5). Over the course of years, mycetoma progresses from small nodules to large, bone-invasive, mutilating lesions. Mycetoma manifests as a triad of painless firm subcutaneous masses, formation of multiple sinuses within the masses, and a purulent or seropurulent discharge containing sandlike visible particles (grains) that can be white, yellow, red, or black.28 Lesions usually are painless in early disease and are slowly progressive. Large lesion size, bone destruction, secondary bacterial infections, and actinomycetoma may lead to higher likelihood of pain.32


Diagnosis—Other conditions that could manifest with the same triad seen in mycetoma such as botryomycosis should be included in the differential. Other differential diagnoses include foreign body granuloma, filariasis, mycobacterial infection, skeletal tuberculosis, and yaws.
Proper treatment requires an accurate diagnosis that distinguishes actinomycetoma from eumycetoma.33 Culturing of grains obtained from deep lesion aspirates enables identification of the causative organism (Figure 6). The color of the grains may provide clues to their etiology: black grains are caused by fungus, red grains by a bacterium (A pelletieri), and pale (yellow or white) grains can be caused by either one.31Nocardia mycetoma grains are very small and usually cannot be appreciated with the naked eye. Histopathology of deep biopsy specimens (biopsy needle or surgical biopsy) stained with hematoxylin and eosin can diagnose actinomycetoma and eumycetoma. Punch biopsies often are not helpful, as the inflammatory mass is too deeply located. Deep surgical biopsy is preferred; however, species identification cannot be made without culture. Molecular tests for certain causative organisms of mycetoma have been developed but are not readily available.34,35 Currently, no serologic tests can diagnose mycetoma reliably. Ultrasonography can be used to diagnose mycetoma and, with appropriate training, distinguish between actinomycetoma and eumycetoma; it also can be combined with needle aspiration for taking grain samples.36

Treatment—Treatment of mycetoma depends on identification of the causal etiology and requires long-term and expensive drug regimens. It is not possible to determine the causative organism clinically. Actinomycetoma generally responds to medical treatment, and surgery rarely is needed. The current first-line treatment is co-trimoxazole (trimethoprim/sulfamethoxazole) in combination with amoxicillin and clavulanate acid or co-trimoxazole and amikacin for refractory disease; linezolid also may be a promising option for refractory disease.37
Eumycetoma is less responsive to medical therapies, and recurrence is common. Current recommended therapy is itraconazole for 9 to 12 months; however, cure rates ranging from 26% to 75% in combination with surgery have been reported, and fungi often can still be cultured from lesions posttreatment.38,39 Surgical excision often is used following 6 months of treatment with itraconazole to obtain better outcomes. Amputation may be required if the combination of antifungals and surgical excision fails. Fosravuconazole has shown promise in one clinical trial, but it is not approved in most countries, including the United States.39
Final Thoughts
Chromoblastomycosis, subcutaneous phaeohyphomycosis, and mycetoma can cause devastating disease. Patients with these conditions often are unable to carry out daily activities and experience stigma and discrimination. Limited diagnostic and treatment options hamper the ability of clinicians to respond appropriately to suspect and confirmed disease. Effectively examining the skin is the starting point for diagnosing and managing these diseases and can help clinicians to care for patients and prevent severe disease.
- Smith DJ, Soebono H, Parajuli N, et al. South-east Asia regional neglected tropical disease framework: improving control of mycetoma, chromoblastomycosis, and sporotrichosis. Lancet Reg Health Southeast Asia. 2025;35:100561. doi:10.1016/j.lansea.2025.100561
- Abbas M, Scolding PS, Yosif AA, et al. The disabling consequences of mycetoma. PLoS Negl Trop Dis. 2018;12:E0007019. doi:10.1371/journal.pntd.0007019
- Siregar GO, Harianja M, Rinonce HT, et al. Chromoblastomycosis: a case series from Sumba, eastern Indonesia. Clin Exp Dermatol. Published online March 8, 2025. doi:10.1093/ced/llaf111
- World Health Organization. Ending the neglect to attain the Sustainable Development Goals: a road map for neglected tropical diseases 2021-2030. Published January 28, 2021. Accessed May 5, 2024. https://www.who.int/publications/i/item/9789240010352
- Impact Global Health. The G-FINDER 2024 neglected disease R&D report. Impact Global Health. Published January 30, 2025. Accessed January 12, 2025. https://cdn.impactglobalhealth.org/media/G-FINDER%202024_Full%20report-1.pdf
- Queiroz-Telles F, de Hoog S, Santos DWCL, et al. Chromoblastomycosis. Clin Microbiol Rev. 2017;30:233-276. doi:10.1128/CMR.00032-16
- Santos DWCL, de Azevedo CMPS, Vicente VA, et al. The global burden of chromoblastomycosis. PLoS Negl Trop Dis. 2021;15:E0009611. doi:10.1371/journal.pntd.0009611
- Gold JAW, Smith DJ, Benedict K, et al. Epidemiology of implantation mycoses in the United States: an analysis of commercial insurance claims data, 2017 to 2021. J Am Acad Dermatol. 2023;89:427-430. doi:10.1016/j.jaad.2023.04.048
- Smith DJ, Queiroz-Telles F, Rabenja FR, et al. A global chromoblastomycosis strategy and development of the global chromoblastomycosis working group. PLoS Negl Trop Dis. 2024;18:e0012562. doi:10.1371/journal.pntd.0012562
- Heath CP, Sharma PC, Sontakke S, et al. The brief case: hidden in plain sight—exophiala jeanselmei subcutaneous phaeohyphomycosis of hand masquerading as a hematoma. J Clin Microbiol. 2024;62:E01068-24. doi:10.1128/jcm.01068-24
- Azevedo CMPS, Marques SG, Santos DWCL, et al. Squamous cell carcinoma derived from chronic chromoblastomycosis in Brazil. Clin Infect Dis. 2015;60:1500-1504. doi:10.1093/cid/civ104
- Sun J, Najafzadeh MJ, Gerrits van den Ende AHG, et al. Molecular characterization of pathogenic members of the genus Fonsecaea using multilocus analysis. PloS One. 2012;7:E41512. doi:10.1371/journal.pone.0041512
- Najafzadeh MJ, Sun J, Vicente V, et al. Fonsecaea nubica sp. nov, a new agent of human chromoblastomycosis revealed using molecular data. Med Mycol. 2010;48:800-806. doi:10.3109/13693780903503081
- Andrade TS, Castro LGM, Nunes RS, et al. Susceptibility of sequential Fonsecaea pedrosoi isolates from chromoblastomycosis patients to antifungal agents. Mycoses. 2004;47:216-221. doi:10.1111/j.1439-0507.2004.00984.x
- Smith DJ, Melhem MSC, Dirven J, et al. Establishment of epidemiological cutoff values for Fonsecaea pedrosoi, the primary etiologic agent of chromoblastomycosis, and eight antifungal medications. J Clin Microbiol. Published online April 4, 2025. doi:10.1128/jcm.01903-24
- Revankar SG, Sutton DA. Melanized fungi in human disease. Clin Microbiol Rev. 2010;23:884-928. doi:10.1128/CMR.00019-10
- de Sousa M da GT, Belda W, Spina R, et al. Topical application of imiquimod as a treatment for chromoblastomycosis. Clin Infect Dis. 2014;58:1734-1737. doi:10.1093/cid/ciu168
- Logan C, Singh M, Fox N, et al. Chromoblastomycosis treated with posaconazole and adjunctive imiquimod: lending innate immunity a helping hand. Open Forum Infect Dis. Published online March 14, 2023. doi:10.1093/ofid/ofad124
- Castro LGM, Pimentel ERA, Lacaz CS. Treatment of chromomycosis by cryosurgery with liquid nitrogen: 15 years’ experience. Int J Dermatol. 2003;42:408-412. doi:10.1046/j.1365-4362.2003.01532.x
- Tagami H, Ohi M, Aoshima T, et al. Topical heat therapy for cutaneous chromomycosis. Arch Dermatol. 1979;115:740-741.
- Lyon JP, Pedroso e Silva Azevedo C de M, Moreira LM, et al. Photodynamic antifungal therapy against chromoblastomycosis. Mycopathologia. 2011;172:293-297. doi:10.1007/s11046-011-9434-6
- Kinbara T, Fukushiro R, Eryu Y. Chromomycosis—report of two cases successfully treated with local heat therapy. Mykosen. 1982;25:689-694. doi:10.1111/j.1439-0507.1982.tb01944.x
- Yang Y, Hu Y, Zhang J, et al. A refractory case of chromoblastomycosis due to Fonsecaea monophora with improvement by photodynamic therapy. Med Mycol. 2012;50:649-653. doi:10.3109/13693786.2012.655258
- Sánchez-Cárdenas CD, Isa-Pimentel M, Arenas R. Phaeohyphomycosis: a review. Microbiol Res. 2023;14:1751-1763. doi:10.3390/microbiolres14040120
- Guillet J, Berkaoui I, Gargala G, et al. Cutaneous alternariosis. Mycopathologia. 2024;189:81. doi:10.1007/s11046-024-00888-5
- Wang X, Wang W, Lin Z, et al. CARD9 mutations linked to subcutaneous phaeohyphomycosis and TH17 cell deficiencies. J Allergy Clin Immunol. 2014;133:905-908. doi:10.1016/j.jaci.2013.09.033
- Revankar SG, Baddley JW, Chen SCA, et al. A mycoses study group international prospective study of phaeohyphomycosis: an analysis of 99 proven/probable cases. Open Forum Infect Dis. 2017;4:ofx200. doi:10.1093/ofid/ofx200
- Zijlstra EE, van de Sande WWJ, Welsh O, et al. Mycetoma: a unique neglected tropical disease. Lancet Infect Dis. 2016;16:100-112. doi:10.1016/S1473-3099(15)00359-X
- Emery D, Denning DW. The global distribution of actinomycetoma and eumycetoma. PLoS Negl Trop Dis. 2020;14:E0008397. doi:10.1371/journal.pntd.0008397
- van de Sande WWJ, Fahal AH. An updated list of eumycetoma causative agents and their differences in grain formation and treatment response. Clin Microbiol Rev. Published online May 2024. doi:10.1128/cmr.00034-23
- Nenoff P, van de Sande WWJ, Fahal AH, et al. Eumycetoma and actinomycetoma—an update on causative agents, epidemiology, pathogenesis, diagnostics and therapy. J Eur Acad Dermatol Venereol. 2015;29:1873-1883. doi:10.1111/jdv.13008
- El-Amin SO, El-Amin RO, El-Amin SM, et al. Painful mycetoma: a study to understand the risk factors in patients visiting the Mycetoma Research Centre (MRC) in Khartoum, Sudan. Trans R Soc Trop Med Hyg. 2025;119:145-151. doi:10.1093/trstmh/trae093
- Ahmed AA, van de Sande W, Fahal AH. Mycetoma laboratory diagnosis: review article. PLoS Negl Trop Dis. 2017;11:e0005638. doi:10.1371/journal.pntd.0005638
- Siddig EE, Ahmed A, Hassan OB, et al. Using a Madurella mycetomatis specific PCR on grains obtained via noninvasive fine needle aspirated material is more accurate than cytology. Mycoses. Published online February 5, 2023. doi:10.1111/myc.13572
- Konings M, Siddig E, Eadie K, et al. The development of a multiplex recombinase polymerase amplification reaction to detect the most common causative agents of eumycetoma. Eur J Clin Microbiol Infect Dis. Published online April 30, 2025. doi:10.1007/s10096-025-05134-4
- Siddig EE, El Had Bakhait O, El nour Hussein Bahar M, et al. Ultrasound-guided fine-needle aspiration cytology significantly improved mycetoma diagnosis. J Eur Acad Dermatol Venereol. 2022;36:1845-1850. doi:10.1111/jdv.18363
- Bonifaz A, García-Sotelo RS, Lumbán-Ramirez F, et al. Update on actinomycetoma treatment: linezolid in the treatment of actinomycetomas due to Nocardia spp and Actinomadura madurae resistant to conventional treatments. Expert Rev Anti Infect Ther. 2025;23:79-89. doi:10.1080/14787210.2024.2448723
- Chandler DJ, Bonifaz A, van de Sande WWJ. An update on the development of novel antifungal agents for eumycetoma. Front Pharmacol. 2023;14:1165273. doi:10.3389/fphar.2023.1165273
- Fahal AH, Siddig Ahmed E, Mubarak Bakhiet S, et al. Two dose levels of once-weekly fosravuconazole versus daily itraconazole, in combination with surgery, in patients with eumycetoma in Sudan: a randomised, double-blind, phase 2, proof-of-concept superiority trial. Lancet Infect Dis. 2024;24:1254-1265. doi:10.1016/S1473-3099(24)00404-3
Implantation mycoses such as chromoblastomycosis, subcutaneous phaeohyphomycosis, and mycetoma are a diverse group of fungal diseases that occur when a break in the skin allows the entry of the causative fungus. These diseases disproportionately affect individuals in low- and middle-income countries causing substantial disability, decreased quality of life, and severe social stigma.1-3 Timely diagnosis and appropriate treatment are critical.
Chromoblastomycosis and mycetoma are designated as neglected tropical diseases, but research to improve their management is sparse, even compared to other neglected tropical diseases.4,5 Since there are no global diagnostic and treatment guidelines to date, we outline steps to diagnose and manage chromoblastomycosis, subcutaneous phaeohyphomycosis, and mycetoma.
Chromoblastomycosis
Chromoblastomycosis is caused by dematiaceous fungi that typically affect the skin and subcutaneous tissue. Chromoblastomycosis is distinguished from subcutaneous phaeohyphomycosis by microscopically visualizing the characteristic thick-walled, single, or multicellular clusters of pigmented fungal cells (also known as medlar bodies, muriform cells, or sclerotic bodies).6 In phaeohyphomycosis, short hyphae and pseudohyphae plus some single cells typically are seen.
Epidemiology—Globally, the distribution and burden of chromoblastomycosis are relatively unknown. Infections are more common in tropical and subtropical areas but can be acquired anywhere. A literature review conducted in 2021 identified 7740 cases of chromoblastomycosis, mostly reported in South America, Africa, Central America and Mexico, and Asia.7 Most of the patients were male, and the median age was 52 years. One study found an incidence of 14.7 per 1,000,000 patients in the United States for both chromoblastomycosis and phaeohyphomycotic abscesses (which included both skin and brain abscesses).8 Most patients were aged 65 years or older, with a higher incidence in males. Geographically, the incidence was highest in the Northeast followed by the South; patients in rural areas also had higher incidence of disease.8
Causative Organisms—Causative species cannot reliably distinguish between chromoblastomycosis and subcutaneous phaeohyphomycosis, as some species overlap. Cladophialophora carrionii, Fonsecaea species, Phialophora verrucosa species complex, and Rhinocladiella aquaspersa most commonly cause chromoblastomycosis.9,10
Clinical Manifestations—Chromoblastomycosis initially manifests as a solitary erythematous macule at a site of trauma (often not recalled by the patient) that can evolve to a smooth pink papule and may progress to 1 of 5 morphologies: nodular, verrucous, tumorous, cicatricial, or plaque.6 Patients may present with more than one morphology, particularly in long-standing or advanced disease. Lesions commonly manifest on the arms and legs in otherwise healthy individuals in environments (eg, rural, agricultural) that have more opportunities for injury and exposure to the causative fungi. Affected individuals often have small black specks on the lesion surface that are visible with the naked eye.6
Diagnosis—Common differential diagnoses include cutaneous blastomycosis, fixed sporotrichosis, warty tuberculosis nocardiosis, cutaneous leishmaniasis, human papillomavirus (HPV) infection, podoconiosis, lymphatic filariasis, cutaneous tuberculosis, and psoriasis.6 Squamous cell carcinoma is both a differential diagnosis as well as a potential complication of the disease.11
Potassium hydroxide preparation with skin scapings or a biopsy from the lesion has high sensitivity and quick turnaround times. There often is a background histopathologic reaction of pseudoepitheliomatous hyperplasia. Examining samples taken from areas with the visible small black dots on the skin surface can increase the likelihood of detecting fungal elements (Figure 1). Clinicians also may choose to obtain a 6- to 8-mm deep skin biopsy from the lesion and splice it in half, with one sample sent for histopathology and the other for culture (Figure 2). Skin scrapings can be sent for culture instead. In the case of verrucous lesions, biopsy is preferred if feasible.


Treatment should not be delayed while awaiting the culture results if infection is otherwise confirmed by direct microscopy or histopathology. The treatment approach remains similar regardless of the causative species. If the culture results are positive, the causative genus can be identified by the microscopic morphology; however, molecular diagnostic tools are needed for accurate species identification.12,13
Antifungal Susceptibility Testing—For most dematiaceous fungi, interpreting minimum inhibitory concentrations (MICs) is challenging due to a lack of data from multicenter studies. One report examined sequential isolates of Fonsecaea pedrosoi and demonstrated both high MIC values and clinical resistance to itraconazole in some cases, likely from treatment pressure.14 Clinical Laboratory Standards Institute–approved epidemiologic cutoff values (ECVs) are established for F pedrosoi for commonly used antifungals including itraconazole (0.5 µg/mL), terbinafine (0.25 µg/mL), and posaconazole (0.5 µg/mL).15 Clinicians may choose to obtain sequential isolates for any causative fungi in recalcitrant disease to monitor for increases in MIC.
Management—In early-stage disease, excision of the skin nodule may be curative, although concomitant treatment for several months with an antifungal is advised. If antifungals are needed, itraconazole is the most commonly prescribed agent, typically at a dose of 100 to 200 mg twice daily. Terbinafine also has been used first-line at a dose of 250 to 500 mg per day. Voriconazole and posaconazole also may be suitable options for first-line or for refractory disease treatment. Fluconazole does not have good activity against dematiaceous fungi and should be avoided.16 Topical antifungals will not reach the site of infection in adequate concentrations. Topical corticosteroids can make the disease worse and should be avoided. The duration of therapy usually is several months, but many patients require years of therapy until resolution of lesions.
Clinicians can consider combination therapy with an antifungal and a topical immunomodulator such as imiquimod (applied topically 3 times per week); this combination can be considered in refractory disease and even upon initial diagnosis, especially in severe disease.17,18 Nonpharmacologic interventions such as cryotherapy, heat, and light-based therapies have been used, but outcome data are scarce.19-23
Subcutaneous Phaeohyphomycosis
Subcutaneous phaeohyphomycosis also is caused by dematiaceous fungi that typically affect the skin and subcutaneous tissue. Subcutaneous phaeohyphomycosis is distinguished from chromoblastomycosis by short hyphae and hyphal fragments usually seen microscopically instead of visualizing thick-walled, single, or multicellular clusters of pigmented fungal cells.6
Epidemiology—Globally, the burden and distribution of phaeohyphomycosis, including its cutaneous manifestations, are not well understood. Infections are more common in tropical and subtropical areas but can be acquired anywhere. Phaeohyphomycosis is a generic term used to describe infections caused by pigmented hyphal fungi that can manifest on the skin (subcutaneous phaeohyphomycosis) but also can affect deep structures including the brain (systemic phaeohyphomycosis).24
Causative Organisms—Alternaria, Bipolaris, Cladosporium, Curvularia, Exophiala, and Exserohilum species most commonly cause subcutaneous phaeohyphomycosis. Alternaria infections manifesting with skin lesions often are referred to as cutaneous alternariosis.25
Clinical Manifestations—The most common skin manifestation of phaeohyphomycosis is a subcutaneous cyst (cystic phaeohyphomycosis)(Figure 2). Subcutaneous phaeohyphomycosis also may manifest with nodules or plaques (Figure 3). Phaeohyphomycosis appears to occur more commonly in individuals who are immunosuppressed, those in whom T-cell function is affected, in congenital immunodeficiency states (eg, individuals with CARD9 mutations).26

Diagnosis—Culture is the gold standard for confirming phaeohyphomycosis.27 For cystic phaeohyphomycosis, clinicians can consider aspiration of the cyst for direct microscopic examination and culture. Histopathology may be utilized but can have lower sensitivity in showing dematiaceous hyphae and granulomatous inflammation; using the Masson-Fontana stain for melanin can be helpful. Molecular diagnostic tools including metagenomics applied directly to the tissue may be useful but are likely to have lower sensitivity than culture and require specialist diagnostic facilities.
Management—The approaches to managing chromoblastomycosis and subcutaneous phaeohyphomycosis are similar, though the preferred agents often differ. In early-stage disease, excision of the skin nodule may be curative, although concomitant treatment for several months with an antifungal is advised. In localized forms, itraconazole usually is used, but in those cases associated with immunodeficiency states, voriconazole may be necessary. Fluconazole does not have good activity against dematiaceous fungi and should be avoided.16 Topical antifungals will not reach the site of infection in adequate concentrations. Topical corticosteroids can make the disease worse and should be avoided. The duration of therapy may be substantially longer for chromoblastomycosis (months to years) compared to subcutaneous phaeohyphomycosis (weeks to months), although in immunocompromised individuals treatment may be even more prolonged.
Mycetoma
Mycetoma is caused by one of several different types of fungi (eumycetoma) and bacteria (actinomycetoma) that lead to progressively debilitating yet painless subcutaneous tumorlike lesions. The lesions usually manifest on the arms and legs but can occur anywhere.
Epidemiology—Little is known about the true global burden of mycetoma, but it occurs more frequently in low-income communities in rural areas.28 A retrospective review identified 19,494 cases published from 1876 to 2019, with cases reported in 102 countries.29 The countries with the highest numbers of cases are Sudan and Mexico, where there is more information on the distribution of the disease. Cases often are reported in what is known as the mycetoma belt (between latitudes 15° south and 30° north) but are increasingly identified outside this region.28 Young men aged 20 to 40 years are most commonly affected.
In the United States, mycetoma is uncommon, but clinicians can encounter locally acquired and travel-associated cases; hence, taking a good travel history is essential. One study specifically evaluating eumycetoma found a prevalence of 5.2 per 1,000,000 patients.8 Women and those aged 65 years or older had a higher incidence. Incidence was similar across US regions, but a higher incidence was reported in nonrural areas.8
Causative Organisms—More than 60 different species of fungi can cause eumycetoma; most cases are caused by Madurella mycetomatis, Trematosphaeria grisea (formerly Madurella grisea); Pseudallescheria boydii species complex, and Falciformispora (formerly Leptosphaeria) senegalensis.30 Actinomycetoma commonly is caused by Nocardia species (Nocardia brasiliensis, Nocardia asteroides, Nocardia otitidiscaviarum, Nocardia transvalensis, Nocardia harenae, and Nocardia takedensis), Streptomyces somaliensis, and Actinomadura species (Actinomadura madurae, Actinomadura pelletieri).31
Clinical Manifestations—Mycetoma is a chronic granulomatous disease with a progressive inflammatory reaction (Figures 4 and 5). Over the course of years, mycetoma progresses from small nodules to large, bone-invasive, mutilating lesions. Mycetoma manifests as a triad of painless firm subcutaneous masses, formation of multiple sinuses within the masses, and a purulent or seropurulent discharge containing sandlike visible particles (grains) that can be white, yellow, red, or black.28 Lesions usually are painless in early disease and are slowly progressive. Large lesion size, bone destruction, secondary bacterial infections, and actinomycetoma may lead to higher likelihood of pain.32


Diagnosis—Other conditions that could manifest with the same triad seen in mycetoma such as botryomycosis should be included in the differential. Other differential diagnoses include foreign body granuloma, filariasis, mycobacterial infection, skeletal tuberculosis, and yaws.
Proper treatment requires an accurate diagnosis that distinguishes actinomycetoma from eumycetoma.33 Culturing of grains obtained from deep lesion aspirates enables identification of the causative organism (Figure 6). The color of the grains may provide clues to their etiology: black grains are caused by fungus, red grains by a bacterium (A pelletieri), and pale (yellow or white) grains can be caused by either one.31Nocardia mycetoma grains are very small and usually cannot be appreciated with the naked eye. Histopathology of deep biopsy specimens (biopsy needle or surgical biopsy) stained with hematoxylin and eosin can diagnose actinomycetoma and eumycetoma. Punch biopsies often are not helpful, as the inflammatory mass is too deeply located. Deep surgical biopsy is preferred; however, species identification cannot be made without culture. Molecular tests for certain causative organisms of mycetoma have been developed but are not readily available.34,35 Currently, no serologic tests can diagnose mycetoma reliably. Ultrasonography can be used to diagnose mycetoma and, with appropriate training, distinguish between actinomycetoma and eumycetoma; it also can be combined with needle aspiration for taking grain samples.36

Treatment—Treatment of mycetoma depends on identification of the causal etiology and requires long-term and expensive drug regimens. It is not possible to determine the causative organism clinically. Actinomycetoma generally responds to medical treatment, and surgery rarely is needed. The current first-line treatment is co-trimoxazole (trimethoprim/sulfamethoxazole) in combination with amoxicillin and clavulanate acid or co-trimoxazole and amikacin for refractory disease; linezolid also may be a promising option for refractory disease.37
Eumycetoma is less responsive to medical therapies, and recurrence is common. Current recommended therapy is itraconazole for 9 to 12 months; however, cure rates ranging from 26% to 75% in combination with surgery have been reported, and fungi often can still be cultured from lesions posttreatment.38,39 Surgical excision often is used following 6 months of treatment with itraconazole to obtain better outcomes. Amputation may be required if the combination of antifungals and surgical excision fails. Fosravuconazole has shown promise in one clinical trial, but it is not approved in most countries, including the United States.39
Final Thoughts
Chromoblastomycosis, subcutaneous phaeohyphomycosis, and mycetoma can cause devastating disease. Patients with these conditions often are unable to carry out daily activities and experience stigma and discrimination. Limited diagnostic and treatment options hamper the ability of clinicians to respond appropriately to suspect and confirmed disease. Effectively examining the skin is the starting point for diagnosing and managing these diseases and can help clinicians to care for patients and prevent severe disease.
Implantation mycoses such as chromoblastomycosis, subcutaneous phaeohyphomycosis, and mycetoma are a diverse group of fungal diseases that occur when a break in the skin allows the entry of the causative fungus. These diseases disproportionately affect individuals in low- and middle-income countries causing substantial disability, decreased quality of life, and severe social stigma.1-3 Timely diagnosis and appropriate treatment are critical.
Chromoblastomycosis and mycetoma are designated as neglected tropical diseases, but research to improve their management is sparse, even compared to other neglected tropical diseases.4,5 Since there are no global diagnostic and treatment guidelines to date, we outline steps to diagnose and manage chromoblastomycosis, subcutaneous phaeohyphomycosis, and mycetoma.
Chromoblastomycosis
Chromoblastomycosis is caused by dematiaceous fungi that typically affect the skin and subcutaneous tissue. Chromoblastomycosis is distinguished from subcutaneous phaeohyphomycosis by microscopically visualizing the characteristic thick-walled, single, or multicellular clusters of pigmented fungal cells (also known as medlar bodies, muriform cells, or sclerotic bodies).6 In phaeohyphomycosis, short hyphae and pseudohyphae plus some single cells typically are seen.
Epidemiology—Globally, the distribution and burden of chromoblastomycosis are relatively unknown. Infections are more common in tropical and subtropical areas but can be acquired anywhere. A literature review conducted in 2021 identified 7740 cases of chromoblastomycosis, mostly reported in South America, Africa, Central America and Mexico, and Asia.7 Most of the patients were male, and the median age was 52 years. One study found an incidence of 14.7 per 1,000,000 patients in the United States for both chromoblastomycosis and phaeohyphomycotic abscesses (which included both skin and brain abscesses).8 Most patients were aged 65 years or older, with a higher incidence in males. Geographically, the incidence was highest in the Northeast followed by the South; patients in rural areas also had higher incidence of disease.8
Causative Organisms—Causative species cannot reliably distinguish between chromoblastomycosis and subcutaneous phaeohyphomycosis, as some species overlap. Cladophialophora carrionii, Fonsecaea species, Phialophora verrucosa species complex, and Rhinocladiella aquaspersa most commonly cause chromoblastomycosis.9,10
Clinical Manifestations—Chromoblastomycosis initially manifests as a solitary erythematous macule at a site of trauma (often not recalled by the patient) that can evolve to a smooth pink papule and may progress to 1 of 5 morphologies: nodular, verrucous, tumorous, cicatricial, or plaque.6 Patients may present with more than one morphology, particularly in long-standing or advanced disease. Lesions commonly manifest on the arms and legs in otherwise healthy individuals in environments (eg, rural, agricultural) that have more opportunities for injury and exposure to the causative fungi. Affected individuals often have small black specks on the lesion surface that are visible with the naked eye.6
Diagnosis—Common differential diagnoses include cutaneous blastomycosis, fixed sporotrichosis, warty tuberculosis nocardiosis, cutaneous leishmaniasis, human papillomavirus (HPV) infection, podoconiosis, lymphatic filariasis, cutaneous tuberculosis, and psoriasis.6 Squamous cell carcinoma is both a differential diagnosis as well as a potential complication of the disease.11
Potassium hydroxide preparation with skin scapings or a biopsy from the lesion has high sensitivity and quick turnaround times. There often is a background histopathologic reaction of pseudoepitheliomatous hyperplasia. Examining samples taken from areas with the visible small black dots on the skin surface can increase the likelihood of detecting fungal elements (Figure 1). Clinicians also may choose to obtain a 6- to 8-mm deep skin biopsy from the lesion and splice it in half, with one sample sent for histopathology and the other for culture (Figure 2). Skin scrapings can be sent for culture instead. In the case of verrucous lesions, biopsy is preferred if feasible.


Treatment should not be delayed while awaiting the culture results if infection is otherwise confirmed by direct microscopy or histopathology. The treatment approach remains similar regardless of the causative species. If the culture results are positive, the causative genus can be identified by the microscopic morphology; however, molecular diagnostic tools are needed for accurate species identification.12,13
Antifungal Susceptibility Testing—For most dematiaceous fungi, interpreting minimum inhibitory concentrations (MICs) is challenging due to a lack of data from multicenter studies. One report examined sequential isolates of Fonsecaea pedrosoi and demonstrated both high MIC values and clinical resistance to itraconazole in some cases, likely from treatment pressure.14 Clinical Laboratory Standards Institute–approved epidemiologic cutoff values (ECVs) are established for F pedrosoi for commonly used antifungals including itraconazole (0.5 µg/mL), terbinafine (0.25 µg/mL), and posaconazole (0.5 µg/mL).15 Clinicians may choose to obtain sequential isolates for any causative fungi in recalcitrant disease to monitor for increases in MIC.
Management—In early-stage disease, excision of the skin nodule may be curative, although concomitant treatment for several months with an antifungal is advised. If antifungals are needed, itraconazole is the most commonly prescribed agent, typically at a dose of 100 to 200 mg twice daily. Terbinafine also has been used first-line at a dose of 250 to 500 mg per day. Voriconazole and posaconazole also may be suitable options for first-line or for refractory disease treatment. Fluconazole does not have good activity against dematiaceous fungi and should be avoided.16 Topical antifungals will not reach the site of infection in adequate concentrations. Topical corticosteroids can make the disease worse and should be avoided. The duration of therapy usually is several months, but many patients require years of therapy until resolution of lesions.
Clinicians can consider combination therapy with an antifungal and a topical immunomodulator such as imiquimod (applied topically 3 times per week); this combination can be considered in refractory disease and even upon initial diagnosis, especially in severe disease.17,18 Nonpharmacologic interventions such as cryotherapy, heat, and light-based therapies have been used, but outcome data are scarce.19-23
Subcutaneous Phaeohyphomycosis
Subcutaneous phaeohyphomycosis also is caused by dematiaceous fungi that typically affect the skin and subcutaneous tissue. Subcutaneous phaeohyphomycosis is distinguished from chromoblastomycosis by short hyphae and hyphal fragments usually seen microscopically instead of visualizing thick-walled, single, or multicellular clusters of pigmented fungal cells.6
Epidemiology—Globally, the burden and distribution of phaeohyphomycosis, including its cutaneous manifestations, are not well understood. Infections are more common in tropical and subtropical areas but can be acquired anywhere. Phaeohyphomycosis is a generic term used to describe infections caused by pigmented hyphal fungi that can manifest on the skin (subcutaneous phaeohyphomycosis) but also can affect deep structures including the brain (systemic phaeohyphomycosis).24
Causative Organisms—Alternaria, Bipolaris, Cladosporium, Curvularia, Exophiala, and Exserohilum species most commonly cause subcutaneous phaeohyphomycosis. Alternaria infections manifesting with skin lesions often are referred to as cutaneous alternariosis.25
Clinical Manifestations—The most common skin manifestation of phaeohyphomycosis is a subcutaneous cyst (cystic phaeohyphomycosis)(Figure 2). Subcutaneous phaeohyphomycosis also may manifest with nodules or plaques (Figure 3). Phaeohyphomycosis appears to occur more commonly in individuals who are immunosuppressed, those in whom T-cell function is affected, in congenital immunodeficiency states (eg, individuals with CARD9 mutations).26

Diagnosis—Culture is the gold standard for confirming phaeohyphomycosis.27 For cystic phaeohyphomycosis, clinicians can consider aspiration of the cyst for direct microscopic examination and culture. Histopathology may be utilized but can have lower sensitivity in showing dematiaceous hyphae and granulomatous inflammation; using the Masson-Fontana stain for melanin can be helpful. Molecular diagnostic tools including metagenomics applied directly to the tissue may be useful but are likely to have lower sensitivity than culture and require specialist diagnostic facilities.
Management—The approaches to managing chromoblastomycosis and subcutaneous phaeohyphomycosis are similar, though the preferred agents often differ. In early-stage disease, excision of the skin nodule may be curative, although concomitant treatment for several months with an antifungal is advised. In localized forms, itraconazole usually is used, but in those cases associated with immunodeficiency states, voriconazole may be necessary. Fluconazole does not have good activity against dematiaceous fungi and should be avoided.16 Topical antifungals will not reach the site of infection in adequate concentrations. Topical corticosteroids can make the disease worse and should be avoided. The duration of therapy may be substantially longer for chromoblastomycosis (months to years) compared to subcutaneous phaeohyphomycosis (weeks to months), although in immunocompromised individuals treatment may be even more prolonged.
Mycetoma
Mycetoma is caused by one of several different types of fungi (eumycetoma) and bacteria (actinomycetoma) that lead to progressively debilitating yet painless subcutaneous tumorlike lesions. The lesions usually manifest on the arms and legs but can occur anywhere.
Epidemiology—Little is known about the true global burden of mycetoma, but it occurs more frequently in low-income communities in rural areas.28 A retrospective review identified 19,494 cases published from 1876 to 2019, with cases reported in 102 countries.29 The countries with the highest numbers of cases are Sudan and Mexico, where there is more information on the distribution of the disease. Cases often are reported in what is known as the mycetoma belt (between latitudes 15° south and 30° north) but are increasingly identified outside this region.28 Young men aged 20 to 40 years are most commonly affected.
In the United States, mycetoma is uncommon, but clinicians can encounter locally acquired and travel-associated cases; hence, taking a good travel history is essential. One study specifically evaluating eumycetoma found a prevalence of 5.2 per 1,000,000 patients.8 Women and those aged 65 years or older had a higher incidence. Incidence was similar across US regions, but a higher incidence was reported in nonrural areas.8
Causative Organisms—More than 60 different species of fungi can cause eumycetoma; most cases are caused by Madurella mycetomatis, Trematosphaeria grisea (formerly Madurella grisea); Pseudallescheria boydii species complex, and Falciformispora (formerly Leptosphaeria) senegalensis.30 Actinomycetoma commonly is caused by Nocardia species (Nocardia brasiliensis, Nocardia asteroides, Nocardia otitidiscaviarum, Nocardia transvalensis, Nocardia harenae, and Nocardia takedensis), Streptomyces somaliensis, and Actinomadura species (Actinomadura madurae, Actinomadura pelletieri).31
Clinical Manifestations—Mycetoma is a chronic granulomatous disease with a progressive inflammatory reaction (Figures 4 and 5). Over the course of years, mycetoma progresses from small nodules to large, bone-invasive, mutilating lesions. Mycetoma manifests as a triad of painless firm subcutaneous masses, formation of multiple sinuses within the masses, and a purulent or seropurulent discharge containing sandlike visible particles (grains) that can be white, yellow, red, or black.28 Lesions usually are painless in early disease and are slowly progressive. Large lesion size, bone destruction, secondary bacterial infections, and actinomycetoma may lead to higher likelihood of pain.32


Diagnosis—Other conditions that could manifest with the same triad seen in mycetoma such as botryomycosis should be included in the differential. Other differential diagnoses include foreign body granuloma, filariasis, mycobacterial infection, skeletal tuberculosis, and yaws.
Proper treatment requires an accurate diagnosis that distinguishes actinomycetoma from eumycetoma.33 Culturing of grains obtained from deep lesion aspirates enables identification of the causative organism (Figure 6). The color of the grains may provide clues to their etiology: black grains are caused by fungus, red grains by a bacterium (A pelletieri), and pale (yellow or white) grains can be caused by either one.31Nocardia mycetoma grains are very small and usually cannot be appreciated with the naked eye. Histopathology of deep biopsy specimens (biopsy needle or surgical biopsy) stained with hematoxylin and eosin can diagnose actinomycetoma and eumycetoma. Punch biopsies often are not helpful, as the inflammatory mass is too deeply located. Deep surgical biopsy is preferred; however, species identification cannot be made without culture. Molecular tests for certain causative organisms of mycetoma have been developed but are not readily available.34,35 Currently, no serologic tests can diagnose mycetoma reliably. Ultrasonography can be used to diagnose mycetoma and, with appropriate training, distinguish between actinomycetoma and eumycetoma; it also can be combined with needle aspiration for taking grain samples.36

Treatment—Treatment of mycetoma depends on identification of the causal etiology and requires long-term and expensive drug regimens. It is not possible to determine the causative organism clinically. Actinomycetoma generally responds to medical treatment, and surgery rarely is needed. The current first-line treatment is co-trimoxazole (trimethoprim/sulfamethoxazole) in combination with amoxicillin and clavulanate acid or co-trimoxazole and amikacin for refractory disease; linezolid also may be a promising option for refractory disease.37
Eumycetoma is less responsive to medical therapies, and recurrence is common. Current recommended therapy is itraconazole for 9 to 12 months; however, cure rates ranging from 26% to 75% in combination with surgery have been reported, and fungi often can still be cultured from lesions posttreatment.38,39 Surgical excision often is used following 6 months of treatment with itraconazole to obtain better outcomes. Amputation may be required if the combination of antifungals and surgical excision fails. Fosravuconazole has shown promise in one clinical trial, but it is not approved in most countries, including the United States.39
Final Thoughts
Chromoblastomycosis, subcutaneous phaeohyphomycosis, and mycetoma can cause devastating disease. Patients with these conditions often are unable to carry out daily activities and experience stigma and discrimination. Limited diagnostic and treatment options hamper the ability of clinicians to respond appropriately to suspect and confirmed disease. Effectively examining the skin is the starting point for diagnosing and managing these diseases and can help clinicians to care for patients and prevent severe disease.
- Smith DJ, Soebono H, Parajuli N, et al. South-east Asia regional neglected tropical disease framework: improving control of mycetoma, chromoblastomycosis, and sporotrichosis. Lancet Reg Health Southeast Asia. 2025;35:100561. doi:10.1016/j.lansea.2025.100561
- Abbas M, Scolding PS, Yosif AA, et al. The disabling consequences of mycetoma. PLoS Negl Trop Dis. 2018;12:E0007019. doi:10.1371/journal.pntd.0007019
- Siregar GO, Harianja M, Rinonce HT, et al. Chromoblastomycosis: a case series from Sumba, eastern Indonesia. Clin Exp Dermatol. Published online March 8, 2025. doi:10.1093/ced/llaf111
- World Health Organization. Ending the neglect to attain the Sustainable Development Goals: a road map for neglected tropical diseases 2021-2030. Published January 28, 2021. Accessed May 5, 2024. https://www.who.int/publications/i/item/9789240010352
- Impact Global Health. The G-FINDER 2024 neglected disease R&D report. Impact Global Health. Published January 30, 2025. Accessed January 12, 2025. https://cdn.impactglobalhealth.org/media/G-FINDER%202024_Full%20report-1.pdf
- Queiroz-Telles F, de Hoog S, Santos DWCL, et al. Chromoblastomycosis. Clin Microbiol Rev. 2017;30:233-276. doi:10.1128/CMR.00032-16
- Santos DWCL, de Azevedo CMPS, Vicente VA, et al. The global burden of chromoblastomycosis. PLoS Negl Trop Dis. 2021;15:E0009611. doi:10.1371/journal.pntd.0009611
- Gold JAW, Smith DJ, Benedict K, et al. Epidemiology of implantation mycoses in the United States: an analysis of commercial insurance claims data, 2017 to 2021. J Am Acad Dermatol. 2023;89:427-430. doi:10.1016/j.jaad.2023.04.048
- Smith DJ, Queiroz-Telles F, Rabenja FR, et al. A global chromoblastomycosis strategy and development of the global chromoblastomycosis working group. PLoS Negl Trop Dis. 2024;18:e0012562. doi:10.1371/journal.pntd.0012562
- Heath CP, Sharma PC, Sontakke S, et al. The brief case: hidden in plain sight—exophiala jeanselmei subcutaneous phaeohyphomycosis of hand masquerading as a hematoma. J Clin Microbiol. 2024;62:E01068-24. doi:10.1128/jcm.01068-24
- Azevedo CMPS, Marques SG, Santos DWCL, et al. Squamous cell carcinoma derived from chronic chromoblastomycosis in Brazil. Clin Infect Dis. 2015;60:1500-1504. doi:10.1093/cid/civ104
- Sun J, Najafzadeh MJ, Gerrits van den Ende AHG, et al. Molecular characterization of pathogenic members of the genus Fonsecaea using multilocus analysis. PloS One. 2012;7:E41512. doi:10.1371/journal.pone.0041512
- Najafzadeh MJ, Sun J, Vicente V, et al. Fonsecaea nubica sp. nov, a new agent of human chromoblastomycosis revealed using molecular data. Med Mycol. 2010;48:800-806. doi:10.3109/13693780903503081
- Andrade TS, Castro LGM, Nunes RS, et al. Susceptibility of sequential Fonsecaea pedrosoi isolates from chromoblastomycosis patients to antifungal agents. Mycoses. 2004;47:216-221. doi:10.1111/j.1439-0507.2004.00984.x
- Smith DJ, Melhem MSC, Dirven J, et al. Establishment of epidemiological cutoff values for Fonsecaea pedrosoi, the primary etiologic agent of chromoblastomycosis, and eight antifungal medications. J Clin Microbiol. Published online April 4, 2025. doi:10.1128/jcm.01903-24
- Revankar SG, Sutton DA. Melanized fungi in human disease. Clin Microbiol Rev. 2010;23:884-928. doi:10.1128/CMR.00019-10
- de Sousa M da GT, Belda W, Spina R, et al. Topical application of imiquimod as a treatment for chromoblastomycosis. Clin Infect Dis. 2014;58:1734-1737. doi:10.1093/cid/ciu168
- Logan C, Singh M, Fox N, et al. Chromoblastomycosis treated with posaconazole and adjunctive imiquimod: lending innate immunity a helping hand. Open Forum Infect Dis. Published online March 14, 2023. doi:10.1093/ofid/ofad124
- Castro LGM, Pimentel ERA, Lacaz CS. Treatment of chromomycosis by cryosurgery with liquid nitrogen: 15 years’ experience. Int J Dermatol. 2003;42:408-412. doi:10.1046/j.1365-4362.2003.01532.x
- Tagami H, Ohi M, Aoshima T, et al. Topical heat therapy for cutaneous chromomycosis. Arch Dermatol. 1979;115:740-741.
- Lyon JP, Pedroso e Silva Azevedo C de M, Moreira LM, et al. Photodynamic antifungal therapy against chromoblastomycosis. Mycopathologia. 2011;172:293-297. doi:10.1007/s11046-011-9434-6
- Kinbara T, Fukushiro R, Eryu Y. Chromomycosis—report of two cases successfully treated with local heat therapy. Mykosen. 1982;25:689-694. doi:10.1111/j.1439-0507.1982.tb01944.x
- Yang Y, Hu Y, Zhang J, et al. A refractory case of chromoblastomycosis due to Fonsecaea monophora with improvement by photodynamic therapy. Med Mycol. 2012;50:649-653. doi:10.3109/13693786.2012.655258
- Sánchez-Cárdenas CD, Isa-Pimentel M, Arenas R. Phaeohyphomycosis: a review. Microbiol Res. 2023;14:1751-1763. doi:10.3390/microbiolres14040120
- Guillet J, Berkaoui I, Gargala G, et al. Cutaneous alternariosis. Mycopathologia. 2024;189:81. doi:10.1007/s11046-024-00888-5
- Wang X, Wang W, Lin Z, et al. CARD9 mutations linked to subcutaneous phaeohyphomycosis and TH17 cell deficiencies. J Allergy Clin Immunol. 2014;133:905-908. doi:10.1016/j.jaci.2013.09.033
- Revankar SG, Baddley JW, Chen SCA, et al. A mycoses study group international prospective study of phaeohyphomycosis: an analysis of 99 proven/probable cases. Open Forum Infect Dis. 2017;4:ofx200. doi:10.1093/ofid/ofx200
- Zijlstra EE, van de Sande WWJ, Welsh O, et al. Mycetoma: a unique neglected tropical disease. Lancet Infect Dis. 2016;16:100-112. doi:10.1016/S1473-3099(15)00359-X
- Emery D, Denning DW. The global distribution of actinomycetoma and eumycetoma. PLoS Negl Trop Dis. 2020;14:E0008397. doi:10.1371/journal.pntd.0008397
- van de Sande WWJ, Fahal AH. An updated list of eumycetoma causative agents and their differences in grain formation and treatment response. Clin Microbiol Rev. Published online May 2024. doi:10.1128/cmr.00034-23
- Nenoff P, van de Sande WWJ, Fahal AH, et al. Eumycetoma and actinomycetoma—an update on causative agents, epidemiology, pathogenesis, diagnostics and therapy. J Eur Acad Dermatol Venereol. 2015;29:1873-1883. doi:10.1111/jdv.13008
- El-Amin SO, El-Amin RO, El-Amin SM, et al. Painful mycetoma: a study to understand the risk factors in patients visiting the Mycetoma Research Centre (MRC) in Khartoum, Sudan. Trans R Soc Trop Med Hyg. 2025;119:145-151. doi:10.1093/trstmh/trae093
- Ahmed AA, van de Sande W, Fahal AH. Mycetoma laboratory diagnosis: review article. PLoS Negl Trop Dis. 2017;11:e0005638. doi:10.1371/journal.pntd.0005638
- Siddig EE, Ahmed A, Hassan OB, et al. Using a Madurella mycetomatis specific PCR on grains obtained via noninvasive fine needle aspirated material is more accurate than cytology. Mycoses. Published online February 5, 2023. doi:10.1111/myc.13572
- Konings M, Siddig E, Eadie K, et al. The development of a multiplex recombinase polymerase amplification reaction to detect the most common causative agents of eumycetoma. Eur J Clin Microbiol Infect Dis. Published online April 30, 2025. doi:10.1007/s10096-025-05134-4
- Siddig EE, El Had Bakhait O, El nour Hussein Bahar M, et al. Ultrasound-guided fine-needle aspiration cytology significantly improved mycetoma diagnosis. J Eur Acad Dermatol Venereol. 2022;36:1845-1850. doi:10.1111/jdv.18363
- Bonifaz A, García-Sotelo RS, Lumbán-Ramirez F, et al. Update on actinomycetoma treatment: linezolid in the treatment of actinomycetomas due to Nocardia spp and Actinomadura madurae resistant to conventional treatments. Expert Rev Anti Infect Ther. 2025;23:79-89. doi:10.1080/14787210.2024.2448723
- Chandler DJ, Bonifaz A, van de Sande WWJ. An update on the development of novel antifungal agents for eumycetoma. Front Pharmacol. 2023;14:1165273. doi:10.3389/fphar.2023.1165273
- Fahal AH, Siddig Ahmed E, Mubarak Bakhiet S, et al. Two dose levels of once-weekly fosravuconazole versus daily itraconazole, in combination with surgery, in patients with eumycetoma in Sudan: a randomised, double-blind, phase 2, proof-of-concept superiority trial. Lancet Infect Dis. 2024;24:1254-1265. doi:10.1016/S1473-3099(24)00404-3
- Smith DJ, Soebono H, Parajuli N, et al. South-east Asia regional neglected tropical disease framework: improving control of mycetoma, chromoblastomycosis, and sporotrichosis. Lancet Reg Health Southeast Asia. 2025;35:100561. doi:10.1016/j.lansea.2025.100561
- Abbas M, Scolding PS, Yosif AA, et al. The disabling consequences of mycetoma. PLoS Negl Trop Dis. 2018;12:E0007019. doi:10.1371/journal.pntd.0007019
- Siregar GO, Harianja M, Rinonce HT, et al. Chromoblastomycosis: a case series from Sumba, eastern Indonesia. Clin Exp Dermatol. Published online March 8, 2025. doi:10.1093/ced/llaf111
- World Health Organization. Ending the neglect to attain the Sustainable Development Goals: a road map for neglected tropical diseases 2021-2030. Published January 28, 2021. Accessed May 5, 2024. https://www.who.int/publications/i/item/9789240010352
- Impact Global Health. The G-FINDER 2024 neglected disease R&D report. Impact Global Health. Published January 30, 2025. Accessed January 12, 2025. https://cdn.impactglobalhealth.org/media/G-FINDER%202024_Full%20report-1.pdf
- Queiroz-Telles F, de Hoog S, Santos DWCL, et al. Chromoblastomycosis. Clin Microbiol Rev. 2017;30:233-276. doi:10.1128/CMR.00032-16
- Santos DWCL, de Azevedo CMPS, Vicente VA, et al. The global burden of chromoblastomycosis. PLoS Negl Trop Dis. 2021;15:E0009611. doi:10.1371/journal.pntd.0009611
- Gold JAW, Smith DJ, Benedict K, et al. Epidemiology of implantation mycoses in the United States: an analysis of commercial insurance claims data, 2017 to 2021. J Am Acad Dermatol. 2023;89:427-430. doi:10.1016/j.jaad.2023.04.048
- Smith DJ, Queiroz-Telles F, Rabenja FR, et al. A global chromoblastomycosis strategy and development of the global chromoblastomycosis working group. PLoS Negl Trop Dis. 2024;18:e0012562. doi:10.1371/journal.pntd.0012562
- Heath CP, Sharma PC, Sontakke S, et al. The brief case: hidden in plain sight—exophiala jeanselmei subcutaneous phaeohyphomycosis of hand masquerading as a hematoma. J Clin Microbiol. 2024;62:E01068-24. doi:10.1128/jcm.01068-24
- Azevedo CMPS, Marques SG, Santos DWCL, et al. Squamous cell carcinoma derived from chronic chromoblastomycosis in Brazil. Clin Infect Dis. 2015;60:1500-1504. doi:10.1093/cid/civ104
- Sun J, Najafzadeh MJ, Gerrits van den Ende AHG, et al. Molecular characterization of pathogenic members of the genus Fonsecaea using multilocus analysis. PloS One. 2012;7:E41512. doi:10.1371/journal.pone.0041512
- Najafzadeh MJ, Sun J, Vicente V, et al. Fonsecaea nubica sp. nov, a new agent of human chromoblastomycosis revealed using molecular data. Med Mycol. 2010;48:800-806. doi:10.3109/13693780903503081
- Andrade TS, Castro LGM, Nunes RS, et al. Susceptibility of sequential Fonsecaea pedrosoi isolates from chromoblastomycosis patients to antifungal agents. Mycoses. 2004;47:216-221. doi:10.1111/j.1439-0507.2004.00984.x
- Smith DJ, Melhem MSC, Dirven J, et al. Establishment of epidemiological cutoff values for Fonsecaea pedrosoi, the primary etiologic agent of chromoblastomycosis, and eight antifungal medications. J Clin Microbiol. Published online April 4, 2025. doi:10.1128/jcm.01903-24
- Revankar SG, Sutton DA. Melanized fungi in human disease. Clin Microbiol Rev. 2010;23:884-928. doi:10.1128/CMR.00019-10
- de Sousa M da GT, Belda W, Spina R, et al. Topical application of imiquimod as a treatment for chromoblastomycosis. Clin Infect Dis. 2014;58:1734-1737. doi:10.1093/cid/ciu168
- Logan C, Singh M, Fox N, et al. Chromoblastomycosis treated with posaconazole and adjunctive imiquimod: lending innate immunity a helping hand. Open Forum Infect Dis. Published online March 14, 2023. doi:10.1093/ofid/ofad124
- Castro LGM, Pimentel ERA, Lacaz CS. Treatment of chromomycosis by cryosurgery with liquid nitrogen: 15 years’ experience. Int J Dermatol. 2003;42:408-412. doi:10.1046/j.1365-4362.2003.01532.x
- Tagami H, Ohi M, Aoshima T, et al. Topical heat therapy for cutaneous chromomycosis. Arch Dermatol. 1979;115:740-741.
- Lyon JP, Pedroso e Silva Azevedo C de M, Moreira LM, et al. Photodynamic antifungal therapy against chromoblastomycosis. Mycopathologia. 2011;172:293-297. doi:10.1007/s11046-011-9434-6
- Kinbara T, Fukushiro R, Eryu Y. Chromomycosis—report of two cases successfully treated with local heat therapy. Mykosen. 1982;25:689-694. doi:10.1111/j.1439-0507.1982.tb01944.x
- Yang Y, Hu Y, Zhang J, et al. A refractory case of chromoblastomycosis due to Fonsecaea monophora with improvement by photodynamic therapy. Med Mycol. 2012;50:649-653. doi:10.3109/13693786.2012.655258
- Sánchez-Cárdenas CD, Isa-Pimentel M, Arenas R. Phaeohyphomycosis: a review. Microbiol Res. 2023;14:1751-1763. doi:10.3390/microbiolres14040120
- Guillet J, Berkaoui I, Gargala G, et al. Cutaneous alternariosis. Mycopathologia. 2024;189:81. doi:10.1007/s11046-024-00888-5
- Wang X, Wang W, Lin Z, et al. CARD9 mutations linked to subcutaneous phaeohyphomycosis and TH17 cell deficiencies. J Allergy Clin Immunol. 2014;133:905-908. doi:10.1016/j.jaci.2013.09.033
- Revankar SG, Baddley JW, Chen SCA, et al. A mycoses study group international prospective study of phaeohyphomycosis: an analysis of 99 proven/probable cases. Open Forum Infect Dis. 2017;4:ofx200. doi:10.1093/ofid/ofx200
- Zijlstra EE, van de Sande WWJ, Welsh O, et al. Mycetoma: a unique neglected tropical disease. Lancet Infect Dis. 2016;16:100-112. doi:10.1016/S1473-3099(15)00359-X
- Emery D, Denning DW. The global distribution of actinomycetoma and eumycetoma. PLoS Negl Trop Dis. 2020;14:E0008397. doi:10.1371/journal.pntd.0008397
- van de Sande WWJ, Fahal AH. An updated list of eumycetoma causative agents and their differences in grain formation and treatment response. Clin Microbiol Rev. Published online May 2024. doi:10.1128/cmr.00034-23
- Nenoff P, van de Sande WWJ, Fahal AH, et al. Eumycetoma and actinomycetoma—an update on causative agents, epidemiology, pathogenesis, diagnostics and therapy. J Eur Acad Dermatol Venereol. 2015;29:1873-1883. doi:10.1111/jdv.13008
- El-Amin SO, El-Amin RO, El-Amin SM, et al. Painful mycetoma: a study to understand the risk factors in patients visiting the Mycetoma Research Centre (MRC) in Khartoum, Sudan. Trans R Soc Trop Med Hyg. 2025;119:145-151. doi:10.1093/trstmh/trae093
- Ahmed AA, van de Sande W, Fahal AH. Mycetoma laboratory diagnosis: review article. PLoS Negl Trop Dis. 2017;11:e0005638. doi:10.1371/journal.pntd.0005638
- Siddig EE, Ahmed A, Hassan OB, et al. Using a Madurella mycetomatis specific PCR on grains obtained via noninvasive fine needle aspirated material is more accurate than cytology. Mycoses. Published online February 5, 2023. doi:10.1111/myc.13572
- Konings M, Siddig E, Eadie K, et al. The development of a multiplex recombinase polymerase amplification reaction to detect the most common causative agents of eumycetoma. Eur J Clin Microbiol Infect Dis. Published online April 30, 2025. doi:10.1007/s10096-025-05134-4
- Siddig EE, El Had Bakhait O, El nour Hussein Bahar M, et al. Ultrasound-guided fine-needle aspiration cytology significantly improved mycetoma diagnosis. J Eur Acad Dermatol Venereol. 2022;36:1845-1850. doi:10.1111/jdv.18363
- Bonifaz A, García-Sotelo RS, Lumbán-Ramirez F, et al. Update on actinomycetoma treatment: linezolid in the treatment of actinomycetomas due to Nocardia spp and Actinomadura madurae resistant to conventional treatments. Expert Rev Anti Infect Ther. 2025;23:79-89. doi:10.1080/14787210.2024.2448723
- Chandler DJ, Bonifaz A, van de Sande WWJ. An update on the development of novel antifungal agents for eumycetoma. Front Pharmacol. 2023;14:1165273. doi:10.3389/fphar.2023.1165273
- Fahal AH, Siddig Ahmed E, Mubarak Bakhiet S, et al. Two dose levels of once-weekly fosravuconazole versus daily itraconazole, in combination with surgery, in patients with eumycetoma in Sudan: a randomised, double-blind, phase 2, proof-of-concept superiority trial. Lancet Infect Dis. 2024;24:1254-1265. doi:10.1016/S1473-3099(24)00404-3
Approach to Diagnosing and Managing Implantation Mycoses
Approach to Diagnosing and Managing Implantation Mycoses
Practice Points
- Chromoblastomycosis, subcutaneous phaeohyphomycosis, and mycetoma are implantation mycoses that cause substantial morbidity, decreased quality of life, and social stigma.
- Consider obtaining a biopsy of suspected chromoblastomycosis and subcutaneous phaeohyphomycosis to confirm infection while sending half of the sample for culture for organism identification.
- Distinguishing between actinomycetoma (caused by filamentous bacteria) and eumycetoma (caused by fungi) is critical for appropriate mycetoma treatment.
Immune Responses and Health Disparities Warrant Scabies Vaccine Development
Immune Responses and Health Disparities Warrant Scabies Vaccine Development
The scabies mite, originally known as Acarus scabiei,1 now is considered an arthropod of the class Arachnida, order Astigmata, and family Sarcoptidae.2 Scabies mites are able to adhere to the surface of human skin.3 The mites burrow and lay eggs in the top layer of the epidermis; most patients have 10 to 15 mites.3 The patient’s immune system incites an allergic reaction to the mite protein and feces in the skin, causing itching and rash.4
Scabies is common in indigenous populations and in low-income areas of developing countries.5 It is most prevalent in Africa, South America, Australia, and Southeast Asia, in part due to poverty, poor nutritional status, homelessness, and inadequate hygiene.2 In 2009, the World Health Organization declared scabies a neglected skin disease2; however, in 2010, 1.5 million disability adjusted life-years were attributed to scabies,6 and it is estimated that 200 million people worldwide have scabies at any given time. Children and elderly individuals in resource-poor communities are the most at risk. In fact, 5% to 50% of children in low-income areas have scabies.4
The purpose of this article is to provide background on scabies and its effect on the human immune system. We also discuss manipulation of the immune response for the purposes of creating a potential scabies vaccine.
Life Cycle and Transmission
The life cycle of Sarcoptes scabiei consists of 4 stages. The first is the egg. As female scabies mites burrow under the skin, they lay 2 to 3 ovular eggs per day.3 The second stage is the larva. When the egg hatches, the larva has 3 pairs of legs and travels to the surface of the skin where it burrows into the stratum corneum, creating short, nearly invisible burrows called molting pouches. After 3 to 4 days, the larva molts into a nymph, which is the third stage. The nymph has 4 pairs of legs and will continue to grow before molting into an adult, which is the fourth stage. Both the larva and nymph may be found in hair follicles or molting pouches. The fourth stage is the adult, which is round and saclike and does not have eyes. Adult females are 0.30 mm to 0.45 mm long and 0.25 mm to 0.35 mm wide, which is half the size of adult males.3 On warm skin, the female mite can crawl at a rate of 2.5 cm per minute.7
Scabies mites mate via an active male penetrating the molting pouch of a female. This only occurs once but leaves the female fertile for the rest of her life. Once a female is pregnant, she leaves her molting pouch and travels along the surface of the skin looking for a place to make her permanent burrow.3 The most common sites for scabies burrows are the axillae, umbilicus, interdigital spaces, beltline, buttocks, flexor surfaces of the wrists, female nipples, and male penile shaft.5 Once she finds an acceptable location, the female scabies mite will create a serpentine burrow and lay her eggs. Once she burrows, she will stay there and continue to lay eggs for the rest of her life, lengthening the burrow as needed.3 Female mites lay their eggs in the superficial epidermis, and the eggs take approximately 2 to 3 weeks to hatch. Female mites die 30 to 60 days later.2
Scabies infestations typically spread via the transfer of pregnant adult females during skin-to-skin contact, but they also can spread via fomites.3 During all stages of their life cycle, scabies mites can secrete enzymes that allow them to penetrate the intact epidermis in less than 30 minutes; in fact, an otherwise healthy patient with scabies must have 15 to 20 minutes of close skin-to-skin contact with an infected individual for the disease to be transmitted.7 Because scabies mites can survive for more than 3 days outside the human body, it is thought that fomites also may be involved in transmission. Scabies mites also have been collected from clothing, bedding, and furniture, which further supports the idea that fomites are involved in disease transmission.7
Clinical Manifestation of Scabies
Scabies symptoms include severe pruritus as well as linear burrows and vesicles in the interdigital spaces on the hands, wrists, arms and legs, and lower abdomen. Infants and young children also can develop a rash on the palms, soles, ankles, and scalp. Men can develop inflammatory scabies nodules on the penis and scrotum, while women can develop these nodules on the nipple.4 Type I and type IV hypersensitivity reactions contribute to the rash and itching associated with scabies infestation via host allergic and inflammatory reactions to the mites and their byproducts. Patients with scabies typically are infested with fewer than 15 mites,6 but just a few can cause substantial pruritus and scratching, leading to hyperkeratosis.8
Additionally, when patients with scabies scratch the skin, they become vulnerable to bacterial infections.4 Scabies lesions can be coinfected with group A streptococci and Staphylococcus aureus,8 potentially leading to abscesses and septicemia. These secondary infections also can cause renal and cardiac complications; in fact, in tropical areas, scabies infections are considered a risk factor for kidney disease and rheumatic heart disease.4
The 2 main forms of scabies infestations are ordinary and crusted. The most common form is ordinary scabies, which typically manifests with fewer than 15 mites per patient; crusted scabies (CS) is the more rare and extreme form.6 Cases of CS present with thousands to millions of mites per patient, leading to more widespread and severe symptoms.4 Because of the large increase in the number of mites, CS is more contagious than ordinary scabies.6
Patients with CS typically present with hyperkeratotic skin disease, as evidenced by thick scaly crusts with large numbers of mites, which can lead to permanent skin disfiguration. Patients with CS also can develop deep fissuring of the crusts, within which other microbes can gain entry to the body and lead to secondary infection and possibly sepsis and death. Also, because of the increased number of mites as well as the crusted skin, patients with CS are contagious for longer. As it is more difficult to eradicate, reinfestation is common with CS.6
Patients with compromised immune systems are predisposed to CS. Specifically, patients with HIV or human T-lymphotropic virus 1 or those undergoing organ transplantation are thought to be the most at risk for CS.6 Crusted scabies also has been identified in large numbers in patients with Down syndrome and in Aboriginal Australians; however, the reasoning for this is poorly understood.6
Immune Response
The inflammatory reaction associated with scabies infestations occurs 4 to 6 weeks after initial exposure. It is hypothesized that scabies can alter parts of the host immune system, which contributes to the delayed onset of symptoms. Scabies mites also produce inactivated protease paralogues and serpins, which help to protect the mites from the host immune system by inhibiting the complement system.6
The complement system is part of the innate immune response and is the first line of defense against pathogens. Specifically with scabies infestations, C3 and C4 complement components have been found in skin lesions.6 C3a and C4a fragments cause local inflammation, while C3a and C5a activate mast cells to release histamine and tumor necrosis factor (TNF) α, further amplifying the inflammatory response; however, CS lesions show low C3 and C4, which can indicate immunodeficiency in patients with CS. It also can be due to the sheer number of mites in a CS infection causing the host immune system to be overloaded.6
Innate effector immune cells also are an important part of the innate immune response to scabies; for example, eosinophilia is seen in scabies infections. Specifically, in CS, eosinophils help modulate and sustain the T-helper (Th) 2 inflammatory response. One cytokine secreted by Th2 cells is IL-5, which is closely associated with the attraction, maturation, and survival of eosinophils.6 Eosinophils also can influence the Th1 inflammatory response in that they produce IL-12, interferon (IFN) γ, and several Toll-like receptors. Furthermore, eosinophilic expression of IL-2 can lead to expansion of regulatory T cells, while eosinophilic expression of IL-10 and transforming growth factor (TGF) Β also can suppress local inflammation by influencing regulatory T cells.6
Additionally, mast cells and basophils are important in the IgE-mediated allergic reaction as well as the host immune response to parasites. When activated, basophils and mast cells produce TNF-α, IL-6, Il-4, IL-5, and IL-13, which contribute to the Th2 inflammatory response; however, the role of mast cells and basophils in scabies infections still is poorly understood.6
Macrophages, neutrophils, and dendritic cells (DCs) contribute to phagocytosis, antigen presentation, and differentiation of T cells, which also contribute to the inflammatory and allergic reactions associated with parasitic infections.6 Macrophages have been found in low numbers in scabies infestation, possibly due to immune-modulating molecules secreted by scabies mites. Early in an infestation, the mites secrete immune-modulating molecules, which inhibit macrophage migration to the site of inflammation, allowing the mites to grow.6 Neutrophils and DCs also are involved in the host immune response to scabies. Neutrophils are the predominant inflammatory cell infiltrate in scabies lesions. The scabies protein SMSB4 inhibits neutrophil opsonization and phagocytosis, thus suppressing bacterial killing.6 Some of the first antigen-presenting cells encountered by the antigen are DCs. They are involved in preparing the antigens for presentation to effector T cells, which leads to T-cell differentiation and activation.6
Cytokines are another important factor in the innate immune response. The host immune response to ordinary scabies is Th1-cell mediated, during which CD4+ and CD8+ T cells secrete IFN-γ, TNF-α, and IL-2.6 Therefore, IFN- γ and TNF-α are elevated in the serum of patients with ordinary scabies. Conversely, the host immune response to CS is Th2-cell mediated. T-helper 2 cells are needed in IgE-mediated hypersensitivity reactions, and they secrete IL-4, IL-5, and IL-13. In the serum of patients with CS, IL-l4, IL-5, and IL-13 are elevated while IFN-γ is decreased.6 Additionally, IL-6, TGF-Β, IL-23, IL-1Β, or IL-18 can induce Th17 cells to generate and secrete IL-17, which enhances the inflammatory response by inducing further expression of TNF-α, IL-1Β, IL-6, keratinocytes, and fibroblasts. T-helper 17 and IL-17 also are involved in psoriasis and atopic dermatitis, as well as Leishmania major and Schistosoma japonicum.6
Regulatory T cells Tregs secrete TGF-Β and IL-10, which suppress pathologic inflammation, and IL-10 is substantially reduced in patients with CS compared to those with ordinary scabies and uninfected control patients. Additionally, IL-10 can inhibit the synthesis of TNF-γ and IFN-α. Reduced IL-10 expression can lead to proliferation of IL-17 secretion, resulting in a regulatory T cell/Th17 dysfunctional immune response.6
Immunoglobulins are antibodies that are involved in the host’s adaptive immune response. The first antibody to appear in response to an antigen is IgM, and IgM bound to scabies antigens is present in 74%6 of patients with ordinary scabies. Because IgM is the first antibody to appear in response to a scabies infection, detection of serum IgM may allow for earlier detection of scabies; however, IgM has a high cross-reactivity between scabies mites and dust mites, which can hinder scabies diagnosis via IgM detection.6
Both patients with ordinary scabies and CS also show an increased circulatory IgG concentration compared to control groups; patients with CS have higher concentrations. Increased IgG also can be in part due to concurrent bacterial infections.6 When IgG or IgM antibodies bind to a pathogen, they activate the complement cascade, which further enhances the activity of these antibodies.9
Additionally, IgA is important in mucosal immune function. In both patients with ordinary scabies and CS, there is increased IgA binding to recombinant scabies mite antigens.6Sarcoptes scabiei proteases that are localized in the mite’s gut and scybala suggest their involvement in mite digestion and burrowing. The increased secretion of these proteases into the host skin may contribute to the increased IgA,9 and these increased IgA levels have been shown to be positively correlated with severity of scabies infection.6
Also essential in allergic and parasitic inflammation, IgE is observed at higher levels in secondary infections of scabies compared to primary infections.6 Additionally, T-cell infiltrates are implicated in adaptive immune response to scabies. CD4+ T cells are the most prevalent T cells in ordinary scabies skin lesions; however, CD4+ T cells are minimal and CD8+ T cells are elevated in CS skin lesions. The increased CD8+ T cells may cause apoptosis of keratinocytes, leading to epidermal hyperproliferation. The apoptotic keratinocytes can secrete cytokines, which can lead to tissue damage.6 These T cells also may be involved in the failure of the skin’s immune system to mount an effective response to the parasite infestation, leading to uncontrolled parasitic growth. Because patients with AIDS who are infected with scabies mites often develop CS, it is also thought that CD4+ T cells are essential in the immune response to scabies.6
Diagnosis and Current Treatment Options
Current diagnosis of scabies is based on mites, eggs, and fecal matter from the host’s skin. Dermoscopy and fluorescent dermoscopy can be helpful in identifying the mites, eggs, and feces on the patient’s skin. Scabies treatment sometimes may be based solely on symptoms without any positive tests.8
Acaricides are the current method of treatment for scabies infestations.5 Acaricides can be expensive and toxic to the environment and food sources,10 and some agents have been associated with neurotoxicity5 in children or the development of certain cancers.11 Although topical acaricides are the standard form of treatment, oral ivermectin also can be used. Ivermectin is not associated with selective fetal toxicity, but there are limited safety data in pregnant women and in children weighing less than 15 kg (33 lb). Additionally, because symptoms typically are not present during an early infection, treating everyone in the household and those who had close contact with the patient can help prevent reinfection.4
Although these drugs have been shown to be effective at treating scabies, scabies mites are becoming increasingly resistant to acaricides.5 There are 4 main proposed mechanisms for why this occurs.12 The first is through voltage-gated sodium channels, which are involved in the normal functioning of neurons and myocytes. Permethrin, a type of acaricide, binds to voltage-gated sodium channels when it is in an open or active state and prevents it from closing. This creates repetitive neuron firing and hyperactivity, which ultimately kills the scabies mite. Some mites have mutated to close this channel, which reduces the binding potential of permethrin. Glutathione S-transferase is another mechanism of resistance. It catalyzes a bond that tags drugs for elimination. Increased activity or expressivity of glutathione S-transferase by scabies mites can lead to drug resistance.12 Adenosine triphosphate– binding cassette (ABC) transporters also may contribute to this resistance. The ABC transporters use adenosine triphosphate to facilitate the import or export of molecules. Scabies mites express a protein called the multidrug-resistant protein, which is an ABC transporter that is associated with drug resistance and is present in scabies mites.12 Lastly, ligand-gated chloride channels have been implicated in scabies resistance to acaricides. Ligand-gated chloride channels also are important in normal functioning of neurons and myocytes. Some antiparasitic drugs act on these channels, leading to a continuous influx of chloride, but some scabies mites have mutated this pathway.12
Pesticides and the Risk for Cancer
Pesticides commonly are used to treat scabies; however, a link between pesticide exposure and leukemia and lymphoma has been seen through epidemiologic studies, and there also is increasing biological evidence to suggest this.11 For example, the pesticide permethrin, which works by paralyzing the nervous system of insects,13 has been associated with an increased risk for leukemia and lymphoma in humans. Permethrin is a pyrethroid and, compared to control patients, children with leukemia had higher levels of pyrethroid metabolites in their blood.14 Numerical and structural chromosomal aberrations that give rise to gene fusions are the most common abnormalities seen in leukemia, and permethrin has been shown to induce DNA breaks, chromosome aberrations, and sister chromatid exchanges.14 Permethrin also has been associated with an increased risk for multiple myeloma.13
Furthermore, in utero exposure to pesticides has been associated with an increased risk for childhood leukemia.15 Pesticide exposure shortly before conception, during pregnancy, and after birth is associated with an increased risk for acute lymphocytic leukemia.16 In fact, the children of mothers who were exposed to pesticides 3 months before conception have been found to be at least twice as likely to be diagnosed with acute lymphocytic leukemia within the first year of life compared with children whose mothers were not exposed to pesticides.17 It is hypothesized that permethrin can cross the placenta and alter the hematopoietic precursor cells in the fetus, resulting in leukemogenesis.18 Pyrethroid metabolites also have been detected in umbilical cord blood samples and breast milk.15
In contrast to the research demonstrating a link between permethrin and cancer, other studies have found no association between permethrin19 and leukemia20; non-Hodgkin lymphoma19; or cancers of the colon, rectum, pancreas, lungs, skin, female breast, prostate, and urinary bladder.20 Because of conflicting research on the link between permethrin and cancer, more research is needed.,20
Importance of a Scabies Vaccine
Because scabies mites are developing increasing treatment resistance, more radical approaches such as vaccines are becoming important. While a scabies vaccine is still aspirational, animals that have been infected for a second time with scabies demonstrate a milder response to the second infection compared to the first infection, which could mean there is a potential for disease prevention through a vaccine.21 While educating patients and physicians, reporting cases of infection, and improving drug supply and access can help decrease scabies infestations, these are costly and difficult to implement. Scabies already is most prevalent in low-income areas, so costly interventions are even less feasible. An effective, one-dose vaccine would cost less than these efforts and therefore could be implemented more easily.9
In older adults, scabies more often manifests atypically and is more likely to progress to CS. Aged care centers are prone to institutional outbreaks, even in developed countries, so a vaccine also would greatly help this population. Additionally, the number of children attending day care centers, which also are prone to scabies outbreaks, is increasing. When a child contracts scabies, all close contacts need to be treated, so a preventive vaccine can be useful.9
One potential candidate for a scabies vaccine is total mite extract. Studies show that rabbits immunized with a total mite extract induce antibodies to more antigens than rabbits naturally infested with scabies mites; however, the mites cannot be cultured in vitro, which makes obtaining a large amount of their total extract difficult. Therefore, recombinant vaccines also have been proposed, as they are more easily available.22 One recombinant vaccine candidate is recombinant S scabiei serpin (rSs-serpin). Immunization with rSs-serpin has strong immunogenicity and produced immune protection in rabbits.22
Two other recombinant vaccine candidates are the rSs chitinaselike protein (CLP) 12 and the rSsCLP5. Chitinaselike proteins are very similar to chitinases; however, they are unable to degrade chitin. They are involved in immune reactions to infections, and CLPs from scabies mites have been shown to induce the host immune response.22 For example, in a particular rabbit study, rSsCLP5 demonstrated high immunoreactivity and immunogenicity. In fact, after exposure to S scabiei, 74.3% of rabbits who were vaccinated with rSsCLP5 had no detectable lesions.5 Also, after immunization with rSsCLP5 and rSsCLP12, there were increased levels of specific IgG and IgE antibodies produced and decreased numbers of infesting mites.22 Weight loss also is associated with severe scabies infection. Rabbits vaccinated with rSsCLP5 and exposed to the parasite gained weight, indicating protection via rSsCLP5. Even rabbits who did develop symptoms of scabies after immunization with rSsCLP5 and exposure to S scabiei showed less serious manifestations.5
A combination vaccine cocktail of rSs-serpin, rSsCLP12, and rSsCLP5 also has been proposed by Shen et al.22 Four test groups and a control group (n=12 per group) were included in a vaccine trial. Between 83.33% and 91.67% of rabbits vaccinated with this mixed recombinant cocktail vaccine had no detectable skin lesions from scabies. After immunization with the cocktail vaccine, the specific serum IgG and IgE antibodies also increased. For both IgG and IgE, increased levels were first detected at 1 week postimmunization and peaked at 2 weeks postimmunization.22 A multiepitope vaccine derived from these 3 recombinant proteins also was explored by Shen et al22; fewer rabbits vaccinated with it had no detectable scabies skin lesions compared to those treated with the vaccine cocktail. Although the multiepitope vaccine yielded less immume protection, it was associated with a slower disease course and milder symptoms compared with no vaccination.22
Two more proposed scabies recombinant vaccine candidates are derived from the antigens Ssag1 and Ssag2; however, rabbits vaccinated with Ssag1 or Ssag2 showed no immune protection or mite burden reduction.22 The lack of protection could be due to denaturation or degradation of the protective antigens. It also can be due to the low abundance of these antigens, meaning they may not be vital for the mite’s survival—survival—a potential avenue for future research. The antigens also could have lost their native structure and immunogenic properties during the purification and production process. Therefore, more research is needed to investigate how to purify these vaccines to keep the peptides more structurally similar to their native makeups.10 More research also is needed to better understand the antigen or antigens and their mechanisms that elicit a protective immune response.9
Final Thoughts
Scabies causes severe pruritus in mild cases but also can lead to severe disfigurement, sepsis, and even death. Scabies infestations are seen disproportionately more often in low-income and resource-poor communities, and the current treatment options are less accessible to these populations. Scabies infestations induce a complex immune response that involves multiple aspects of both the innate and adaptive immune systems and can be targeted to create a scabies vaccine. Development of a scabies vaccine is crucial considering the growing resistance to current standard treatments. Acaricides potentially are associated with an increased risk for malignancy, which further amplifies the need for a scabies vaccine. There currently are multiple promising scabies vaccine candidates; however, more research is needed to better understand the host’s immune response to scabies as well as how to more accurately and efficiently produce the vaccine. The development of a safe, effective, economical vaccine that can be mass distributed would be beneficial in the treatment of scabies, especially in resource-poor communities.
- Arlian LG, Morgan MS. A review of Sarcoptes scabiei: past, present and future. Parasit Vectors. 2017;10:297. doi:10.1186/s13071-017-2234-1
- Murray RL, Crane JS. Scabies. In: StatPearls. StatPearls Publishing. Updated July 31, 2023.
- Centers for Disease Control and Prevention. CDC—scabies—biology. November 2, 2010. https://www.cdc.gov/dpdx/scabies/index.html
- World Health Organization. Scabies. May 31, 2023. Accessed May 8, 2025. https://www.who.int/news-room/fact-sheets/detail/scabies
- Shen N, Zhang H, Ren Y, et al. A chitinase-like protein from Sarcoptes scabiei as a candidate anti-mite vaccine that contributes to immune protection in rabbits. Parasit Vectors. 2018;11:599. doi:10.1186/s13071- 018-3184-y
- Bhat SA, Mounsey KE, Liu X, et al. Host immune responses to the itch mite, Sarcoptes scabiei, in humans. Parasit Vectors. 2017;10:385. doi:10.1186/s13071-017-2320-4
- Hicks MI, Elston DM. Scabies. Dermatolog Ther. 2009;22:279-292. doi:10.1111/j.1529-8019.2009.01243.x
- Morgan MS, Arlian LG, Rider SD, et al. A proteomic analysis of Sarcoptes scabiei (acari: Sarcoptidae). J Med Entomol. 2016;53:553-561. doi:10.1093/jme/tjv247
- Liu X, Walton S, Mounsey K. Vaccine against scabies: necessity and possibility. Parasitology. 2014;141:725-732. doi:10.1017 /s0031182013002047
- Casais R, Granda V, Balseiro A, et al. Vaccination of rabbits with immunodominant antigens from Sarcoptes scabiei induced high levels of humoral responses and pro-inflammatory cytokines but confers limited protection. Parasit Vectors. 2016;9:435. doi:10.1186 /s13071-016-1717-9?
- Navarrete-Meneses MP, Pedraza-Meléndez AI, Salas-Labadía C, et al. Low concentrations of permethrin and malathion induce numerical and structural abnormalities in KMT2A and IGH genes in vitro. J Appl Toxicol. 2018;38:1262-1270. doi:10.1002/jat.3638
- Khalil S, Abbas O, Kibbi AG, et al. Scabies in the age of increasing drug resistance. PLoS Negl Trop Dis. 2017;11:E0005920. doi:10.1371 /journal.pntd.0005920
- Rusiecki JA, Patel R, Koutros S, et al. Cancer incidence among pesticide applicators exposed to permethrin in the Agricultural Health Study. Environ Health Perspect. 2009;117:581-586. doi:10.1289 /ehp.11318
- Navarrete-Meneses MP, Salas-Labadía C, Sanabrais-Jiménez M, et al. Exposure to the insecticides permethrin and malathion induces leukemia and lymphoma-associated gene aberrations in vitro. Toxicol In Vitro. 2017;44:17-26. doi:10.1016/j.tiv.2017.06.013
- Navarrete-Meneses MDP, Pérez-Vera P. Pyrethroid pesticide exposure and hematological cancer: epidemiological, biological and molecular evidence. Rev Environ Health. 2019;34:197-210. doi:10.1515 /reveh-2018-0070
- Madrigal JM, Jones RR, Gunier RB, et al. Residential exposure to carbamate, organophosphate, and pyrethroid insecticides in house dust and risk of childhood acute lymphoblastic leukemia. Environ Res. 2021;201:111501. doi:10.1016/j.envres.2021.111501
- Ferreira JD, Couto AC, Pombo-de-Oliveira MS, et al. In utero pesticide exposure and leukemia in Brazilian children <2 years of age. Environ Health Perspect. 2013;121:269-275. doi:10.1289/ehp.1103942
- Borkhardt A, Wilda M, Fuchs U, et al. Congenital leukaemia after heavy abuse of permethrin during pregnancy. Arch Dis Child Fetal Neonatal Ed. 2003;88:F436-F437. doi:10.1136/fn.88.5.f436
- De Roos AJ, Schinasi LH, Miligi L, et al. Occupational insecticide exposure and risk of non]Hodgkin lymphoma: a pooled case]control study from the InterLymph consortium. Int J Cancer. 2021;149:1768-1786. doi:10.1002/ijc.33740
- Boffett, P, Desai V. Exposure to permethrin and cancer risk: a systematic review. Crit Rev Toxicol. 2018;48:433-442. doi:10.1080/1040 8444.2018.1439449
- Adji A, Rumokoy LJM, Salaki CL. Scabies vaccine as a new breakthrough for the challenge of acaricides resistance. Adv Biolog Sci Res. 2020;8:208-213. doi:10.2991/absr.k.200513.036
- Shen N, Wei W, Chen Y, et al. Vaccination with a cocktail vaccine elicits significant protection against Sarcoptes scabiei in rabbits, whereas the multi-epitope vaccine offers limited protection. Exp Parasitol. 2023;245:108442. doi:10.1016/j.exppara.2022.108442
The scabies mite, originally known as Acarus scabiei,1 now is considered an arthropod of the class Arachnida, order Astigmata, and family Sarcoptidae.2 Scabies mites are able to adhere to the surface of human skin.3 The mites burrow and lay eggs in the top layer of the epidermis; most patients have 10 to 15 mites.3 The patient’s immune system incites an allergic reaction to the mite protein and feces in the skin, causing itching and rash.4
Scabies is common in indigenous populations and in low-income areas of developing countries.5 It is most prevalent in Africa, South America, Australia, and Southeast Asia, in part due to poverty, poor nutritional status, homelessness, and inadequate hygiene.2 In 2009, the World Health Organization declared scabies a neglected skin disease2; however, in 2010, 1.5 million disability adjusted life-years were attributed to scabies,6 and it is estimated that 200 million people worldwide have scabies at any given time. Children and elderly individuals in resource-poor communities are the most at risk. In fact, 5% to 50% of children in low-income areas have scabies.4
The purpose of this article is to provide background on scabies and its effect on the human immune system. We also discuss manipulation of the immune response for the purposes of creating a potential scabies vaccine.
Life Cycle and Transmission
The life cycle of Sarcoptes scabiei consists of 4 stages. The first is the egg. As female scabies mites burrow under the skin, they lay 2 to 3 ovular eggs per day.3 The second stage is the larva. When the egg hatches, the larva has 3 pairs of legs and travels to the surface of the skin where it burrows into the stratum corneum, creating short, nearly invisible burrows called molting pouches. After 3 to 4 days, the larva molts into a nymph, which is the third stage. The nymph has 4 pairs of legs and will continue to grow before molting into an adult, which is the fourth stage. Both the larva and nymph may be found in hair follicles or molting pouches. The fourth stage is the adult, which is round and saclike and does not have eyes. Adult females are 0.30 mm to 0.45 mm long and 0.25 mm to 0.35 mm wide, which is half the size of adult males.3 On warm skin, the female mite can crawl at a rate of 2.5 cm per minute.7
Scabies mites mate via an active male penetrating the molting pouch of a female. This only occurs once but leaves the female fertile for the rest of her life. Once a female is pregnant, she leaves her molting pouch and travels along the surface of the skin looking for a place to make her permanent burrow.3 The most common sites for scabies burrows are the axillae, umbilicus, interdigital spaces, beltline, buttocks, flexor surfaces of the wrists, female nipples, and male penile shaft.5 Once she finds an acceptable location, the female scabies mite will create a serpentine burrow and lay her eggs. Once she burrows, she will stay there and continue to lay eggs for the rest of her life, lengthening the burrow as needed.3 Female mites lay their eggs in the superficial epidermis, and the eggs take approximately 2 to 3 weeks to hatch. Female mites die 30 to 60 days later.2
Scabies infestations typically spread via the transfer of pregnant adult females during skin-to-skin contact, but they also can spread via fomites.3 During all stages of their life cycle, scabies mites can secrete enzymes that allow them to penetrate the intact epidermis in less than 30 minutes; in fact, an otherwise healthy patient with scabies must have 15 to 20 minutes of close skin-to-skin contact with an infected individual for the disease to be transmitted.7 Because scabies mites can survive for more than 3 days outside the human body, it is thought that fomites also may be involved in transmission. Scabies mites also have been collected from clothing, bedding, and furniture, which further supports the idea that fomites are involved in disease transmission.7
Clinical Manifestation of Scabies
Scabies symptoms include severe pruritus as well as linear burrows and vesicles in the interdigital spaces on the hands, wrists, arms and legs, and lower abdomen. Infants and young children also can develop a rash on the palms, soles, ankles, and scalp. Men can develop inflammatory scabies nodules on the penis and scrotum, while women can develop these nodules on the nipple.4 Type I and type IV hypersensitivity reactions contribute to the rash and itching associated with scabies infestation via host allergic and inflammatory reactions to the mites and their byproducts. Patients with scabies typically are infested with fewer than 15 mites,6 but just a few can cause substantial pruritus and scratching, leading to hyperkeratosis.8
Additionally, when patients with scabies scratch the skin, they become vulnerable to bacterial infections.4 Scabies lesions can be coinfected with group A streptococci and Staphylococcus aureus,8 potentially leading to abscesses and septicemia. These secondary infections also can cause renal and cardiac complications; in fact, in tropical areas, scabies infections are considered a risk factor for kidney disease and rheumatic heart disease.4
The 2 main forms of scabies infestations are ordinary and crusted. The most common form is ordinary scabies, which typically manifests with fewer than 15 mites per patient; crusted scabies (CS) is the more rare and extreme form.6 Cases of CS present with thousands to millions of mites per patient, leading to more widespread and severe symptoms.4 Because of the large increase in the number of mites, CS is more contagious than ordinary scabies.6
Patients with CS typically present with hyperkeratotic skin disease, as evidenced by thick scaly crusts with large numbers of mites, which can lead to permanent skin disfiguration. Patients with CS also can develop deep fissuring of the crusts, within which other microbes can gain entry to the body and lead to secondary infection and possibly sepsis and death. Also, because of the increased number of mites as well as the crusted skin, patients with CS are contagious for longer. As it is more difficult to eradicate, reinfestation is common with CS.6
Patients with compromised immune systems are predisposed to CS. Specifically, patients with HIV or human T-lymphotropic virus 1 or those undergoing organ transplantation are thought to be the most at risk for CS.6 Crusted scabies also has been identified in large numbers in patients with Down syndrome and in Aboriginal Australians; however, the reasoning for this is poorly understood.6
Immune Response
The inflammatory reaction associated with scabies infestations occurs 4 to 6 weeks after initial exposure. It is hypothesized that scabies can alter parts of the host immune system, which contributes to the delayed onset of symptoms. Scabies mites also produce inactivated protease paralogues and serpins, which help to protect the mites from the host immune system by inhibiting the complement system.6
The complement system is part of the innate immune response and is the first line of defense against pathogens. Specifically with scabies infestations, C3 and C4 complement components have been found in skin lesions.6 C3a and C4a fragments cause local inflammation, while C3a and C5a activate mast cells to release histamine and tumor necrosis factor (TNF) α, further amplifying the inflammatory response; however, CS lesions show low C3 and C4, which can indicate immunodeficiency in patients with CS. It also can be due to the sheer number of mites in a CS infection causing the host immune system to be overloaded.6
Innate effector immune cells also are an important part of the innate immune response to scabies; for example, eosinophilia is seen in scabies infections. Specifically, in CS, eosinophils help modulate and sustain the T-helper (Th) 2 inflammatory response. One cytokine secreted by Th2 cells is IL-5, which is closely associated with the attraction, maturation, and survival of eosinophils.6 Eosinophils also can influence the Th1 inflammatory response in that they produce IL-12, interferon (IFN) γ, and several Toll-like receptors. Furthermore, eosinophilic expression of IL-2 can lead to expansion of regulatory T cells, while eosinophilic expression of IL-10 and transforming growth factor (TGF) Β also can suppress local inflammation by influencing regulatory T cells.6
Additionally, mast cells and basophils are important in the IgE-mediated allergic reaction as well as the host immune response to parasites. When activated, basophils and mast cells produce TNF-α, IL-6, Il-4, IL-5, and IL-13, which contribute to the Th2 inflammatory response; however, the role of mast cells and basophils in scabies infections still is poorly understood.6
Macrophages, neutrophils, and dendritic cells (DCs) contribute to phagocytosis, antigen presentation, and differentiation of T cells, which also contribute to the inflammatory and allergic reactions associated with parasitic infections.6 Macrophages have been found in low numbers in scabies infestation, possibly due to immune-modulating molecules secreted by scabies mites. Early in an infestation, the mites secrete immune-modulating molecules, which inhibit macrophage migration to the site of inflammation, allowing the mites to grow.6 Neutrophils and DCs also are involved in the host immune response to scabies. Neutrophils are the predominant inflammatory cell infiltrate in scabies lesions. The scabies protein SMSB4 inhibits neutrophil opsonization and phagocytosis, thus suppressing bacterial killing.6 Some of the first antigen-presenting cells encountered by the antigen are DCs. They are involved in preparing the antigens for presentation to effector T cells, which leads to T-cell differentiation and activation.6
Cytokines are another important factor in the innate immune response. The host immune response to ordinary scabies is Th1-cell mediated, during which CD4+ and CD8+ T cells secrete IFN-γ, TNF-α, and IL-2.6 Therefore, IFN- γ and TNF-α are elevated in the serum of patients with ordinary scabies. Conversely, the host immune response to CS is Th2-cell mediated. T-helper 2 cells are needed in IgE-mediated hypersensitivity reactions, and they secrete IL-4, IL-5, and IL-13. In the serum of patients with CS, IL-l4, IL-5, and IL-13 are elevated while IFN-γ is decreased.6 Additionally, IL-6, TGF-Β, IL-23, IL-1Β, or IL-18 can induce Th17 cells to generate and secrete IL-17, which enhances the inflammatory response by inducing further expression of TNF-α, IL-1Β, IL-6, keratinocytes, and fibroblasts. T-helper 17 and IL-17 also are involved in psoriasis and atopic dermatitis, as well as Leishmania major and Schistosoma japonicum.6
Regulatory T cells Tregs secrete TGF-Β and IL-10, which suppress pathologic inflammation, and IL-10 is substantially reduced in patients with CS compared to those with ordinary scabies and uninfected control patients. Additionally, IL-10 can inhibit the synthesis of TNF-γ and IFN-α. Reduced IL-10 expression can lead to proliferation of IL-17 secretion, resulting in a regulatory T cell/Th17 dysfunctional immune response.6
Immunoglobulins are antibodies that are involved in the host’s adaptive immune response. The first antibody to appear in response to an antigen is IgM, and IgM bound to scabies antigens is present in 74%6 of patients with ordinary scabies. Because IgM is the first antibody to appear in response to a scabies infection, detection of serum IgM may allow for earlier detection of scabies; however, IgM has a high cross-reactivity between scabies mites and dust mites, which can hinder scabies diagnosis via IgM detection.6
Both patients with ordinary scabies and CS also show an increased circulatory IgG concentration compared to control groups; patients with CS have higher concentrations. Increased IgG also can be in part due to concurrent bacterial infections.6 When IgG or IgM antibodies bind to a pathogen, they activate the complement cascade, which further enhances the activity of these antibodies.9
Additionally, IgA is important in mucosal immune function. In both patients with ordinary scabies and CS, there is increased IgA binding to recombinant scabies mite antigens.6Sarcoptes scabiei proteases that are localized in the mite’s gut and scybala suggest their involvement in mite digestion and burrowing. The increased secretion of these proteases into the host skin may contribute to the increased IgA,9 and these increased IgA levels have been shown to be positively correlated with severity of scabies infection.6
Also essential in allergic and parasitic inflammation, IgE is observed at higher levels in secondary infections of scabies compared to primary infections.6 Additionally, T-cell infiltrates are implicated in adaptive immune response to scabies. CD4+ T cells are the most prevalent T cells in ordinary scabies skin lesions; however, CD4+ T cells are minimal and CD8+ T cells are elevated in CS skin lesions. The increased CD8+ T cells may cause apoptosis of keratinocytes, leading to epidermal hyperproliferation. The apoptotic keratinocytes can secrete cytokines, which can lead to tissue damage.6 These T cells also may be involved in the failure of the skin’s immune system to mount an effective response to the parasite infestation, leading to uncontrolled parasitic growth. Because patients with AIDS who are infected with scabies mites often develop CS, it is also thought that CD4+ T cells are essential in the immune response to scabies.6
Diagnosis and Current Treatment Options
Current diagnosis of scabies is based on mites, eggs, and fecal matter from the host’s skin. Dermoscopy and fluorescent dermoscopy can be helpful in identifying the mites, eggs, and feces on the patient’s skin. Scabies treatment sometimes may be based solely on symptoms without any positive tests.8
Acaricides are the current method of treatment for scabies infestations.5 Acaricides can be expensive and toxic to the environment and food sources,10 and some agents have been associated with neurotoxicity5 in children or the development of certain cancers.11 Although topical acaricides are the standard form of treatment, oral ivermectin also can be used. Ivermectin is not associated with selective fetal toxicity, but there are limited safety data in pregnant women and in children weighing less than 15 kg (33 lb). Additionally, because symptoms typically are not present during an early infection, treating everyone in the household and those who had close contact with the patient can help prevent reinfection.4
Although these drugs have been shown to be effective at treating scabies, scabies mites are becoming increasingly resistant to acaricides.5 There are 4 main proposed mechanisms for why this occurs.12 The first is through voltage-gated sodium channels, which are involved in the normal functioning of neurons and myocytes. Permethrin, a type of acaricide, binds to voltage-gated sodium channels when it is in an open or active state and prevents it from closing. This creates repetitive neuron firing and hyperactivity, which ultimately kills the scabies mite. Some mites have mutated to close this channel, which reduces the binding potential of permethrin. Glutathione S-transferase is another mechanism of resistance. It catalyzes a bond that tags drugs for elimination. Increased activity or expressivity of glutathione S-transferase by scabies mites can lead to drug resistance.12 Adenosine triphosphate– binding cassette (ABC) transporters also may contribute to this resistance. The ABC transporters use adenosine triphosphate to facilitate the import or export of molecules. Scabies mites express a protein called the multidrug-resistant protein, which is an ABC transporter that is associated with drug resistance and is present in scabies mites.12 Lastly, ligand-gated chloride channels have been implicated in scabies resistance to acaricides. Ligand-gated chloride channels also are important in normal functioning of neurons and myocytes. Some antiparasitic drugs act on these channels, leading to a continuous influx of chloride, but some scabies mites have mutated this pathway.12
Pesticides and the Risk for Cancer
Pesticides commonly are used to treat scabies; however, a link between pesticide exposure and leukemia and lymphoma has been seen through epidemiologic studies, and there also is increasing biological evidence to suggest this.11 For example, the pesticide permethrin, which works by paralyzing the nervous system of insects,13 has been associated with an increased risk for leukemia and lymphoma in humans. Permethrin is a pyrethroid and, compared to control patients, children with leukemia had higher levels of pyrethroid metabolites in their blood.14 Numerical and structural chromosomal aberrations that give rise to gene fusions are the most common abnormalities seen in leukemia, and permethrin has been shown to induce DNA breaks, chromosome aberrations, and sister chromatid exchanges.14 Permethrin also has been associated with an increased risk for multiple myeloma.13
Furthermore, in utero exposure to pesticides has been associated with an increased risk for childhood leukemia.15 Pesticide exposure shortly before conception, during pregnancy, and after birth is associated with an increased risk for acute lymphocytic leukemia.16 In fact, the children of mothers who were exposed to pesticides 3 months before conception have been found to be at least twice as likely to be diagnosed with acute lymphocytic leukemia within the first year of life compared with children whose mothers were not exposed to pesticides.17 It is hypothesized that permethrin can cross the placenta and alter the hematopoietic precursor cells in the fetus, resulting in leukemogenesis.18 Pyrethroid metabolites also have been detected in umbilical cord blood samples and breast milk.15
In contrast to the research demonstrating a link between permethrin and cancer, other studies have found no association between permethrin19 and leukemia20; non-Hodgkin lymphoma19; or cancers of the colon, rectum, pancreas, lungs, skin, female breast, prostate, and urinary bladder.20 Because of conflicting research on the link between permethrin and cancer, more research is needed.,20
Importance of a Scabies Vaccine
Because scabies mites are developing increasing treatment resistance, more radical approaches such as vaccines are becoming important. While a scabies vaccine is still aspirational, animals that have been infected for a second time with scabies demonstrate a milder response to the second infection compared to the first infection, which could mean there is a potential for disease prevention through a vaccine.21 While educating patients and physicians, reporting cases of infection, and improving drug supply and access can help decrease scabies infestations, these are costly and difficult to implement. Scabies already is most prevalent in low-income areas, so costly interventions are even less feasible. An effective, one-dose vaccine would cost less than these efforts and therefore could be implemented more easily.9
In older adults, scabies more often manifests atypically and is more likely to progress to CS. Aged care centers are prone to institutional outbreaks, even in developed countries, so a vaccine also would greatly help this population. Additionally, the number of children attending day care centers, which also are prone to scabies outbreaks, is increasing. When a child contracts scabies, all close contacts need to be treated, so a preventive vaccine can be useful.9
One potential candidate for a scabies vaccine is total mite extract. Studies show that rabbits immunized with a total mite extract induce antibodies to more antigens than rabbits naturally infested with scabies mites; however, the mites cannot be cultured in vitro, which makes obtaining a large amount of their total extract difficult. Therefore, recombinant vaccines also have been proposed, as they are more easily available.22 One recombinant vaccine candidate is recombinant S scabiei serpin (rSs-serpin). Immunization with rSs-serpin has strong immunogenicity and produced immune protection in rabbits.22
Two other recombinant vaccine candidates are the rSs chitinaselike protein (CLP) 12 and the rSsCLP5. Chitinaselike proteins are very similar to chitinases; however, they are unable to degrade chitin. They are involved in immune reactions to infections, and CLPs from scabies mites have been shown to induce the host immune response.22 For example, in a particular rabbit study, rSsCLP5 demonstrated high immunoreactivity and immunogenicity. In fact, after exposure to S scabiei, 74.3% of rabbits who were vaccinated with rSsCLP5 had no detectable lesions.5 Also, after immunization with rSsCLP5 and rSsCLP12, there were increased levels of specific IgG and IgE antibodies produced and decreased numbers of infesting mites.22 Weight loss also is associated with severe scabies infection. Rabbits vaccinated with rSsCLP5 and exposed to the parasite gained weight, indicating protection via rSsCLP5. Even rabbits who did develop symptoms of scabies after immunization with rSsCLP5 and exposure to S scabiei showed less serious manifestations.5
A combination vaccine cocktail of rSs-serpin, rSsCLP12, and rSsCLP5 also has been proposed by Shen et al.22 Four test groups and a control group (n=12 per group) were included in a vaccine trial. Between 83.33% and 91.67% of rabbits vaccinated with this mixed recombinant cocktail vaccine had no detectable skin lesions from scabies. After immunization with the cocktail vaccine, the specific serum IgG and IgE antibodies also increased. For both IgG and IgE, increased levels were first detected at 1 week postimmunization and peaked at 2 weeks postimmunization.22 A multiepitope vaccine derived from these 3 recombinant proteins also was explored by Shen et al22; fewer rabbits vaccinated with it had no detectable scabies skin lesions compared to those treated with the vaccine cocktail. Although the multiepitope vaccine yielded less immume protection, it was associated with a slower disease course and milder symptoms compared with no vaccination.22
Two more proposed scabies recombinant vaccine candidates are derived from the antigens Ssag1 and Ssag2; however, rabbits vaccinated with Ssag1 or Ssag2 showed no immune protection or mite burden reduction.22 The lack of protection could be due to denaturation or degradation of the protective antigens. It also can be due to the low abundance of these antigens, meaning they may not be vital for the mite’s survival—survival—a potential avenue for future research. The antigens also could have lost their native structure and immunogenic properties during the purification and production process. Therefore, more research is needed to investigate how to purify these vaccines to keep the peptides more structurally similar to their native makeups.10 More research also is needed to better understand the antigen or antigens and their mechanisms that elicit a protective immune response.9
Final Thoughts
Scabies causes severe pruritus in mild cases but also can lead to severe disfigurement, sepsis, and even death. Scabies infestations are seen disproportionately more often in low-income and resource-poor communities, and the current treatment options are less accessible to these populations. Scabies infestations induce a complex immune response that involves multiple aspects of both the innate and adaptive immune systems and can be targeted to create a scabies vaccine. Development of a scabies vaccine is crucial considering the growing resistance to current standard treatments. Acaricides potentially are associated with an increased risk for malignancy, which further amplifies the need for a scabies vaccine. There currently are multiple promising scabies vaccine candidates; however, more research is needed to better understand the host’s immune response to scabies as well as how to more accurately and efficiently produce the vaccine. The development of a safe, effective, economical vaccine that can be mass distributed would be beneficial in the treatment of scabies, especially in resource-poor communities.
The scabies mite, originally known as Acarus scabiei,1 now is considered an arthropod of the class Arachnida, order Astigmata, and family Sarcoptidae.2 Scabies mites are able to adhere to the surface of human skin.3 The mites burrow and lay eggs in the top layer of the epidermis; most patients have 10 to 15 mites.3 The patient’s immune system incites an allergic reaction to the mite protein and feces in the skin, causing itching and rash.4
Scabies is common in indigenous populations and in low-income areas of developing countries.5 It is most prevalent in Africa, South America, Australia, and Southeast Asia, in part due to poverty, poor nutritional status, homelessness, and inadequate hygiene.2 In 2009, the World Health Organization declared scabies a neglected skin disease2; however, in 2010, 1.5 million disability adjusted life-years were attributed to scabies,6 and it is estimated that 200 million people worldwide have scabies at any given time. Children and elderly individuals in resource-poor communities are the most at risk. In fact, 5% to 50% of children in low-income areas have scabies.4
The purpose of this article is to provide background on scabies and its effect on the human immune system. We also discuss manipulation of the immune response for the purposes of creating a potential scabies vaccine.
Life Cycle and Transmission
The life cycle of Sarcoptes scabiei consists of 4 stages. The first is the egg. As female scabies mites burrow under the skin, they lay 2 to 3 ovular eggs per day.3 The second stage is the larva. When the egg hatches, the larva has 3 pairs of legs and travels to the surface of the skin where it burrows into the stratum corneum, creating short, nearly invisible burrows called molting pouches. After 3 to 4 days, the larva molts into a nymph, which is the third stage. The nymph has 4 pairs of legs and will continue to grow before molting into an adult, which is the fourth stage. Both the larva and nymph may be found in hair follicles or molting pouches. The fourth stage is the adult, which is round and saclike and does not have eyes. Adult females are 0.30 mm to 0.45 mm long and 0.25 mm to 0.35 mm wide, which is half the size of adult males.3 On warm skin, the female mite can crawl at a rate of 2.5 cm per minute.7
Scabies mites mate via an active male penetrating the molting pouch of a female. This only occurs once but leaves the female fertile for the rest of her life. Once a female is pregnant, she leaves her molting pouch and travels along the surface of the skin looking for a place to make her permanent burrow.3 The most common sites for scabies burrows are the axillae, umbilicus, interdigital spaces, beltline, buttocks, flexor surfaces of the wrists, female nipples, and male penile shaft.5 Once she finds an acceptable location, the female scabies mite will create a serpentine burrow and lay her eggs. Once she burrows, she will stay there and continue to lay eggs for the rest of her life, lengthening the burrow as needed.3 Female mites lay their eggs in the superficial epidermis, and the eggs take approximately 2 to 3 weeks to hatch. Female mites die 30 to 60 days later.2
Scabies infestations typically spread via the transfer of pregnant adult females during skin-to-skin contact, but they also can spread via fomites.3 During all stages of their life cycle, scabies mites can secrete enzymes that allow them to penetrate the intact epidermis in less than 30 minutes; in fact, an otherwise healthy patient with scabies must have 15 to 20 minutes of close skin-to-skin contact with an infected individual for the disease to be transmitted.7 Because scabies mites can survive for more than 3 days outside the human body, it is thought that fomites also may be involved in transmission. Scabies mites also have been collected from clothing, bedding, and furniture, which further supports the idea that fomites are involved in disease transmission.7
Clinical Manifestation of Scabies
Scabies symptoms include severe pruritus as well as linear burrows and vesicles in the interdigital spaces on the hands, wrists, arms and legs, and lower abdomen. Infants and young children also can develop a rash on the palms, soles, ankles, and scalp. Men can develop inflammatory scabies nodules on the penis and scrotum, while women can develop these nodules on the nipple.4 Type I and type IV hypersensitivity reactions contribute to the rash and itching associated with scabies infestation via host allergic and inflammatory reactions to the mites and their byproducts. Patients with scabies typically are infested with fewer than 15 mites,6 but just a few can cause substantial pruritus and scratching, leading to hyperkeratosis.8
Additionally, when patients with scabies scratch the skin, they become vulnerable to bacterial infections.4 Scabies lesions can be coinfected with group A streptococci and Staphylococcus aureus,8 potentially leading to abscesses and septicemia. These secondary infections also can cause renal and cardiac complications; in fact, in tropical areas, scabies infections are considered a risk factor for kidney disease and rheumatic heart disease.4
The 2 main forms of scabies infestations are ordinary and crusted. The most common form is ordinary scabies, which typically manifests with fewer than 15 mites per patient; crusted scabies (CS) is the more rare and extreme form.6 Cases of CS present with thousands to millions of mites per patient, leading to more widespread and severe symptoms.4 Because of the large increase in the number of mites, CS is more contagious than ordinary scabies.6
Patients with CS typically present with hyperkeratotic skin disease, as evidenced by thick scaly crusts with large numbers of mites, which can lead to permanent skin disfiguration. Patients with CS also can develop deep fissuring of the crusts, within which other microbes can gain entry to the body and lead to secondary infection and possibly sepsis and death. Also, because of the increased number of mites as well as the crusted skin, patients with CS are contagious for longer. As it is more difficult to eradicate, reinfestation is common with CS.6
Patients with compromised immune systems are predisposed to CS. Specifically, patients with HIV or human T-lymphotropic virus 1 or those undergoing organ transplantation are thought to be the most at risk for CS.6 Crusted scabies also has been identified in large numbers in patients with Down syndrome and in Aboriginal Australians; however, the reasoning for this is poorly understood.6
Immune Response
The inflammatory reaction associated with scabies infestations occurs 4 to 6 weeks after initial exposure. It is hypothesized that scabies can alter parts of the host immune system, which contributes to the delayed onset of symptoms. Scabies mites also produce inactivated protease paralogues and serpins, which help to protect the mites from the host immune system by inhibiting the complement system.6
The complement system is part of the innate immune response and is the first line of defense against pathogens. Specifically with scabies infestations, C3 and C4 complement components have been found in skin lesions.6 C3a and C4a fragments cause local inflammation, while C3a and C5a activate mast cells to release histamine and tumor necrosis factor (TNF) α, further amplifying the inflammatory response; however, CS lesions show low C3 and C4, which can indicate immunodeficiency in patients with CS. It also can be due to the sheer number of mites in a CS infection causing the host immune system to be overloaded.6
Innate effector immune cells also are an important part of the innate immune response to scabies; for example, eosinophilia is seen in scabies infections. Specifically, in CS, eosinophils help modulate and sustain the T-helper (Th) 2 inflammatory response. One cytokine secreted by Th2 cells is IL-5, which is closely associated with the attraction, maturation, and survival of eosinophils.6 Eosinophils also can influence the Th1 inflammatory response in that they produce IL-12, interferon (IFN) γ, and several Toll-like receptors. Furthermore, eosinophilic expression of IL-2 can lead to expansion of regulatory T cells, while eosinophilic expression of IL-10 and transforming growth factor (TGF) Β also can suppress local inflammation by influencing regulatory T cells.6
Additionally, mast cells and basophils are important in the IgE-mediated allergic reaction as well as the host immune response to parasites. When activated, basophils and mast cells produce TNF-α, IL-6, Il-4, IL-5, and IL-13, which contribute to the Th2 inflammatory response; however, the role of mast cells and basophils in scabies infections still is poorly understood.6
Macrophages, neutrophils, and dendritic cells (DCs) contribute to phagocytosis, antigen presentation, and differentiation of T cells, which also contribute to the inflammatory and allergic reactions associated with parasitic infections.6 Macrophages have been found in low numbers in scabies infestation, possibly due to immune-modulating molecules secreted by scabies mites. Early in an infestation, the mites secrete immune-modulating molecules, which inhibit macrophage migration to the site of inflammation, allowing the mites to grow.6 Neutrophils and DCs also are involved in the host immune response to scabies. Neutrophils are the predominant inflammatory cell infiltrate in scabies lesions. The scabies protein SMSB4 inhibits neutrophil opsonization and phagocytosis, thus suppressing bacterial killing.6 Some of the first antigen-presenting cells encountered by the antigen are DCs. They are involved in preparing the antigens for presentation to effector T cells, which leads to T-cell differentiation and activation.6
Cytokines are another important factor in the innate immune response. The host immune response to ordinary scabies is Th1-cell mediated, during which CD4+ and CD8+ T cells secrete IFN-γ, TNF-α, and IL-2.6 Therefore, IFN- γ and TNF-α are elevated in the serum of patients with ordinary scabies. Conversely, the host immune response to CS is Th2-cell mediated. T-helper 2 cells are needed in IgE-mediated hypersensitivity reactions, and they secrete IL-4, IL-5, and IL-13. In the serum of patients with CS, IL-l4, IL-5, and IL-13 are elevated while IFN-γ is decreased.6 Additionally, IL-6, TGF-Β, IL-23, IL-1Β, or IL-18 can induce Th17 cells to generate and secrete IL-17, which enhances the inflammatory response by inducing further expression of TNF-α, IL-1Β, IL-6, keratinocytes, and fibroblasts. T-helper 17 and IL-17 also are involved in psoriasis and atopic dermatitis, as well as Leishmania major and Schistosoma japonicum.6
Regulatory T cells Tregs secrete TGF-Β and IL-10, which suppress pathologic inflammation, and IL-10 is substantially reduced in patients with CS compared to those with ordinary scabies and uninfected control patients. Additionally, IL-10 can inhibit the synthesis of TNF-γ and IFN-α. Reduced IL-10 expression can lead to proliferation of IL-17 secretion, resulting in a regulatory T cell/Th17 dysfunctional immune response.6
Immunoglobulins are antibodies that are involved in the host’s adaptive immune response. The first antibody to appear in response to an antigen is IgM, and IgM bound to scabies antigens is present in 74%6 of patients with ordinary scabies. Because IgM is the first antibody to appear in response to a scabies infection, detection of serum IgM may allow for earlier detection of scabies; however, IgM has a high cross-reactivity between scabies mites and dust mites, which can hinder scabies diagnosis via IgM detection.6
Both patients with ordinary scabies and CS also show an increased circulatory IgG concentration compared to control groups; patients with CS have higher concentrations. Increased IgG also can be in part due to concurrent bacterial infections.6 When IgG or IgM antibodies bind to a pathogen, they activate the complement cascade, which further enhances the activity of these antibodies.9
Additionally, IgA is important in mucosal immune function. In both patients with ordinary scabies and CS, there is increased IgA binding to recombinant scabies mite antigens.6Sarcoptes scabiei proteases that are localized in the mite’s gut and scybala suggest their involvement in mite digestion and burrowing. The increased secretion of these proteases into the host skin may contribute to the increased IgA,9 and these increased IgA levels have been shown to be positively correlated with severity of scabies infection.6
Also essential in allergic and parasitic inflammation, IgE is observed at higher levels in secondary infections of scabies compared to primary infections.6 Additionally, T-cell infiltrates are implicated in adaptive immune response to scabies. CD4+ T cells are the most prevalent T cells in ordinary scabies skin lesions; however, CD4+ T cells are minimal and CD8+ T cells are elevated in CS skin lesions. The increased CD8+ T cells may cause apoptosis of keratinocytes, leading to epidermal hyperproliferation. The apoptotic keratinocytes can secrete cytokines, which can lead to tissue damage.6 These T cells also may be involved in the failure of the skin’s immune system to mount an effective response to the parasite infestation, leading to uncontrolled parasitic growth. Because patients with AIDS who are infected with scabies mites often develop CS, it is also thought that CD4+ T cells are essential in the immune response to scabies.6
Diagnosis and Current Treatment Options
Current diagnosis of scabies is based on mites, eggs, and fecal matter from the host’s skin. Dermoscopy and fluorescent dermoscopy can be helpful in identifying the mites, eggs, and feces on the patient’s skin. Scabies treatment sometimes may be based solely on symptoms without any positive tests.8
Acaricides are the current method of treatment for scabies infestations.5 Acaricides can be expensive and toxic to the environment and food sources,10 and some agents have been associated with neurotoxicity5 in children or the development of certain cancers.11 Although topical acaricides are the standard form of treatment, oral ivermectin also can be used. Ivermectin is not associated with selective fetal toxicity, but there are limited safety data in pregnant women and in children weighing less than 15 kg (33 lb). Additionally, because symptoms typically are not present during an early infection, treating everyone in the household and those who had close contact with the patient can help prevent reinfection.4
Although these drugs have been shown to be effective at treating scabies, scabies mites are becoming increasingly resistant to acaricides.5 There are 4 main proposed mechanisms for why this occurs.12 The first is through voltage-gated sodium channels, which are involved in the normal functioning of neurons and myocytes. Permethrin, a type of acaricide, binds to voltage-gated sodium channels when it is in an open or active state and prevents it from closing. This creates repetitive neuron firing and hyperactivity, which ultimately kills the scabies mite. Some mites have mutated to close this channel, which reduces the binding potential of permethrin. Glutathione S-transferase is another mechanism of resistance. It catalyzes a bond that tags drugs for elimination. Increased activity or expressivity of glutathione S-transferase by scabies mites can lead to drug resistance.12 Adenosine triphosphate– binding cassette (ABC) transporters also may contribute to this resistance. The ABC transporters use adenosine triphosphate to facilitate the import or export of molecules. Scabies mites express a protein called the multidrug-resistant protein, which is an ABC transporter that is associated with drug resistance and is present in scabies mites.12 Lastly, ligand-gated chloride channels have been implicated in scabies resistance to acaricides. Ligand-gated chloride channels also are important in normal functioning of neurons and myocytes. Some antiparasitic drugs act on these channels, leading to a continuous influx of chloride, but some scabies mites have mutated this pathway.12
Pesticides and the Risk for Cancer
Pesticides commonly are used to treat scabies; however, a link between pesticide exposure and leukemia and lymphoma has been seen through epidemiologic studies, and there also is increasing biological evidence to suggest this.11 For example, the pesticide permethrin, which works by paralyzing the nervous system of insects,13 has been associated with an increased risk for leukemia and lymphoma in humans. Permethrin is a pyrethroid and, compared to control patients, children with leukemia had higher levels of pyrethroid metabolites in their blood.14 Numerical and structural chromosomal aberrations that give rise to gene fusions are the most common abnormalities seen in leukemia, and permethrin has been shown to induce DNA breaks, chromosome aberrations, and sister chromatid exchanges.14 Permethrin also has been associated with an increased risk for multiple myeloma.13
Furthermore, in utero exposure to pesticides has been associated with an increased risk for childhood leukemia.15 Pesticide exposure shortly before conception, during pregnancy, and after birth is associated with an increased risk for acute lymphocytic leukemia.16 In fact, the children of mothers who were exposed to pesticides 3 months before conception have been found to be at least twice as likely to be diagnosed with acute lymphocytic leukemia within the first year of life compared with children whose mothers were not exposed to pesticides.17 It is hypothesized that permethrin can cross the placenta and alter the hematopoietic precursor cells in the fetus, resulting in leukemogenesis.18 Pyrethroid metabolites also have been detected in umbilical cord blood samples and breast milk.15
In contrast to the research demonstrating a link between permethrin and cancer, other studies have found no association between permethrin19 and leukemia20; non-Hodgkin lymphoma19; or cancers of the colon, rectum, pancreas, lungs, skin, female breast, prostate, and urinary bladder.20 Because of conflicting research on the link between permethrin and cancer, more research is needed.,20
Importance of a Scabies Vaccine
Because scabies mites are developing increasing treatment resistance, more radical approaches such as vaccines are becoming important. While a scabies vaccine is still aspirational, animals that have been infected for a second time with scabies demonstrate a milder response to the second infection compared to the first infection, which could mean there is a potential for disease prevention through a vaccine.21 While educating patients and physicians, reporting cases of infection, and improving drug supply and access can help decrease scabies infestations, these are costly and difficult to implement. Scabies already is most prevalent in low-income areas, so costly interventions are even less feasible. An effective, one-dose vaccine would cost less than these efforts and therefore could be implemented more easily.9
In older adults, scabies more often manifests atypically and is more likely to progress to CS. Aged care centers are prone to institutional outbreaks, even in developed countries, so a vaccine also would greatly help this population. Additionally, the number of children attending day care centers, which also are prone to scabies outbreaks, is increasing. When a child contracts scabies, all close contacts need to be treated, so a preventive vaccine can be useful.9
One potential candidate for a scabies vaccine is total mite extract. Studies show that rabbits immunized with a total mite extract induce antibodies to more antigens than rabbits naturally infested with scabies mites; however, the mites cannot be cultured in vitro, which makes obtaining a large amount of their total extract difficult. Therefore, recombinant vaccines also have been proposed, as they are more easily available.22 One recombinant vaccine candidate is recombinant S scabiei serpin (rSs-serpin). Immunization with rSs-serpin has strong immunogenicity and produced immune protection in rabbits.22
Two other recombinant vaccine candidates are the rSs chitinaselike protein (CLP) 12 and the rSsCLP5. Chitinaselike proteins are very similar to chitinases; however, they are unable to degrade chitin. They are involved in immune reactions to infections, and CLPs from scabies mites have been shown to induce the host immune response.22 For example, in a particular rabbit study, rSsCLP5 demonstrated high immunoreactivity and immunogenicity. In fact, after exposure to S scabiei, 74.3% of rabbits who were vaccinated with rSsCLP5 had no detectable lesions.5 Also, after immunization with rSsCLP5 and rSsCLP12, there were increased levels of specific IgG and IgE antibodies produced and decreased numbers of infesting mites.22 Weight loss also is associated with severe scabies infection. Rabbits vaccinated with rSsCLP5 and exposed to the parasite gained weight, indicating protection via rSsCLP5. Even rabbits who did develop symptoms of scabies after immunization with rSsCLP5 and exposure to S scabiei showed less serious manifestations.5
A combination vaccine cocktail of rSs-serpin, rSsCLP12, and rSsCLP5 also has been proposed by Shen et al.22 Four test groups and a control group (n=12 per group) were included in a vaccine trial. Between 83.33% and 91.67% of rabbits vaccinated with this mixed recombinant cocktail vaccine had no detectable skin lesions from scabies. After immunization with the cocktail vaccine, the specific serum IgG and IgE antibodies also increased. For both IgG and IgE, increased levels were first detected at 1 week postimmunization and peaked at 2 weeks postimmunization.22 A multiepitope vaccine derived from these 3 recombinant proteins also was explored by Shen et al22; fewer rabbits vaccinated with it had no detectable scabies skin lesions compared to those treated with the vaccine cocktail. Although the multiepitope vaccine yielded less immume protection, it was associated with a slower disease course and milder symptoms compared with no vaccination.22
Two more proposed scabies recombinant vaccine candidates are derived from the antigens Ssag1 and Ssag2; however, rabbits vaccinated with Ssag1 or Ssag2 showed no immune protection or mite burden reduction.22 The lack of protection could be due to denaturation or degradation of the protective antigens. It also can be due to the low abundance of these antigens, meaning they may not be vital for the mite’s survival—survival—a potential avenue for future research. The antigens also could have lost their native structure and immunogenic properties during the purification and production process. Therefore, more research is needed to investigate how to purify these vaccines to keep the peptides more structurally similar to their native makeups.10 More research also is needed to better understand the antigen or antigens and their mechanisms that elicit a protective immune response.9
Final Thoughts
Scabies causes severe pruritus in mild cases but also can lead to severe disfigurement, sepsis, and even death. Scabies infestations are seen disproportionately more often in low-income and resource-poor communities, and the current treatment options are less accessible to these populations. Scabies infestations induce a complex immune response that involves multiple aspects of both the innate and adaptive immune systems and can be targeted to create a scabies vaccine. Development of a scabies vaccine is crucial considering the growing resistance to current standard treatments. Acaricides potentially are associated with an increased risk for malignancy, which further amplifies the need for a scabies vaccine. There currently are multiple promising scabies vaccine candidates; however, more research is needed to better understand the host’s immune response to scabies as well as how to more accurately and efficiently produce the vaccine. The development of a safe, effective, economical vaccine that can be mass distributed would be beneficial in the treatment of scabies, especially in resource-poor communities.
- Arlian LG, Morgan MS. A review of Sarcoptes scabiei: past, present and future. Parasit Vectors. 2017;10:297. doi:10.1186/s13071-017-2234-1
- Murray RL, Crane JS. Scabies. In: StatPearls. StatPearls Publishing. Updated July 31, 2023.
- Centers for Disease Control and Prevention. CDC—scabies—biology. November 2, 2010. https://www.cdc.gov/dpdx/scabies/index.html
- World Health Organization. Scabies. May 31, 2023. Accessed May 8, 2025. https://www.who.int/news-room/fact-sheets/detail/scabies
- Shen N, Zhang H, Ren Y, et al. A chitinase-like protein from Sarcoptes scabiei as a candidate anti-mite vaccine that contributes to immune protection in rabbits. Parasit Vectors. 2018;11:599. doi:10.1186/s13071- 018-3184-y
- Bhat SA, Mounsey KE, Liu X, et al. Host immune responses to the itch mite, Sarcoptes scabiei, in humans. Parasit Vectors. 2017;10:385. doi:10.1186/s13071-017-2320-4
- Hicks MI, Elston DM. Scabies. Dermatolog Ther. 2009;22:279-292. doi:10.1111/j.1529-8019.2009.01243.x
- Morgan MS, Arlian LG, Rider SD, et al. A proteomic analysis of Sarcoptes scabiei (acari: Sarcoptidae). J Med Entomol. 2016;53:553-561. doi:10.1093/jme/tjv247
- Liu X, Walton S, Mounsey K. Vaccine against scabies: necessity and possibility. Parasitology. 2014;141:725-732. doi:10.1017 /s0031182013002047
- Casais R, Granda V, Balseiro A, et al. Vaccination of rabbits with immunodominant antigens from Sarcoptes scabiei induced high levels of humoral responses and pro-inflammatory cytokines but confers limited protection. Parasit Vectors. 2016;9:435. doi:10.1186 /s13071-016-1717-9?
- Navarrete-Meneses MP, Pedraza-Meléndez AI, Salas-Labadía C, et al. Low concentrations of permethrin and malathion induce numerical and structural abnormalities in KMT2A and IGH genes in vitro. J Appl Toxicol. 2018;38:1262-1270. doi:10.1002/jat.3638
- Khalil S, Abbas O, Kibbi AG, et al. Scabies in the age of increasing drug resistance. PLoS Negl Trop Dis. 2017;11:E0005920. doi:10.1371 /journal.pntd.0005920
- Rusiecki JA, Patel R, Koutros S, et al. Cancer incidence among pesticide applicators exposed to permethrin in the Agricultural Health Study. Environ Health Perspect. 2009;117:581-586. doi:10.1289 /ehp.11318
- Navarrete-Meneses MP, Salas-Labadía C, Sanabrais-Jiménez M, et al. Exposure to the insecticides permethrin and malathion induces leukemia and lymphoma-associated gene aberrations in vitro. Toxicol In Vitro. 2017;44:17-26. doi:10.1016/j.tiv.2017.06.013
- Navarrete-Meneses MDP, Pérez-Vera P. Pyrethroid pesticide exposure and hematological cancer: epidemiological, biological and molecular evidence. Rev Environ Health. 2019;34:197-210. doi:10.1515 /reveh-2018-0070
- Madrigal JM, Jones RR, Gunier RB, et al. Residential exposure to carbamate, organophosphate, and pyrethroid insecticides in house dust and risk of childhood acute lymphoblastic leukemia. Environ Res. 2021;201:111501. doi:10.1016/j.envres.2021.111501
- Ferreira JD, Couto AC, Pombo-de-Oliveira MS, et al. In utero pesticide exposure and leukemia in Brazilian children <2 years of age. Environ Health Perspect. 2013;121:269-275. doi:10.1289/ehp.1103942
- Borkhardt A, Wilda M, Fuchs U, et al. Congenital leukaemia after heavy abuse of permethrin during pregnancy. Arch Dis Child Fetal Neonatal Ed. 2003;88:F436-F437. doi:10.1136/fn.88.5.f436
- De Roos AJ, Schinasi LH, Miligi L, et al. Occupational insecticide exposure and risk of non]Hodgkin lymphoma: a pooled case]control study from the InterLymph consortium. Int J Cancer. 2021;149:1768-1786. doi:10.1002/ijc.33740
- Boffett, P, Desai V. Exposure to permethrin and cancer risk: a systematic review. Crit Rev Toxicol. 2018;48:433-442. doi:10.1080/1040 8444.2018.1439449
- Adji A, Rumokoy LJM, Salaki CL. Scabies vaccine as a new breakthrough for the challenge of acaricides resistance. Adv Biolog Sci Res. 2020;8:208-213. doi:10.2991/absr.k.200513.036
- Shen N, Wei W, Chen Y, et al. Vaccination with a cocktail vaccine elicits significant protection against Sarcoptes scabiei in rabbits, whereas the multi-epitope vaccine offers limited protection. Exp Parasitol. 2023;245:108442. doi:10.1016/j.exppara.2022.108442
- Arlian LG, Morgan MS. A review of Sarcoptes scabiei: past, present and future. Parasit Vectors. 2017;10:297. doi:10.1186/s13071-017-2234-1
- Murray RL, Crane JS. Scabies. In: StatPearls. StatPearls Publishing. Updated July 31, 2023.
- Centers for Disease Control and Prevention. CDC—scabies—biology. November 2, 2010. https://www.cdc.gov/dpdx/scabies/index.html
- World Health Organization. Scabies. May 31, 2023. Accessed May 8, 2025. https://www.who.int/news-room/fact-sheets/detail/scabies
- Shen N, Zhang H, Ren Y, et al. A chitinase-like protein from Sarcoptes scabiei as a candidate anti-mite vaccine that contributes to immune protection in rabbits. Parasit Vectors. 2018;11:599. doi:10.1186/s13071- 018-3184-y
- Bhat SA, Mounsey KE, Liu X, et al. Host immune responses to the itch mite, Sarcoptes scabiei, in humans. Parasit Vectors. 2017;10:385. doi:10.1186/s13071-017-2320-4
- Hicks MI, Elston DM. Scabies. Dermatolog Ther. 2009;22:279-292. doi:10.1111/j.1529-8019.2009.01243.x
- Morgan MS, Arlian LG, Rider SD, et al. A proteomic analysis of Sarcoptes scabiei (acari: Sarcoptidae). J Med Entomol. 2016;53:553-561. doi:10.1093/jme/tjv247
- Liu X, Walton S, Mounsey K. Vaccine against scabies: necessity and possibility. Parasitology. 2014;141:725-732. doi:10.1017 /s0031182013002047
- Casais R, Granda V, Balseiro A, et al. Vaccination of rabbits with immunodominant antigens from Sarcoptes scabiei induced high levels of humoral responses and pro-inflammatory cytokines but confers limited protection. Parasit Vectors. 2016;9:435. doi:10.1186 /s13071-016-1717-9?
- Navarrete-Meneses MP, Pedraza-Meléndez AI, Salas-Labadía C, et al. Low concentrations of permethrin and malathion induce numerical and structural abnormalities in KMT2A and IGH genes in vitro. J Appl Toxicol. 2018;38:1262-1270. doi:10.1002/jat.3638
- Khalil S, Abbas O, Kibbi AG, et al. Scabies in the age of increasing drug resistance. PLoS Negl Trop Dis. 2017;11:E0005920. doi:10.1371 /journal.pntd.0005920
- Rusiecki JA, Patel R, Koutros S, et al. Cancer incidence among pesticide applicators exposed to permethrin in the Agricultural Health Study. Environ Health Perspect. 2009;117:581-586. doi:10.1289 /ehp.11318
- Navarrete-Meneses MP, Salas-Labadía C, Sanabrais-Jiménez M, et al. Exposure to the insecticides permethrin and malathion induces leukemia and lymphoma-associated gene aberrations in vitro. Toxicol In Vitro. 2017;44:17-26. doi:10.1016/j.tiv.2017.06.013
- Navarrete-Meneses MDP, Pérez-Vera P. Pyrethroid pesticide exposure and hematological cancer: epidemiological, biological and molecular evidence. Rev Environ Health. 2019;34:197-210. doi:10.1515 /reveh-2018-0070
- Madrigal JM, Jones RR, Gunier RB, et al. Residential exposure to carbamate, organophosphate, and pyrethroid insecticides in house dust and risk of childhood acute lymphoblastic leukemia. Environ Res. 2021;201:111501. doi:10.1016/j.envres.2021.111501
- Ferreira JD, Couto AC, Pombo-de-Oliveira MS, et al. In utero pesticide exposure and leukemia in Brazilian children <2 years of age. Environ Health Perspect. 2013;121:269-275. doi:10.1289/ehp.1103942
- Borkhardt A, Wilda M, Fuchs U, et al. Congenital leukaemia after heavy abuse of permethrin during pregnancy. Arch Dis Child Fetal Neonatal Ed. 2003;88:F436-F437. doi:10.1136/fn.88.5.f436
- De Roos AJ, Schinasi LH, Miligi L, et al. Occupational insecticide exposure and risk of non]Hodgkin lymphoma: a pooled case]control study from the InterLymph consortium. Int J Cancer. 2021;149:1768-1786. doi:10.1002/ijc.33740
- Boffett, P, Desai V. Exposure to permethrin and cancer risk: a systematic review. Crit Rev Toxicol. 2018;48:433-442. doi:10.1080/1040 8444.2018.1439449
- Adji A, Rumokoy LJM, Salaki CL. Scabies vaccine as a new breakthrough for the challenge of acaricides resistance. Adv Biolog Sci Res. 2020;8:208-213. doi:10.2991/absr.k.200513.036
- Shen N, Wei W, Chen Y, et al. Vaccination with a cocktail vaccine elicits significant protection against Sarcoptes scabiei in rabbits, whereas the multi-epitope vaccine offers limited protection. Exp Parasitol. 2023;245:108442. doi:10.1016/j.exppara.2022.108442
Immune Responses and Health Disparities Warrant Scabies Vaccine Development
Immune Responses and Health Disparities Warrant Scabies Vaccine Development
PRACTICE POINTS
- Dermatologists should be aware of the impact scabies has on patients, especially on those in lower socioeconomic groups.
- Physicians and patients should be educated on scabies prevention and treatment to help decrease the spread of scabies infections.
Managing Cutaneous Reactions to Yellow Fly (Diachlorus ferrugatus) Bites
Managing Cutaneous Reactions to Yellow Fly (Diachlorus ferrugatus) Bites
The yellow fly (Diachlorus ferrugatus) is a flying biting insect belonging to the order Diptera, family Tabanidae, which also includes deer flies (genus Chrysops) and horse flies (genus Tabanus).1 They are different from stinging insects of the order Hymenoptera (bees, wasps, yellow jackets, and hornets). As the name suggests, the yellow fly has a distinct yellow appearance, and adult yellow flies have a body length of approximately 1 cm.1,2 Distinguishing features of the yellow fly include prominently dark forelegs (the remaining legs are yellow), dark purple to black eyes with 2 fluorescent green lines, and a yellow abdomen with black hairs along the lateral regions and a broad central yellow stripe.1-3 Their wings have longitudinal black veins with clear spaces in between and a conspicuous brown patch at the apex (Figure 1A). In comparison, horse flies are darker and larger (Figure 1B), and deer flies are similar in shape but have stripes on the abdomen and thorax and mottled wings with dark patches near the apex (Figure 1C).1

The Tabanidae family comprises 4455 species belonging to 137 genera and is notorious for bites that result in localized pain, swelling, itching, and discomfort.4 While some Tabanidae species are mechanical or biologic vectors of pathogens (eg, Loa loa, equine infectious anemia virus, Trypanosoma species, cattle and sheep anthrax and tularemia), yellow flies do not appear to play a considerable role in disease transmission.4,5 Nonetheless, their bites can cause discomfort and create a nuisance for individuals residing within their distribution areas as well as for agricultural livestock, contributing to lower weight gain and milk production.1
Yellow flies are a commonly occurring species in the southeastern United States; their distribution spans several states, including New Jersey, Florida, and Texas.1,2 In Florida, specifically, yellow flies exhibit a seasonal pattern, with peak activity typically occurring from April through June.6-9 Activity levels are heightened around sunset as well as sunrise.1,9 Tabanids can be found in forests, parks, and gardens—particularly those that contain waterways such as freshwater lakes and streams—and typically stay near shaded woodlands that are prone to flooding.9
Tabanids go through the life cycle stages of egg, larva, pupa, and adult; the life cycle typically spans 1 year, with the adults living 30 to 60 days.1 Mating occurs soon after adults emerge from the pupal case in the soil.1,10 Females then are attracted to large dark moving objects and will feed on blood to develop eggs.2,10 Only female members of the Tabanidae family have modifications of the mouth parts that allow wounding of the skin (Figure 2). Their bites introduce saliva to the skin containing anticoagulants and other likely allergens. The tongue is used to lap between 20 to 600 microliters of blood.11 Males feed primarily on pollen and nectar.10 Most tabanid bites result in transient wheal-and-flare reactions, but some can result in more severe allergic reactions such as in our reported case.10 Rarely, anaphylactic reactions have been documented.10,12

Case Report
A 48-year-old man presented with swelling of the left hand following a yellow fly bite to the wrist 30 minutes prior while he worked outside at a ranch in central Florida (Figure 3). The patient was afebrile and reported no respiratory or gastrointestinal symptoms. The left hand and forearm were warm to the touch and appeared red and edematous (Figure 4). He was not tachycardic and did not appear to be in any distress. The patient reported that he had worked on the ranch for several years, and during that time had noted he was developing worsening localized reactions to yellow fly bites. He had visually identified the offending insect prior to the current presentation and had trapped some flies in previous incidents. Recently he had experienced rapid swelling at the bite sites but had never experienced respiratory difficulties or signs of systemic allergic reactions. He previously had used topical steroids when bites resulted in mild wheal-and-flare reactions, but he reported that these were no longer effective.


Management of the current bite reaction included oral prednisone tapered over 1 week from 40 mg to 10 mg daily as well as oral cetirizine 10 mg daily. Although bacterial cellulitis was considered in the differential diagnosis, no oral antibiotics were prescribed given the patient’s history of similar clinical presentations following yellow fly bites. His symptoms resolved within a few hours of his dose of prednisone. Incidentally, our patient has been able to control the progression of subsequent hypersensitivity reactions to yellow fly bites with a single 20-mg dose of prednisone administered at the onset of the bite.
Comment
In general, blood-feeding (hematophagous) insects rarely cause anaphylaxis and are more likely to cause cutaneous hypersensitivity reactions, possibly due to the small amount of antigen injected from a bite.13,14 The immediate wheal-and-flare reaction is an IgE-mediated type 1 immune reaction compared to a less common type 4 T-cell mediated delayed hypersensitivity reaction.14,15 There are many protein allergens in the saliva of biting insects that are not well characterized. Relevant allergens include a 69 kDa salivary gland protein as well as a Tab y 1 (anticoagulant), Tab y 2 (hyaluronidase), and Tab y 5 (antigen 5–related venom protein).11,15-17 Some of these proteins have structural homology between insects of different orders and can cause cross-reactivity in patients who also are allergic to Hymenoptera stings (wasp-horsefly syndrome).12,16
Our patient’s cutaneous reaction was localized and clinically manifested with rapidly progressive erythema and edema at the bite location. He did not exhibit signs of a systemic reaction such as angioedema, respiratory or gastrointestinal symptoms, tachycardia, or hypotension. Management of affected patients depends on the extent of the reaction and may include oral or parenteral antihistamines as well as oral steroids for more severe edema.11 Anaphylactic reactions generally respond to subcutaneous epinephrine.15 It would be prudent for patients with a relevant anaphylactic history to carry an autoinjectable epinephrine pen in case of difficulty breathing or general malaise following a bite. Besides avoidance of insect bites, personal protection methods include wearing long-sleeved shirts and pants and using insect repellents containing diethyl toluamide (DEET), citronella, or geraniol.1
At present, diagnosis of cutaneous reactions to yellow fly bites is best made based on the patient’s personal history.14 If the offending fly is trapped, it can be identified. As most patients cannot differentiate between insects, it may be helpful for dermatologists to know that a small amount of blood at the bite site is suggestive of a fly bite rather than a sting from a member of the order Hymenoptera. Currently, there are no consistently useful extracts for intradermal skin testing.11 Although there are several commercially available serum-specific IgE tests for suspected horse fly reactions, their usefulness is doubtful without further information on sensitivity and specificity as well as the allergen utilized.11,18,19 The use of allergen immunotherapy to induce hyposensitization in patients who experience cutaneous reactions is not standardized and poses some risks including severe allergic reactions requiring facilities for resuscitation, variability of response patterns, and supporting evidence is weak.11
Final Thoughts
Cutaneous reactions to yellow fly bites rarely are described in the dermatology literature. The salivary proteins implicated in inducing an allergic response and cross-reactivity of D ferrugatus with other biting and stinging insects as well as the natural course of immune reactions over time need to be further characterized.
- Squitier JM. Deer flies, yellow flies, and horse flies, Chrysops, Diachlorus and Tabanus spp. (Insecta: Diptera: Tabanidae). University of Florida. Accessed March 11, 2025. https://edis.ifas.ufl.edu/publication/IN155
- Fairchild GB, Weems HB Jr, Fasulo TR. Yellow fly, Diachlorus ferrugatus (Fabricius)(Insecta: Diptera: Tabanidae). University of Florida. Accessed March 11, 2025. https://edis.ifas.ufl.edu/publication/IN595
- Mullens BA. Horse flies and deer flies (Tabanidae). In: Mullen G, Durden L. Med Vet Entomol. Elsevier Science; 2009:327-344.
- Akhoundi M, Sereno D, Marteau A, et al. Who bites me? A tentative discriminative key to diagnose hematophagous ectoparasites biting using clinical manifestations. Diagnostics (Basel). 2020;10:308.
- Cheng TC. General Parasitology. 2nd ed. Elsevier Science; 2021:660.
- Wells K, Varnadoe C, Dorman D, et al. Survey of the distribution and seasonal activity of yellow flies (Diptera: Tabanidae) in Florida, USA. J Vector Ecol. 2019;44:235-242.
- Hribar LJ, Leppla NC, Beshear RJ, et al. Seasonal abundance of Diachlorus ferrugatus (Diptera: Tabanidae) in Monroe County, Florida. Florida Scientist. 2003;66:52-54.
- Fairchild GB, Weems HV. Diachlorus ferrugatus (Fabricius), a fierce biting fly (Diptera: Tabanidae). Florida Department of Agriculture and Consumer Services, Division of Plant Industry. Entomology Circular. 1973;139.
- Cilek JE, Schreiber ET. Diel host-seeking activity of adult Diachlorus ferrugatus (F.) (Diptera: Tabanidae) in Northwestern Florida. J Entomol Sci. 1999;34:462-466.
- Sean S. Tabanids (horseflies). Dermatol Online J. 1999;5:6.
- Whyte AF, Popeseu FD, Carlson J. Tabanidae insect (horsefly and deerfly) allergy in humans: a review of the literature. Clin Exp Allergy. 2020;50:886-893.
- Buonomo A, Rizzi A, Aruanno A, et al. Anaphylaxis after horsefly sting: a strange case of wasp-horsefly syndrome. Postepi Dermatol Alergol. 2021;2:331-332.
- Freye HB, Litwin C. Coexistent anaphylaxis to Diptera and Hymenoptera. Ann Allergy Asthma Immunol. 1996 76:270-272.
- Hemmer W, Wantke F. Insect hypersensitivity beyond bee and wasp venom allergy. Allergol Select. 2020;4:97-104.
- Ewan PW. Allergy to insect stings: a review. J R Soc Med. 1985;78:234-239.
- Ma D, Li Y, Dong J, et al. Purification and characterization of two new allergens from the salivary glands of the horsefly Tabanus yao. Allergy. 2011;66:101-109.
- Hemmer W, Focke M, Vieluf D, et al. Anaphylaxis induced by horsefly bites: identification of a 69 kd IgE-binding protein from Chrysops spp. (Diptera: Tabanidae) by western blot analysis. J Allergy Clin Immunol. 1998;101:134-136.
- Mayo Clinic Laboratories. Test catalog: horse fly. Accessed March 11, 2025. https://www.mayocliniclabs.com/search?q=horse%20fly
- HealthLabs.com. Horsefly allergy test. Accessed March 11, 2025. https://www.healthlabs.com/horsefly-allergy-testing
The yellow fly (Diachlorus ferrugatus) is a flying biting insect belonging to the order Diptera, family Tabanidae, which also includes deer flies (genus Chrysops) and horse flies (genus Tabanus).1 They are different from stinging insects of the order Hymenoptera (bees, wasps, yellow jackets, and hornets). As the name suggests, the yellow fly has a distinct yellow appearance, and adult yellow flies have a body length of approximately 1 cm.1,2 Distinguishing features of the yellow fly include prominently dark forelegs (the remaining legs are yellow), dark purple to black eyes with 2 fluorescent green lines, and a yellow abdomen with black hairs along the lateral regions and a broad central yellow stripe.1-3 Their wings have longitudinal black veins with clear spaces in between and a conspicuous brown patch at the apex (Figure 1A). In comparison, horse flies are darker and larger (Figure 1B), and deer flies are similar in shape but have stripes on the abdomen and thorax and mottled wings with dark patches near the apex (Figure 1C).1

The Tabanidae family comprises 4455 species belonging to 137 genera and is notorious for bites that result in localized pain, swelling, itching, and discomfort.4 While some Tabanidae species are mechanical or biologic vectors of pathogens (eg, Loa loa, equine infectious anemia virus, Trypanosoma species, cattle and sheep anthrax and tularemia), yellow flies do not appear to play a considerable role in disease transmission.4,5 Nonetheless, their bites can cause discomfort and create a nuisance for individuals residing within their distribution areas as well as for agricultural livestock, contributing to lower weight gain and milk production.1
Yellow flies are a commonly occurring species in the southeastern United States; their distribution spans several states, including New Jersey, Florida, and Texas.1,2 In Florida, specifically, yellow flies exhibit a seasonal pattern, with peak activity typically occurring from April through June.6-9 Activity levels are heightened around sunset as well as sunrise.1,9 Tabanids can be found in forests, parks, and gardens—particularly those that contain waterways such as freshwater lakes and streams—and typically stay near shaded woodlands that are prone to flooding.9
Tabanids go through the life cycle stages of egg, larva, pupa, and adult; the life cycle typically spans 1 year, with the adults living 30 to 60 days.1 Mating occurs soon after adults emerge from the pupal case in the soil.1,10 Females then are attracted to large dark moving objects and will feed on blood to develop eggs.2,10 Only female members of the Tabanidae family have modifications of the mouth parts that allow wounding of the skin (Figure 2). Their bites introduce saliva to the skin containing anticoagulants and other likely allergens. The tongue is used to lap between 20 to 600 microliters of blood.11 Males feed primarily on pollen and nectar.10 Most tabanid bites result in transient wheal-and-flare reactions, but some can result in more severe allergic reactions such as in our reported case.10 Rarely, anaphylactic reactions have been documented.10,12

Case Report
A 48-year-old man presented with swelling of the left hand following a yellow fly bite to the wrist 30 minutes prior while he worked outside at a ranch in central Florida (Figure 3). The patient was afebrile and reported no respiratory or gastrointestinal symptoms. The left hand and forearm were warm to the touch and appeared red and edematous (Figure 4). He was not tachycardic and did not appear to be in any distress. The patient reported that he had worked on the ranch for several years, and during that time had noted he was developing worsening localized reactions to yellow fly bites. He had visually identified the offending insect prior to the current presentation and had trapped some flies in previous incidents. Recently he had experienced rapid swelling at the bite sites but had never experienced respiratory difficulties or signs of systemic allergic reactions. He previously had used topical steroids when bites resulted in mild wheal-and-flare reactions, but he reported that these were no longer effective.


Management of the current bite reaction included oral prednisone tapered over 1 week from 40 mg to 10 mg daily as well as oral cetirizine 10 mg daily. Although bacterial cellulitis was considered in the differential diagnosis, no oral antibiotics were prescribed given the patient’s history of similar clinical presentations following yellow fly bites. His symptoms resolved within a few hours of his dose of prednisone. Incidentally, our patient has been able to control the progression of subsequent hypersensitivity reactions to yellow fly bites with a single 20-mg dose of prednisone administered at the onset of the bite.
Comment
In general, blood-feeding (hematophagous) insects rarely cause anaphylaxis and are more likely to cause cutaneous hypersensitivity reactions, possibly due to the small amount of antigen injected from a bite.13,14 The immediate wheal-and-flare reaction is an IgE-mediated type 1 immune reaction compared to a less common type 4 T-cell mediated delayed hypersensitivity reaction.14,15 There are many protein allergens in the saliva of biting insects that are not well characterized. Relevant allergens include a 69 kDa salivary gland protein as well as a Tab y 1 (anticoagulant), Tab y 2 (hyaluronidase), and Tab y 5 (antigen 5–related venom protein).11,15-17 Some of these proteins have structural homology between insects of different orders and can cause cross-reactivity in patients who also are allergic to Hymenoptera stings (wasp-horsefly syndrome).12,16
Our patient’s cutaneous reaction was localized and clinically manifested with rapidly progressive erythema and edema at the bite location. He did not exhibit signs of a systemic reaction such as angioedema, respiratory or gastrointestinal symptoms, tachycardia, or hypotension. Management of affected patients depends on the extent of the reaction and may include oral or parenteral antihistamines as well as oral steroids for more severe edema.11 Anaphylactic reactions generally respond to subcutaneous epinephrine.15 It would be prudent for patients with a relevant anaphylactic history to carry an autoinjectable epinephrine pen in case of difficulty breathing or general malaise following a bite. Besides avoidance of insect bites, personal protection methods include wearing long-sleeved shirts and pants and using insect repellents containing diethyl toluamide (DEET), citronella, or geraniol.1
At present, diagnosis of cutaneous reactions to yellow fly bites is best made based on the patient’s personal history.14 If the offending fly is trapped, it can be identified. As most patients cannot differentiate between insects, it may be helpful for dermatologists to know that a small amount of blood at the bite site is suggestive of a fly bite rather than a sting from a member of the order Hymenoptera. Currently, there are no consistently useful extracts for intradermal skin testing.11 Although there are several commercially available serum-specific IgE tests for suspected horse fly reactions, their usefulness is doubtful without further information on sensitivity and specificity as well as the allergen utilized.11,18,19 The use of allergen immunotherapy to induce hyposensitization in patients who experience cutaneous reactions is not standardized and poses some risks including severe allergic reactions requiring facilities for resuscitation, variability of response patterns, and supporting evidence is weak.11
Final Thoughts
Cutaneous reactions to yellow fly bites rarely are described in the dermatology literature. The salivary proteins implicated in inducing an allergic response and cross-reactivity of D ferrugatus with other biting and stinging insects as well as the natural course of immune reactions over time need to be further characterized.
The yellow fly (Diachlorus ferrugatus) is a flying biting insect belonging to the order Diptera, family Tabanidae, which also includes deer flies (genus Chrysops) and horse flies (genus Tabanus).1 They are different from stinging insects of the order Hymenoptera (bees, wasps, yellow jackets, and hornets). As the name suggests, the yellow fly has a distinct yellow appearance, and adult yellow flies have a body length of approximately 1 cm.1,2 Distinguishing features of the yellow fly include prominently dark forelegs (the remaining legs are yellow), dark purple to black eyes with 2 fluorescent green lines, and a yellow abdomen with black hairs along the lateral regions and a broad central yellow stripe.1-3 Their wings have longitudinal black veins with clear spaces in between and a conspicuous brown patch at the apex (Figure 1A). In comparison, horse flies are darker and larger (Figure 1B), and deer flies are similar in shape but have stripes on the abdomen and thorax and mottled wings with dark patches near the apex (Figure 1C).1

The Tabanidae family comprises 4455 species belonging to 137 genera and is notorious for bites that result in localized pain, swelling, itching, and discomfort.4 While some Tabanidae species are mechanical or biologic vectors of pathogens (eg, Loa loa, equine infectious anemia virus, Trypanosoma species, cattle and sheep anthrax and tularemia), yellow flies do not appear to play a considerable role in disease transmission.4,5 Nonetheless, their bites can cause discomfort and create a nuisance for individuals residing within their distribution areas as well as for agricultural livestock, contributing to lower weight gain and milk production.1
Yellow flies are a commonly occurring species in the southeastern United States; their distribution spans several states, including New Jersey, Florida, and Texas.1,2 In Florida, specifically, yellow flies exhibit a seasonal pattern, with peak activity typically occurring from April through June.6-9 Activity levels are heightened around sunset as well as sunrise.1,9 Tabanids can be found in forests, parks, and gardens—particularly those that contain waterways such as freshwater lakes and streams—and typically stay near shaded woodlands that are prone to flooding.9
Tabanids go through the life cycle stages of egg, larva, pupa, and adult; the life cycle typically spans 1 year, with the adults living 30 to 60 days.1 Mating occurs soon after adults emerge from the pupal case in the soil.1,10 Females then are attracted to large dark moving objects and will feed on blood to develop eggs.2,10 Only female members of the Tabanidae family have modifications of the mouth parts that allow wounding of the skin (Figure 2). Their bites introduce saliva to the skin containing anticoagulants and other likely allergens. The tongue is used to lap between 20 to 600 microliters of blood.11 Males feed primarily on pollen and nectar.10 Most tabanid bites result in transient wheal-and-flare reactions, but some can result in more severe allergic reactions such as in our reported case.10 Rarely, anaphylactic reactions have been documented.10,12

Case Report
A 48-year-old man presented with swelling of the left hand following a yellow fly bite to the wrist 30 minutes prior while he worked outside at a ranch in central Florida (Figure 3). The patient was afebrile and reported no respiratory or gastrointestinal symptoms. The left hand and forearm were warm to the touch and appeared red and edematous (Figure 4). He was not tachycardic and did not appear to be in any distress. The patient reported that he had worked on the ranch for several years, and during that time had noted he was developing worsening localized reactions to yellow fly bites. He had visually identified the offending insect prior to the current presentation and had trapped some flies in previous incidents. Recently he had experienced rapid swelling at the bite sites but had never experienced respiratory difficulties or signs of systemic allergic reactions. He previously had used topical steroids when bites resulted in mild wheal-and-flare reactions, but he reported that these were no longer effective.


Management of the current bite reaction included oral prednisone tapered over 1 week from 40 mg to 10 mg daily as well as oral cetirizine 10 mg daily. Although bacterial cellulitis was considered in the differential diagnosis, no oral antibiotics were prescribed given the patient’s history of similar clinical presentations following yellow fly bites. His symptoms resolved within a few hours of his dose of prednisone. Incidentally, our patient has been able to control the progression of subsequent hypersensitivity reactions to yellow fly bites with a single 20-mg dose of prednisone administered at the onset of the bite.
Comment
In general, blood-feeding (hematophagous) insects rarely cause anaphylaxis and are more likely to cause cutaneous hypersensitivity reactions, possibly due to the small amount of antigen injected from a bite.13,14 The immediate wheal-and-flare reaction is an IgE-mediated type 1 immune reaction compared to a less common type 4 T-cell mediated delayed hypersensitivity reaction.14,15 There are many protein allergens in the saliva of biting insects that are not well characterized. Relevant allergens include a 69 kDa salivary gland protein as well as a Tab y 1 (anticoagulant), Tab y 2 (hyaluronidase), and Tab y 5 (antigen 5–related venom protein).11,15-17 Some of these proteins have structural homology between insects of different orders and can cause cross-reactivity in patients who also are allergic to Hymenoptera stings (wasp-horsefly syndrome).12,16
Our patient’s cutaneous reaction was localized and clinically manifested with rapidly progressive erythema and edema at the bite location. He did not exhibit signs of a systemic reaction such as angioedema, respiratory or gastrointestinal symptoms, tachycardia, or hypotension. Management of affected patients depends on the extent of the reaction and may include oral or parenteral antihistamines as well as oral steroids for more severe edema.11 Anaphylactic reactions generally respond to subcutaneous epinephrine.15 It would be prudent for patients with a relevant anaphylactic history to carry an autoinjectable epinephrine pen in case of difficulty breathing or general malaise following a bite. Besides avoidance of insect bites, personal protection methods include wearing long-sleeved shirts and pants and using insect repellents containing diethyl toluamide (DEET), citronella, or geraniol.1
At present, diagnosis of cutaneous reactions to yellow fly bites is best made based on the patient’s personal history.14 If the offending fly is trapped, it can be identified. As most patients cannot differentiate between insects, it may be helpful for dermatologists to know that a small amount of blood at the bite site is suggestive of a fly bite rather than a sting from a member of the order Hymenoptera. Currently, there are no consistently useful extracts for intradermal skin testing.11 Although there are several commercially available serum-specific IgE tests for suspected horse fly reactions, their usefulness is doubtful without further information on sensitivity and specificity as well as the allergen utilized.11,18,19 The use of allergen immunotherapy to induce hyposensitization in patients who experience cutaneous reactions is not standardized and poses some risks including severe allergic reactions requiring facilities for resuscitation, variability of response patterns, and supporting evidence is weak.11
Final Thoughts
Cutaneous reactions to yellow fly bites rarely are described in the dermatology literature. The salivary proteins implicated in inducing an allergic response and cross-reactivity of D ferrugatus with other biting and stinging insects as well as the natural course of immune reactions over time need to be further characterized.
- Squitier JM. Deer flies, yellow flies, and horse flies, Chrysops, Diachlorus and Tabanus spp. (Insecta: Diptera: Tabanidae). University of Florida. Accessed March 11, 2025. https://edis.ifas.ufl.edu/publication/IN155
- Fairchild GB, Weems HB Jr, Fasulo TR. Yellow fly, Diachlorus ferrugatus (Fabricius)(Insecta: Diptera: Tabanidae). University of Florida. Accessed March 11, 2025. https://edis.ifas.ufl.edu/publication/IN595
- Mullens BA. Horse flies and deer flies (Tabanidae). In: Mullen G, Durden L. Med Vet Entomol. Elsevier Science; 2009:327-344.
- Akhoundi M, Sereno D, Marteau A, et al. Who bites me? A tentative discriminative key to diagnose hematophagous ectoparasites biting using clinical manifestations. Diagnostics (Basel). 2020;10:308.
- Cheng TC. General Parasitology. 2nd ed. Elsevier Science; 2021:660.
- Wells K, Varnadoe C, Dorman D, et al. Survey of the distribution and seasonal activity of yellow flies (Diptera: Tabanidae) in Florida, USA. J Vector Ecol. 2019;44:235-242.
- Hribar LJ, Leppla NC, Beshear RJ, et al. Seasonal abundance of Diachlorus ferrugatus (Diptera: Tabanidae) in Monroe County, Florida. Florida Scientist. 2003;66:52-54.
- Fairchild GB, Weems HV. Diachlorus ferrugatus (Fabricius), a fierce biting fly (Diptera: Tabanidae). Florida Department of Agriculture and Consumer Services, Division of Plant Industry. Entomology Circular. 1973;139.
- Cilek JE, Schreiber ET. Diel host-seeking activity of adult Diachlorus ferrugatus (F.) (Diptera: Tabanidae) in Northwestern Florida. J Entomol Sci. 1999;34:462-466.
- Sean S. Tabanids (horseflies). Dermatol Online J. 1999;5:6.
- Whyte AF, Popeseu FD, Carlson J. Tabanidae insect (horsefly and deerfly) allergy in humans: a review of the literature. Clin Exp Allergy. 2020;50:886-893.
- Buonomo A, Rizzi A, Aruanno A, et al. Anaphylaxis after horsefly sting: a strange case of wasp-horsefly syndrome. Postepi Dermatol Alergol. 2021;2:331-332.
- Freye HB, Litwin C. Coexistent anaphylaxis to Diptera and Hymenoptera. Ann Allergy Asthma Immunol. 1996 76:270-272.
- Hemmer W, Wantke F. Insect hypersensitivity beyond bee and wasp venom allergy. Allergol Select. 2020;4:97-104.
- Ewan PW. Allergy to insect stings: a review. J R Soc Med. 1985;78:234-239.
- Ma D, Li Y, Dong J, et al. Purification and characterization of two new allergens from the salivary glands of the horsefly Tabanus yao. Allergy. 2011;66:101-109.
- Hemmer W, Focke M, Vieluf D, et al. Anaphylaxis induced by horsefly bites: identification of a 69 kd IgE-binding protein from Chrysops spp. (Diptera: Tabanidae) by western blot analysis. J Allergy Clin Immunol. 1998;101:134-136.
- Mayo Clinic Laboratories. Test catalog: horse fly. Accessed March 11, 2025. https://www.mayocliniclabs.com/search?q=horse%20fly
- HealthLabs.com. Horsefly allergy test. Accessed March 11, 2025. https://www.healthlabs.com/horsefly-allergy-testing
- Squitier JM. Deer flies, yellow flies, and horse flies, Chrysops, Diachlorus and Tabanus spp. (Insecta: Diptera: Tabanidae). University of Florida. Accessed March 11, 2025. https://edis.ifas.ufl.edu/publication/IN155
- Fairchild GB, Weems HB Jr, Fasulo TR. Yellow fly, Diachlorus ferrugatus (Fabricius)(Insecta: Diptera: Tabanidae). University of Florida. Accessed March 11, 2025. https://edis.ifas.ufl.edu/publication/IN595
- Mullens BA. Horse flies and deer flies (Tabanidae). In: Mullen G, Durden L. Med Vet Entomol. Elsevier Science; 2009:327-344.
- Akhoundi M, Sereno D, Marteau A, et al. Who bites me? A tentative discriminative key to diagnose hematophagous ectoparasites biting using clinical manifestations. Diagnostics (Basel). 2020;10:308.
- Cheng TC. General Parasitology. 2nd ed. Elsevier Science; 2021:660.
- Wells K, Varnadoe C, Dorman D, et al. Survey of the distribution and seasonal activity of yellow flies (Diptera: Tabanidae) in Florida, USA. J Vector Ecol. 2019;44:235-242.
- Hribar LJ, Leppla NC, Beshear RJ, et al. Seasonal abundance of Diachlorus ferrugatus (Diptera: Tabanidae) in Monroe County, Florida. Florida Scientist. 2003;66:52-54.
- Fairchild GB, Weems HV. Diachlorus ferrugatus (Fabricius), a fierce biting fly (Diptera: Tabanidae). Florida Department of Agriculture and Consumer Services, Division of Plant Industry. Entomology Circular. 1973;139.
- Cilek JE, Schreiber ET. Diel host-seeking activity of adult Diachlorus ferrugatus (F.) (Diptera: Tabanidae) in Northwestern Florida. J Entomol Sci. 1999;34:462-466.
- Sean S. Tabanids (horseflies). Dermatol Online J. 1999;5:6.
- Whyte AF, Popeseu FD, Carlson J. Tabanidae insect (horsefly and deerfly) allergy in humans: a review of the literature. Clin Exp Allergy. 2020;50:886-893.
- Buonomo A, Rizzi A, Aruanno A, et al. Anaphylaxis after horsefly sting: a strange case of wasp-horsefly syndrome. Postepi Dermatol Alergol. 2021;2:331-332.
- Freye HB, Litwin C. Coexistent anaphylaxis to Diptera and Hymenoptera. Ann Allergy Asthma Immunol. 1996 76:270-272.
- Hemmer W, Wantke F. Insect hypersensitivity beyond bee and wasp venom allergy. Allergol Select. 2020;4:97-104.
- Ewan PW. Allergy to insect stings: a review. J R Soc Med. 1985;78:234-239.
- Ma D, Li Y, Dong J, et al. Purification and characterization of two new allergens from the salivary glands of the horsefly Tabanus yao. Allergy. 2011;66:101-109.
- Hemmer W, Focke M, Vieluf D, et al. Anaphylaxis induced by horsefly bites: identification of a 69 kd IgE-binding protein from Chrysops spp. (Diptera: Tabanidae) by western blot analysis. J Allergy Clin Immunol. 1998;101:134-136.
- Mayo Clinic Laboratories. Test catalog: horse fly. Accessed March 11, 2025. https://www.mayocliniclabs.com/search?q=horse%20fly
- HealthLabs.com. Horsefly allergy test. Accessed March 11, 2025. https://www.healthlabs.com/horsefly-allergy-testing
Managing Cutaneous Reactions to Yellow Fly (Diachlorus ferrugatus) Bites
Managing Cutaneous Reactions to Yellow Fly (Diachlorus ferrugatus) Bites
PRACTICE POINTS
- Diachlorus ferrugatus, commonly known as the yellow fly, belongs to the Tabanidae family of insects that also includes deer flies and horse flies.
- The female yellow fly can instill a painful bite in humans and can cause local and systemic allergic reactions.
- Medical management of yellow fly bites is dictated by the severity of the reaction.
Not as Bland as You May Think: Celery (Apium graveolens) Commonly Induces Phytophotodermatitis
Not as Bland as You May Think: Celery (Apium graveolens) Commonly Induces Phytophotodermatitis
Celery (Apium graveolens)—that lowly vegetable that often languishes in the refrigerator crisper and apparently supplies fewer calories than are required to consume it—contains a myriad of photosensitizing chemicals known as furocoumarins and psoralens that can cause phytophotodermatitis (PPD) when handled prior to exposure to UV light.1 Individuals who are most likely to develop PPD caused by repeated contact with celery include food industry workers (eg, grocery store workers, farmers) who pick, handle, or prepare celery for consumption. While eating celery as part of a standard diet is highly unlikely to cause PPD, celery infected with Sclerotinia sclerotiorum (known as pink rot) causes more severe generalized sun sensitivity due to an increased amount of furocoumarins produced in response to the fungus.2 Contact with celery also can induce cutaneous manifestations unrelated to sun exposure in some individuals, including urticaria, allergic contact dermatitis, and anaphylaxis.3 In this article, we provide an overview of the life cycle and origin of celery as well as its irritant and allergic properties. We also describe cutaneous rashes associated with PPD caused by exposure to celery and highlight treatment options.
Morphology and Distribution
The Apiaceae family features aromatic flowering plants that comprise more than 3500 species, including many economically important vegetables, herbs, and spices.4 It also includes many alkaloid-containing species that are known to be poisonous to humans, such as poison hemlock (Conium maculatum) and water hemlock (Cicuta maculate). Most Apiaceae plants that are consumed by humans originate from the Mediterranean region.5 While known for their diversity of flavor and aroma, most of the plants from this family have low caloric value and provide minimal amounts of energy.
Members of the Apiaceae family have flowers that create a classic umbel shape mimicking the appearance of an upside-down umbrella (thus the former name for this family, Umbelliferae). The pedicles—the small stems attached to the base of each flower—spread from a common center to form the umbel.5 The Apiaceae family also includes the greatest number of plants that cause PPD due to their high concentration of furocoumarins, which deter fungus from harming the plants.6
A biennial plant, celery completes its life cycle in 2 years. During the first season, the stems, roots, and leaves sprout; in the second and final year, the flowers, fruits, and seeds proliferate, followed by decomposition. Apium graveolens approaches heights of 2 to 3 ft, growing upright and displaying grooved stems. Each stem terminates in a basal rosette of leaves. The second season brings white flower blooms in terminal or axillary umbels.7
Celery originated in the temperate Mediterranean regions of Europe, but farmers now cultivate it globally.8 It grows best in rich moist soil with full exposure to sunlight. Plants multiply their numbers through self-seeding. Celery commonly is found in suburban and rural homes, both in refrigerators for consumption as well as in medicine cabinets in capsule form for the treatment of arthritis.4
Irritant and Allergenic Properties
Despite the potential health benefits of celery, the Apiaceae family, which includes hogweed, dill, and fennel, prevails as the most common culprit for phytotoxic reactions. The Rutaceae family, including citrus plants and rue, remains runner-up for causes of PPD.9 Phytophotodermatitis is not an immunologic reaction, making anyone susceptible to formation of the cutaneous lesions when exposed to UV light after handling celery. Pruritis rarely occurs, unlike in allergic phytodermatitis.10 Upon photoexcitation from exposure to UVA light, individual psoralen molecules covalently bind to pyrimidine bases, causing interstrand cross-linking that prevents DNA replication and triggering a cascade leading to apoptosis of the cell. Apoptosis induces cell membrane edema, which manifests as cutaneous vesicles and bullae on the skin.10 Regardless of plant species, PPD reactions have similar appearance.
Celery roots contain the greatest concentration of psoralens, making it the most likely part of the plant to induce PPD.6 Phytophotodermatitis caused by celery can occur at any time of the year, but most eruptions occur during the summer months due to increased sunlight exposure and intensity. Among 320 randomly selected Michigan celery harvesters, 163 (51%) displayed evidence of vesicular and bullous dermatitis on the fingers, hands, and forearms.11 In this study, celery infected with pink rot fungus induced an erythematous eruption with vesicles and bullae within 48 hours of contact after just 30 seconds of summer sunlight exposure; however, eruptions are not limited to summer months, as the cutaneous presentation depends solely on exposure to UVA light, which can occur year-round.
Use of tanning beds is a major risk factor for PPD.12 Tanning beds utilize fluorescent bulbs that primarily emit UVA light, with UVB light emitted to a lesser degree. The UVA radiation produced by tanning beds is more than 3 times as intense as natural sunlight.12 Among grocery store employees, the combination of these 2 risk factors—regular contact with celery and tanning bed use—resulted in a prevalence ratio for PPD more than 40 times greater than that of individuals with neither risk factor.13
Cutaneous Manifestations of PPD
Phytophotodermatitis is a nonimmunologic dermatitis that forms via the interaction between UV light exposure and the photosensitizing chemicals inherent to some plant species. Development of PPD following contact with celery may be caused by the photoactive substances in celery, including the psoralens 8-methoxypsoralen and 5-methoxypsoralen.14 The psoralens must become activated by UV light with wavelengths between 320 nm and 400 nm (UVA) to initiate biologic effects.15
Once chemically activated, the photoactive mediators cause an erythematous and edematous sunburnlike reaction. Current hypotheses state that psoralen plus UVA generates reactive oxygen species, which damage the DNA within cells and alter receptors on cell membranes within the epidermis.14 The cutaneous eruption usually appears between 12 and 36 hours after sun exposure. Although they generally are not pruritic, the eruptions may induce pain. Within 7 to 10 days following development of the rash, hyperpigmentation occurs in the affected area and often persists for months to years.16 Ingestion of large amounts of celery has been cited to cause generalized phototoxic reactions; however, PPD rarely arises solely after ingestion, unless excessive amounts are consumed with concomitant exposure to psoralen plus UVA or tanning beds.17 In these cases, patients develop diffuse redness with superficial scaling, pain, and blistering if severe.
Treatment of PPD
Prevention remains the best form of treatment for PPD caused by exposure to celery. Postcontact management includes washing the affected area with soap and water and changing clothes promptly. Topical corticosteroids have mild utility in treatment of PPD.18 Oral steroid tapers, which reduce acute inflammation, also are an option for treatment. Alternatively, intramuscular triamcinolone acetonide 1 mg/kg mixed with budesonide 0.1 mg/kg is an option and is associated with a reduced risk for adverse effects compared to oral steroids. The resulting hyperpigmentation develops 1 to 2 weeks postepithelialization.19 Hyperpigmentation often fades slowly over several months in lighter-skinned individuals but may last for years or indefinitely in darker-skinned patients.
Final Thoughts
Dermatologists should be knowledgeable about the various plant culprits that can induce PPD. Understanding the mechanism and pathophysiology can help guide both therapeutic interventions and preventive counseling. Understanding that even readily available vegetables such as celery can induce cutaneous eruptions should put PPD in the differential diagnosis more commonly when unspecified dermatitides are present.
- Walansky A. Study finally confirms eating celery burns more calories than it contains. Food & Wine. June 22, 2017. Accessed January 17, 2025. https://www.foodandwine.com/news/study-finally-confirms-eating-celery-burns-more-caloriesit-contains
- Puig L. Enhancement of PUVA phototoxic effects following celery ingestion: cool broth also can burn. Arch Dermatol. 1994;130:809-810. doi:10.1001/archderm.130.6.809
- Perez-Pimiento AJ, Moneo I, Santaolalla M, et al. Anaphylactic reaction to young garlic. Allergy. 1999;54:626-629.
- The Editors of Encyclopaedia Britannica. Apiaceae. Britannica. Updated November 25, 2024. Accessed January 17, 2025. https://www.britannica.com/plant/Apiaceae
- Smith R. Celery. In: Geoffriau E, Simon PW, eds. Carrots and Related Apiaceae Crops. 2nd ed. CABI; 2021:272-282.
- Dijkstra JWE, Chang L. Severe phototoxic burn following celery ingestion. Arch Dermatol. 1992;128:1277.
- Tobyn G, Denham A, Whitelegg M. Apium graveolens, wild celery. The Western Herbal Tradition: 2000 years of Medicinal Plant Knowledge. Elsevier. 2011:79-89. doi:10.1016/b978-0-443-10344-5.00014-8
- Rademaker M. Celery. DermNet. Accessed January 17, 2025. https://dermnetnz.org/topics/celery
- Sasseville D. Clinical patterns of phytophotodermatitis. Dermatol Clin. 2009;27:299-308.
- Jin Goon AT, Goh CL. Plant dermatitis: Asian perspective. Indian J Dermatol. 2011;56:707-710. doi:10.4103/0019-5154.91833
- Birmingham DJ, Key MM, Tublich GE. Phototoxic bullae among celery harvesters. Arch Dermatol. 1961;83:73-87.
- Robb-Nicholson C. By the way, doctor: is a tanning bed safer than sunlight? Harvard Health Publishing. Harvard Medical School. September 1, 2009. Accessed January 17, 2025. https://www.health.harvard.edu/staying-healthy/is-a-tanning-bed-saferthan-sunlight
- Vester L, Thyssen JP, Menne T, et al. Consequences of occupational food-related hand dermatoses with a focus on protein contact dermatitis. Contact Dermatitis. 2012;67:328-333.
- Ling TC, Clayton TH, Crawley J, et al. British Association of Dermatologists and British Photodermatology Group guidelines for the safe and effective use of psoralen-ultraviolet A therapy 2015. Br J Dermatol. 2016;174:24-55.
- Laskin JD. Cellular and molecular mechanisms in photochemical sensitization: studies on the mechanism of action of psoralens. Food Chem Toxicol. 1994;32:119-127. doi:10.1016/0278-6915(94)90172-4
- Elmets CA. Photosensitivity disorders (photodermatoses): clinical manifestations, diagnosis, and treatment. UpToDate. Updated February 23, 2023. Accessed January 17, 2025. https://www.uptodate.com/contents/photosensitivity-disorders-photodermatoses-clinical-manifestations-diagnosis-and-treatment
- Boffa, MJ, Gilmour E, Ead RD. Celery soup causing severe phototoxity during PUVA therapy. Br J Dermatol. 1996;135:334. doi:10.1111/j.1365-2133.1996.tb01182.x
- Sarhane KA, Ibrahim A, Fagan SP, et al. Phytophotodermatitis. Eplasty. 2013;13:ic57.
- McGovern TW. Dermatoses due to plants. In: Bolognia JL, Jorizzo JL, Rapini RP, et al, eds. Dermatology. Mosby; 2018:286-303.
Celery (Apium graveolens)—that lowly vegetable that often languishes in the refrigerator crisper and apparently supplies fewer calories than are required to consume it—contains a myriad of photosensitizing chemicals known as furocoumarins and psoralens that can cause phytophotodermatitis (PPD) when handled prior to exposure to UV light.1 Individuals who are most likely to develop PPD caused by repeated contact with celery include food industry workers (eg, grocery store workers, farmers) who pick, handle, or prepare celery for consumption. While eating celery as part of a standard diet is highly unlikely to cause PPD, celery infected with Sclerotinia sclerotiorum (known as pink rot) causes more severe generalized sun sensitivity due to an increased amount of furocoumarins produced in response to the fungus.2 Contact with celery also can induce cutaneous manifestations unrelated to sun exposure in some individuals, including urticaria, allergic contact dermatitis, and anaphylaxis.3 In this article, we provide an overview of the life cycle and origin of celery as well as its irritant and allergic properties. We also describe cutaneous rashes associated with PPD caused by exposure to celery and highlight treatment options.
Morphology and Distribution
The Apiaceae family features aromatic flowering plants that comprise more than 3500 species, including many economically important vegetables, herbs, and spices.4 It also includes many alkaloid-containing species that are known to be poisonous to humans, such as poison hemlock (Conium maculatum) and water hemlock (Cicuta maculate). Most Apiaceae plants that are consumed by humans originate from the Mediterranean region.5 While known for their diversity of flavor and aroma, most of the plants from this family have low caloric value and provide minimal amounts of energy.
Members of the Apiaceae family have flowers that create a classic umbel shape mimicking the appearance of an upside-down umbrella (thus the former name for this family, Umbelliferae). The pedicles—the small stems attached to the base of each flower—spread from a common center to form the umbel.5 The Apiaceae family also includes the greatest number of plants that cause PPD due to their high concentration of furocoumarins, which deter fungus from harming the plants.6
A biennial plant, celery completes its life cycle in 2 years. During the first season, the stems, roots, and leaves sprout; in the second and final year, the flowers, fruits, and seeds proliferate, followed by decomposition. Apium graveolens approaches heights of 2 to 3 ft, growing upright and displaying grooved stems. Each stem terminates in a basal rosette of leaves. The second season brings white flower blooms in terminal or axillary umbels.7
Celery originated in the temperate Mediterranean regions of Europe, but farmers now cultivate it globally.8 It grows best in rich moist soil with full exposure to sunlight. Plants multiply their numbers through self-seeding. Celery commonly is found in suburban and rural homes, both in refrigerators for consumption as well as in medicine cabinets in capsule form for the treatment of arthritis.4
Irritant and Allergenic Properties
Despite the potential health benefits of celery, the Apiaceae family, which includes hogweed, dill, and fennel, prevails as the most common culprit for phytotoxic reactions. The Rutaceae family, including citrus plants and rue, remains runner-up for causes of PPD.9 Phytophotodermatitis is not an immunologic reaction, making anyone susceptible to formation of the cutaneous lesions when exposed to UV light after handling celery. Pruritis rarely occurs, unlike in allergic phytodermatitis.10 Upon photoexcitation from exposure to UVA light, individual psoralen molecules covalently bind to pyrimidine bases, causing interstrand cross-linking that prevents DNA replication and triggering a cascade leading to apoptosis of the cell. Apoptosis induces cell membrane edema, which manifests as cutaneous vesicles and bullae on the skin.10 Regardless of plant species, PPD reactions have similar appearance.
Celery roots contain the greatest concentration of psoralens, making it the most likely part of the plant to induce PPD.6 Phytophotodermatitis caused by celery can occur at any time of the year, but most eruptions occur during the summer months due to increased sunlight exposure and intensity. Among 320 randomly selected Michigan celery harvesters, 163 (51%) displayed evidence of vesicular and bullous dermatitis on the fingers, hands, and forearms.11 In this study, celery infected with pink rot fungus induced an erythematous eruption with vesicles and bullae within 48 hours of contact after just 30 seconds of summer sunlight exposure; however, eruptions are not limited to summer months, as the cutaneous presentation depends solely on exposure to UVA light, which can occur year-round.
Use of tanning beds is a major risk factor for PPD.12 Tanning beds utilize fluorescent bulbs that primarily emit UVA light, with UVB light emitted to a lesser degree. The UVA radiation produced by tanning beds is more than 3 times as intense as natural sunlight.12 Among grocery store employees, the combination of these 2 risk factors—regular contact with celery and tanning bed use—resulted in a prevalence ratio for PPD more than 40 times greater than that of individuals with neither risk factor.13
Cutaneous Manifestations of PPD
Phytophotodermatitis is a nonimmunologic dermatitis that forms via the interaction between UV light exposure and the photosensitizing chemicals inherent to some plant species. Development of PPD following contact with celery may be caused by the photoactive substances in celery, including the psoralens 8-methoxypsoralen and 5-methoxypsoralen.14 The psoralens must become activated by UV light with wavelengths between 320 nm and 400 nm (UVA) to initiate biologic effects.15
Once chemically activated, the photoactive mediators cause an erythematous and edematous sunburnlike reaction. Current hypotheses state that psoralen plus UVA generates reactive oxygen species, which damage the DNA within cells and alter receptors on cell membranes within the epidermis.14 The cutaneous eruption usually appears between 12 and 36 hours after sun exposure. Although they generally are not pruritic, the eruptions may induce pain. Within 7 to 10 days following development of the rash, hyperpigmentation occurs in the affected area and often persists for months to years.16 Ingestion of large amounts of celery has been cited to cause generalized phototoxic reactions; however, PPD rarely arises solely after ingestion, unless excessive amounts are consumed with concomitant exposure to psoralen plus UVA or tanning beds.17 In these cases, patients develop diffuse redness with superficial scaling, pain, and blistering if severe.
Treatment of PPD
Prevention remains the best form of treatment for PPD caused by exposure to celery. Postcontact management includes washing the affected area with soap and water and changing clothes promptly. Topical corticosteroids have mild utility in treatment of PPD.18 Oral steroid tapers, which reduce acute inflammation, also are an option for treatment. Alternatively, intramuscular triamcinolone acetonide 1 mg/kg mixed with budesonide 0.1 mg/kg is an option and is associated with a reduced risk for adverse effects compared to oral steroids. The resulting hyperpigmentation develops 1 to 2 weeks postepithelialization.19 Hyperpigmentation often fades slowly over several months in lighter-skinned individuals but may last for years or indefinitely in darker-skinned patients.
Final Thoughts
Dermatologists should be knowledgeable about the various plant culprits that can induce PPD. Understanding the mechanism and pathophysiology can help guide both therapeutic interventions and preventive counseling. Understanding that even readily available vegetables such as celery can induce cutaneous eruptions should put PPD in the differential diagnosis more commonly when unspecified dermatitides are present.
Celery (Apium graveolens)—that lowly vegetable that often languishes in the refrigerator crisper and apparently supplies fewer calories than are required to consume it—contains a myriad of photosensitizing chemicals known as furocoumarins and psoralens that can cause phytophotodermatitis (PPD) when handled prior to exposure to UV light.1 Individuals who are most likely to develop PPD caused by repeated contact with celery include food industry workers (eg, grocery store workers, farmers) who pick, handle, or prepare celery for consumption. While eating celery as part of a standard diet is highly unlikely to cause PPD, celery infected with Sclerotinia sclerotiorum (known as pink rot) causes more severe generalized sun sensitivity due to an increased amount of furocoumarins produced in response to the fungus.2 Contact with celery also can induce cutaneous manifestations unrelated to sun exposure in some individuals, including urticaria, allergic contact dermatitis, and anaphylaxis.3 In this article, we provide an overview of the life cycle and origin of celery as well as its irritant and allergic properties. We also describe cutaneous rashes associated with PPD caused by exposure to celery and highlight treatment options.
Morphology and Distribution
The Apiaceae family features aromatic flowering plants that comprise more than 3500 species, including many economically important vegetables, herbs, and spices.4 It also includes many alkaloid-containing species that are known to be poisonous to humans, such as poison hemlock (Conium maculatum) and water hemlock (Cicuta maculate). Most Apiaceae plants that are consumed by humans originate from the Mediterranean region.5 While known for their diversity of flavor and aroma, most of the plants from this family have low caloric value and provide minimal amounts of energy.
Members of the Apiaceae family have flowers that create a classic umbel shape mimicking the appearance of an upside-down umbrella (thus the former name for this family, Umbelliferae). The pedicles—the small stems attached to the base of each flower—spread from a common center to form the umbel.5 The Apiaceae family also includes the greatest number of plants that cause PPD due to their high concentration of furocoumarins, which deter fungus from harming the plants.6
A biennial plant, celery completes its life cycle in 2 years. During the first season, the stems, roots, and leaves sprout; in the second and final year, the flowers, fruits, and seeds proliferate, followed by decomposition. Apium graveolens approaches heights of 2 to 3 ft, growing upright and displaying grooved stems. Each stem terminates in a basal rosette of leaves. The second season brings white flower blooms in terminal or axillary umbels.7
Celery originated in the temperate Mediterranean regions of Europe, but farmers now cultivate it globally.8 It grows best in rich moist soil with full exposure to sunlight. Plants multiply their numbers through self-seeding. Celery commonly is found in suburban and rural homes, both in refrigerators for consumption as well as in medicine cabinets in capsule form for the treatment of arthritis.4
Irritant and Allergenic Properties
Despite the potential health benefits of celery, the Apiaceae family, which includes hogweed, dill, and fennel, prevails as the most common culprit for phytotoxic reactions. The Rutaceae family, including citrus plants and rue, remains runner-up for causes of PPD.9 Phytophotodermatitis is not an immunologic reaction, making anyone susceptible to formation of the cutaneous lesions when exposed to UV light after handling celery. Pruritis rarely occurs, unlike in allergic phytodermatitis.10 Upon photoexcitation from exposure to UVA light, individual psoralen molecules covalently bind to pyrimidine bases, causing interstrand cross-linking that prevents DNA replication and triggering a cascade leading to apoptosis of the cell. Apoptosis induces cell membrane edema, which manifests as cutaneous vesicles and bullae on the skin.10 Regardless of plant species, PPD reactions have similar appearance.
Celery roots contain the greatest concentration of psoralens, making it the most likely part of the plant to induce PPD.6 Phytophotodermatitis caused by celery can occur at any time of the year, but most eruptions occur during the summer months due to increased sunlight exposure and intensity. Among 320 randomly selected Michigan celery harvesters, 163 (51%) displayed evidence of vesicular and bullous dermatitis on the fingers, hands, and forearms.11 In this study, celery infected with pink rot fungus induced an erythematous eruption with vesicles and bullae within 48 hours of contact after just 30 seconds of summer sunlight exposure; however, eruptions are not limited to summer months, as the cutaneous presentation depends solely on exposure to UVA light, which can occur year-round.
Use of tanning beds is a major risk factor for PPD.12 Tanning beds utilize fluorescent bulbs that primarily emit UVA light, with UVB light emitted to a lesser degree. The UVA radiation produced by tanning beds is more than 3 times as intense as natural sunlight.12 Among grocery store employees, the combination of these 2 risk factors—regular contact with celery and tanning bed use—resulted in a prevalence ratio for PPD more than 40 times greater than that of individuals with neither risk factor.13
Cutaneous Manifestations of PPD
Phytophotodermatitis is a nonimmunologic dermatitis that forms via the interaction between UV light exposure and the photosensitizing chemicals inherent to some plant species. Development of PPD following contact with celery may be caused by the photoactive substances in celery, including the psoralens 8-methoxypsoralen and 5-methoxypsoralen.14 The psoralens must become activated by UV light with wavelengths between 320 nm and 400 nm (UVA) to initiate biologic effects.15
Once chemically activated, the photoactive mediators cause an erythematous and edematous sunburnlike reaction. Current hypotheses state that psoralen plus UVA generates reactive oxygen species, which damage the DNA within cells and alter receptors on cell membranes within the epidermis.14 The cutaneous eruption usually appears between 12 and 36 hours after sun exposure. Although they generally are not pruritic, the eruptions may induce pain. Within 7 to 10 days following development of the rash, hyperpigmentation occurs in the affected area and often persists for months to years.16 Ingestion of large amounts of celery has been cited to cause generalized phototoxic reactions; however, PPD rarely arises solely after ingestion, unless excessive amounts are consumed with concomitant exposure to psoralen plus UVA or tanning beds.17 In these cases, patients develop diffuse redness with superficial scaling, pain, and blistering if severe.
Treatment of PPD
Prevention remains the best form of treatment for PPD caused by exposure to celery. Postcontact management includes washing the affected area with soap and water and changing clothes promptly. Topical corticosteroids have mild utility in treatment of PPD.18 Oral steroid tapers, which reduce acute inflammation, also are an option for treatment. Alternatively, intramuscular triamcinolone acetonide 1 mg/kg mixed with budesonide 0.1 mg/kg is an option and is associated with a reduced risk for adverse effects compared to oral steroids. The resulting hyperpigmentation develops 1 to 2 weeks postepithelialization.19 Hyperpigmentation often fades slowly over several months in lighter-skinned individuals but may last for years or indefinitely in darker-skinned patients.
Final Thoughts
Dermatologists should be knowledgeable about the various plant culprits that can induce PPD. Understanding the mechanism and pathophysiology can help guide both therapeutic interventions and preventive counseling. Understanding that even readily available vegetables such as celery can induce cutaneous eruptions should put PPD in the differential diagnosis more commonly when unspecified dermatitides are present.
- Walansky A. Study finally confirms eating celery burns more calories than it contains. Food & Wine. June 22, 2017. Accessed January 17, 2025. https://www.foodandwine.com/news/study-finally-confirms-eating-celery-burns-more-caloriesit-contains
- Puig L. Enhancement of PUVA phototoxic effects following celery ingestion: cool broth also can burn. Arch Dermatol. 1994;130:809-810. doi:10.1001/archderm.130.6.809
- Perez-Pimiento AJ, Moneo I, Santaolalla M, et al. Anaphylactic reaction to young garlic. Allergy. 1999;54:626-629.
- The Editors of Encyclopaedia Britannica. Apiaceae. Britannica. Updated November 25, 2024. Accessed January 17, 2025. https://www.britannica.com/plant/Apiaceae
- Smith R. Celery. In: Geoffriau E, Simon PW, eds. Carrots and Related Apiaceae Crops. 2nd ed. CABI; 2021:272-282.
- Dijkstra JWE, Chang L. Severe phototoxic burn following celery ingestion. Arch Dermatol. 1992;128:1277.
- Tobyn G, Denham A, Whitelegg M. Apium graveolens, wild celery. The Western Herbal Tradition: 2000 years of Medicinal Plant Knowledge. Elsevier. 2011:79-89. doi:10.1016/b978-0-443-10344-5.00014-8
- Rademaker M. Celery. DermNet. Accessed January 17, 2025. https://dermnetnz.org/topics/celery
- Sasseville D. Clinical patterns of phytophotodermatitis. Dermatol Clin. 2009;27:299-308.
- Jin Goon AT, Goh CL. Plant dermatitis: Asian perspective. Indian J Dermatol. 2011;56:707-710. doi:10.4103/0019-5154.91833
- Birmingham DJ, Key MM, Tublich GE. Phototoxic bullae among celery harvesters. Arch Dermatol. 1961;83:73-87.
- Robb-Nicholson C. By the way, doctor: is a tanning bed safer than sunlight? Harvard Health Publishing. Harvard Medical School. September 1, 2009. Accessed January 17, 2025. https://www.health.harvard.edu/staying-healthy/is-a-tanning-bed-saferthan-sunlight
- Vester L, Thyssen JP, Menne T, et al. Consequences of occupational food-related hand dermatoses with a focus on protein contact dermatitis. Contact Dermatitis. 2012;67:328-333.
- Ling TC, Clayton TH, Crawley J, et al. British Association of Dermatologists and British Photodermatology Group guidelines for the safe and effective use of psoralen-ultraviolet A therapy 2015. Br J Dermatol. 2016;174:24-55.
- Laskin JD. Cellular and molecular mechanisms in photochemical sensitization: studies on the mechanism of action of psoralens. Food Chem Toxicol. 1994;32:119-127. doi:10.1016/0278-6915(94)90172-4
- Elmets CA. Photosensitivity disorders (photodermatoses): clinical manifestations, diagnosis, and treatment. UpToDate. Updated February 23, 2023. Accessed January 17, 2025. https://www.uptodate.com/contents/photosensitivity-disorders-photodermatoses-clinical-manifestations-diagnosis-and-treatment
- Boffa, MJ, Gilmour E, Ead RD. Celery soup causing severe phototoxity during PUVA therapy. Br J Dermatol. 1996;135:334. doi:10.1111/j.1365-2133.1996.tb01182.x
- Sarhane KA, Ibrahim A, Fagan SP, et al. Phytophotodermatitis. Eplasty. 2013;13:ic57.
- McGovern TW. Dermatoses due to plants. In: Bolognia JL, Jorizzo JL, Rapini RP, et al, eds. Dermatology. Mosby; 2018:286-303.
- Walansky A. Study finally confirms eating celery burns more calories than it contains. Food & Wine. June 22, 2017. Accessed January 17, 2025. https://www.foodandwine.com/news/study-finally-confirms-eating-celery-burns-more-caloriesit-contains
- Puig L. Enhancement of PUVA phototoxic effects following celery ingestion: cool broth also can burn. Arch Dermatol. 1994;130:809-810. doi:10.1001/archderm.130.6.809
- Perez-Pimiento AJ, Moneo I, Santaolalla M, et al. Anaphylactic reaction to young garlic. Allergy. 1999;54:626-629.
- The Editors of Encyclopaedia Britannica. Apiaceae. Britannica. Updated November 25, 2024. Accessed January 17, 2025. https://www.britannica.com/plant/Apiaceae
- Smith R. Celery. In: Geoffriau E, Simon PW, eds. Carrots and Related Apiaceae Crops. 2nd ed. CABI; 2021:272-282.
- Dijkstra JWE, Chang L. Severe phototoxic burn following celery ingestion. Arch Dermatol. 1992;128:1277.
- Tobyn G, Denham A, Whitelegg M. Apium graveolens, wild celery. The Western Herbal Tradition: 2000 years of Medicinal Plant Knowledge. Elsevier. 2011:79-89. doi:10.1016/b978-0-443-10344-5.00014-8
- Rademaker M. Celery. DermNet. Accessed January 17, 2025. https://dermnetnz.org/topics/celery
- Sasseville D. Clinical patterns of phytophotodermatitis. Dermatol Clin. 2009;27:299-308.
- Jin Goon AT, Goh CL. Plant dermatitis: Asian perspective. Indian J Dermatol. 2011;56:707-710. doi:10.4103/0019-5154.91833
- Birmingham DJ, Key MM, Tublich GE. Phototoxic bullae among celery harvesters. Arch Dermatol. 1961;83:73-87.
- Robb-Nicholson C. By the way, doctor: is a tanning bed safer than sunlight? Harvard Health Publishing. Harvard Medical School. September 1, 2009. Accessed January 17, 2025. https://www.health.harvard.edu/staying-healthy/is-a-tanning-bed-saferthan-sunlight
- Vester L, Thyssen JP, Menne T, et al. Consequences of occupational food-related hand dermatoses with a focus on protein contact dermatitis. Contact Dermatitis. 2012;67:328-333.
- Ling TC, Clayton TH, Crawley J, et al. British Association of Dermatologists and British Photodermatology Group guidelines for the safe and effective use of psoralen-ultraviolet A therapy 2015. Br J Dermatol. 2016;174:24-55.
- Laskin JD. Cellular and molecular mechanisms in photochemical sensitization: studies on the mechanism of action of psoralens. Food Chem Toxicol. 1994;32:119-127. doi:10.1016/0278-6915(94)90172-4
- Elmets CA. Photosensitivity disorders (photodermatoses): clinical manifestations, diagnosis, and treatment. UpToDate. Updated February 23, 2023. Accessed January 17, 2025. https://www.uptodate.com/contents/photosensitivity-disorders-photodermatoses-clinical-manifestations-diagnosis-and-treatment
- Boffa, MJ, Gilmour E, Ead RD. Celery soup causing severe phototoxity during PUVA therapy. Br J Dermatol. 1996;135:334. doi:10.1111/j.1365-2133.1996.tb01182.x
- Sarhane KA, Ibrahim A, Fagan SP, et al. Phytophotodermatitis. Eplasty. 2013;13:ic57.
- McGovern TW. Dermatoses due to plants. In: Bolognia JL, Jorizzo JL, Rapini RP, et al, eds. Dermatology. Mosby; 2018:286-303.
Not as Bland as You May Think: Celery (Apium graveolens) Commonly Induces Phytophotodermatitis
Not as Bland as You May Think: Celery (Apium graveolens) Commonly Induces Phytophotodermatitis
PRACTICE POINTS
- Clinicians should consider phytophotodermatitis (PPD) in the differential diagnosis for erythematous eruptions with bullae and vesicles manifesting in sun-exposed distributions.
- A clinical history that includes the patient’s occupation, diet, and history of treatment with psoralen plus UVA and use of tanning beds may help diagnose PPD.
- It is important to educate patients who regularly handle celery and other plants containing furocoumarins and psoralens on how to prevent PPD and utilize effective photoprotection.
Key Features of North American Venomous Snake Bites
Key Features of North American Venomous Snake Bites
North American venomous snakes traditionally are classified as members of either the Viperidae (eg, rattlesnakes, copperheads, cottonmouths) or Elapidae (eg, coral snakes) families and account for roughly 5000 to 10,000 reported envenomations annually.1,2 In 2021, America’s Poison Centers reported 2287 calls related to copperheads, 71 related to coral snakes, 229 related to cottonmouths, 1184 related to rattlesnakes, and 524 related to unknown snakes.3 The majority of calls related to snake bites were for adult patients, resulting in absent to minor outcomes. Only 1 death due to a rattlesnake bite was reported.3 Death by envenomation from a North American snake species is considered rare and typically is attributed to a lapse in medical attention; however, rattlesnakes are the most common reported cause of death by snake envenomation (Figure 1).1,3 A study comparing snake bites and hospital stays in the southeast vs southwest United States found that the southeast had the highest incidence of copperhead bites (37%), while the southwest had a higher incidence of rattlesnake bites (70%); those who were bitten by a rattlesnake were reported to have more severe symptoms and greater need for medical attention and antivenin.4 Some reports have linked pediatric and elderly patients to worse outcomes.5 However, one study examining 24,388 emergency department visits for snake bites from 2006 through 2014 found that the majority of pediatric cases were handled by non– trauma centers in the southern United States,6 supporting evidence found by Campbell et al7 indicating that most snake bites in children can be managed with conservative care. Though reported complications—including weakness, paralysis, hypovolemic shock, thrombocytopenia, and death—from North American venomous snake bites are low, they are still considered a medical emergency.8 It is essential for physicians to understand the clinical manifestations and treatment of North American venomous snake bites and to educate patients on how to protect themselves against and avoid provoking snakes, particularly in rural areas.2 In this article, we review the characteristics of common North American venomous snakes and the clinical manifestations of their bites. We also discuss the appropriate measures for staging, evaluating, and treating snake envenomation to improve patient management and care.

Features of North American Venomous Snakes
Individual snakes within the Viperidae family vary in size, markings and coloration, activity, and region, and physicians should consult their local health departments regarding snakes that are common in their area.2 Cottonmouth snakes are semiaquatic and traditionally are found within the southern and central United States. With a spade-shaped head and distinct two-tone coloration, cottonmouths may be mistaken for other nonvenomous water snakes in these regions (Figure 2).2 Copperheads, true to their name, are red in color; they inhabit a large portion of the southeastern United States and eastern Texas regions and are the cause of the majority of venomous snake bites in North America (Figure 3). Both cottonmouths and copperheads are believed to bite and envenomate as a defensive mechanism when provoked.


Coral snakes, found in the eastern United States and Texas regions, are the only subspecies of the Elapidae family (Figure 4).2,9 They can be distinguished from the nonvenomous milk snake by their characteristic banding, as coral snakes are patterned in a red-yellow-black band sequence and milk snakes are patterned in a red-black-yellow or white sequence. The differences in appearance of these snakes often is remembered by the phrase “red on yellow kills a fellow.”

Anatomic differences between the Viperidae and Elapidae families, including fang size, placement, and type, as well as venom composition, are directly linked to clinical manifestations of the bites. Viperidae fangs extend from the maxillary bones and are mobile, long, and hollow, making it easy for the snake to control fang movement and envenomation.9 Viperidae snakes are uniquely capable of inflicting puncture wounds without the injection of venom, known as dry bites. In contrast, Elapidae snakes have short, hollow, and fixed fangs, and thus patients can protect themselves by wearing appropriate clothing and covered footwear.9 Currently, identifying the type of snake responsible for the bite relies on visualization of the snake and/or the identification of clinical symptoms of envenomation by a dermatologist.
Clinical Manifestations of Venomous Snake Bites
Clinical manifestations and cutaneous findings often are used to grade the severity of venomous snake bites as well as to dictate treatment procedures. Grade 0 indicates a bite has occurred without envenomation, while grades I to V describe the progression and severity of envenomation.10 Grade I describes minimal erythema and edema around the site (fang marks may or may not be present) and no systemic symptoms. Grade II describes erythema and edema extending up the extremity to the first joint (eg, hand to wrist), pain, some systemic symptoms if there is rapid progression, and potential bleeding at the site. Grade III describes erythema and edema spreading to the second joint in the extremity, pain, and systemic symptoms, including coagulation defects. Grade IV describes erythema and edema of the whole extremity, a rapid reaction and progression following the bite, and risk for compartment syndrome. Grade V includes erythema and edema beyond the extremity and increasing systemic symptoms.10
Local pain and edema, usually on easily accessible or exposed extremities, are the most common clinical symptoms reported following a Viperidae snake bite.11 Due to their capability of producing a dry bite, puncture markings alone do not indicate envenomation. Patients will need to be monitored for several hours for signs of envenomation, which may include swelling, pain, ecchymosis, and indications of systemic manifestation (eg, weakness, dizziness, nausea, severe hypotension, thrombocytopenia).11 Viperidae venom hemorrhagic metalloproteinases act on capillary blood vessels by cleaving basement membrane proteins and allowing for extravasation of fluid into local tissue.12 The inflammatory response produced at the site of envenomation likely is due to the release of tumor necrosis factor á and endogenous matrix metalloprotein.12 There is a higher risk for death associated with bites from rattlesnakes within the Viperidae family because their venom contains a unique neurotoxin that works by blocking presynaptic junctions and causing a range of paralytic symptoms from ptosis to respiratory failure.13
The severity of Elapidae bites is thought to be related to the amount of venom injected, the size of the victim, and the length of the snake. Though clothing may offer protection, envenomation occurs in 75% of coral snake bites and can produce devastating consequences due to the venom content.14 In a retrospective study between 2002 and 2004, 90% of Elapidae snake bite patients (n=82) reported local pain, redness, and paresthesia, while around 7% developed systemic symptoms.15 Elapidae venom primarily is neurotoxic and is thought to spread via lymphatics.16 Delayed reactions are common and may take up to 12 hours to develop. Patients should be monitored, as local reactions may progress to weakness, fasciculations, extremity paralysis, and lastly, respiratory paralysis. Due to the risk for progression, all patients with likely coral snake bites should be given antivenin.8,15,17
Much like the North American coral snake, the venomous snake species Gloydius blomhoffii—referred to as the salmosa or mamushi snake depending on the region of origin (ie, Korea or Japan)—is a frequent source of devastating rural snake bites due to neurotoxins (Figure 5). The species’ slender fangs are thought to directly inject the snake’s potent venom, which contains hemorrhagic toxins and α-neurotoxins and Β-neurotoxins, into the bloodstream; however, the salmosa is considered a viper like the North American cottonmouth and copperhead because of its triangular head shape and hollow fangs, which allow for the accommodation of venom-containing glands and mechanism of venom injection. Salmosa venom shares both Viperidae and Elapidae characteristics. Cutaneous findings such as progressive edema, erythema, and bleeding frequently are reported and are attributed to the proteases and hemorrhagic toxins characteristic of vipers (Figure 6). α-Neurotoxins and Β-neurotoxins, similar to the proteolytic venom of the Elapidae family, are responsible for the unique visual disturbances (binocular diplopia) caused by the salmosa.12,18,19


Treatment
Treating snake bites begins with assessing the patient’s airway, breathing, and circulation, followed by a thorough medical and encounter history (including description of how the bite occurred). Due to the range of Viperidae symptoms, it generally is recommended that patients remove any restrictive clothing or jewelry near the bite and/or over the affected limb or body part, place the affected body part at the level of the heart, and go to the nearest medical facility for prompt care. Historically, empiric antibiotics often were used to prevent wound infections; however, studies have since demonstrated that antibiotics are not necessary and lack efficacy in uncomplicated snake bites.16,20 In a study of 114 pediatric cases from 1995 to 2005, it was determined that most patients could be managed with conservative treatment directed at pain management and swelling reduction via elevation of the affected extremity.6 While conservative management may be all that is needed to care for the majority of cases, one retrospective study from Texas indicated that 70% of pediatric venomous snake bites were treated with either intravenous antibiotics and/or antivenin, highlighting the variability in management and opportunity for improvement.21
Antivenin, specifically antivenin (Crotalidae) polyvalent, is the indicated treatment for Viperidae hemorrhagic or coagulopathic envenomation.13,22 Per guidelines from the World Health Organization, physical examination will yield a grading of the snake bite based on cutaneous findings. Grades III to V are considered moderate to severe and should be given antivenin.23 Physicians should look for signs of progressive injury and coagulopathy, such as increased swelling, bruising, hypotension, or altered mental status.22 Due to the major neurotoxic risks associated with Elapidae venom, all coral snake bites should be treated with antivenin; early intubation and ventilation may be considered.13 Similarly, patients who report a salmosa snake bite require prompt treatment with antivenin and/or cepharanthine, an additive agent to reduce swelling and pain.18 Due to the nature of the neurotoxins contained in the salmosa venom (α-neurotoxin causing postsynaptic inhibition of the neuromuscular junction and Β-neurotoxin inhibiting neurotransmitter release from the presynaptic terminal), anticholinesterases, which work by blocking the enzymatic breakdown of the neurotransmitter acetylcholine, should not be used.19 While bleeding and skin and systemic changes may be reversed by antivenin, visual changes are unlikely to resolve with antivenin administration due to the presynaptic binding of Β-neurotoxin and the blockade of neuromuscular signaling.19
Antivenin should be administered intravenously for the fastest onset of action in a setting suitable for the management of anaphylaxis.24 In situations when the benefits may outweigh the risks (eg, if the patient has had a prior allergic reaction or is not in an environment where they can be watched for at least 8 hours for progression of envenomation or adverse reactions), premedication with an antihistamine or epinephrine may be considered.17 Per the World Allergy Organization and World Health Organization, adverse reactions should be treated with crystalloid solutions and antihistamines, corticosteroids, or epinephrine as indicated.25 In a qualitative analysis of emergency physicians’ attitudes toward antivenin, most expressed treatment hesitancy due to lack of knowledge and experience using the medication.26 When possible, snake bites should thus be managed in consultation with a toxicologist.2
Conclusion
Snake bites and envenomation occur commonly in the United States due to exposure to a variety of venomous snakes in the North American Viperidae and Elapidae families. Appropriate and successful management of snake bites by physicians requires general knowledge of regional snakes, the cutaneous and systemic manifestations of snake bites and envenomation, and current treatment methods.
- Greene SC, Folt J, Wyatt K, et al. Epidemiology of fatal snakebites in the United States 1981-2018. Am J Emerg Med. 2021;45:309-316.
- Wozniak EJ, Wisser J, Schwartz M. Venomous adversaries: a reference to snake identification, field safety, and bite-victim first aid for disaster-response personnel deploying into the hurricaneprone regions of North America. Wilderness Environ Med. 2006; 17:246-266.
- Gummin DD, Mowry JB, Beuhler MC, et al. 2021 annual report of National Poison Data System (NPDS) from America’s Poison Centers: 39th Annual Report. Clin Toxicol (Phila). 2022;60:1381-1643.
- Chotai PN, Watlington J, Lewis S, et al. Pediatric snakebites: comparing patients in two geographic locations in the United States. J Surg Res. 2021;265:297-302.
- Johnson PN, McGoodwin L, Banner W Jr. Utilisation of Crotalidae polyvalent immune fab (ovine) for Viperidae envenomations in children. Emerg Med J. 2008;25:793-798.
- Tadros A, Sharon M, Davis S, et al. Emergency department visits by pediatric patients for snakebites. Pediatr Emerg Care. 2022; 38:279-282.
- Campbell BT, Corsi JM, Boneti C, et al. Pediatric snake bites: lessons learned from 114 cases. J Pediatr Surg. 2008;43:1338-1341.
- Peterson ME. Snake bites: coral snakes. Clin Tech Small Anim Pract. 2006;21:183-186.
- Porter KR. Herpetology. WB Saunders Company; 1972.
- Rana A, Kheora S. Grading and envenomation of the snake bite among the emergency cases in a medical college in rural India. Hmlyn Jr Appl Med Sci Res. 2021;2:33-36.
- Peterson ME. Snake bite: pit vipers. Clin Tech Small Anim Pract. 2006;21:174-182.
- Gutierrez JM, Rucavado A. Snake venom metalloproteinases: their role in the pathogenesis of local tissue damage. Biochimie. 2000;82:841-850.
- Weinstein SA, Dart RC, Staples A, et al. Envenomations: an overview of clinical toxicology for the primary care physician. Am Fam Physician. 2009;80:793-802.
- Kitchens CS, Van Mierop LH. Envenomation by the eastern coral snake (Micrurus fulvius fulvius): a study of 39 victims. JAMA. 1987;258:1615-1618.
- Morgan DL, Borys DJ, Stanford R, et al. Texas coral snake (Micrurus tener) bites. South Med J. 2007;100:152-156.
- Clark RF, Delden BS, Furbee B. The incidence of wound infection following crotalid envenomation. J Emerg Med. 1993; 11:583-586.
- Gold BS, Dart RC, Barish RA. Bites of venomous snakes. N Engl J Med. 2002;347:347-356.
- Hifumi T, Sakai A, Kondo Y, et al. Venomous snake bites: clinical diagnosis and treatment. J Intensive Care. 2015;3:16.
- Igari R, Iseki K, Abe S, et al. Binocular diplopia and ptosis due to snake bite (Agkistrodon blomhoffi “mamushi”) case report. Brain Nerve. 2010;62:273-277.
- Kerrigan KR, Mertz BL, Nelson SJ, et al. Antibiotic prophylaxis for pit viper envenomation: prospective, controlled trial. World J Surg. 1997;21:369-372.
- Correa JA, Fallon SC, Cruz AT, et al. Management of pediatric snake bites: are we doing too much? J Pediatr Surg. 2014;49:1009-1015.
- Dart RC, McNally J. Efficacy, safety and use of snake antivenoms in the United States. Ann Emerg Med. 2001;47:181-188.
- World Health Organization Regional Office for South-East Asia. Guidelines for the Management of Snakebites. 2nd ed. World Health Organization; 2016.
- Clark RF, McKinney PE, Chase PB, et al. Immediate and delayed allergic reactions to Crotalidae polyvalent immune Fab (ovine) antivenom. Ann Emerg Med. 2002;39:671-676.
- World Health Organization. WHO Guidelines for the production, control, and regulation of snake antivenom immunoglobulins. Accessed November 25, 2024. https://extranet.who.int/prequal/vaccines/guidelines-production-control-and-regulation-snake-antivenom-immunoglobulins
- Tupetz A, Barcenas LK, Phillips AJ, et al. Bites study: a qualitive analysis among emergency medicine physicians on snake envenomation management practices. PloS One. 2022;17:E0262215.
North American venomous snakes traditionally are classified as members of either the Viperidae (eg, rattlesnakes, copperheads, cottonmouths) or Elapidae (eg, coral snakes) families and account for roughly 5000 to 10,000 reported envenomations annually.1,2 In 2021, America’s Poison Centers reported 2287 calls related to copperheads, 71 related to coral snakes, 229 related to cottonmouths, 1184 related to rattlesnakes, and 524 related to unknown snakes.3 The majority of calls related to snake bites were for adult patients, resulting in absent to minor outcomes. Only 1 death due to a rattlesnake bite was reported.3 Death by envenomation from a North American snake species is considered rare and typically is attributed to a lapse in medical attention; however, rattlesnakes are the most common reported cause of death by snake envenomation (Figure 1).1,3 A study comparing snake bites and hospital stays in the southeast vs southwest United States found that the southeast had the highest incidence of copperhead bites (37%), while the southwest had a higher incidence of rattlesnake bites (70%); those who were bitten by a rattlesnake were reported to have more severe symptoms and greater need for medical attention and antivenin.4 Some reports have linked pediatric and elderly patients to worse outcomes.5 However, one study examining 24,388 emergency department visits for snake bites from 2006 through 2014 found that the majority of pediatric cases were handled by non– trauma centers in the southern United States,6 supporting evidence found by Campbell et al7 indicating that most snake bites in children can be managed with conservative care. Though reported complications—including weakness, paralysis, hypovolemic shock, thrombocytopenia, and death—from North American venomous snake bites are low, they are still considered a medical emergency.8 It is essential for physicians to understand the clinical manifestations and treatment of North American venomous snake bites and to educate patients on how to protect themselves against and avoid provoking snakes, particularly in rural areas.2 In this article, we review the characteristics of common North American venomous snakes and the clinical manifestations of their bites. We also discuss the appropriate measures for staging, evaluating, and treating snake envenomation to improve patient management and care.

Features of North American Venomous Snakes
Individual snakes within the Viperidae family vary in size, markings and coloration, activity, and region, and physicians should consult their local health departments regarding snakes that are common in their area.2 Cottonmouth snakes are semiaquatic and traditionally are found within the southern and central United States. With a spade-shaped head and distinct two-tone coloration, cottonmouths may be mistaken for other nonvenomous water snakes in these regions (Figure 2).2 Copperheads, true to their name, are red in color; they inhabit a large portion of the southeastern United States and eastern Texas regions and are the cause of the majority of venomous snake bites in North America (Figure 3). Both cottonmouths and copperheads are believed to bite and envenomate as a defensive mechanism when provoked.


Coral snakes, found in the eastern United States and Texas regions, are the only subspecies of the Elapidae family (Figure 4).2,9 They can be distinguished from the nonvenomous milk snake by their characteristic banding, as coral snakes are patterned in a red-yellow-black band sequence and milk snakes are patterned in a red-black-yellow or white sequence. The differences in appearance of these snakes often is remembered by the phrase “red on yellow kills a fellow.”

Anatomic differences between the Viperidae and Elapidae families, including fang size, placement, and type, as well as venom composition, are directly linked to clinical manifestations of the bites. Viperidae fangs extend from the maxillary bones and are mobile, long, and hollow, making it easy for the snake to control fang movement and envenomation.9 Viperidae snakes are uniquely capable of inflicting puncture wounds without the injection of venom, known as dry bites. In contrast, Elapidae snakes have short, hollow, and fixed fangs, and thus patients can protect themselves by wearing appropriate clothing and covered footwear.9 Currently, identifying the type of snake responsible for the bite relies on visualization of the snake and/or the identification of clinical symptoms of envenomation by a dermatologist.
Clinical Manifestations of Venomous Snake Bites
Clinical manifestations and cutaneous findings often are used to grade the severity of venomous snake bites as well as to dictate treatment procedures. Grade 0 indicates a bite has occurred without envenomation, while grades I to V describe the progression and severity of envenomation.10 Grade I describes minimal erythema and edema around the site (fang marks may or may not be present) and no systemic symptoms. Grade II describes erythema and edema extending up the extremity to the first joint (eg, hand to wrist), pain, some systemic symptoms if there is rapid progression, and potential bleeding at the site. Grade III describes erythema and edema spreading to the second joint in the extremity, pain, and systemic symptoms, including coagulation defects. Grade IV describes erythema and edema of the whole extremity, a rapid reaction and progression following the bite, and risk for compartment syndrome. Grade V includes erythema and edema beyond the extremity and increasing systemic symptoms.10
Local pain and edema, usually on easily accessible or exposed extremities, are the most common clinical symptoms reported following a Viperidae snake bite.11 Due to their capability of producing a dry bite, puncture markings alone do not indicate envenomation. Patients will need to be monitored for several hours for signs of envenomation, which may include swelling, pain, ecchymosis, and indications of systemic manifestation (eg, weakness, dizziness, nausea, severe hypotension, thrombocytopenia).11 Viperidae venom hemorrhagic metalloproteinases act on capillary blood vessels by cleaving basement membrane proteins and allowing for extravasation of fluid into local tissue.12 The inflammatory response produced at the site of envenomation likely is due to the release of tumor necrosis factor á and endogenous matrix metalloprotein.12 There is a higher risk for death associated with bites from rattlesnakes within the Viperidae family because their venom contains a unique neurotoxin that works by blocking presynaptic junctions and causing a range of paralytic symptoms from ptosis to respiratory failure.13
The severity of Elapidae bites is thought to be related to the amount of venom injected, the size of the victim, and the length of the snake. Though clothing may offer protection, envenomation occurs in 75% of coral snake bites and can produce devastating consequences due to the venom content.14 In a retrospective study between 2002 and 2004, 90% of Elapidae snake bite patients (n=82) reported local pain, redness, and paresthesia, while around 7% developed systemic symptoms.15 Elapidae venom primarily is neurotoxic and is thought to spread via lymphatics.16 Delayed reactions are common and may take up to 12 hours to develop. Patients should be monitored, as local reactions may progress to weakness, fasciculations, extremity paralysis, and lastly, respiratory paralysis. Due to the risk for progression, all patients with likely coral snake bites should be given antivenin.8,15,17
Much like the North American coral snake, the venomous snake species Gloydius blomhoffii—referred to as the salmosa or mamushi snake depending on the region of origin (ie, Korea or Japan)—is a frequent source of devastating rural snake bites due to neurotoxins (Figure 5). The species’ slender fangs are thought to directly inject the snake’s potent venom, which contains hemorrhagic toxins and α-neurotoxins and Β-neurotoxins, into the bloodstream; however, the salmosa is considered a viper like the North American cottonmouth and copperhead because of its triangular head shape and hollow fangs, which allow for the accommodation of venom-containing glands and mechanism of venom injection. Salmosa venom shares both Viperidae and Elapidae characteristics. Cutaneous findings such as progressive edema, erythema, and bleeding frequently are reported and are attributed to the proteases and hemorrhagic toxins characteristic of vipers (Figure 6). α-Neurotoxins and Β-neurotoxins, similar to the proteolytic venom of the Elapidae family, are responsible for the unique visual disturbances (binocular diplopia) caused by the salmosa.12,18,19


Treatment
Treating snake bites begins with assessing the patient’s airway, breathing, and circulation, followed by a thorough medical and encounter history (including description of how the bite occurred). Due to the range of Viperidae symptoms, it generally is recommended that patients remove any restrictive clothing or jewelry near the bite and/or over the affected limb or body part, place the affected body part at the level of the heart, and go to the nearest medical facility for prompt care. Historically, empiric antibiotics often were used to prevent wound infections; however, studies have since demonstrated that antibiotics are not necessary and lack efficacy in uncomplicated snake bites.16,20 In a study of 114 pediatric cases from 1995 to 2005, it was determined that most patients could be managed with conservative treatment directed at pain management and swelling reduction via elevation of the affected extremity.6 While conservative management may be all that is needed to care for the majority of cases, one retrospective study from Texas indicated that 70% of pediatric venomous snake bites were treated with either intravenous antibiotics and/or antivenin, highlighting the variability in management and opportunity for improvement.21
Antivenin, specifically antivenin (Crotalidae) polyvalent, is the indicated treatment for Viperidae hemorrhagic or coagulopathic envenomation.13,22 Per guidelines from the World Health Organization, physical examination will yield a grading of the snake bite based on cutaneous findings. Grades III to V are considered moderate to severe and should be given antivenin.23 Physicians should look for signs of progressive injury and coagulopathy, such as increased swelling, bruising, hypotension, or altered mental status.22 Due to the major neurotoxic risks associated with Elapidae venom, all coral snake bites should be treated with antivenin; early intubation and ventilation may be considered.13 Similarly, patients who report a salmosa snake bite require prompt treatment with antivenin and/or cepharanthine, an additive agent to reduce swelling and pain.18 Due to the nature of the neurotoxins contained in the salmosa venom (α-neurotoxin causing postsynaptic inhibition of the neuromuscular junction and Β-neurotoxin inhibiting neurotransmitter release from the presynaptic terminal), anticholinesterases, which work by blocking the enzymatic breakdown of the neurotransmitter acetylcholine, should not be used.19 While bleeding and skin and systemic changes may be reversed by antivenin, visual changes are unlikely to resolve with antivenin administration due to the presynaptic binding of Β-neurotoxin and the blockade of neuromuscular signaling.19
Antivenin should be administered intravenously for the fastest onset of action in a setting suitable for the management of anaphylaxis.24 In situations when the benefits may outweigh the risks (eg, if the patient has had a prior allergic reaction or is not in an environment where they can be watched for at least 8 hours for progression of envenomation or adverse reactions), premedication with an antihistamine or epinephrine may be considered.17 Per the World Allergy Organization and World Health Organization, adverse reactions should be treated with crystalloid solutions and antihistamines, corticosteroids, or epinephrine as indicated.25 In a qualitative analysis of emergency physicians’ attitudes toward antivenin, most expressed treatment hesitancy due to lack of knowledge and experience using the medication.26 When possible, snake bites should thus be managed in consultation with a toxicologist.2
Conclusion
Snake bites and envenomation occur commonly in the United States due to exposure to a variety of venomous snakes in the North American Viperidae and Elapidae families. Appropriate and successful management of snake bites by physicians requires general knowledge of regional snakes, the cutaneous and systemic manifestations of snake bites and envenomation, and current treatment methods.
North American venomous snakes traditionally are classified as members of either the Viperidae (eg, rattlesnakes, copperheads, cottonmouths) or Elapidae (eg, coral snakes) families and account for roughly 5000 to 10,000 reported envenomations annually.1,2 In 2021, America’s Poison Centers reported 2287 calls related to copperheads, 71 related to coral snakes, 229 related to cottonmouths, 1184 related to rattlesnakes, and 524 related to unknown snakes.3 The majority of calls related to snake bites were for adult patients, resulting in absent to minor outcomes. Only 1 death due to a rattlesnake bite was reported.3 Death by envenomation from a North American snake species is considered rare and typically is attributed to a lapse in medical attention; however, rattlesnakes are the most common reported cause of death by snake envenomation (Figure 1).1,3 A study comparing snake bites and hospital stays in the southeast vs southwest United States found that the southeast had the highest incidence of copperhead bites (37%), while the southwest had a higher incidence of rattlesnake bites (70%); those who were bitten by a rattlesnake were reported to have more severe symptoms and greater need for medical attention and antivenin.4 Some reports have linked pediatric and elderly patients to worse outcomes.5 However, one study examining 24,388 emergency department visits for snake bites from 2006 through 2014 found that the majority of pediatric cases were handled by non– trauma centers in the southern United States,6 supporting evidence found by Campbell et al7 indicating that most snake bites in children can be managed with conservative care. Though reported complications—including weakness, paralysis, hypovolemic shock, thrombocytopenia, and death—from North American venomous snake bites are low, they are still considered a medical emergency.8 It is essential for physicians to understand the clinical manifestations and treatment of North American venomous snake bites and to educate patients on how to protect themselves against and avoid provoking snakes, particularly in rural areas.2 In this article, we review the characteristics of common North American venomous snakes and the clinical manifestations of their bites. We also discuss the appropriate measures for staging, evaluating, and treating snake envenomation to improve patient management and care.

Features of North American Venomous Snakes
Individual snakes within the Viperidae family vary in size, markings and coloration, activity, and region, and physicians should consult their local health departments regarding snakes that are common in their area.2 Cottonmouth snakes are semiaquatic and traditionally are found within the southern and central United States. With a spade-shaped head and distinct two-tone coloration, cottonmouths may be mistaken for other nonvenomous water snakes in these regions (Figure 2).2 Copperheads, true to their name, are red in color; they inhabit a large portion of the southeastern United States and eastern Texas regions and are the cause of the majority of venomous snake bites in North America (Figure 3). Both cottonmouths and copperheads are believed to bite and envenomate as a defensive mechanism when provoked.


Coral snakes, found in the eastern United States and Texas regions, are the only subspecies of the Elapidae family (Figure 4).2,9 They can be distinguished from the nonvenomous milk snake by their characteristic banding, as coral snakes are patterned in a red-yellow-black band sequence and milk snakes are patterned in a red-black-yellow or white sequence. The differences in appearance of these snakes often is remembered by the phrase “red on yellow kills a fellow.”

Anatomic differences between the Viperidae and Elapidae families, including fang size, placement, and type, as well as venom composition, are directly linked to clinical manifestations of the bites. Viperidae fangs extend from the maxillary bones and are mobile, long, and hollow, making it easy for the snake to control fang movement and envenomation.9 Viperidae snakes are uniquely capable of inflicting puncture wounds without the injection of venom, known as dry bites. In contrast, Elapidae snakes have short, hollow, and fixed fangs, and thus patients can protect themselves by wearing appropriate clothing and covered footwear.9 Currently, identifying the type of snake responsible for the bite relies on visualization of the snake and/or the identification of clinical symptoms of envenomation by a dermatologist.
Clinical Manifestations of Venomous Snake Bites
Clinical manifestations and cutaneous findings often are used to grade the severity of venomous snake bites as well as to dictate treatment procedures. Grade 0 indicates a bite has occurred without envenomation, while grades I to V describe the progression and severity of envenomation.10 Grade I describes minimal erythema and edema around the site (fang marks may or may not be present) and no systemic symptoms. Grade II describes erythema and edema extending up the extremity to the first joint (eg, hand to wrist), pain, some systemic symptoms if there is rapid progression, and potential bleeding at the site. Grade III describes erythema and edema spreading to the second joint in the extremity, pain, and systemic symptoms, including coagulation defects. Grade IV describes erythema and edema of the whole extremity, a rapid reaction and progression following the bite, and risk for compartment syndrome. Grade V includes erythema and edema beyond the extremity and increasing systemic symptoms.10
Local pain and edema, usually on easily accessible or exposed extremities, are the most common clinical symptoms reported following a Viperidae snake bite.11 Due to their capability of producing a dry bite, puncture markings alone do not indicate envenomation. Patients will need to be monitored for several hours for signs of envenomation, which may include swelling, pain, ecchymosis, and indications of systemic manifestation (eg, weakness, dizziness, nausea, severe hypotension, thrombocytopenia).11 Viperidae venom hemorrhagic metalloproteinases act on capillary blood vessels by cleaving basement membrane proteins and allowing for extravasation of fluid into local tissue.12 The inflammatory response produced at the site of envenomation likely is due to the release of tumor necrosis factor á and endogenous matrix metalloprotein.12 There is a higher risk for death associated with bites from rattlesnakes within the Viperidae family because their venom contains a unique neurotoxin that works by blocking presynaptic junctions and causing a range of paralytic symptoms from ptosis to respiratory failure.13
The severity of Elapidae bites is thought to be related to the amount of venom injected, the size of the victim, and the length of the snake. Though clothing may offer protection, envenomation occurs in 75% of coral snake bites and can produce devastating consequences due to the venom content.14 In a retrospective study between 2002 and 2004, 90% of Elapidae snake bite patients (n=82) reported local pain, redness, and paresthesia, while around 7% developed systemic symptoms.15 Elapidae venom primarily is neurotoxic and is thought to spread via lymphatics.16 Delayed reactions are common and may take up to 12 hours to develop. Patients should be monitored, as local reactions may progress to weakness, fasciculations, extremity paralysis, and lastly, respiratory paralysis. Due to the risk for progression, all patients with likely coral snake bites should be given antivenin.8,15,17
Much like the North American coral snake, the venomous snake species Gloydius blomhoffii—referred to as the salmosa or mamushi snake depending on the region of origin (ie, Korea or Japan)—is a frequent source of devastating rural snake bites due to neurotoxins (Figure 5). The species’ slender fangs are thought to directly inject the snake’s potent venom, which contains hemorrhagic toxins and α-neurotoxins and Β-neurotoxins, into the bloodstream; however, the salmosa is considered a viper like the North American cottonmouth and copperhead because of its triangular head shape and hollow fangs, which allow for the accommodation of venom-containing glands and mechanism of venom injection. Salmosa venom shares both Viperidae and Elapidae characteristics. Cutaneous findings such as progressive edema, erythema, and bleeding frequently are reported and are attributed to the proteases and hemorrhagic toxins characteristic of vipers (Figure 6). α-Neurotoxins and Β-neurotoxins, similar to the proteolytic venom of the Elapidae family, are responsible for the unique visual disturbances (binocular diplopia) caused by the salmosa.12,18,19


Treatment
Treating snake bites begins with assessing the patient’s airway, breathing, and circulation, followed by a thorough medical and encounter history (including description of how the bite occurred). Due to the range of Viperidae symptoms, it generally is recommended that patients remove any restrictive clothing or jewelry near the bite and/or over the affected limb or body part, place the affected body part at the level of the heart, and go to the nearest medical facility for prompt care. Historically, empiric antibiotics often were used to prevent wound infections; however, studies have since demonstrated that antibiotics are not necessary and lack efficacy in uncomplicated snake bites.16,20 In a study of 114 pediatric cases from 1995 to 2005, it was determined that most patients could be managed with conservative treatment directed at pain management and swelling reduction via elevation of the affected extremity.6 While conservative management may be all that is needed to care for the majority of cases, one retrospective study from Texas indicated that 70% of pediatric venomous snake bites were treated with either intravenous antibiotics and/or antivenin, highlighting the variability in management and opportunity for improvement.21
Antivenin, specifically antivenin (Crotalidae) polyvalent, is the indicated treatment for Viperidae hemorrhagic or coagulopathic envenomation.13,22 Per guidelines from the World Health Organization, physical examination will yield a grading of the snake bite based on cutaneous findings. Grades III to V are considered moderate to severe and should be given antivenin.23 Physicians should look for signs of progressive injury and coagulopathy, such as increased swelling, bruising, hypotension, or altered mental status.22 Due to the major neurotoxic risks associated with Elapidae venom, all coral snake bites should be treated with antivenin; early intubation and ventilation may be considered.13 Similarly, patients who report a salmosa snake bite require prompt treatment with antivenin and/or cepharanthine, an additive agent to reduce swelling and pain.18 Due to the nature of the neurotoxins contained in the salmosa venom (α-neurotoxin causing postsynaptic inhibition of the neuromuscular junction and Β-neurotoxin inhibiting neurotransmitter release from the presynaptic terminal), anticholinesterases, which work by blocking the enzymatic breakdown of the neurotransmitter acetylcholine, should not be used.19 While bleeding and skin and systemic changes may be reversed by antivenin, visual changes are unlikely to resolve with antivenin administration due to the presynaptic binding of Β-neurotoxin and the blockade of neuromuscular signaling.19
Antivenin should be administered intravenously for the fastest onset of action in a setting suitable for the management of anaphylaxis.24 In situations when the benefits may outweigh the risks (eg, if the patient has had a prior allergic reaction or is not in an environment where they can be watched for at least 8 hours for progression of envenomation or adverse reactions), premedication with an antihistamine or epinephrine may be considered.17 Per the World Allergy Organization and World Health Organization, adverse reactions should be treated with crystalloid solutions and antihistamines, corticosteroids, or epinephrine as indicated.25 In a qualitative analysis of emergency physicians’ attitudes toward antivenin, most expressed treatment hesitancy due to lack of knowledge and experience using the medication.26 When possible, snake bites should thus be managed in consultation with a toxicologist.2
Conclusion
Snake bites and envenomation occur commonly in the United States due to exposure to a variety of venomous snakes in the North American Viperidae and Elapidae families. Appropriate and successful management of snake bites by physicians requires general knowledge of regional snakes, the cutaneous and systemic manifestations of snake bites and envenomation, and current treatment methods.
- Greene SC, Folt J, Wyatt K, et al. Epidemiology of fatal snakebites in the United States 1981-2018. Am J Emerg Med. 2021;45:309-316.
- Wozniak EJ, Wisser J, Schwartz M. Venomous adversaries: a reference to snake identification, field safety, and bite-victim first aid for disaster-response personnel deploying into the hurricaneprone regions of North America. Wilderness Environ Med. 2006; 17:246-266.
- Gummin DD, Mowry JB, Beuhler MC, et al. 2021 annual report of National Poison Data System (NPDS) from America’s Poison Centers: 39th Annual Report. Clin Toxicol (Phila). 2022;60:1381-1643.
- Chotai PN, Watlington J, Lewis S, et al. Pediatric snakebites: comparing patients in two geographic locations in the United States. J Surg Res. 2021;265:297-302.
- Johnson PN, McGoodwin L, Banner W Jr. Utilisation of Crotalidae polyvalent immune fab (ovine) for Viperidae envenomations in children. Emerg Med J. 2008;25:793-798.
- Tadros A, Sharon M, Davis S, et al. Emergency department visits by pediatric patients for snakebites. Pediatr Emerg Care. 2022; 38:279-282.
- Campbell BT, Corsi JM, Boneti C, et al. Pediatric snake bites: lessons learned from 114 cases. J Pediatr Surg. 2008;43:1338-1341.
- Peterson ME. Snake bites: coral snakes. Clin Tech Small Anim Pract. 2006;21:183-186.
- Porter KR. Herpetology. WB Saunders Company; 1972.
- Rana A, Kheora S. Grading and envenomation of the snake bite among the emergency cases in a medical college in rural India. Hmlyn Jr Appl Med Sci Res. 2021;2:33-36.
- Peterson ME. Snake bite: pit vipers. Clin Tech Small Anim Pract. 2006;21:174-182.
- Gutierrez JM, Rucavado A. Snake venom metalloproteinases: their role in the pathogenesis of local tissue damage. Biochimie. 2000;82:841-850.
- Weinstein SA, Dart RC, Staples A, et al. Envenomations: an overview of clinical toxicology for the primary care physician. Am Fam Physician. 2009;80:793-802.
- Kitchens CS, Van Mierop LH. Envenomation by the eastern coral snake (Micrurus fulvius fulvius): a study of 39 victims. JAMA. 1987;258:1615-1618.
- Morgan DL, Borys DJ, Stanford R, et al. Texas coral snake (Micrurus tener) bites. South Med J. 2007;100:152-156.
- Clark RF, Delden BS, Furbee B. The incidence of wound infection following crotalid envenomation. J Emerg Med. 1993; 11:583-586.
- Gold BS, Dart RC, Barish RA. Bites of venomous snakes. N Engl J Med. 2002;347:347-356.
- Hifumi T, Sakai A, Kondo Y, et al. Venomous snake bites: clinical diagnosis and treatment. J Intensive Care. 2015;3:16.
- Igari R, Iseki K, Abe S, et al. Binocular diplopia and ptosis due to snake bite (Agkistrodon blomhoffi “mamushi”) case report. Brain Nerve. 2010;62:273-277.
- Kerrigan KR, Mertz BL, Nelson SJ, et al. Antibiotic prophylaxis for pit viper envenomation: prospective, controlled trial. World J Surg. 1997;21:369-372.
- Correa JA, Fallon SC, Cruz AT, et al. Management of pediatric snake bites: are we doing too much? J Pediatr Surg. 2014;49:1009-1015.
- Dart RC, McNally J. Efficacy, safety and use of snake antivenoms in the United States. Ann Emerg Med. 2001;47:181-188.
- World Health Organization Regional Office for South-East Asia. Guidelines for the Management of Snakebites. 2nd ed. World Health Organization; 2016.
- Clark RF, McKinney PE, Chase PB, et al. Immediate and delayed allergic reactions to Crotalidae polyvalent immune Fab (ovine) antivenom. Ann Emerg Med. 2002;39:671-676.
- World Health Organization. WHO Guidelines for the production, control, and regulation of snake antivenom immunoglobulins. Accessed November 25, 2024. https://extranet.who.int/prequal/vaccines/guidelines-production-control-and-regulation-snake-antivenom-immunoglobulins
- Tupetz A, Barcenas LK, Phillips AJ, et al. Bites study: a qualitive analysis among emergency medicine physicians on snake envenomation management practices. PloS One. 2022;17:E0262215.
- Greene SC, Folt J, Wyatt K, et al. Epidemiology of fatal snakebites in the United States 1981-2018. Am J Emerg Med. 2021;45:309-316.
- Wozniak EJ, Wisser J, Schwartz M. Venomous adversaries: a reference to snake identification, field safety, and bite-victim first aid for disaster-response personnel deploying into the hurricaneprone regions of North America. Wilderness Environ Med. 2006; 17:246-266.
- Gummin DD, Mowry JB, Beuhler MC, et al. 2021 annual report of National Poison Data System (NPDS) from America’s Poison Centers: 39th Annual Report. Clin Toxicol (Phila). 2022;60:1381-1643.
- Chotai PN, Watlington J, Lewis S, et al. Pediatric snakebites: comparing patients in two geographic locations in the United States. J Surg Res. 2021;265:297-302.
- Johnson PN, McGoodwin L, Banner W Jr. Utilisation of Crotalidae polyvalent immune fab (ovine) for Viperidae envenomations in children. Emerg Med J. 2008;25:793-798.
- Tadros A, Sharon M, Davis S, et al. Emergency department visits by pediatric patients for snakebites. Pediatr Emerg Care. 2022; 38:279-282.
- Campbell BT, Corsi JM, Boneti C, et al. Pediatric snake bites: lessons learned from 114 cases. J Pediatr Surg. 2008;43:1338-1341.
- Peterson ME. Snake bites: coral snakes. Clin Tech Small Anim Pract. 2006;21:183-186.
- Porter KR. Herpetology. WB Saunders Company; 1972.
- Rana A, Kheora S. Grading and envenomation of the snake bite among the emergency cases in a medical college in rural India. Hmlyn Jr Appl Med Sci Res. 2021;2:33-36.
- Peterson ME. Snake bite: pit vipers. Clin Tech Small Anim Pract. 2006;21:174-182.
- Gutierrez JM, Rucavado A. Snake venom metalloproteinases: their role in the pathogenesis of local tissue damage. Biochimie. 2000;82:841-850.
- Weinstein SA, Dart RC, Staples A, et al. Envenomations: an overview of clinical toxicology for the primary care physician. Am Fam Physician. 2009;80:793-802.
- Kitchens CS, Van Mierop LH. Envenomation by the eastern coral snake (Micrurus fulvius fulvius): a study of 39 victims. JAMA. 1987;258:1615-1618.
- Morgan DL, Borys DJ, Stanford R, et al. Texas coral snake (Micrurus tener) bites. South Med J. 2007;100:152-156.
- Clark RF, Delden BS, Furbee B. The incidence of wound infection following crotalid envenomation. J Emerg Med. 1993; 11:583-586.
- Gold BS, Dart RC, Barish RA. Bites of venomous snakes. N Engl J Med. 2002;347:347-356.
- Hifumi T, Sakai A, Kondo Y, et al. Venomous snake bites: clinical diagnosis and treatment. J Intensive Care. 2015;3:16.
- Igari R, Iseki K, Abe S, et al. Binocular diplopia and ptosis due to snake bite (Agkistrodon blomhoffi “mamushi”) case report. Brain Nerve. 2010;62:273-277.
- Kerrigan KR, Mertz BL, Nelson SJ, et al. Antibiotic prophylaxis for pit viper envenomation: prospective, controlled trial. World J Surg. 1997;21:369-372.
- Correa JA, Fallon SC, Cruz AT, et al. Management of pediatric snake bites: are we doing too much? J Pediatr Surg. 2014;49:1009-1015.
- Dart RC, McNally J. Efficacy, safety and use of snake antivenoms in the United States. Ann Emerg Med. 2001;47:181-188.
- World Health Organization Regional Office for South-East Asia. Guidelines for the Management of Snakebites. 2nd ed. World Health Organization; 2016.
- Clark RF, McKinney PE, Chase PB, et al. Immediate and delayed allergic reactions to Crotalidae polyvalent immune Fab (ovine) antivenom. Ann Emerg Med. 2002;39:671-676.
- World Health Organization. WHO Guidelines for the production, control, and regulation of snake antivenom immunoglobulins. Accessed November 25, 2024. https://extranet.who.int/prequal/vaccines/guidelines-production-control-and-regulation-snake-antivenom-immunoglobulins
- Tupetz A, Barcenas LK, Phillips AJ, et al. Bites study: a qualitive analysis among emergency medicine physicians on snake envenomation management practices. PloS One. 2022;17:E0262215.
Key Features of North American Venomous Snake Bites
Key Features of North American Venomous Snake Bites
PRACTICE POINTS
- Venomous snake bites require prompt medical attention and assessment of symptoms to determine the optimal course of management and need for antivenin.
- Envenomation may cause may cause discoloration and swelling of the skin as well as thrombotic or paralytic changes.
Buruli Ulcer Transmission: Environmental Pathways and Implications for Dermatologic Care
Buruli Ulcer Transmission: Environmental Pathways and Implications for Dermatologic Care
Buruli ulcer (BU) is a potentially disabling necrotizing skin and soft tissue disease caused by Mycobacterium ulcerans infection.1,2 Buruli ulcer is most common in hot and humid climates and has caused considerable morbidity in Western African countries (Côte d’Ivoire, Ghana, and Benin account for 73% of annual cases) and the temperate areas of Australia (283 reported cases in 2017).1-4 In fact, the first recognizable cases of BU were described in 6 Australian individuals living in a riverine area in 1948, although the term Buruli ulcer is derived from the increased number of cases reported from Buruli county in Uganda near the Nile River.1,3,4
From 2002 to 2017, 66,000 cases of BU were reported in 33 countries.1 While the focal distribution has been demonstrated in the tropical areas of Sri Lanka, Malaysia, Papua New Guinea, Peru, and Mexico,4 nontropical nations such as Japan also are affected. Since 1981, 66 cases have been reported in Japan with M ulcerans subspecies—primarily Shinshuense, which has adapted to higher latitudes.1 Herein, we provide an overview of the pathogenesis, clinical presentation, and treatment of BU and highlight aquatic insects and mosquitoes as possible vectors of transmission.
Pathogenesis
Mycobacterium ulcerans is a nontuberculous mycobacterium and ubiquitous acid-fast gram-positive bacillus that can be cultured using a Lowenstein-Jensen agar and has a doubling rate of 48 hours.1,5 It produces the small 174-kb plasmid pMUM001-encoded compound mycolactone, a pathogenic toxin that causes immunosuppression, analgesia, and cytotoxic-associated tissue necrosis.1,5-9
Mycolactone is a polyketide macrolide with a 12-membrane lactone with 2 attached acyl side chains.1,7 Mycolactone is synthesized by the giant polyketide synthetases of M ulcerans. Mycolactone post-transcriptionally inhibits the development of lipopolysaccharide-dependent proinflammatory mediators—specifically by blocking protein translocation from the cytosol into the endoplasmic reticulum by targeting the SEC61 translocon.1,6 The lack of translocation of 30% to 50% of proteins leads to cellular stress and apoptosis mediated by Bim/Bcl2. A single point mutation in the SEC61 translocon subunit alpha 1 gene (SEC61A1) is associated with resistance to the cytotoxic effects of mycolactone.1
There are divergent hypotheses regarding the relationship of mycolactone to the Wiskott-Aldrich syndrome protein, with some researchers suggesting that mycolactone can attach to this protein, leading to cell detachment and death.7 However, others have proposed that mycolactone inhibits mTOR, activating the Wiskott-Aldrich syndrome protein and leading to subsequent extensive cytoskeleton remodeling.1 Mycolactone also can cause hypoesthesia, either by activating type 2 angiotensin II receptors and creating downstream neuron hyperpolarization or by killing Schwann cells.1
Transmission
Buruli ulcer caused by M ulcerans has a poorly understood transmission mechanism, and further studies are required to understand the underlying pathophysiology to decrease transmission rates and associated morbidity. Buruli ulcer is widely accepted to be transmitted to humans via predominantly water-rich environments; most cases occur around slow-moving and still bodies of water such as swamps, ponds, and marshes.1Mycobacterium ulcerans DNA has been found in fish, water insects, and snails.1,4 It also has been present in samples from aquatic insects such as Hemiptera (water strider), Naucoridae (creeping water bugs and saucer bugs), and Belostomatidae (giant water bugs) in West Africa and also from Aulacodes feces and moss.1
Variations in geographic climate may lead to different modes of transmission of BU. For example, mosquitoes have been studied as a potential vector for BU in the temperate climate of Australia.2 However, more data are needed from other countries to support mosquitoes as possible vectors. Wallace et al10 performed a study that showed skin puncture from insect bites or other injuries increases the chance of transmitting M ulcerans in the environment to the skin.
Clinical Presentation
Buruli ulcer most often manifests in healthy children younger than 15 years.1,8 Potential risk factors include residing near a contaminated water source, swimming in a river, and being bitten by an insect in a river during the rainy season. Lack of protective clothing and mosquito nets also have been proposed as considerable risk factors for BU.2 Genetic polymorphism in the solute carrier family 11 member 1 gene (SLC11A1) may increase the risk for BU with M ulcerans transmission. It is essential to understand that infection with M ulcerans does not always lead to the development of BU.1
Buruli ulcer often begins as a painless nodule or papule that patients may confuse with an insect bite. Within a couple of weeks, the induration will grow into ill-defined edematous plaques that gradually turn into necrotic skin, which will eventually slough off to create painless to mildly painful irregular skin ulceration (Figure).11 The surrounding uninvolved skin often is edematous and pigmented. Unfortunately, deep ulcerations can lead to osteomyelitis with exposure of the underlying bone. A secondary bacterial infection may be involved if a foul smell accompanies the ulcer. The vast extension of the ulcer has been known to lead to amputations, contractures, or deformities.1-5 The nodule progression to ulceration varies and can occur within 3 weeks to 1 year of the initial exposure.1,8
skin, which will eventually slough off to create painless to mildly painful
irregular skin ulceration. The image is in the public domain. Ezzedine K,
Pistone T, Cottin J, et al. Buruli ulcer in long-term traveler to Senegal.
Emerg Infect Dis. 2009;15:118-119. doi:10.3201/eid1501.080123
The World Health Organization (WHO) classifies BU into 3 categories: category 1 includes ulcers less than 5 cm in diameter; category 2 involves ulcers that are 5 to 15 cm in diameter; and category 3 involves ulcers that are larger than 15 cm in diameter as well as those involving the breasts, genitals, eyes, bones, or joints.4,8
Diagnosis
Cultures and microscopic examination of M ulcerans acid-fast bacilli can be used to confirm the diagnosis of BU. However, polymerase chain reaction (PCR) is the best confirmatory test, as the WHO reports that 70% of reported cases of BU are confirmed by PCR detection of DNA.1,4 Unfortunately, many BU-endemic areas lack feasible access to perform confirmatory tests such as PCR. Antigen detection assays, loop-mediated isothermal amplification tests, and detection of mycolactone by thinlayer chromatography are being developed to create more rapid and sensitive testing for BU.12
The lack of diagnostic testing for BU means physicians must rely on clinical diagnosis.1 However, the differential diagnosis is extensive and includes ulcers due to diabetes and arterial and venous insufficiency, cutaneous leishmaniasis, and Haemophilus ducreyi ulcers.5 Despite the broad differential, Eddyani et al12 found that BU diagnosed clinically by physicians had a sensitivity of 92%.
Treatment
Surgery was the first-line treatment for BU before the introduction of antibiotics for this condition. Antibiotics have created better outcomes with increased cure rates and decreased amputation.4
Pharmacotherapy—In the early 2000s, the WHO recommended a treatment regimen of once-daily 10 mg/kg rifampin (oral) and 15 mg/kg streptomycin ( intramuscular) for 8 weeks. This treatment protocol is effective for lesions measuring less than 10 cm in diameter and has an average cure rate of 50%.5 Unfortunately, streptomycin is associated with ototoxicity and nephrotoxicity.1,4 Clinicians should be aware that 1.9% to 26% of patients may have paradoxical worsening of BU early during antibiotic use due to increased host inflammatory response, but it subsides with continued treatment.1,4
Researchers in Australia have begun testing and using rifampin plus oral clarithromycin, ciprofloxacin, or moxifloxacin for 3 months. A common combination is oncedaily 10 mg/kg rifampicin and 400 mg/kg moxifloxacin.1 After multiple randomized controlled trials showed the efficacy of rifampicin in combination with clarithromycin, many physicians now recommend 10 mg/kg of rifampicin once daily and 7.5 mg/kg of clarithromycin twice daily.1,5 When BU is severe, intravenous amikacin and oral rifampin can be used for 4 to 8 weeks.5
Wound Management and Surgical Considerations—Since BU can cause extensive widespread ulceration, daily wound care is recommended. Clinicians should note that patients often experience pain during wound dressing, as gauze impairs dermal regeneration and adheres to wounds. A second-line treatment to combat patients’ intolerance to gauze placement—especially for large BU lesions causing mobility issues—includes surgical debridement with wide margins and grafting 4 weeks after antibiotic therapy. This surgical procedure also can treat the releasing contractures that BU is known to cause.1 Severe cases of BU also can be treated with physiotherapy to prevent further disability.5
If histologic analysis of the margins reveals the presence of acid-fast bacilli and granulomas, the probability of future recurrence is high. In those instances, antibiotic therapy is given for prevention. In Australia, the Consensus Council Conference has recommended the removal of not only necrotic tissue but also a small margin of normal tissue to prevent the spread leading to recurrence.1,5,8
Prevention—Multiple prevention techniques have been suggested to combat BU. Long sleeves and pants should be worn outdoors along with insect repellents in BU-endemic areas. Comprehensive—but perhaps impractical—prevention measures include avoidance of swimming and aquatic activities such as boating and fishing in BU-endemic areas. In the event of a skin abrasion, the wound should be cleaned and covered promptly.
There is no vaccine currently available for BU. Bacillus Calmette—Guérin vaccination can provide minimal protection against disseminated BU but with a short-term response.5 Fortunately, M ulcerans–specific vaccines are being developed. Currently, tested vaccines target an enzyme called mycolyl transferase, which is essential for the stability of the mycobacterial cell wall and could have powerful implications in preventing these ulcers. These mycolyl transferase–directed vaccines need to be further explored in the plight against BU.1,5,8
Final Thoughts
Buruli ulcer remains a considerable public health challenge in endemic regions, with substantial morbidity and potential long-term disability. Hence, continued research into its transmission mechanisms, treatment options, and preventive measures is crucial for reducing the impact of this disease on affected populations.
- Yotsu RR, Suzuki K, Simmonds RE, et al. Buruli ulcer: a review of the current knowledge. Curr Trop Med Rep. 2018;5:247-256. doi:10.1007 /s40475-018-0166-2
- Muleta AJ, Lappan R, Stinear TP, et al. Understanding the transmission of Mycobacterium ulcerans: a step towards controlling Buruli ulcer. PLoS Negl Trop Dis. 2021;15:E0009678. doi:10.1371/journal.pntd.0009678
- MacCallum P, Tolhurst JC. A new mycobacterial infection in man. J Pathol Bacteriol. 1948;60:93-122.
- Van der Werf TS, Stienstra Y, Johnson RC, et al. Mycobacterium ulcerans disease. Bull World Health Organ. 2005;83:785-791.
- World Health Organization. Buruli ulcer (Mycobacterium ulcerans infection). January 12, 2023. Accessed November 7, 2024. https://www.who.int/news-room/fact-sheets/detail/buruli-ulcer-(mycobacterium-ulcerans-infection)
- Hall BS, Hill K, McKenna M, et al. The pathogenic mechanism of the Mycobacterium ulcerans virulence factor, mycolactone, depends on blockade of protein translocation into the ER. PLoS Pathog. 2014;10:E1004061. doi:10.1371/journal.ppat.1004061
- Sarfo FS, Phillips R, Wansbrough-Jones M, et al. Recent advances: role of mycolactone in the pathogenesis and monitoring of Mycobacterium ulcerans infection/Buruli ulcer disease. Cell Microbiol. 2016;18:17-29. doi:10.1111/cmi.12547
- Guarner J. Buruli ulcer: review of a neglected skin mycobacterial disease. J Clin Microbiol. 2018;56:E01507- E01517. doi:10.1128 /JCM.01507-17
- Adusumilli S, Mve-Obiang A, Sparer T, et al. Mycobacterium ulcerans toxic macrolide, mycolactone modulates the host immune response and cellular location of M ulcerans in vitro and in vivo. Cell Microbiol. 2005;7:1295-1304. doi:10.1111/j.1462-5822.2005.00557
- Wallace JR, Mangas KM, Porter JL, et al. Mycobacterium ulcerans low infectious dose and mechanical transmission support insect bites and puncturing injuries in the spread of Buruli ulcer. PLoS Negl Trop Dis. 2017;11:E0005553. doi:10.1371/journal.pntd.0005553
- Ezzedine K, Pistone T, Cottin J, et al. Buruli ulcer in long-term traveler to Senegal. Emerg Infect Dis. 2009;15:118-119. doi:10.3201 /eid1501.080123
- Eddyani M, Sopoh GE, Ayelo G, et al. Diagnostic accuracy of clinical and microbiological signs in patients with skin lesions resembling Buruli ulcer in an endemic region. Clin Infect Dis. 2018;67:827-834. doi:10.1093/cid/ciy197
Buruli ulcer (BU) is a potentially disabling necrotizing skin and soft tissue disease caused by Mycobacterium ulcerans infection.1,2 Buruli ulcer is most common in hot and humid climates and has caused considerable morbidity in Western African countries (Côte d’Ivoire, Ghana, and Benin account for 73% of annual cases) and the temperate areas of Australia (283 reported cases in 2017).1-4 In fact, the first recognizable cases of BU were described in 6 Australian individuals living in a riverine area in 1948, although the term Buruli ulcer is derived from the increased number of cases reported from Buruli county in Uganda near the Nile River.1,3,4
From 2002 to 2017, 66,000 cases of BU were reported in 33 countries.1 While the focal distribution has been demonstrated in the tropical areas of Sri Lanka, Malaysia, Papua New Guinea, Peru, and Mexico,4 nontropical nations such as Japan also are affected. Since 1981, 66 cases have been reported in Japan with M ulcerans subspecies—primarily Shinshuense, which has adapted to higher latitudes.1 Herein, we provide an overview of the pathogenesis, clinical presentation, and treatment of BU and highlight aquatic insects and mosquitoes as possible vectors of transmission.
Pathogenesis
Mycobacterium ulcerans is a nontuberculous mycobacterium and ubiquitous acid-fast gram-positive bacillus that can be cultured using a Lowenstein-Jensen agar and has a doubling rate of 48 hours.1,5 It produces the small 174-kb plasmid pMUM001-encoded compound mycolactone, a pathogenic toxin that causes immunosuppression, analgesia, and cytotoxic-associated tissue necrosis.1,5-9
Mycolactone is a polyketide macrolide with a 12-membrane lactone with 2 attached acyl side chains.1,7 Mycolactone is synthesized by the giant polyketide synthetases of M ulcerans. Mycolactone post-transcriptionally inhibits the development of lipopolysaccharide-dependent proinflammatory mediators—specifically by blocking protein translocation from the cytosol into the endoplasmic reticulum by targeting the SEC61 translocon.1,6 The lack of translocation of 30% to 50% of proteins leads to cellular stress and apoptosis mediated by Bim/Bcl2. A single point mutation in the SEC61 translocon subunit alpha 1 gene (SEC61A1) is associated with resistance to the cytotoxic effects of mycolactone.1
There are divergent hypotheses regarding the relationship of mycolactone to the Wiskott-Aldrich syndrome protein, with some researchers suggesting that mycolactone can attach to this protein, leading to cell detachment and death.7 However, others have proposed that mycolactone inhibits mTOR, activating the Wiskott-Aldrich syndrome protein and leading to subsequent extensive cytoskeleton remodeling.1 Mycolactone also can cause hypoesthesia, either by activating type 2 angiotensin II receptors and creating downstream neuron hyperpolarization or by killing Schwann cells.1
Transmission
Buruli ulcer caused by M ulcerans has a poorly understood transmission mechanism, and further studies are required to understand the underlying pathophysiology to decrease transmission rates and associated morbidity. Buruli ulcer is widely accepted to be transmitted to humans via predominantly water-rich environments; most cases occur around slow-moving and still bodies of water such as swamps, ponds, and marshes.1Mycobacterium ulcerans DNA has been found in fish, water insects, and snails.1,4 It also has been present in samples from aquatic insects such as Hemiptera (water strider), Naucoridae (creeping water bugs and saucer bugs), and Belostomatidae (giant water bugs) in West Africa and also from Aulacodes feces and moss.1
Variations in geographic climate may lead to different modes of transmission of BU. For example, mosquitoes have been studied as a potential vector for BU in the temperate climate of Australia.2 However, more data are needed from other countries to support mosquitoes as possible vectors. Wallace et al10 performed a study that showed skin puncture from insect bites or other injuries increases the chance of transmitting M ulcerans in the environment to the skin.
Clinical Presentation
Buruli ulcer most often manifests in healthy children younger than 15 years.1,8 Potential risk factors include residing near a contaminated water source, swimming in a river, and being bitten by an insect in a river during the rainy season. Lack of protective clothing and mosquito nets also have been proposed as considerable risk factors for BU.2 Genetic polymorphism in the solute carrier family 11 member 1 gene (SLC11A1) may increase the risk for BU with M ulcerans transmission. It is essential to understand that infection with M ulcerans does not always lead to the development of BU.1
Buruli ulcer often begins as a painless nodule or papule that patients may confuse with an insect bite. Within a couple of weeks, the induration will grow into ill-defined edematous plaques that gradually turn into necrotic skin, which will eventually slough off to create painless to mildly painful irregular skin ulceration (Figure).11 The surrounding uninvolved skin often is edematous and pigmented. Unfortunately, deep ulcerations can lead to osteomyelitis with exposure of the underlying bone. A secondary bacterial infection may be involved if a foul smell accompanies the ulcer. The vast extension of the ulcer has been known to lead to amputations, contractures, or deformities.1-5 The nodule progression to ulceration varies and can occur within 3 weeks to 1 year of the initial exposure.1,8
skin, which will eventually slough off to create painless to mildly painful
irregular skin ulceration. The image is in the public domain. Ezzedine K,
Pistone T, Cottin J, et al. Buruli ulcer in long-term traveler to Senegal.
Emerg Infect Dis. 2009;15:118-119. doi:10.3201/eid1501.080123
The World Health Organization (WHO) classifies BU into 3 categories: category 1 includes ulcers less than 5 cm in diameter; category 2 involves ulcers that are 5 to 15 cm in diameter; and category 3 involves ulcers that are larger than 15 cm in diameter as well as those involving the breasts, genitals, eyes, bones, or joints.4,8
Diagnosis
Cultures and microscopic examination of M ulcerans acid-fast bacilli can be used to confirm the diagnosis of BU. However, polymerase chain reaction (PCR) is the best confirmatory test, as the WHO reports that 70% of reported cases of BU are confirmed by PCR detection of DNA.1,4 Unfortunately, many BU-endemic areas lack feasible access to perform confirmatory tests such as PCR. Antigen detection assays, loop-mediated isothermal amplification tests, and detection of mycolactone by thinlayer chromatography are being developed to create more rapid and sensitive testing for BU.12
The lack of diagnostic testing for BU means physicians must rely on clinical diagnosis.1 However, the differential diagnosis is extensive and includes ulcers due to diabetes and arterial and venous insufficiency, cutaneous leishmaniasis, and Haemophilus ducreyi ulcers.5 Despite the broad differential, Eddyani et al12 found that BU diagnosed clinically by physicians had a sensitivity of 92%.
Treatment
Surgery was the first-line treatment for BU before the introduction of antibiotics for this condition. Antibiotics have created better outcomes with increased cure rates and decreased amputation.4
Pharmacotherapy—In the early 2000s, the WHO recommended a treatment regimen of once-daily 10 mg/kg rifampin (oral) and 15 mg/kg streptomycin ( intramuscular) for 8 weeks. This treatment protocol is effective for lesions measuring less than 10 cm in diameter and has an average cure rate of 50%.5 Unfortunately, streptomycin is associated with ototoxicity and nephrotoxicity.1,4 Clinicians should be aware that 1.9% to 26% of patients may have paradoxical worsening of BU early during antibiotic use due to increased host inflammatory response, but it subsides with continued treatment.1,4
Researchers in Australia have begun testing and using rifampin plus oral clarithromycin, ciprofloxacin, or moxifloxacin for 3 months. A common combination is oncedaily 10 mg/kg rifampicin and 400 mg/kg moxifloxacin.1 After multiple randomized controlled trials showed the efficacy of rifampicin in combination with clarithromycin, many physicians now recommend 10 mg/kg of rifampicin once daily and 7.5 mg/kg of clarithromycin twice daily.1,5 When BU is severe, intravenous amikacin and oral rifampin can be used for 4 to 8 weeks.5
Wound Management and Surgical Considerations—Since BU can cause extensive widespread ulceration, daily wound care is recommended. Clinicians should note that patients often experience pain during wound dressing, as gauze impairs dermal regeneration and adheres to wounds. A second-line treatment to combat patients’ intolerance to gauze placement—especially for large BU lesions causing mobility issues—includes surgical debridement with wide margins and grafting 4 weeks after antibiotic therapy. This surgical procedure also can treat the releasing contractures that BU is known to cause.1 Severe cases of BU also can be treated with physiotherapy to prevent further disability.5
If histologic analysis of the margins reveals the presence of acid-fast bacilli and granulomas, the probability of future recurrence is high. In those instances, antibiotic therapy is given for prevention. In Australia, the Consensus Council Conference has recommended the removal of not only necrotic tissue but also a small margin of normal tissue to prevent the spread leading to recurrence.1,5,8
Prevention—Multiple prevention techniques have been suggested to combat BU. Long sleeves and pants should be worn outdoors along with insect repellents in BU-endemic areas. Comprehensive—but perhaps impractical—prevention measures include avoidance of swimming and aquatic activities such as boating and fishing in BU-endemic areas. In the event of a skin abrasion, the wound should be cleaned and covered promptly.
There is no vaccine currently available for BU. Bacillus Calmette—Guérin vaccination can provide minimal protection against disseminated BU but with a short-term response.5 Fortunately, M ulcerans–specific vaccines are being developed. Currently, tested vaccines target an enzyme called mycolyl transferase, which is essential for the stability of the mycobacterial cell wall and could have powerful implications in preventing these ulcers. These mycolyl transferase–directed vaccines need to be further explored in the plight against BU.1,5,8
Final Thoughts
Buruli ulcer remains a considerable public health challenge in endemic regions, with substantial morbidity and potential long-term disability. Hence, continued research into its transmission mechanisms, treatment options, and preventive measures is crucial for reducing the impact of this disease on affected populations.
Buruli ulcer (BU) is a potentially disabling necrotizing skin and soft tissue disease caused by Mycobacterium ulcerans infection.1,2 Buruli ulcer is most common in hot and humid climates and has caused considerable morbidity in Western African countries (Côte d’Ivoire, Ghana, and Benin account for 73% of annual cases) and the temperate areas of Australia (283 reported cases in 2017).1-4 In fact, the first recognizable cases of BU were described in 6 Australian individuals living in a riverine area in 1948, although the term Buruli ulcer is derived from the increased number of cases reported from Buruli county in Uganda near the Nile River.1,3,4
From 2002 to 2017, 66,000 cases of BU were reported in 33 countries.1 While the focal distribution has been demonstrated in the tropical areas of Sri Lanka, Malaysia, Papua New Guinea, Peru, and Mexico,4 nontropical nations such as Japan also are affected. Since 1981, 66 cases have been reported in Japan with M ulcerans subspecies—primarily Shinshuense, which has adapted to higher latitudes.1 Herein, we provide an overview of the pathogenesis, clinical presentation, and treatment of BU and highlight aquatic insects and mosquitoes as possible vectors of transmission.
Pathogenesis
Mycobacterium ulcerans is a nontuberculous mycobacterium and ubiquitous acid-fast gram-positive bacillus that can be cultured using a Lowenstein-Jensen agar and has a doubling rate of 48 hours.1,5 It produces the small 174-kb plasmid pMUM001-encoded compound mycolactone, a pathogenic toxin that causes immunosuppression, analgesia, and cytotoxic-associated tissue necrosis.1,5-9
Mycolactone is a polyketide macrolide with a 12-membrane lactone with 2 attached acyl side chains.1,7 Mycolactone is synthesized by the giant polyketide synthetases of M ulcerans. Mycolactone post-transcriptionally inhibits the development of lipopolysaccharide-dependent proinflammatory mediators—specifically by blocking protein translocation from the cytosol into the endoplasmic reticulum by targeting the SEC61 translocon.1,6 The lack of translocation of 30% to 50% of proteins leads to cellular stress and apoptosis mediated by Bim/Bcl2. A single point mutation in the SEC61 translocon subunit alpha 1 gene (SEC61A1) is associated with resistance to the cytotoxic effects of mycolactone.1
There are divergent hypotheses regarding the relationship of mycolactone to the Wiskott-Aldrich syndrome protein, with some researchers suggesting that mycolactone can attach to this protein, leading to cell detachment and death.7 However, others have proposed that mycolactone inhibits mTOR, activating the Wiskott-Aldrich syndrome protein and leading to subsequent extensive cytoskeleton remodeling.1 Mycolactone also can cause hypoesthesia, either by activating type 2 angiotensin II receptors and creating downstream neuron hyperpolarization or by killing Schwann cells.1
Transmission
Buruli ulcer caused by M ulcerans has a poorly understood transmission mechanism, and further studies are required to understand the underlying pathophysiology to decrease transmission rates and associated morbidity. Buruli ulcer is widely accepted to be transmitted to humans via predominantly water-rich environments; most cases occur around slow-moving and still bodies of water such as swamps, ponds, and marshes.1Mycobacterium ulcerans DNA has been found in fish, water insects, and snails.1,4 It also has been present in samples from aquatic insects such as Hemiptera (water strider), Naucoridae (creeping water bugs and saucer bugs), and Belostomatidae (giant water bugs) in West Africa and also from Aulacodes feces and moss.1
Variations in geographic climate may lead to different modes of transmission of BU. For example, mosquitoes have been studied as a potential vector for BU in the temperate climate of Australia.2 However, more data are needed from other countries to support mosquitoes as possible vectors. Wallace et al10 performed a study that showed skin puncture from insect bites or other injuries increases the chance of transmitting M ulcerans in the environment to the skin.
Clinical Presentation
Buruli ulcer most often manifests in healthy children younger than 15 years.1,8 Potential risk factors include residing near a contaminated water source, swimming in a river, and being bitten by an insect in a river during the rainy season. Lack of protective clothing and mosquito nets also have been proposed as considerable risk factors for BU.2 Genetic polymorphism in the solute carrier family 11 member 1 gene (SLC11A1) may increase the risk for BU with M ulcerans transmission. It is essential to understand that infection with M ulcerans does not always lead to the development of BU.1
Buruli ulcer often begins as a painless nodule or papule that patients may confuse with an insect bite. Within a couple of weeks, the induration will grow into ill-defined edematous plaques that gradually turn into necrotic skin, which will eventually slough off to create painless to mildly painful irregular skin ulceration (Figure).11 The surrounding uninvolved skin often is edematous and pigmented. Unfortunately, deep ulcerations can lead to osteomyelitis with exposure of the underlying bone. A secondary bacterial infection may be involved if a foul smell accompanies the ulcer. The vast extension of the ulcer has been known to lead to amputations, contractures, or deformities.1-5 The nodule progression to ulceration varies and can occur within 3 weeks to 1 year of the initial exposure.1,8
skin, which will eventually slough off to create painless to mildly painful
irregular skin ulceration. The image is in the public domain. Ezzedine K,
Pistone T, Cottin J, et al. Buruli ulcer in long-term traveler to Senegal.
Emerg Infect Dis. 2009;15:118-119. doi:10.3201/eid1501.080123
The World Health Organization (WHO) classifies BU into 3 categories: category 1 includes ulcers less than 5 cm in diameter; category 2 involves ulcers that are 5 to 15 cm in diameter; and category 3 involves ulcers that are larger than 15 cm in diameter as well as those involving the breasts, genitals, eyes, bones, or joints.4,8
Diagnosis
Cultures and microscopic examination of M ulcerans acid-fast bacilli can be used to confirm the diagnosis of BU. However, polymerase chain reaction (PCR) is the best confirmatory test, as the WHO reports that 70% of reported cases of BU are confirmed by PCR detection of DNA.1,4 Unfortunately, many BU-endemic areas lack feasible access to perform confirmatory tests such as PCR. Antigen detection assays, loop-mediated isothermal amplification tests, and detection of mycolactone by thinlayer chromatography are being developed to create more rapid and sensitive testing for BU.12
The lack of diagnostic testing for BU means physicians must rely on clinical diagnosis.1 However, the differential diagnosis is extensive and includes ulcers due to diabetes and arterial and venous insufficiency, cutaneous leishmaniasis, and Haemophilus ducreyi ulcers.5 Despite the broad differential, Eddyani et al12 found that BU diagnosed clinically by physicians had a sensitivity of 92%.
Treatment
Surgery was the first-line treatment for BU before the introduction of antibiotics for this condition. Antibiotics have created better outcomes with increased cure rates and decreased amputation.4
Pharmacotherapy—In the early 2000s, the WHO recommended a treatment regimen of once-daily 10 mg/kg rifampin (oral) and 15 mg/kg streptomycin ( intramuscular) for 8 weeks. This treatment protocol is effective for lesions measuring less than 10 cm in diameter and has an average cure rate of 50%.5 Unfortunately, streptomycin is associated with ototoxicity and nephrotoxicity.1,4 Clinicians should be aware that 1.9% to 26% of patients may have paradoxical worsening of BU early during antibiotic use due to increased host inflammatory response, but it subsides with continued treatment.1,4
Researchers in Australia have begun testing and using rifampin plus oral clarithromycin, ciprofloxacin, or moxifloxacin for 3 months. A common combination is oncedaily 10 mg/kg rifampicin and 400 mg/kg moxifloxacin.1 After multiple randomized controlled trials showed the efficacy of rifampicin in combination with clarithromycin, many physicians now recommend 10 mg/kg of rifampicin once daily and 7.5 mg/kg of clarithromycin twice daily.1,5 When BU is severe, intravenous amikacin and oral rifampin can be used for 4 to 8 weeks.5
Wound Management and Surgical Considerations—Since BU can cause extensive widespread ulceration, daily wound care is recommended. Clinicians should note that patients often experience pain during wound dressing, as gauze impairs dermal regeneration and adheres to wounds. A second-line treatment to combat patients’ intolerance to gauze placement—especially for large BU lesions causing mobility issues—includes surgical debridement with wide margins and grafting 4 weeks after antibiotic therapy. This surgical procedure also can treat the releasing contractures that BU is known to cause.1 Severe cases of BU also can be treated with physiotherapy to prevent further disability.5
If histologic analysis of the margins reveals the presence of acid-fast bacilli and granulomas, the probability of future recurrence is high. In those instances, antibiotic therapy is given for prevention. In Australia, the Consensus Council Conference has recommended the removal of not only necrotic tissue but also a small margin of normal tissue to prevent the spread leading to recurrence.1,5,8
Prevention—Multiple prevention techniques have been suggested to combat BU. Long sleeves and pants should be worn outdoors along with insect repellents in BU-endemic areas. Comprehensive—but perhaps impractical—prevention measures include avoidance of swimming and aquatic activities such as boating and fishing in BU-endemic areas. In the event of a skin abrasion, the wound should be cleaned and covered promptly.
There is no vaccine currently available for BU. Bacillus Calmette—Guérin vaccination can provide minimal protection against disseminated BU but with a short-term response.5 Fortunately, M ulcerans–specific vaccines are being developed. Currently, tested vaccines target an enzyme called mycolyl transferase, which is essential for the stability of the mycobacterial cell wall and could have powerful implications in preventing these ulcers. These mycolyl transferase–directed vaccines need to be further explored in the plight against BU.1,5,8
Final Thoughts
Buruli ulcer remains a considerable public health challenge in endemic regions, with substantial morbidity and potential long-term disability. Hence, continued research into its transmission mechanisms, treatment options, and preventive measures is crucial for reducing the impact of this disease on affected populations.
- Yotsu RR, Suzuki K, Simmonds RE, et al. Buruli ulcer: a review of the current knowledge. Curr Trop Med Rep. 2018;5:247-256. doi:10.1007 /s40475-018-0166-2
- Muleta AJ, Lappan R, Stinear TP, et al. Understanding the transmission of Mycobacterium ulcerans: a step towards controlling Buruli ulcer. PLoS Negl Trop Dis. 2021;15:E0009678. doi:10.1371/journal.pntd.0009678
- MacCallum P, Tolhurst JC. A new mycobacterial infection in man. J Pathol Bacteriol. 1948;60:93-122.
- Van der Werf TS, Stienstra Y, Johnson RC, et al. Mycobacterium ulcerans disease. Bull World Health Organ. 2005;83:785-791.
- World Health Organization. Buruli ulcer (Mycobacterium ulcerans infection). January 12, 2023. Accessed November 7, 2024. https://www.who.int/news-room/fact-sheets/detail/buruli-ulcer-(mycobacterium-ulcerans-infection)
- Hall BS, Hill K, McKenna M, et al. The pathogenic mechanism of the Mycobacterium ulcerans virulence factor, mycolactone, depends on blockade of protein translocation into the ER. PLoS Pathog. 2014;10:E1004061. doi:10.1371/journal.ppat.1004061
- Sarfo FS, Phillips R, Wansbrough-Jones M, et al. Recent advances: role of mycolactone in the pathogenesis and monitoring of Mycobacterium ulcerans infection/Buruli ulcer disease. Cell Microbiol. 2016;18:17-29. doi:10.1111/cmi.12547
- Guarner J. Buruli ulcer: review of a neglected skin mycobacterial disease. J Clin Microbiol. 2018;56:E01507- E01517. doi:10.1128 /JCM.01507-17
- Adusumilli S, Mve-Obiang A, Sparer T, et al. Mycobacterium ulcerans toxic macrolide, mycolactone modulates the host immune response and cellular location of M ulcerans in vitro and in vivo. Cell Microbiol. 2005;7:1295-1304. doi:10.1111/j.1462-5822.2005.00557
- Wallace JR, Mangas KM, Porter JL, et al. Mycobacterium ulcerans low infectious dose and mechanical transmission support insect bites and puncturing injuries in the spread of Buruli ulcer. PLoS Negl Trop Dis. 2017;11:E0005553. doi:10.1371/journal.pntd.0005553
- Ezzedine K, Pistone T, Cottin J, et al. Buruli ulcer in long-term traveler to Senegal. Emerg Infect Dis. 2009;15:118-119. doi:10.3201 /eid1501.080123
- Eddyani M, Sopoh GE, Ayelo G, et al. Diagnostic accuracy of clinical and microbiological signs in patients with skin lesions resembling Buruli ulcer in an endemic region. Clin Infect Dis. 2018;67:827-834. doi:10.1093/cid/ciy197
- Yotsu RR, Suzuki K, Simmonds RE, et al. Buruli ulcer: a review of the current knowledge. Curr Trop Med Rep. 2018;5:247-256. doi:10.1007 /s40475-018-0166-2
- Muleta AJ, Lappan R, Stinear TP, et al. Understanding the transmission of Mycobacterium ulcerans: a step towards controlling Buruli ulcer. PLoS Negl Trop Dis. 2021;15:E0009678. doi:10.1371/journal.pntd.0009678
- MacCallum P, Tolhurst JC. A new mycobacterial infection in man. J Pathol Bacteriol. 1948;60:93-122.
- Van der Werf TS, Stienstra Y, Johnson RC, et al. Mycobacterium ulcerans disease. Bull World Health Organ. 2005;83:785-791.
- World Health Organization. Buruli ulcer (Mycobacterium ulcerans infection). January 12, 2023. Accessed November 7, 2024. https://www.who.int/news-room/fact-sheets/detail/buruli-ulcer-(mycobacterium-ulcerans-infection)
- Hall BS, Hill K, McKenna M, et al. The pathogenic mechanism of the Mycobacterium ulcerans virulence factor, mycolactone, depends on blockade of protein translocation into the ER. PLoS Pathog. 2014;10:E1004061. doi:10.1371/journal.ppat.1004061
- Sarfo FS, Phillips R, Wansbrough-Jones M, et al. Recent advances: role of mycolactone in the pathogenesis and monitoring of Mycobacterium ulcerans infection/Buruli ulcer disease. Cell Microbiol. 2016;18:17-29. doi:10.1111/cmi.12547
- Guarner J. Buruli ulcer: review of a neglected skin mycobacterial disease. J Clin Microbiol. 2018;56:E01507- E01517. doi:10.1128 /JCM.01507-17
- Adusumilli S, Mve-Obiang A, Sparer T, et al. Mycobacterium ulcerans toxic macrolide, mycolactone modulates the host immune response and cellular location of M ulcerans in vitro and in vivo. Cell Microbiol. 2005;7:1295-1304. doi:10.1111/j.1462-5822.2005.00557
- Wallace JR, Mangas KM, Porter JL, et al. Mycobacterium ulcerans low infectious dose and mechanical transmission support insect bites and puncturing injuries in the spread of Buruli ulcer. PLoS Negl Trop Dis. 2017;11:E0005553. doi:10.1371/journal.pntd.0005553
- Ezzedine K, Pistone T, Cottin J, et al. Buruli ulcer in long-term traveler to Senegal. Emerg Infect Dis. 2009;15:118-119. doi:10.3201 /eid1501.080123
- Eddyani M, Sopoh GE, Ayelo G, et al. Diagnostic accuracy of clinical and microbiological signs in patients with skin lesions resembling Buruli ulcer in an endemic region. Clin Infect Dis. 2018;67:827-834. doi:10.1093/cid/ciy197
Buruli Ulcer Transmission: Environmental Pathways and Implications for Dermatologic Care
Buruli Ulcer Transmission: Environmental Pathways and Implications for Dermatologic Care
PRACTICE POINTS
- Buruli ulcer (BU) is a necrotizing cutaneous disease caused by Mycobacterium ulcerans with possible transmission from aquatic insects and mosquitoes.
- Buruli ulcer often manifests in children as painless induration that gradually progresses to painless or mildly painful irregular skin ulceration.
- Treatment options for BU include rifampin and streptomycin, but larger lesions may require surgical debridement.
- No vaccine currently exists for M ulcerans, but clinical trials targeting mycolyl transferase are underway.
What’s Eating You? Hookworm and Cutaneous Larva Migrans
What’s Eating You? Hookworm and
Cutaneous Larva Migrans
It is estimated that the prevalence of human hookworm infection is approximately 450 million individuals worldwide, representing a substantial global disease burden.1 The annual global public health burden ranges from approximately 2 million to 4 million disability-adjusted life-years and $10 billion to $140 billion in hookwormrelated costs.2 In this article, we discuss the lifecycle, transmission, and disease burden of cutaneous larva migrans (CLM) as well as prevention and treatment strategies.
Background
The Ancylostomatidae nematode family comprises at least 68 known species of hookworm that infect more than 110 different species of mammals.3 Many of these parasites are able to infect more than 1 primary host species, but from a disease perspective they can be classified as either anthropophilic, with humans as the intended host, or zoonotic, with humans as an incidental host. It is important to make this distinction because, though the lifecycles and biology of hookworm species generally are similar, the manifestations of incidental human infection from zoonotic hookworms are different from those of anthropophilic hookworms. Of the anthropophilic species, Necator americanus and Ancylostoma duodenale predominate. In the instance of zoonotic hookworm, dog-infecting A caninum and cat- and doginfecting A braziliense and Uncinaria stenocephala are common causes of incidental human disease.3
The life cycle of Ancylostomatidae organisms is astounding. Through millions of years of co-evolution with mammals,4 these parasitic worms have developed perhaps one of the most circuitous paths to propagate themselves in the natural world. Hookworms start their arduous journey as eggs deposited in soil, sand, and ground vegetation from the feces of infected animals.5 Approximately 1 day after the eggs are deposited, they hatch and begin the larval stage, during which they become infective 1 to 5 weeks later. At this point, the larvae become sensitive to their environment, responding to rising temperatures, increasing carbon dioxide levels, and vibrations in the soil—all of which suggest the presence of a potential host and contribute to a concordant increase in undulatory movement of the larvae.5,6 Here, the most vulnerable tissues include the uncovered soles, palms, and buttocks of host mammals that come into contact with contaminated soil. In an undulating fashion and guided by temperature cues, the larvae locate the skin of the host and utilize a mixture of enzymes including hyaluronidases, metalloprotease, and other proteases to penetrate the epidermis.7 Anthropophilic hookworms such as N americanus and A duodenale will enter the circulatory system; from there, the hookworms migrate through the right-sided cardiopulmonary circuit and eventually ascend into the pulmonary vasculature.8 They then penetrate the lung capillary beds and parenchyma to reach the alveoli, ascend the respiratory tree, and, with the help of the mucociliary escalator, reach the esophagus, where they are swallowed by the host. In the gastrointestinal tract, adult hookworms consume host blood, mate, and lay eggs over a period of approximately 1 to 3 years if left untreated.9 Eggs are laid into the lower gastrointestinal tract, and the journey begins again in feces contacting ground or soil.
Geographic Distribution
Hookworms are found in almost all regions of the world, with species-specific distributions that highlight tropical and subtropical regions. Necator americanus and A duodenale are the most common hookworm species, with the former found predominantly in Southeast Asia and Latin America and the latter in Asia-Pacific regions.10 The highest prevalence of hookworms is in Southeast Asia followed by Sub-Saharan Africa, and the unique climate and soil composition of a region help determine the best environments for specific species of hookworm to thrive.11 In addition, socioeconomics and social determinants of health play a big role in the spread of hookworms, as hygiene practices (eg, wearing clean shoes and clothing, bathing), infrastructure (eg, clean water and streets), and anthelmintic campaigns help reduce transmission.12 Soil-transmitted helminths were once endemic to the southeastern United States, with some reports of approximately 40% of individuals infected in the south in the early 1900s.13 Anthelmintic campaigns such as water, sanitation, and hygiene programs as well as deworming of humans and livestock have proven effective in reducing the prevalence of helminth disease in industrialized nations.13,14 However, zoonotic infections remain a problem in these regions, and in some parts of the United States more than 40% of sampled cats and dogs harbored species such as A braziliense.15
Clinical Manifestation
Initial hookworm infection often goes unnoticed because symptoms can range in severity, but it is characterized by transient ground itch—a local pruritic, erythematous, and papular eruption that develops in response to epidermal penetration.16 Because the larvae must traverse the host from skin to target organs for reproduction over several weeks, iron-deficiency anemia will manifest much later than signs of the initial penetration. In the case of incidental infection from zoonotic Ancylostomatidae organisms, the misguided larvae result in CLM, an often intensely pruritic skin condition that will self-resolve in 2 to 8 weeks with eventual death of the larvae.5
Diagnosis and Pathology of Disease
Zoonotic Hookworm—The major presenting sign of zoonotic hookworm infection is CLM. The diagnosis of CLM usually is made clinically, as the larvae themselves are 0.5 mm thick to 10 mm long (Figure 1) and usually extend several centimeters beyond the dermal lesion, with dermoscopy having limited utility.17 Patients may begin to experience itching as little as 1 hour after hookworm penetration of the skin.18 Once in contact with the skin, the hookworms’ hyaluronidases and proteases are capable of breaking through the epidermis, but zoonotic hookworms typically are unable to penetrate the basal layer of the human epidermis and remain entombed between the stratum granulosum and stratum corneum. With the exception of rare cases of direct or indirect pulmonary involvement resulting in Löffler syndrome,19 the larvae will die within weeks to months, and symptoms will subsequently resolve.
Although the infection generally is self-limiting, the dermatologic manifestations of CLM can be severe and warrant intervention. The lesions start as small reddish papules at the site of penetration (Figure 2), then the hallmark elevated, migrating, serpiginous, urticarial rash develops (Figure 3). Cutaneous larva migrans generally manifests unilaterally and is both erythematous and intensely pruritic. As the larvae migrate, they leave behind 1- to 5-cm tunneled creeping eruptions in their wake. The lesions, which can manifest with pain or be painless, may develop eczematous, bullous, follicular, or impetiginized appearances.20 Atypical manifestations include folliculitis and urticarial plaques.17
cutaneous larval migrans on the palm.
Anthropophilic Hookworm—The lifecycles of N americanus and A duodenale are completed in human infection. Dermatologic manifestations are transient with the development of ground itch at the site of epidermal penetration. The hookworms employ collagenases that allow penetration of the basal layer of the skin, and eosinophilia develops as the parasites travel from the skin to the small intestine. Once attached to the gastrointestinal lumen, blood meals and proteolytic enzymes result in iron-deficiency anemia in the host and may lead to weakness, fatigue, and low birth weights in pregnant patients. With prolonged infection or heavy parasitic burden, patients can develop hypoproteinemia, anasarca, and yellowing of the skin known as chlorosis.11 A clinical diagnosis can be made by examining patient stool samples for eggs, and definitive characterization can be made using molecular tools such as polymerase chain reaction.21,22
Common to hookworm infections is the immune reaction, which promotes inflammation with localized eosinophilia and mastocytosis.11 In a clinical biopsy specimen of gut—usually obtained through esophagogastroduodenoscopy— T-helper (Th) 2–type immune (IL-4, IL-5, IL-9 and IL-13), regulatory Th10 (IL-10 and transcription growth factor β), and some evidence of Th1 (interferon gamma and IL-2) cytokines are present, but little evidence of Th17-type immune response was found.23 It is believed that in zoonotic infections, antiparasitic IgE from basophils are somewhat successful at trapping the helminths in the epidermis, but in the anthropophilic species, IgE and Th2 responses are ineffective at clearing the parasite from the gut, and the defeated immune system transitions to a host-tolerance approach of limiting infection.11 It is now believed that this natural armistice can be manipulated into a potential therapy against autoimmune and inflammatory conditions. Intentional infection with zoonotic whipworm or hookworm has been proposed as a mechanism of switching Th1 and Th2 responses to host-tolerant mechanisms in conditions such as Crohn disease and celiac disease,24 and it has even been hypothesized that prior hookworm infection may reduce the chance of developing allergic conditions such as eczema.25
Treatment and Prevention
The World Health Organization and Centers for Disease Control and Prevention recommend a single oral dose of 400 mg albendazole for adults or 10 to 15 mg/kg in children for CLM. A single dose of ivermectin at 12 mg in adults or 150 μg/kg in children can be used as an alternative where albendazole is not available.11 Topical applications of thiabendazole 10% to 15% under occlusion or 3 times daily for 15 days without occlusion also can manage CLM, and pruritus can be treated with topical corticosteroids for symptomatic relief. Oral albendazole 400 mg twice daily or mebendazole 100 mg twice daily for 3 days or a single 500-mg dose, as well as 11 mg/kg (up to a maximum of 1 g) oral pyrantel pamoate once daily for 3 days can be used to treat intestinal hookworm infection, though it should be avoided in pregnancy. Iron deficiency should be managed with supplementation.11
Prevention of hookworm infection is focused around 2 broad public health efforts: mass drug administration programs and the water, sanitation, and hygiene program. In mass drug administration, treatments such as benzimidazoles are given in mass to communities affected by endemic hookworm as a single dose to reduce the burden of disease. Together, these strategies effectively eliminated hookworms in many developed nations, but areas of resurgence are beginning to surface worldwide. With changes in climate, emerging drug resistance, and socioeconomic disparities, particularly affecting the southeast, a resurgence of hookworm has occurred in the United States.26 One recent study demonstrated that almost one-third (19/55) of children sampled in an impoverished area of rural Alabama had hookworm eggs in their stool.27 Furthermore, pets serve not only as zoonotic reservoirs for CLM recurrence but also as vehicles for the evolution of drug-resistant strains, leading some to call for a ban of animals from beaches and playgrounds as well as tightly controlled veterinary programs.5,28 Ubiquitous benzimidazole use in livestock has led to bendazole-resistant strains, and it is likely that with continued and poorly adherent drug use, more zoonotic and anthropophilic drug-resistant strains of hookworm will emerge.29,30
Conclusion
The burden of hookworm infection and CLM is substantial in parts of the United States. Dermatologists play a critical role in the recognition and management of hookworm infection for both treatment of affected patients and the subsequent prevention of its spread. As drug-resistant strains evolve, clinicians, public health officials, and scientists need to continue to work together to prevent and treat hookworm infection.
- Vos T, Abajobir AA, Abate KH, et al. Global, regional, and national incidence, prevalence, and years lived with disability for 328 diseases and injuries for 195 countries, 1990-2016: a systematic analysis for the Global Burden of Disease Study 2016. Lancet. 2017;390:1211-1259.
- Bartsch SM, Hotez PJ, Asti L, et al. The global economic and health burden of human hookworm infection. PLoS Negl Trop Dis. 2016;10:E0004922.
- Seguel M, Gottdenker N. The diversity and impact of hookworm infections in wildlife. Int J Parasitol Parasites Wildl. 2017;6:177-194.
- Adams BJ, Peat SM, Dillman AR. Phylogeny and evolution. In: Entomopathogenic Nematodes: Systematics, Phylogeny and Bacterial Symbionts. Brill; 2010:693-733.
- Heukelbach J, Feldmeier H. Epidemiological and clinical characteristics of hookworm-related cutaneous larva migrans. Lancet Infect Dis. 2008;8:302-309.
- Haas W, Haberl B, Idris I, et al. Infective larvae of the human hookworms Necator americanus and Ancylostoma duodenale differ in their orientation behaviour when crawling on surfaces. Parasitol Res. 2005;95:25-29.
- Hotez P, Narasimhan S, Haggerty J, et al. Hyaluronidase from infective Ancylostoma hookworm larvae and its possible function as a virulence factor in tissue invasion and in cutaneous larva migrans. Infect Immun. 1992;60:1018-1023.
- Brooker S, Bethony J, Hotez PJ. Human hookworm infection in the 21st century. Adv Parasitol. 2004;58:197-288.
- Hoagland K, Schad G. Necator americanus and Ancylostoma duodenale: life history parameters and epidemiological implications of two sympatric hookworms of humans. Exp Parasitol. 1978;44:36-49.
- Clements ACA, Alene KA. Global distribution of human hookworm species and differences in their morbidity effects: a systematic review. Lancet Microbe. 2022;3:E72-E79.
- Loukas A, Hotez PJ, Diemert D, et al. Hookworm infection. Nat Rev Dis Primers. 2016;2:1-18.
- Gazzinelli A, Correa-Oliveira R, Yang GJ, et al. A research agenda for helminth diseases of humans: social ecology, environmental determinants, and health systems. PLoS Negl Trop Dis. 2012;6:E1603.
- Starr MC, Montgomery SP. Soil-transmitted helminthiasis in the United States: a systematic review—1940-2010. Am J Trop Med Hyg. 2011;85:680-684.
- Strunz EC, Addiss DG, Stocks ME, et al. Water, sanitation, hygiene, and soil-transmitted helminth infection: a systematic review and metaanalysis. PLoS Med. 2014;11:E1001620.
- Liotta JL, Youn H, Aksel S, et al. Prevalence of Ancylostoma braziliense in dogs from Alachua and Marion Counties, Florida, United States. J Parasitol. 2012;98:1039-1040.
- Hotez PJ, Brooker S, Bethony JM, et al. Hookworm infection. N Engl J Med. 2004;351:799-807.
- Prickett KA, Ferringer TC. What’s eating you? cutaneous larva migrans. Cutis. 2015;95:126-128.
- Feldmeier H, Schuster A. Mini review: hookworm-related cutaneous larva migrans. Eur J Clin Microbiol Infect Dis. 2012;31:915-918.
- Tan SK, Liu TT. Cutaneous larva migrans complicated by Löffler syndrome. Arch Dermatol. 2010;146:210-212.
- Eksomtramage T, Aiempanakit K. Bullous and pustular cutaneous larva migrans: two case reports and a literature review. IDCases. 2018;12:130-132.
- Utzinger J, Rinaldi L, Lohourignon LK, et al. FLOTAC: a new sensitive technique for the diagnosis of hookworm infections in humans. Trans R Soc Trop Med Hyg. 2008;102:84-90.
- Chidambaram M, Parija SC, Toi PC, et al. Evaluation of the utility of conventional polymerase chain reaction for detection and species differentiation in human hookworm infections. Trop Parasitol. 2017;7:111-116.
- Gaze S, McSorley HJ, Daveson J, et al. Characterising the mucosal and systemic immune responses to experimental human hookworm infection. PLoS Pathog. 2012;8:E1002520.
- Croese J, O’Neil J, Masson J, et al. A proof of concept study establishing Necator americanus in Crohn’s patients and reservoir donors. Gut. 2006;55:136-137.
- Mpairwe H, Amoah AS. Parasites and allergy: observations from Africa. Parasite Immunol. 2019;41:E12589.
- Albonico M, Savioli L. Hookworm: a neglected resurgent infection. Editorial. BMJ. 2017;359:j4813.
- McKenna ML, McAtee S, Bryan PE, et al. Human intestinal parasite burden and poor sanitation in rural Alabama. Am J Trop Med Hyg. 2017;97:1623-1628.
- Traversa D. Pet roundworms and hookworms: a continuing need for global worming. Parasit Vectors. 2012;5:1-19.
- Geerts S, Gryseels B. Drug resistance in human helminths: current situation and lessons from livestock. Clin Microbiol Rev. 2000;13:207-222.
- Jimenez Castro PD, Howell SB, Schaefer JJ, et al. Multiple drug resistance in the canine hookworm Ancylostoma caninum: an emerging threat? Parasit Vectors. 2019;12:1-15.
It is estimated that the prevalence of human hookworm infection is approximately 450 million individuals worldwide, representing a substantial global disease burden.1 The annual global public health burden ranges from approximately 2 million to 4 million disability-adjusted life-years and $10 billion to $140 billion in hookwormrelated costs.2 In this article, we discuss the lifecycle, transmission, and disease burden of cutaneous larva migrans (CLM) as well as prevention and treatment strategies.
Background
The Ancylostomatidae nematode family comprises at least 68 known species of hookworm that infect more than 110 different species of mammals.3 Many of these parasites are able to infect more than 1 primary host species, but from a disease perspective they can be classified as either anthropophilic, with humans as the intended host, or zoonotic, with humans as an incidental host. It is important to make this distinction because, though the lifecycles and biology of hookworm species generally are similar, the manifestations of incidental human infection from zoonotic hookworms are different from those of anthropophilic hookworms. Of the anthropophilic species, Necator americanus and Ancylostoma duodenale predominate. In the instance of zoonotic hookworm, dog-infecting A caninum and cat- and doginfecting A braziliense and Uncinaria stenocephala are common causes of incidental human disease.3
The life cycle of Ancylostomatidae organisms is astounding. Through millions of years of co-evolution with mammals,4 these parasitic worms have developed perhaps one of the most circuitous paths to propagate themselves in the natural world. Hookworms start their arduous journey as eggs deposited in soil, sand, and ground vegetation from the feces of infected animals.5 Approximately 1 day after the eggs are deposited, they hatch and begin the larval stage, during which they become infective 1 to 5 weeks later. At this point, the larvae become sensitive to their environment, responding to rising temperatures, increasing carbon dioxide levels, and vibrations in the soil—all of which suggest the presence of a potential host and contribute to a concordant increase in undulatory movement of the larvae.5,6 Here, the most vulnerable tissues include the uncovered soles, palms, and buttocks of host mammals that come into contact with contaminated soil. In an undulating fashion and guided by temperature cues, the larvae locate the skin of the host and utilize a mixture of enzymes including hyaluronidases, metalloprotease, and other proteases to penetrate the epidermis.7 Anthropophilic hookworms such as N americanus and A duodenale will enter the circulatory system; from there, the hookworms migrate through the right-sided cardiopulmonary circuit and eventually ascend into the pulmonary vasculature.8 They then penetrate the lung capillary beds and parenchyma to reach the alveoli, ascend the respiratory tree, and, with the help of the mucociliary escalator, reach the esophagus, where they are swallowed by the host. In the gastrointestinal tract, adult hookworms consume host blood, mate, and lay eggs over a period of approximately 1 to 3 years if left untreated.9 Eggs are laid into the lower gastrointestinal tract, and the journey begins again in feces contacting ground or soil.
Geographic Distribution
Hookworms are found in almost all regions of the world, with species-specific distributions that highlight tropical and subtropical regions. Necator americanus and A duodenale are the most common hookworm species, with the former found predominantly in Southeast Asia and Latin America and the latter in Asia-Pacific regions.10 The highest prevalence of hookworms is in Southeast Asia followed by Sub-Saharan Africa, and the unique climate and soil composition of a region help determine the best environments for specific species of hookworm to thrive.11 In addition, socioeconomics and social determinants of health play a big role in the spread of hookworms, as hygiene practices (eg, wearing clean shoes and clothing, bathing), infrastructure (eg, clean water and streets), and anthelmintic campaigns help reduce transmission.12 Soil-transmitted helminths were once endemic to the southeastern United States, with some reports of approximately 40% of individuals infected in the south in the early 1900s.13 Anthelmintic campaigns such as water, sanitation, and hygiene programs as well as deworming of humans and livestock have proven effective in reducing the prevalence of helminth disease in industrialized nations.13,14 However, zoonotic infections remain a problem in these regions, and in some parts of the United States more than 40% of sampled cats and dogs harbored species such as A braziliense.15
Clinical Manifestation
Initial hookworm infection often goes unnoticed because symptoms can range in severity, but it is characterized by transient ground itch—a local pruritic, erythematous, and papular eruption that develops in response to epidermal penetration.16 Because the larvae must traverse the host from skin to target organs for reproduction over several weeks, iron-deficiency anemia will manifest much later than signs of the initial penetration. In the case of incidental infection from zoonotic Ancylostomatidae organisms, the misguided larvae result in CLM, an often intensely pruritic skin condition that will self-resolve in 2 to 8 weeks with eventual death of the larvae.5
Diagnosis and Pathology of Disease
Zoonotic Hookworm—The major presenting sign of zoonotic hookworm infection is CLM. The diagnosis of CLM usually is made clinically, as the larvae themselves are 0.5 mm thick to 10 mm long (Figure 1) and usually extend several centimeters beyond the dermal lesion, with dermoscopy having limited utility.17 Patients may begin to experience itching as little as 1 hour after hookworm penetration of the skin.18 Once in contact with the skin, the hookworms’ hyaluronidases and proteases are capable of breaking through the epidermis, but zoonotic hookworms typically are unable to penetrate the basal layer of the human epidermis and remain entombed between the stratum granulosum and stratum corneum. With the exception of rare cases of direct or indirect pulmonary involvement resulting in Löffler syndrome,19 the larvae will die within weeks to months, and symptoms will subsequently resolve.
Although the infection generally is self-limiting, the dermatologic manifestations of CLM can be severe and warrant intervention. The lesions start as small reddish papules at the site of penetration (Figure 2), then the hallmark elevated, migrating, serpiginous, urticarial rash develops (Figure 3). Cutaneous larva migrans generally manifests unilaterally and is both erythematous and intensely pruritic. As the larvae migrate, they leave behind 1- to 5-cm tunneled creeping eruptions in their wake. The lesions, which can manifest with pain or be painless, may develop eczematous, bullous, follicular, or impetiginized appearances.20 Atypical manifestations include folliculitis and urticarial plaques.17
cutaneous larval migrans on the palm.
Anthropophilic Hookworm—The lifecycles of N americanus and A duodenale are completed in human infection. Dermatologic manifestations are transient with the development of ground itch at the site of epidermal penetration. The hookworms employ collagenases that allow penetration of the basal layer of the skin, and eosinophilia develops as the parasites travel from the skin to the small intestine. Once attached to the gastrointestinal lumen, blood meals and proteolytic enzymes result in iron-deficiency anemia in the host and may lead to weakness, fatigue, and low birth weights in pregnant patients. With prolonged infection or heavy parasitic burden, patients can develop hypoproteinemia, anasarca, and yellowing of the skin known as chlorosis.11 A clinical diagnosis can be made by examining patient stool samples for eggs, and definitive characterization can be made using molecular tools such as polymerase chain reaction.21,22
Common to hookworm infections is the immune reaction, which promotes inflammation with localized eosinophilia and mastocytosis.11 In a clinical biopsy specimen of gut—usually obtained through esophagogastroduodenoscopy— T-helper (Th) 2–type immune (IL-4, IL-5, IL-9 and IL-13), regulatory Th10 (IL-10 and transcription growth factor β), and some evidence of Th1 (interferon gamma and IL-2) cytokines are present, but little evidence of Th17-type immune response was found.23 It is believed that in zoonotic infections, antiparasitic IgE from basophils are somewhat successful at trapping the helminths in the epidermis, but in the anthropophilic species, IgE and Th2 responses are ineffective at clearing the parasite from the gut, and the defeated immune system transitions to a host-tolerance approach of limiting infection.11 It is now believed that this natural armistice can be manipulated into a potential therapy against autoimmune and inflammatory conditions. Intentional infection with zoonotic whipworm or hookworm has been proposed as a mechanism of switching Th1 and Th2 responses to host-tolerant mechanisms in conditions such as Crohn disease and celiac disease,24 and it has even been hypothesized that prior hookworm infection may reduce the chance of developing allergic conditions such as eczema.25
Treatment and Prevention
The World Health Organization and Centers for Disease Control and Prevention recommend a single oral dose of 400 mg albendazole for adults or 10 to 15 mg/kg in children for CLM. A single dose of ivermectin at 12 mg in adults or 150 μg/kg in children can be used as an alternative where albendazole is not available.11 Topical applications of thiabendazole 10% to 15% under occlusion or 3 times daily for 15 days without occlusion also can manage CLM, and pruritus can be treated with topical corticosteroids for symptomatic relief. Oral albendazole 400 mg twice daily or mebendazole 100 mg twice daily for 3 days or a single 500-mg dose, as well as 11 mg/kg (up to a maximum of 1 g) oral pyrantel pamoate once daily for 3 days can be used to treat intestinal hookworm infection, though it should be avoided in pregnancy. Iron deficiency should be managed with supplementation.11
Prevention of hookworm infection is focused around 2 broad public health efforts: mass drug administration programs and the water, sanitation, and hygiene program. In mass drug administration, treatments such as benzimidazoles are given in mass to communities affected by endemic hookworm as a single dose to reduce the burden of disease. Together, these strategies effectively eliminated hookworms in many developed nations, but areas of resurgence are beginning to surface worldwide. With changes in climate, emerging drug resistance, and socioeconomic disparities, particularly affecting the southeast, a resurgence of hookworm has occurred in the United States.26 One recent study demonstrated that almost one-third (19/55) of children sampled in an impoverished area of rural Alabama had hookworm eggs in their stool.27 Furthermore, pets serve not only as zoonotic reservoirs for CLM recurrence but also as vehicles for the evolution of drug-resistant strains, leading some to call for a ban of animals from beaches and playgrounds as well as tightly controlled veterinary programs.5,28 Ubiquitous benzimidazole use in livestock has led to bendazole-resistant strains, and it is likely that with continued and poorly adherent drug use, more zoonotic and anthropophilic drug-resistant strains of hookworm will emerge.29,30
Conclusion
The burden of hookworm infection and CLM is substantial in parts of the United States. Dermatologists play a critical role in the recognition and management of hookworm infection for both treatment of affected patients and the subsequent prevention of its spread. As drug-resistant strains evolve, clinicians, public health officials, and scientists need to continue to work together to prevent and treat hookworm infection.
It is estimated that the prevalence of human hookworm infection is approximately 450 million individuals worldwide, representing a substantial global disease burden.1 The annual global public health burden ranges from approximately 2 million to 4 million disability-adjusted life-years and $10 billion to $140 billion in hookwormrelated costs.2 In this article, we discuss the lifecycle, transmission, and disease burden of cutaneous larva migrans (CLM) as well as prevention and treatment strategies.
Background
The Ancylostomatidae nematode family comprises at least 68 known species of hookworm that infect more than 110 different species of mammals.3 Many of these parasites are able to infect more than 1 primary host species, but from a disease perspective they can be classified as either anthropophilic, with humans as the intended host, or zoonotic, with humans as an incidental host. It is important to make this distinction because, though the lifecycles and biology of hookworm species generally are similar, the manifestations of incidental human infection from zoonotic hookworms are different from those of anthropophilic hookworms. Of the anthropophilic species, Necator americanus and Ancylostoma duodenale predominate. In the instance of zoonotic hookworm, dog-infecting A caninum and cat- and doginfecting A braziliense and Uncinaria stenocephala are common causes of incidental human disease.3
The life cycle of Ancylostomatidae organisms is astounding. Through millions of years of co-evolution with mammals,4 these parasitic worms have developed perhaps one of the most circuitous paths to propagate themselves in the natural world. Hookworms start their arduous journey as eggs deposited in soil, sand, and ground vegetation from the feces of infected animals.5 Approximately 1 day after the eggs are deposited, they hatch and begin the larval stage, during which they become infective 1 to 5 weeks later. At this point, the larvae become sensitive to their environment, responding to rising temperatures, increasing carbon dioxide levels, and vibrations in the soil—all of which suggest the presence of a potential host and contribute to a concordant increase in undulatory movement of the larvae.5,6 Here, the most vulnerable tissues include the uncovered soles, palms, and buttocks of host mammals that come into contact with contaminated soil. In an undulating fashion and guided by temperature cues, the larvae locate the skin of the host and utilize a mixture of enzymes including hyaluronidases, metalloprotease, and other proteases to penetrate the epidermis.7 Anthropophilic hookworms such as N americanus and A duodenale will enter the circulatory system; from there, the hookworms migrate through the right-sided cardiopulmonary circuit and eventually ascend into the pulmonary vasculature.8 They then penetrate the lung capillary beds and parenchyma to reach the alveoli, ascend the respiratory tree, and, with the help of the mucociliary escalator, reach the esophagus, where they are swallowed by the host. In the gastrointestinal tract, adult hookworms consume host blood, mate, and lay eggs over a period of approximately 1 to 3 years if left untreated.9 Eggs are laid into the lower gastrointestinal tract, and the journey begins again in feces contacting ground or soil.
Geographic Distribution
Hookworms are found in almost all regions of the world, with species-specific distributions that highlight tropical and subtropical regions. Necator americanus and A duodenale are the most common hookworm species, with the former found predominantly in Southeast Asia and Latin America and the latter in Asia-Pacific regions.10 The highest prevalence of hookworms is in Southeast Asia followed by Sub-Saharan Africa, and the unique climate and soil composition of a region help determine the best environments for specific species of hookworm to thrive.11 In addition, socioeconomics and social determinants of health play a big role in the spread of hookworms, as hygiene practices (eg, wearing clean shoes and clothing, bathing), infrastructure (eg, clean water and streets), and anthelmintic campaigns help reduce transmission.12 Soil-transmitted helminths were once endemic to the southeastern United States, with some reports of approximately 40% of individuals infected in the south in the early 1900s.13 Anthelmintic campaigns such as water, sanitation, and hygiene programs as well as deworming of humans and livestock have proven effective in reducing the prevalence of helminth disease in industrialized nations.13,14 However, zoonotic infections remain a problem in these regions, and in some parts of the United States more than 40% of sampled cats and dogs harbored species such as A braziliense.15
Clinical Manifestation
Initial hookworm infection often goes unnoticed because symptoms can range in severity, but it is characterized by transient ground itch—a local pruritic, erythematous, and papular eruption that develops in response to epidermal penetration.16 Because the larvae must traverse the host from skin to target organs for reproduction over several weeks, iron-deficiency anemia will manifest much later than signs of the initial penetration. In the case of incidental infection from zoonotic Ancylostomatidae organisms, the misguided larvae result in CLM, an often intensely pruritic skin condition that will self-resolve in 2 to 8 weeks with eventual death of the larvae.5
Diagnosis and Pathology of Disease
Zoonotic Hookworm—The major presenting sign of zoonotic hookworm infection is CLM. The diagnosis of CLM usually is made clinically, as the larvae themselves are 0.5 mm thick to 10 mm long (Figure 1) and usually extend several centimeters beyond the dermal lesion, with dermoscopy having limited utility.17 Patients may begin to experience itching as little as 1 hour after hookworm penetration of the skin.18 Once in contact with the skin, the hookworms’ hyaluronidases and proteases are capable of breaking through the epidermis, but zoonotic hookworms typically are unable to penetrate the basal layer of the human epidermis and remain entombed between the stratum granulosum and stratum corneum. With the exception of rare cases of direct or indirect pulmonary involvement resulting in Löffler syndrome,19 the larvae will die within weeks to months, and symptoms will subsequently resolve.
Although the infection generally is self-limiting, the dermatologic manifestations of CLM can be severe and warrant intervention. The lesions start as small reddish papules at the site of penetration (Figure 2), then the hallmark elevated, migrating, serpiginous, urticarial rash develops (Figure 3). Cutaneous larva migrans generally manifests unilaterally and is both erythematous and intensely pruritic. As the larvae migrate, they leave behind 1- to 5-cm tunneled creeping eruptions in their wake. The lesions, which can manifest with pain or be painless, may develop eczematous, bullous, follicular, or impetiginized appearances.20 Atypical manifestations include folliculitis and urticarial plaques.17
cutaneous larval migrans on the palm.
Anthropophilic Hookworm—The lifecycles of N americanus and A duodenale are completed in human infection. Dermatologic manifestations are transient with the development of ground itch at the site of epidermal penetration. The hookworms employ collagenases that allow penetration of the basal layer of the skin, and eosinophilia develops as the parasites travel from the skin to the small intestine. Once attached to the gastrointestinal lumen, blood meals and proteolytic enzymes result in iron-deficiency anemia in the host and may lead to weakness, fatigue, and low birth weights in pregnant patients. With prolonged infection or heavy parasitic burden, patients can develop hypoproteinemia, anasarca, and yellowing of the skin known as chlorosis.11 A clinical diagnosis can be made by examining patient stool samples for eggs, and definitive characterization can be made using molecular tools such as polymerase chain reaction.21,22
Common to hookworm infections is the immune reaction, which promotes inflammation with localized eosinophilia and mastocytosis.11 In a clinical biopsy specimen of gut—usually obtained through esophagogastroduodenoscopy— T-helper (Th) 2–type immune (IL-4, IL-5, IL-9 and IL-13), regulatory Th10 (IL-10 and transcription growth factor β), and some evidence of Th1 (interferon gamma and IL-2) cytokines are present, but little evidence of Th17-type immune response was found.23 It is believed that in zoonotic infections, antiparasitic IgE from basophils are somewhat successful at trapping the helminths in the epidermis, but in the anthropophilic species, IgE and Th2 responses are ineffective at clearing the parasite from the gut, and the defeated immune system transitions to a host-tolerance approach of limiting infection.11 It is now believed that this natural armistice can be manipulated into a potential therapy against autoimmune and inflammatory conditions. Intentional infection with zoonotic whipworm or hookworm has been proposed as a mechanism of switching Th1 and Th2 responses to host-tolerant mechanisms in conditions such as Crohn disease and celiac disease,24 and it has even been hypothesized that prior hookworm infection may reduce the chance of developing allergic conditions such as eczema.25
Treatment and Prevention
The World Health Organization and Centers for Disease Control and Prevention recommend a single oral dose of 400 mg albendazole for adults or 10 to 15 mg/kg in children for CLM. A single dose of ivermectin at 12 mg in adults or 150 μg/kg in children can be used as an alternative where albendazole is not available.11 Topical applications of thiabendazole 10% to 15% under occlusion or 3 times daily for 15 days without occlusion also can manage CLM, and pruritus can be treated with topical corticosteroids for symptomatic relief. Oral albendazole 400 mg twice daily or mebendazole 100 mg twice daily for 3 days or a single 500-mg dose, as well as 11 mg/kg (up to a maximum of 1 g) oral pyrantel pamoate once daily for 3 days can be used to treat intestinal hookworm infection, though it should be avoided in pregnancy. Iron deficiency should be managed with supplementation.11
Prevention of hookworm infection is focused around 2 broad public health efforts: mass drug administration programs and the water, sanitation, and hygiene program. In mass drug administration, treatments such as benzimidazoles are given in mass to communities affected by endemic hookworm as a single dose to reduce the burden of disease. Together, these strategies effectively eliminated hookworms in many developed nations, but areas of resurgence are beginning to surface worldwide. With changes in climate, emerging drug resistance, and socioeconomic disparities, particularly affecting the southeast, a resurgence of hookworm has occurred in the United States.26 One recent study demonstrated that almost one-third (19/55) of children sampled in an impoverished area of rural Alabama had hookworm eggs in their stool.27 Furthermore, pets serve not only as zoonotic reservoirs for CLM recurrence but also as vehicles for the evolution of drug-resistant strains, leading some to call for a ban of animals from beaches and playgrounds as well as tightly controlled veterinary programs.5,28 Ubiquitous benzimidazole use in livestock has led to bendazole-resistant strains, and it is likely that with continued and poorly adherent drug use, more zoonotic and anthropophilic drug-resistant strains of hookworm will emerge.29,30
Conclusion
The burden of hookworm infection and CLM is substantial in parts of the United States. Dermatologists play a critical role in the recognition and management of hookworm infection for both treatment of affected patients and the subsequent prevention of its spread. As drug-resistant strains evolve, clinicians, public health officials, and scientists need to continue to work together to prevent and treat hookworm infection.
- Vos T, Abajobir AA, Abate KH, et al. Global, regional, and national incidence, prevalence, and years lived with disability for 328 diseases and injuries for 195 countries, 1990-2016: a systematic analysis for the Global Burden of Disease Study 2016. Lancet. 2017;390:1211-1259.
- Bartsch SM, Hotez PJ, Asti L, et al. The global economic and health burden of human hookworm infection. PLoS Negl Trop Dis. 2016;10:E0004922.
- Seguel M, Gottdenker N. The diversity and impact of hookworm infections in wildlife. Int J Parasitol Parasites Wildl. 2017;6:177-194.
- Adams BJ, Peat SM, Dillman AR. Phylogeny and evolution. In: Entomopathogenic Nematodes: Systematics, Phylogeny and Bacterial Symbionts. Brill; 2010:693-733.
- Heukelbach J, Feldmeier H. Epidemiological and clinical characteristics of hookworm-related cutaneous larva migrans. Lancet Infect Dis. 2008;8:302-309.
- Haas W, Haberl B, Idris I, et al. Infective larvae of the human hookworms Necator americanus and Ancylostoma duodenale differ in their orientation behaviour when crawling on surfaces. Parasitol Res. 2005;95:25-29.
- Hotez P, Narasimhan S, Haggerty J, et al. Hyaluronidase from infective Ancylostoma hookworm larvae and its possible function as a virulence factor in tissue invasion and in cutaneous larva migrans. Infect Immun. 1992;60:1018-1023.
- Brooker S, Bethony J, Hotez PJ. Human hookworm infection in the 21st century. Adv Parasitol. 2004;58:197-288.
- Hoagland K, Schad G. Necator americanus and Ancylostoma duodenale: life history parameters and epidemiological implications of two sympatric hookworms of humans. Exp Parasitol. 1978;44:36-49.
- Clements ACA, Alene KA. Global distribution of human hookworm species and differences in their morbidity effects: a systematic review. Lancet Microbe. 2022;3:E72-E79.
- Loukas A, Hotez PJ, Diemert D, et al. Hookworm infection. Nat Rev Dis Primers. 2016;2:1-18.
- Gazzinelli A, Correa-Oliveira R, Yang GJ, et al. A research agenda for helminth diseases of humans: social ecology, environmental determinants, and health systems. PLoS Negl Trop Dis. 2012;6:E1603.
- Starr MC, Montgomery SP. Soil-transmitted helminthiasis in the United States: a systematic review—1940-2010. Am J Trop Med Hyg. 2011;85:680-684.
- Strunz EC, Addiss DG, Stocks ME, et al. Water, sanitation, hygiene, and soil-transmitted helminth infection: a systematic review and metaanalysis. PLoS Med. 2014;11:E1001620.
- Liotta JL, Youn H, Aksel S, et al. Prevalence of Ancylostoma braziliense in dogs from Alachua and Marion Counties, Florida, United States. J Parasitol. 2012;98:1039-1040.
- Hotez PJ, Brooker S, Bethony JM, et al. Hookworm infection. N Engl J Med. 2004;351:799-807.
- Prickett KA, Ferringer TC. What’s eating you? cutaneous larva migrans. Cutis. 2015;95:126-128.
- Feldmeier H, Schuster A. Mini review: hookworm-related cutaneous larva migrans. Eur J Clin Microbiol Infect Dis. 2012;31:915-918.
- Tan SK, Liu TT. Cutaneous larva migrans complicated by Löffler syndrome. Arch Dermatol. 2010;146:210-212.
- Eksomtramage T, Aiempanakit K. Bullous and pustular cutaneous larva migrans: two case reports and a literature review. IDCases. 2018;12:130-132.
- Utzinger J, Rinaldi L, Lohourignon LK, et al. FLOTAC: a new sensitive technique for the diagnosis of hookworm infections in humans. Trans R Soc Trop Med Hyg. 2008;102:84-90.
- Chidambaram M, Parija SC, Toi PC, et al. Evaluation of the utility of conventional polymerase chain reaction for detection and species differentiation in human hookworm infections. Trop Parasitol. 2017;7:111-116.
- Gaze S, McSorley HJ, Daveson J, et al. Characterising the mucosal and systemic immune responses to experimental human hookworm infection. PLoS Pathog. 2012;8:E1002520.
- Croese J, O’Neil J, Masson J, et al. A proof of concept study establishing Necator americanus in Crohn’s patients and reservoir donors. Gut. 2006;55:136-137.
- Mpairwe H, Amoah AS. Parasites and allergy: observations from Africa. Parasite Immunol. 2019;41:E12589.
- Albonico M, Savioli L. Hookworm: a neglected resurgent infection. Editorial. BMJ. 2017;359:j4813.
- McKenna ML, McAtee S, Bryan PE, et al. Human intestinal parasite burden and poor sanitation in rural Alabama. Am J Trop Med Hyg. 2017;97:1623-1628.
- Traversa D. Pet roundworms and hookworms: a continuing need for global worming. Parasit Vectors. 2012;5:1-19.
- Geerts S, Gryseels B. Drug resistance in human helminths: current situation and lessons from livestock. Clin Microbiol Rev. 2000;13:207-222.
- Jimenez Castro PD, Howell SB, Schaefer JJ, et al. Multiple drug resistance in the canine hookworm Ancylostoma caninum: an emerging threat? Parasit Vectors. 2019;12:1-15.
- Vos T, Abajobir AA, Abate KH, et al. Global, regional, and national incidence, prevalence, and years lived with disability for 328 diseases and injuries for 195 countries, 1990-2016: a systematic analysis for the Global Burden of Disease Study 2016. Lancet. 2017;390:1211-1259.
- Bartsch SM, Hotez PJ, Asti L, et al. The global economic and health burden of human hookworm infection. PLoS Negl Trop Dis. 2016;10:E0004922.
- Seguel M, Gottdenker N. The diversity and impact of hookworm infections in wildlife. Int J Parasitol Parasites Wildl. 2017;6:177-194.
- Adams BJ, Peat SM, Dillman AR. Phylogeny and evolution. In: Entomopathogenic Nematodes: Systematics, Phylogeny and Bacterial Symbionts. Brill; 2010:693-733.
- Heukelbach J, Feldmeier H. Epidemiological and clinical characteristics of hookworm-related cutaneous larva migrans. Lancet Infect Dis. 2008;8:302-309.
- Haas W, Haberl B, Idris I, et al. Infective larvae of the human hookworms Necator americanus and Ancylostoma duodenale differ in their orientation behaviour when crawling on surfaces. Parasitol Res. 2005;95:25-29.
- Hotez P, Narasimhan S, Haggerty J, et al. Hyaluronidase from infective Ancylostoma hookworm larvae and its possible function as a virulence factor in tissue invasion and in cutaneous larva migrans. Infect Immun. 1992;60:1018-1023.
- Brooker S, Bethony J, Hotez PJ. Human hookworm infection in the 21st century. Adv Parasitol. 2004;58:197-288.
- Hoagland K, Schad G. Necator americanus and Ancylostoma duodenale: life history parameters and epidemiological implications of two sympatric hookworms of humans. Exp Parasitol. 1978;44:36-49.
- Clements ACA, Alene KA. Global distribution of human hookworm species and differences in their morbidity effects: a systematic review. Lancet Microbe. 2022;3:E72-E79.
- Loukas A, Hotez PJ, Diemert D, et al. Hookworm infection. Nat Rev Dis Primers. 2016;2:1-18.
- Gazzinelli A, Correa-Oliveira R, Yang GJ, et al. A research agenda for helminth diseases of humans: social ecology, environmental determinants, and health systems. PLoS Negl Trop Dis. 2012;6:E1603.
- Starr MC, Montgomery SP. Soil-transmitted helminthiasis in the United States: a systematic review—1940-2010. Am J Trop Med Hyg. 2011;85:680-684.
- Strunz EC, Addiss DG, Stocks ME, et al. Water, sanitation, hygiene, and soil-transmitted helminth infection: a systematic review and metaanalysis. PLoS Med. 2014;11:E1001620.
- Liotta JL, Youn H, Aksel S, et al. Prevalence of Ancylostoma braziliense in dogs from Alachua and Marion Counties, Florida, United States. J Parasitol. 2012;98:1039-1040.
- Hotez PJ, Brooker S, Bethony JM, et al. Hookworm infection. N Engl J Med. 2004;351:799-807.
- Prickett KA, Ferringer TC. What’s eating you? cutaneous larva migrans. Cutis. 2015;95:126-128.
- Feldmeier H, Schuster A. Mini review: hookworm-related cutaneous larva migrans. Eur J Clin Microbiol Infect Dis. 2012;31:915-918.
- Tan SK, Liu TT. Cutaneous larva migrans complicated by Löffler syndrome. Arch Dermatol. 2010;146:210-212.
- Eksomtramage T, Aiempanakit K. Bullous and pustular cutaneous larva migrans: two case reports and a literature review. IDCases. 2018;12:130-132.
- Utzinger J, Rinaldi L, Lohourignon LK, et al. FLOTAC: a new sensitive technique for the diagnosis of hookworm infections in humans. Trans R Soc Trop Med Hyg. 2008;102:84-90.
- Chidambaram M, Parija SC, Toi PC, et al. Evaluation of the utility of conventional polymerase chain reaction for detection and species differentiation in human hookworm infections. Trop Parasitol. 2017;7:111-116.
- Gaze S, McSorley HJ, Daveson J, et al. Characterising the mucosal and systemic immune responses to experimental human hookworm infection. PLoS Pathog. 2012;8:E1002520.
- Croese J, O’Neil J, Masson J, et al. A proof of concept study establishing Necator americanus in Crohn’s patients and reservoir donors. Gut. 2006;55:136-137.
- Mpairwe H, Amoah AS. Parasites and allergy: observations from Africa. Parasite Immunol. 2019;41:E12589.
- Albonico M, Savioli L. Hookworm: a neglected resurgent infection. Editorial. BMJ. 2017;359:j4813.
- McKenna ML, McAtee S, Bryan PE, et al. Human intestinal parasite burden and poor sanitation in rural Alabama. Am J Trop Med Hyg. 2017;97:1623-1628.
- Traversa D. Pet roundworms and hookworms: a continuing need for global worming. Parasit Vectors. 2012;5:1-19.
- Geerts S, Gryseels B. Drug resistance in human helminths: current situation and lessons from livestock. Clin Microbiol Rev. 2000;13:207-222.
- Jimenez Castro PD, Howell SB, Schaefer JJ, et al. Multiple drug resistance in the canine hookworm Ancylostoma caninum: an emerging threat? Parasit Vectors. 2019;12:1-15.
What’s Eating You? Hookworm and
Cutaneous Larva Migrans
What’s Eating You? Hookworm and
Cutaneous Larva Migrans
PRACTICE POINTS
- Anthropophilic hookworm infection should be considered with evidence of either transient ground itch or iron-deficient anemia in individuals who go barefoot, permitting ground-to-skin transmission.
- Zoonotic hookworm infection manifests as cutaneous larva migrans, an elevated serpiginous rash that, while usually self-resolving, can be intensely pruritic and should be treated accordingly.
- Considered a neglected tropical disease, hookworm infection still represents an enormous global disease burden. In addition to ongoing afflicted regions, hookworms are making a resurgence in developed nations, and drug-resistant strains have evolved.



